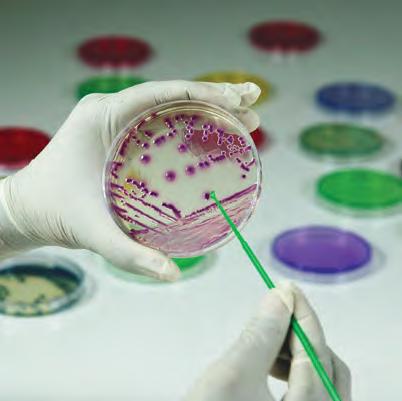

![]()
















































Over 35,000 sq. metres of spectacular shopping. Thousands of limited editions and travel exclusives. Hundreds of the world’s most desirable brands. But only one glorious destination: Dubai Duty Free.




































From the mind and heart of patented scientist and humanitarian Dr. Christina Rahm comes STRATA Biotechnology Labs, a U.S. based manufacturing facility dedicated to formulating the highest quality products using the cleanest ingredients, sourced globally. Designed for humans, pets, and the environment, STRATA pioneers innovation with purity at its core.

MONPARA CHAIRMAN, MODERN GROUP OF




100% Made in Uganda
Tembo Steels stands as a testament to Uganda’s industrial transformation, leading the way since its inception in 2000. By championing sustainability, innovation, and self-reliance, the company has set new benchmarks in steel production, not only within Uganda but across the African continent. Through steadfast support of the Buy Uganda Build Uganda initiative, Tembo Steels has played a crucial role in reducing dependence on imported steel, empowering local industries,andfuelingregionaleconomicprogress.
Among its many achievements, Tembo Steels became the world’s first to manufacture low-carbon steel directly from cast iron, marking a pivotal advancement toward environmentally friendly production. The company has also pioneered the creation of ultra-thin 0.7mm hotrolled sheets using continuous configuration techniques, and introduced the world’s lightest structural sections through direct rolling. These innovations have firmly established Tembo Steels as a leader in sustainable, high-quality steel manufacturing, inspiring growth across Africa’sindustriallandscape.


Tembo leverages synergistic approach of Environmentally Friendlypracticesproventoreduce CO2 emissions up to 70% in primarysteelmaking.


Tembo Steels stands at the forefront of green steel manufacturing, demonstrating a steadfast commitment to environmental responsibility. Through continuous research and development, the company has refined its steel-making processes, embracing innovative technologies that dramatically reduce carbon emissions. By prioritizing sustainable and cost-effective methods, Tembo Steels has successfully achieved a remarkable 70% reduction in CO2 emissions during primary steel production. This achievement positions the company as a trailblazer in eco-friendly manufacturing, setting new benchmarks for the global steel industry.

The only company in Africa to Manufacture HRC, Structural Steel, Wire Rod & TMT from IronOre.


Technologically Advanced
World’s Lightest Structural Steel & 0.6mm HRC through direct rolling in continuousconfiguration.
World’s first convertor to produce low carbonsteelfromCastIronforAfrica


























Kuwait, December 2025 – Boubyan Takaful Insurance Kuwait has successfully implemented its next-generation Medical and Core ERP platform, delivered byAcess Meditech Pvt. Ltd. The initiative underscores a strategic move to enhance Kuwait’s digital insurance ecosystem, streamline operations, and elevate customer experience across core insurance functions.
“This rollout reflects our commitment to modern, intelligent, and customer-centric systems that enable real-time service delivery and scalable growth,” said a Boubyan Takaful spokesperson.
ANew Era of Insurance Technology in Kuwait
With a footprint across KSA, UAE, and Kuwait, Acess Meditech Group has emerged as a leading InsurTech solutions provider in the Middle East and Asia. Its ERP platforms are designed exclusively for insurers, combining deep domain expertise with digital innovation.
Key Capabilities:
• Domain-driven workflows tailored to insurer operations
• Modern underwriting and policy administration
• Seamless claims management
• IFRS-enabled finance and reporting
•AI-supported analytics and process automation
“Our solutions are configurable to each insurer’s operational DNA, ensuring alignment with product lines, customer journeys, and regulatory compliance,” noted Mr. SyedAijazuddin, CEO,Acess Meditech Group.
Boubyan Takaful’s StrategicAchievement
The implementation included:
• LIMRAERP – Supporting general insurance and Takaful operations
• TOSHFAERP – Streamlining medical claims and policy administration
Accelerated deployment enabled immediate activation across key insurance processes. Under CEO Mr. EbrahimAlkhuzam’s leadership, Boubyan achieved rapid adoption of new workflows, including digital policy issuance, centralized claims tracking, and automated approvals.




Boubyan’s teams now benefit from: Automated policy issuance with integrated compliance controls. Launch of brand-new Group Life and Credit Life products — innovative offerings crafted specifically for Kuwait’s insurance landscape.
Secure biometric-enabled customer verification.
Real-time financial modules for budgeting and revenue recognition. End-to-end claims transparency.
AI-powered policy advisory and knowledge-training modules.
Dedicated training programs ensured smooth adoption, strengthened internal governance, and safeguarded business continuity.
ATechnologyAdvancement with Strategic Value
This successful implementation is more than a milestone—it represents a future-aligned direction for Kuwait’s insurance sector, where efficiency, digital service delivery, and intelligent decision-making converge.
Impact for Boubyan Takaful:
•Agile underwriting and precise product administration
• Scalable operations with faster time-to-service
Impact forAcess Meditech:
• Reinforced leadership as a trusted InsurTech partner in Kuwait
• Expansion of regional influence across MENAinsurance markets

“This collaboration sets a new benchmark in leveraging technology for operational excellence and customercentric insurance services,” concluded Mr.Aijazuddin.













For thirty five years, Diagnofirm has grown hand in hand with Botswana, walking a journey of faith, courage, and purpose. What began as a single laboratory in Gaborone has become a name generations of families trust with their health. Founded by Professor Mohammed Iqbal Chand and Mrs Waheeda Chand. Diagnofirm was built on the belief that Batswana could create world class healthcare for their own people. Every test, every report, and every life touched carries that same promise, care delivered with integrity, precision, and heart.
As we celebrate this milestone, we honour the vision that started it all, the people who continue to bring it to life, and the nation that has supported us from the beginning. Thirty five years later, that dream still grows stronger and our story is far from over.













































































“The world looks at India as an important pillar of stability. A friend who can be trusted, a partner who believes in people-centric development, a voice that believes in global good, a voice of the Global South, an engine of growth in the global economy, a technology hub for finding solutions, a powerhouse of talented youth and a democracy that delivers,” these momentous words by none other than the world’s most popular democratic leader (with a 75 percent approval rating, as per US-based data analytics firm Morning Consult), Shri Narendra Modi, strike a chord with varied leaders from across the globe. Rightly so, India’s growing clout has enabled it to acquire a prominent position on the world map. Today, it is being applauded as one of the world’s fastest-growing major economies, a “bright spot” that will contribute significantly to global growth as per the IMF. The World Bank has also pinned high hopes on India’s economic potential. These hopes are backed by the fact that foreign investments in India in 2025 have increased manifold. It witnessed a historic $81 billion worth of foreign investments in FY24-25 alone. Fueled by steady economic growth, a rapidly expanding middle class, and business-friendly policies, India occupies centre stage in global boardrooms. With a large, young, and growing population, India presents a vast domestic market. In fact, one of its major assets is that the nation is the abode of one of the youngest populations in the world, with a median age of 28, a significant advantage for potential innovation and economic growth in the coming decades. Global firms like Airbus, Microsoft, Apple, Foxconn, Amazon, Samsung, NTT Data, Vinfast, Nissan, Renault, Nestle; and nations like US, UK, EU, UAE, Saudi Arabia, Japan, Germany, Israel, Russia, Singapore, and Australia are eager to invest and partner with India, driven by India’s growing economy and focus on sectors like defence, clean energy, infrastructure, digital tech, and manufacturing. Thus, companies from all over the world are investing in India due to its increasing strategic importance in the global economic landscape.
The fact that India is rapidly emerging as a technology hub, with a booming startup ecosystem (the third-largest globally) with a focus on digital infrastructure has garnered much international attention. India’s progress in varied spheres is applauded by one and all as the world benefits from it. This includes sharing expertise in areas like Yoga and Ayurveda, and offering solutions to global challenges, such as providing medicines and vaccines during the COVID-19 pandemic and facilitating the inclusion of African Union during its G20 Presidency. As a “Vishwa Bandhu” (friend of the world), it emphasized upon “One Earth, One Family, One Future” and brought Southern concerns like food/ fuel insecurity and climate finance to the forefront. In a nutshell, India is marching steadily to be a US$ 30 trillion economy with all the attributes of a developed nation (Viksit Bharat) by 2047.
‘Viksit Bharat’ was one of the prominent themes at the 26th Asian Business & Social Forum 2025 hosted by AsiaOne Media Group at the JW Marriott Marquis Hotel Dubai, which was attended by royal dignitaries and eminent personalities from business, cinema, and arts from all over the globe. Distinguished Indian and NRI business leaders such as Dr. Surender Singh Kandhari, Mr. Feroz Allana, Dr. Raza Siddiqui, Mr. Paras Shahdadpuri, Dr. Shafi Ul Mulk, Mr. Avi Bhojani, Mr. Piyush Jha, Dr. Vishal G. Warke and Mr. Anish Singh Thakur were recognised at the forum with ‘Viksit Bharat Commitment Awards.’
Travel enables us to restore, revive, and reconnect. The Ambassadors of Argentina and Jordan describe some of the most attractive travel destinations of the world.
As India is set out on the path of prosperity, inclusivity, sustainability, and good governance, we are pleased to feature our special coverage on ‘Towards a Viksit Bharat 2047 — The India We Dream Of,’ a detailed compilation with messages received from Indian Central government ministers.
A new generation of young leaders is leaving a lasting mark on the world. Our story on the ‘Most Influential Young Leaders of the World’ showcases those
visionaries who are transforming industries, driving technological innovation, and creating opportunities that go far beyond business.
A Readers’ Page is being introduced in our subsequent issues. We want to keep it an open arena, where our readers may contribute on any topic of regional, national, international or personal importance (social, economic, political or emotional). You may send your articles to me for the Reader’s Page and then some constructive feedback on our endeavours and the stories. I’m available at richa@ asiaone.co.in for all that you feel is valuable and intend to share.
RICHA SANG Chief Editor
richa@asiaone.co.in @richa_sang











GLOBAL HEAD & PRINCIPAL PARTNER
RAJAT RAJ SHUKAL rajat@asiaone.co.in
CEO & PUBLISHER
SANDEEP KUMAR sandeep@asiaone.co.in

ROMISA HASSAN

INDERJEET JAIN
SUBSCRIPTION dubai@asiaone.co.in
EDITORIAL
CHIEF EDITOR
ASSISTANT EDITOR
RICHA SANG richa@asiaone.co.in
MONALISA CHOUDHURY monalisa@asiaone.co.in
GENERAL MANAGER ROMISA HASSAN
RESEARCH & PROJECTS
SENIOR ASSOCIATE, EDITORIAL & RESEARCH - EUROPE
VICE PRESIDENT
PAOLA MARTANI
DEEPIKA SHARMA
CORPORATE MARKETING
GENERAL MANAGER
DEPUTY GENERAL MANAGER MANAGER
ALISH PEKHA
RAJASHRI SARKAR
KOMAL TANWAR
ART DESK
ASST. ART DIRECTOR
SENIOR MANAGER
INDERJEET JAIN
NITESH SHARMA



PAOLA MARTANI
ADVERTISEMENT global@asiaone.co.in
Views and opinions expressed in this magazine are not necessarily those of URS Media Consulting Pvt. Ltd. We, at URS AsiaOne do our best to verify the information published. Hence, we do not take responsibility for complete accuracy of the information. URS Media Consulting Pvt. Ltd. does not take responsibility for any investment or any other decision taken by a reader on the basis of information provided here upon.
AsiaOne Ltd. is headquartered at Office #213, Bldg. 6EA, East Wing, Dubai, Airport Freezone, UAE. URS AsiaOne Pte.Ltd. 151 Chin Swee Road #07-12, Manhattan House, Singapore ( 169876 )
Phone : +65 94872470 It’s India Research and Publishing House is Located at Office No. 606, 6th Floor, DLF South Court, Saket District Centre, New Delhi – 110017, India. www.asiaone.me, www.asiaone.co.in
Ph: +971-506695168; +91-011-43281161/62/63/64/65/66 +91-8287940740
URS AsiaOne does not accept responsibility for returning unsolicited manuscripts and photographs. All unsolicited material should be accompanied by self-addressed envelopes and sufficient postage. Published and printed by Sandeep Kumar for and on behalf of the owner. URS Media Consulting Pvt. Ltd. at Office No. 606, 6th Floor, DLF South Court, Saket District Centre, New Delhi – 110017, India and printed at G. H. International, Okhla Industrial Area, Phase – I, New Delhi, India. Editor: Richa Sang. © Reproduction in whole or in part without written permission of the publisher is prohibited. All rights reserved. RNI No. DELENG / 2016 / 68514

RAVI NAIDU Where Vision Shapes Sustainability
DR. SANTOSH GUMTE Driving Positive Change 96
SHEKHAR NATARAJAN The Wedding Ring, The Telegraph, & What AI Should Never Forget
SUKANT MISHRA The Mind Behind Global Impact
SUKH SANDHU Sculpting Excellence





















TECHURATE
BAJAJ
FORE
VINFAST
CAREER
ELPRO
JAIPUR
INDIRA
BILLABONG
BRAMHAPRIYA
BRINDAVAN
GLOBAL
KUMAR


NEP 2020 Aligned Curriculum
Thematic Learning in Schools
Outstanding achievements in scholastic and co-scholastic realms
Excellent Assistance in Placements & Internships
Several Scholarships Available
Holistic and Value-based education rooted in Indian Culture
21st Century Skills at all levels

Apeejay Education awarded as "Leading Education Group of the Year 2023" at World Education Summit, Dubai
26

For more details, please contact:
Apeejay Stya Block, APJ School Road, Sheikh Sarai Phase-1, New Delhi - 110017
Tel: (011) 26012212 / 13 / 14 | Email: admissions.asm@apeejay.edu Website: www.apeejay.edu/asm


DR. J.C. CHAUDHRY EXCELLENCE AWARDS 2025


Dr. J. C. Chaudhry Excellence Awards 2025 is a celebration of leadership that transcends profit charts and boardroom achievements. At its centre is Dr. J.C. Chaudhry himself— a man whose work has changed the way people think about success. Known for introducing numerology into business strategy, he has shown that intuition and intellect can work together to create remarkable results. Through his company, “Chaudhry Numero Pvt. Ltd.”, he has helped countless organisations find direction, make better decisions, and achieve growth with greater clarity and purpose.
Over the years, Dr. Chaudhry’s influence has extended far beyond his professional achievements. He has encouraged a more responsible and compassionate form of entrepreneurship that measures success not just in numbers but in the positive difference made to people and communities. His approach integrates logic with humanity, and this balance has earned him deep respect across industries. To honour his life’s work and recognise others who share his spirit of excellence, AsiaOne


Magazine has instituted “Dr. J.C. Chaudhry Excellence Awards 2025” as a tribute to leaders who are bringing real change to society.
This prestigious award was created to salute leaders and brands that represent responsible leadership and good governance. Named after Dr. Chaudhry, it reflects his lifelong belief that true business excellence comes from service, purpose, and integrity. The idea behind the award is to acknowledge those who not only achieve financial success but also work to improve the world around them.
Dr. J.C. Chaudhry Excellence Award 2025 honours leaders who exemplify dedication to sustainable and socially responsible business practices. It honours individuals and organisations that demonstrate how success and responsibility can move together. The goal is to identify those who utilise creativity and effective management to make a tangible difference, whether through greener business models, inclusive employment practices, or community upliftment programmes.
Apart from recognition, the award seeks to encourage others to follow similar paths — to innovate responsibly, to lead ethically, and to place human welfare at the core of business decisions. It hopes to inspire a new generation of entrepreneurs who value longterm good over short-term gain. By setting this standard, the award reinforces that true excellence is built on fairness, honesty, and a sense of shared progress.
The selection process for Dr. J.C. Chaudhry Excellence Awards is thorough and transparent. Nominees are assessed across several dimensions, such as their contribution to environmental and social sustainability, their efforts in community development, and their adherence to ethical governance. Each contender must show a genuine commitment to making the world better through their work, not merely through compliance and publicity.






Those chosen for the honour are leaders who have brought about real, measurable change, whether by empowering their teams, supporting social causes, or leading innovative initiatives that help society grow. Their achievements show that business can be both successful and kind, ambitious and ethical, modern yet mindful.
In celebrating them, the award also upholds the legacy of Dr. J.C. Chaudhry, a man who proved that leadership is not about authority, but about influence rooted in purpose. Dr. J.C. Chaudhry Excellence Awards 2025 serve as a call to today’s leaders to redefine what success truly means: to grow, to uplift, and to leave a world better than they found it.
H.E. Mr. Benedikt Hoskuldsson, Ambassador of Iceland to India, was honoured with the Diplomatic Excellence Award for his dedication to strengthening bilateral relations, promoting sustainable initiatives, and promoting cultural and economic collaboration between the two nations.
H.E. Ms. Stella Nkomo, Ambassador of Zimbabwe to India, earned the Diplomatic Excellence Award for her outstanding role in promoting trade and investment partnerships. By aligning diplomatic initiatives with Zimbabwe’s Vision 2030, she has strengthened economic cooperation, promoted growth opportunities, and advanced projects that benefit both nations.
H.E. Mr. Mariano Agustin Caucino, Ambassador of Argentina to India, was conferred the Diplomatic Excellence Award for strengthening bilateral relations during the 75th anniversary of Argentina-India ties. He is also known for advancing trade, agricultural cooperation, education, and technology exchanges, promoting cultural and sporting connections, and promoting collaboration in multilateral forums.
H.E. Prof. Joyce Kakuramatsi Kikafunda, High Commissioner of Uganda to India, received the Diplomatic Excellence Award for pioneering Uganda’s first Department of Food Science and Technology and leading research that reduced childhood malnutrition in Western Uganda from 21% to 11%. A global awardee and advocate for women’s education, she is hailed as Uganda’s “mother of food science and nutrition.”
H.E. Ms. Aishath Azeema, High Commissioner of the Maldives to India, was honoured with the Diplomatic Excellence

Award for her illustrious diplomatic career spanning over three decades. She served as Ambassador to China and held key roles across the Maldives Foreign Service, strengthening bilateral relations, advancing trade diplomacy, and shaping the nation’s foreign policy.
H.E. Dr. Nawab Mir Nasir Ali Khan, Honorary Consul of the Republic of Kazakhstan in Hyderabad for Telangana and Andhra Pradesh, also received the Diplomatic Excellence Award for his visionary leadership in sustainable real estate. As Managing Director of MAK Projects, he pioneered eco-friendly developments, such as the award-winning Canadian Wood Villa, advancing green construction and environmental conservation in India’s infrastructure sector.
H.E. Mrs. Anisa Kapufi Mbega, High Commissioner of the United Republic of Tanzania to India, with concurrent accreditation to Singapore, Sri Lanka, Nepal, and Bangladesh, received the Diplomatic Excellence Award for her exemplary diplomatic service. With over two decades in foreign affairs, she has advanced
Tanzania’s global partnerships and diaspora engagement with distinction and dedication.
H.E. Dr. Arshi Ayub Mohamed Zaveri, Senior Advisor at the Private Office of H.H. Sheikh Mohamed Bin Sultan Al Nahyan, UAE Royal Family, and CEO of Trust With Trade Group, was conferred the Viksit Bharat Commitment Award for her global leadership in business, sustainability, and women’s empowerment. A multi-awardwinning entrepreneur, she champions innovation, impact investing, and inclusive growth.
Dr. Nawab Shafi Ul Mulk, President of Mulk Healthcare Enterprises, was honoured with the Viksit Bharat Commitment Award for his visionary leadership in digital health. Through Mulk Med’s pioneering virtual hospital model, he has revolutionised teleradiology and telehealth, besides expanding access to quality healthcare across regions and communities.
Dr. Ruma Devi, Entrepreneur and Philanthropist from Barmer, Rajasthan, received the Women Empowerment Award for transforming the lives of over 22,000 women artisans through GVCS. From humble beginnings, she rose to national acclaim as a designer, social reformer, and Nari Shakti Award recipient, inspiring women across India.
Ms. Ishika Taneja, Miss World Tourism 2017, was honoured with the AsiaOne Women Empowerment Principles Leadership Award 2025 for her achievements in pageantry,
entrepreneurship, and advocacy. Celebrated for empowering women globally, she continues to inspire through her leadership in the beauty and wellness sector and her international accomplishments.
Smt. Deepa Malik, South Asian Representative of the Asian Paralympic Committee and India’s first female Paralympic medallist, received the Viksit Bharat Commitment Award for her exceptional leadership in sports inclusion, disability advocacy, and women’s empowerment, inspiring a progressive and inclusive vision for Bharat.
Mr. Surender Pal Singh Saluja, Chairman and Whole-Time Director of Premier Energies, was honoured with the Person of the Year 2025 Award for his visionary leadership in India’s renewable energy sector. Under his guidance, Premier Energies became a leading solar solutions provider, advancing sustainability, innovation, and the nation’s energy independence.
Ms. Nayla Al Khaja, Director and Producer from the United Arab Emirates, received the Black Swan Style Icon of the Year 2025 Award. As the nation’s first female film director, she has redefined Emirati cinema, blending cultural depth with global storytelling and inspiring women in creative industries.
Mr. Omar Al-Humaidi, Director, Department of Anti-Injurious Economic Practices, Ministry of Economy, Government of UAE, was honoured as Guest of Honour for


his leadership in promoting fair economic practices. With a strong foundation in business management, he exemplifies excellence in policy planning and sustainable economic development.
Dr. Arshi Ayub Mohamed Zaveri, CEO of Trust with Trade Group and Senior Advisor to Private Office of HH Sheikh Mohamed Bin Sultan Al Nahyan, the UAE Royal Family, received the Women Empowerment Award for her outstanding leadership and global advocacy. A visionary entrepreneur and humanitarian, she has inspired women worldwide through innovative leadership, diplomacy, and inclusive growth.
Ms. Fatima Al Taei, Emirati actress and a prominent figure in the UAE film industry, was conferred the Women Empowerment Award for her remarkable contributions to cinema. From her pioneering roles to championing local storytelling, she has inspired women across the UAE to pursue their artistic passions.
Ms. Zainab Al-Eqabi, Content Creator and Speaker from Dubai, was honoured with the Women’s Empowerment Award for advocating disability rights and women’s empowerment. Overcoming life-changing challenges, she has inspired many through her motivational talks, social media content, and dedication to community development and social impact.
Ms. Habiba Al Marashi, Co-founder and Chairperson of Emirates Environmental Group (EEG), received the Women

Empowerment Award for advancing sustainability and corporate responsibility across the UAE and MENA region. A pioneering environmentalist and leader, she founded Arabia CSR Network and coestablished the Emirates Green Building Council.
Ms. Taim Al Falasi, Entrepreneur and Social Media Influencer from the UAE, was honoured with the Women Empowerment Award for redefining digital influence. With millions of followers, she has inspired audiences through lifestyle, fashion, and travel content, building a pioneering career as a creator, media personality, and innovator.
Ms. Mariam Alblooshi, Director of the Department of People of Determination, Community Development Authority, Dubai, was conferred the Women Empowerment Award for advancing care, rehabilitation, and inclusion for people of determination. Her leadership spans psychology, program management, and improving the quality of life across Dubai.
Ms. Chanel Ayan, Dubai’s first Black supermodel, founder of Ayan Beauty, and star of The Real Housewives of Dubai, was honoured with the Women’s Empowerment Award. Balancing motherhood, business, and the launch of a beauty brand, she inspires with elegance, resilience, and trailblazing success in fashion and entrepreneurship.
Mr. A.R. Srinivasan, CEO of Dubai National Insurance, was honoured with the World’s
Greatest Leaders Award 2025, while DNI received the World’s Greatest Brands 2025 recognition. His visionary leadership and business strategies have helped elevate the company through innovative insurance solutions and exceptional client service.
Mr. Ismail Al Hammadi, Founder and CEO of Ruwad Real Estate & Biznet Consulting, was honoured with the World’s Greatest Leaders Award, while Biznet Consulting received the World’s Greatest Brands 2025 recognition. With 28 years in Dubai’s real estate sector, he excels as an entrepreneur, advisor, and industry leader.
Dr. J.C. Chaudhry Excellence Awards 2025 highlights that leadership is not merely about scaling profits but about touching lives, inspiring minds, and building a legacy founded on purpose. The event beautifully reflected Dr. Chaudhry’s belief that true success blossoms when intellect is driven by intuition and ambition is balanced with empathy.
As the evening celebrated extraordinary individuals from diverse walks of life, it highlighted one simple truth that greatness lies in using one’s influence for the greater good. Each awardee, in their own way, echoed Dr. Chaudhry’s philosophy that progress must be human-centred and that business, at its best, is a driver of positive transformation.

India has made history by clinching the inaugural Blind Women’s T20 World Cup title, marking a landmark achievement in the rise of inclusive sports. The Indian visually impaired women’s cricket team delivered a powerful performance throughout the tournament, displaying remarkable skill, resilience, and teamwork to secure the coveted championship. The final match was a testament to India’s dominance and preparation, as the team outplayed its opponent with disciplined bowling, sharp fielding, and confident batting. Players exhibited exceptional coordination and situational awareness—qualities that have been honed through years of dedicated training and strong grassroots support for blind cricket in the country.

India’s journey to the title saw consistent victories in the group stages and impressive displays of grit during the knockout rounds. Coaches praised the team’s strategic approach and commitment to excellence, highlighting their ability to overcome challenges and maintain focus under pressure. The victory holds profound significance beyond the sporting field. It shines a spotlight on the capabilities of visually impaired athletes and underscores India’s commitment to fostering inclusivity in sports.
Organisations supporting blind cricket have also lauded the achievement as a catalyst for greater public attention, improved infrastructure, and increased opportunities for athletes with disabilities. This historic triumph has inspired millions across the nation.
India and France have taken a significant step forward in bilateral defence cooperation with a landmark agreement to jointly produce HAMMER precision-guided munitions on Indian soil. The deal marks a major milestone in India’s pursuit of defence indigenisation under the ‘Make in India’ and ‘Atmanirbhar Bharat’ initiatives, while also

strengthening the long-standing strategic partnership between the two nations. The High Accuracy Modular Munition Extended Range (HAMMER) is a next-generation smart weapon known for its precision strike capabilities, adaptability across platforms, and effectiveness in contested environments. Originally developed by France’s Safran Group, it has been widely recognised for enhancing the operational capabilities of modern fighter aircraft. Under this setup, India will not only procure these weapons but also participate in their local manufacturing, enabling technology transfer and boosting domestic defence production.




India, Australia, and Canada have jointly launched the ACITI Partnership—an ambitious trilateral initiative aimed at advancing cooperation in technology, innovation, and critical industries. The newly formed alliance underscores the growing strategic alignment among the three democracies as they work to strengthen resilient supply chains, boost technological collaboration, and promote sustainable economic development across the Indo-Pacific region. The ACITI Partnership—representing Advanced Critical Industries and Technology Initiative—focuses on areas such as artificial intelligence, cybersecurity, clean energy, semiconductor manufacturing,
Oman has achieved a historic milestone with the successful launch of OmanSat-1, the nation’s first communications satellite, marking a significant advancement in its technological and space ambitions. The satellite, developed as part of Oman’s long-term vision for digital transformation and strategic infrastructure development, positions the Sultanate among the growing list of nations investing in space-based communication capabilities. OmanSat-1 is designed to enhance national telecommunications, strengthen broadband connectivity, and support secure communication networks across the country. By providing improved bandwidth and expanded coverage, the satellite is expected to benefit key sectors including education,
healthcare, defence, media, and disaster management. Officials emphasise that the launch reflects Oman’s commitment to building resilient digital ecosystems aligned with its Vision 2040 goals. The project was executed in collaboration with leading international aerospace partners, ensuring access to cutting-edge satellite technology and advanced operational expertise. Following its deployment into orbit, OmanSat-1 will undergo a series of calibration and testing phases before becoming fully operational. The launch is being celebrated as a defining moment in Oman’s scientific and technological progression. It opens new avenues for research, innovation, and space-sector employment while inspiring a new generation of Omani engineers and students.
digital infrastructure, and defence technologies. It seeks to combine the technical expertise, research capabilities, and industrial strengths of all three nations to create a framework that supports innovation-driven growth. Officials emphasise that the partnership is designed to ensure a secure and transparent technological ecosystem, reducing overdependence on single-source supply chains and fostering shared standards for emerging technologies. Joint research programs, university collaborations, and industrial partnerships will form the backbone of the initiative, encouraging cross-border knowledge exchange and co-development opportunities.

India has once again stamped its dominance on the global kabaddi stage by clinching the Women’s Kabaddi World Cup title, reaffirming its status as the undisputed powerhouse of the sport. The Indian team delivered a commanding performance throughout the tournament, blending strength, agility, strategy, and teamwork to secure yet another championship trophy.
The final match showcased India’s exceptional control of the game, as the team outperformed its opponent with swift raids, impenetrable defence, and tactical brilliance. Analysts praised the team’s balanced combination of experienced players and rising stars, all of whom contributed to a cohesive
unit capable of handling high-pressure moments with composure and confidence. India’s journey to the title was marked by a flawless campaign, including decisive wins in the group stages and hard-fought victories in the knockout rounds. Coaches credited the team’s rigorous preparation, advanced fitness training, and evolving analytical approaches for their consistent success at the international level. This triumph also highlights the growing popularity and professionalisation of women’s kabaddi in India. Increased grassroots participation, improved sports infrastructure, and expanded support from national federations have propelled female athletes to greater competitive heights.

Lary Page, the co-founder of Google and one of the most influential figures in modern technology, has officially become the world’s second-richest person, marking a significant milestone in the global financial landscape. His rise in the billionaire rankings comes on the back of a sharp surge in Alphabet’s market valuation, driven by strong performance in artificial intelligence, cloud computing, and diversified digital services. Page’s wealth has seen
a substantial increase as investor confidence in Alphabet continues to grow. Analysts cite the company’s aggressive AI roadmap, advanced search technologies, and enterprise AI solutions—as a key contributor to its soaring stock price. With higher global interest in AI, it’s strategic leadership has placed Page at the forefront of the world’s technological and economic evolution. Beyond financial metrics, Page’s ascent highlights his long-term approach to innovation.

Fatima Bosch has brought global pride to Mexico by winning the Miss Universe 2025 title, marking a historic moment for the nation on one of the world’s most celebrated pageant stages. Her victory has sparked celebration across Mexico, as millions applaud her grace, intelligence, and compelling advocacy, which stood out throughout the competition. Bosch impressed judges from the outset with her confidence, eloquence, and culturally rich presentation. Her national costume, inspired by Mexico’s vibrant artistic heritage, earned widespread acclaim for its originality and symbolic depth. Throughout the competition, she showcased a unique blend of charm, discipline, and social awareness—qualities that set her apart from contestants representing over 90 nations. A central pillar of Bosch’s Miss Universe journey was
her advocacy for youth empowerment and educational access in underserved communities. In interviews and public forums, she spoke passionately about breaking socio-economic barriers and using global platforms to amplify voices that often go unheard. Her message resonated deeply with both the judges and audiences worldwide. Her crowning moment was met with emotional cheers, as she expressed gratitude to her family, her country, and the global community that supported her journey. Her achievement signals a proud chapter in Mexico’s pageant history, reaffirming the country’s stature in the international beauty and cultural landscape. As Miss Universe 2025, Fatima Bosch is expected to lead global humanitarian initiatives, inspire young women across continents, and continue representing Mexico with dignity, pride, and purpose on the world stage.

TRANSPARENCY
INNOVATION
SUSTAINABILITY
TEAM WORK
RELIABILITY
QUALITY
Emperium: A Legacy of Excellence
ACCOUNTABILITY
COMMITMENT
CONSISTENCY
ACCESSIBILITY
RESPECT
Since its inception in 2015, Emperium has established itself as a trusted and reliable real estate developer, renowned for its commitment to delivering projects before time and exceeding expectations. Our core values of professionalism, integrity, expertise, transparency, accountability, and customer-centricity serve as the foundation for our success. Emperium has transformed the real estate market in Panipat, delivering outstanding returns for its partners and investors. With ambitious plans for pan-India expansion and new projects in Gurugram and Yamunanagar, Emperium is set to become a prominent name in the industry.


Aonishiki Arata has made history by becoming the first Ukrainian ever to win an official sumo tournament, marking a monumental moment for both the athlete and the global sumo community. His landmark victory not only breaks cultural and geographical barriers within the ancient Japanese sport but also highlights sumo’s growing international appeal.
Arata showcased exceptional strength, discipline, and technique throughout the tournament, defeating seasoned rikishi with a combination of calculated strategy and remarkable agility. Spectators praised his composure on the dohyo,
noting his ability to read opponents’ movements and execute decisive counterattacks. His performance demonstrated a mastery of traditional sumo skills blended with the athletic dynamism he developed through years of rigorous training.
His journey to this achievement has been one of perseverance. As a foreign wrestler in a sport deeply rooted in Japanese tradition, Arata faced unique challenges— cultural adaptation, intense training regimens, and the pressure to prove himself in a highly competitive environment. His triumph represents not only personal success but also the expanding inclusivity within professional sumo.
Indian scientists have unveiled a breakthrough AIdriven framework designed to transform the landscape of personalised cancer therapy. Developed by a consortium of researchers from leading institutes in India, the innovative system aims to tailor treatment strategies based on a patient’s unique genetic, molecular, and clinical profile, marking a significant stride toward precision oncology. The new framework leverages advanced machine learning algorithms to analyse vast datasets from tumour genomics, medical imaging, treatment histories, and real-time patient responses.
By integrating these data streams, the AI model is capable of predicting how individual patients might respond to specific therapies, including chemotherapy, immunotherapy, and targeted drug regimens. This allows oncologists to design optimised treatment plans that are more effective while reducing potential side effects. A key highlight of the initiative is its ability to decode tumour heterogeneity—one of the biggest challenges in cancer treatment. The model generates personalised tumour evolution maps, offering insights into how cancer cells may adapt or become resistant

Javokhir Sindarov has etched his name into chess history by becoming the youngest-ever champion of the FIDE World Cup, a milestone that has captivated the global chess community. The Uzbek prodigy, long regarded as one of the brightest talents of his generation, delivered a commanding performance throughout the tournament, showcasing strategic brilliance, composure under pressure, and an exceptional understanding
of complex positions. Sindarov’s journey through the championship was marked by victories over several of the world’s top grandmasters. His ability to adapt to diverse playing styles, coupled with preparation and remarkable technique, allowed him to dominate the event. Analysts have praised his innovative approach, noting how he blends classical principles with modern, dynamic play to outmaneuver seasoned opponents

to certain therapies. This empowers clinicians to plan interventions proactively rather than reactively. Moreover, the AI framework is being built with scalability in mind, making it suitable for deployment across India’s diverse healthcare ecosystem, including resourcelimited settings. Early pilot studies have shown promising results, with improved treatment
outcomes and enhanced decision-making support for oncologists. This development underscores India’s rapidly growing capabilities in artificial intelligence and biomedical research. By combining computational innovation with clinical expertise, Indian scientists are paving the way for a future where cancer treatment becomes more precise.


Imagine a journey where every place you visit sparks a bit of curiosity and a bit of wonder in you. From the rose-red ancient city of Petra in Jordan, carved into quiet desert cliffs, soar across the globe to Argentina, a land pulsing with soul. Trek beneath the jagged peaks of Patagonia, feel the thunderous roar of Iguazú Falls, and be swept up in the electric energy of Buenos Aires. Every destination has its own story to tell through its people, its landscapes, and even its food. This travel series invites you to rediscover your sense of adventure and explore some of the world’s most memorable corners that awaken the senses, stir the imagination, and leave footprints on your heart long after the journey ends

With its remarkable natural, cultural, and geographical diversity, Argentina stands out as one of the world’s most vibrant and captivating nations. Deeply influenced by indigenous traditions and enriched by generations of immigrants, it reflects heritage and modernity in a truly unique way. From trekking across towering glaciers and wandering through lush jungles to discovering historic towns and dynamic cities, Argentina offers breathtaking landscapes, immersive adventures, and a cultural richness that promises unforgettable experiences for every traveller
By H.E. Mr. Mariano Agustin Caucino Ambassador of Argentina to India
While it’s summer in India, Argentina enjoys its winter—ideal for snowfilled holidays at more than 10 exclusive winter resorts. Anyhow, Argentina is a country that can be enjoyed throughout the year, since in each season you can enjoy different activities. In summertime you can enjoy trekking in Patagonia, visiting the glaciers or visiting the beach destinations. Spring and autumn are less-crowded, with ideal temperatures in most of our destinations—ideal for creating unforgettable experiences. From whale watching and moonlit visits to the Iguazú Falls, to trekking at the End of the World, immersing in the passion of tango, and enjoying vibrant, world-class culture and cuisine— Argentina promises an exceptional journey.
Tourism is a national priority and a driving force for regional economies. Currently, more than
80 accommodation projects are underway, including new builds, expansions, and refurbishments. Among the newly launched attractions is the Solar Train in Quebrada (Jujuy), while others—such as the observation wheel in Puerto Madero (Buenos Aires)—are under construction. Additionally, efforts are being made to revitalise the port of Mar del Plata to welcome cruise ships.
In the first half of the year, Argentina welcomed 2.9 million international tourists. The country continues to establish itself as a diverse and wellrounded destination, offering a unique blend of nature, luxury, and authentic cultural experiences. Its variety and richness encourage travelers to return. To further enhance accessibility for major European markets, Argentina is actively strengthening and expanding its air connectivity.
Argentina is a country of striking contrasts. It features towering
mountains, lush rainforests, sprawling wetlands, shimmering salt flats, fertile plains, and colossal glaciers. Its landscapes are as varied as its traditions, languages, and artistic expressions. Argentina’s multicultural identity formed by Indigenous communities, Spanish heritage, European immigrants, and Latin American essence—has fostered an open, welcoming national spirit that embraces diversity. Testament to its commitment to preserving both cultural and natural legacies, Argentina is home to 12 UNESCO World Heritage Sites, reflecting centuries of history, creativity, resilience, and ecological importance.
From the cosmopolitan pulse of Buenos Aires to the timeless rhythms of the Andes and the pristine beauty of Patagonia, Argentina tells a powerful story—one that blends heritage with modernity, nature with innovation, and tradition with global vision.

In the southern reaches of Patagonia lies Argentina’s first UNESCO World Heritage Site, Los Glaciares National Park. This park is a majestic expanse of ice, rock, and pristine wilderness, capturing the dramatic geological history of the region. At its heart is the famous Perito Moreno Glacier, renowned for its rhythmic ruptures and thunderous ice collapses, a living demonstration of Patagonia’s raw power. Surrounded by the Andes, the park is a land of towering ice walls, turquoise lakes, and forests that shimmer in shades of emerald and gold.
Visitors can walk along elevated platforms that offer breathtaking views, sail among floating icebergs, or explore the scenic Route of the Seven Lakes, where every turn reveals untouched natural beauty. Life here moves to nature’s rhythm, and a visit to Los Glaciares is an immersion into the wilderness that has shaped Argentina’s identity.
In the subtropical north lies the Iguazú National Park, another natural marvel. Taller than Niagara and wider than Victoria, these 275 cascading waterfalls emerge from dense rainforest. Mist rises like incense, rainbows arc across the sky, and the thunderous roar of the Devil’s Throat reminds visitors of nature’s unrivaled power.
Winding paths lead through dense rainforest, where toucans, butterflies, capuchin monkeys, and coatis make frequent appearances. The eco-train carries travellers through the verdant forest, while thrill-seekers can get up close to the falls in small boats. Iguazú highlights the rich biodiversity of Argentina’s Litoral region, showing how water, rainforest and ancient geological forces have come together to create a powerful natural spectacle for visitors around the world.
“ARGENTINA
In Santa Cruz Province, Southern Argentina lies a site that connects visitors to humanity’s distant past— Cueva de las Manos, or “Cave of Hands.” The walls are covered with stencilled handprints, hunting scenes, and geometric motifs created more than 9,000 years ago. Many of the handprints belong to young people, offering a haunting glimpse into the lives of ancient hunter-gatherers.
Set in a rugged canyon carved by the Pinturas River, this cave is a UNESCO World Heritage Site that highlights Argentina’s commitment to preserving its archaeological treasures and the stories of prehistoric cultures.
Patagonia, the Region of Giants, reveals its wonders at Península Valdés, a sanctuary for marine life. Recognised by UNESCO for its exceptional wildlife, this peninsula is home to southern right whales, orcas, elephant seals, sea lions, and large colonies of Magellanic penguins. Winds from the Atlantic sweep over its cliffs, sandy beaches, and salt flats, while whales breach offshore and orcas hunt along the shore. Visitors here witness nature’s dramatic cycles in action, a reminder of the richness of Argentina’s marine ecosystems.
At the centre of the country lies Córdoba, a province known for its rolling hills, pristine rivers, and one of Argentina’s most vital historical sites: the Jesuit Block and Estancias. Constructed in the 17th century, these buildings hosted one of the oldest universities in the Americas and served as centers of education, agriculture, and cultural exchange. The Estancias—Caroya, Jesús María, Santa Catalina, La Candelaria, and Alta Gracia—tell the story of Jesuit
FOR EVERY TRAVELLER”

influence on education, architecture, and regional development.
Local traditions thrive here, from festivals to folklore, and even the region’s famous Fernet-with-Cola drink reflects Córdoba’s unique cultural identity.
Further west, the provinces of San Juan and La Rioja present an otherworldly landscape known as Ischigualasto–Talampaya Natural Parks, or “The Moon Valley.” These deep red cliffs and eroded rock formations have preserved some of the oldest dinosaur fossils ever discovered. Walking through this region feels like traveling back millions of years. Rugged canyons, silent deserts, and natural sculptures shaped by wind and water reveal Earth’s earliest chapters—a UNESCO-recognised cradle of paleontological knowledge.


In Argentina’s northwest, the Andean world unfolds dramatically along the Quebrada de Humahuaca, a narrow mountain valley lined with centuriesold villages. Inhabited for over 10,000 years, this UNESCO site is a living cultural corridor used by Indigenous peoples, Inca caravans, colonial traders, and modern travelers.
The valley’s colors defy imagination: the Seven Colors Hill in Purmamarca, the ancient fortress of the Pucará de Tilcara, and crystalline salt flats of Salinas Grandes create surreal backdrops. Traditions such as the Pachamama celebration, Andean music, and the Carnaval of the North preserve the living spirit of Argentina’s Indigenous heritage.
Threading through Argentina from north to west is the monumental
Qhapaq Ñan, the great Inca road system spanning six countries. In Argentina, this UNESCO site connects high-altitude deserts, valleys, and strategic Andean passes. Along these ancient paths lies the Inca Bridge in Mendoza, a natural formation once used along this vast network.
The road system reflects a sophisticated Andean civilization that built trade, communication, and ceremonial routes across impossible terrain. Today, it offers a window into indigenous engineering brilliance and cross-continental cultural exchanges.
In La Plata city stands the Curutchet House, a UNESCO-listed work designed by the legendary architect Le Corbusier. The house embodies modernist principles with natural light, innovative terraces, ramps, and geometric forms, adapted seamlessly to an Argentine context. It is a symbol
of the country’s openness to global artistic movements and its ability to merge international creativity with local culture.
Patagonia reveals yet another wonder in Los Alerces National Park, a UNESCO site safeguarding ancient larch forests. Among these towering trees lives “El Abuelo,” one of the oldest trees on Earth, estimated to be over 2,600 years old. Glacial lakes, crystalline rivers, and dense forests make Los Alerces one of South America’s most pristine ecosystems. This protected reserve reflects Argentina’s dedication to preserving biodiversity and combating climate change.
In the Litoral region, Argentina shares with Brazil and Paraguay the UNESCO-recognized Jesuit Missions of the Guaraní, including San Ignacio Miní, a site that preserves red-stone ruins of Indigenous-Jesuit collaboration. These missions reveal a unique social and cultural model where European religious structures integrated with Indigenous Guaraní knowledge, agricultural practices, and music.
Argentina’s heritage is not confined to monuments or landscapes; it lives in its people, traditions, and the harmonious coexistence of cultures. With 12 UNESCO World Heritage Sites, the nation demonstrates its commitment to preserving its natural ecosystems as well as historical legacies. It is a country where history, geography, and culture intertwine to create one of the world’s most compelling destinations. Argentina is an experiential destination that must be lived to truly appreciate its authenticity. On the Visit Argentina website, agents can access key resources to support their sales, ranging from maps, images, and audiovisual content to a dedicated section for travel professionals that include training materials.


Discover Jordan's charm through its ancient archaeological sites like the UNESCO World Heritage city of Petra and the Roman ruins of Jerash, its natural wonders including the Dead Sea and the Wadi Rum desert, and its rich culture. Come and experience unique activities like floating in the Dead Sea, camping in Wadi Rum to connect with Bedouin culture, and exploring diverse landscapes that range from mountains to the Red Sea
By H.E. Mr. Yousef Mustafa Ali Abdel Ghani, the Ambassador of the Hashemite Kingdom of Jordan to India

Jordan, a country steeped in history, culture, and natural beauty, offers countless historical attractions and experiences that cater to diverse interests. Here are the key attractions, natural wonders and cultural experiences that tourists should not miss when visiting Jordan:
1. Petra: A world wonder and UNESCO World Heritage Site, it is an extraordinary ancient city carved into towering sandstone cliffs. Its stunning rock-cut architecture and the climb of over 900 steps offer unforgettable views of its most iconic and majestic landmarks.
2. Amman: The capital of Jordan, is a fascinating city of contracts ideally situated on a hilly area between the desert and fertile Jordan Valley. The city is an ideal family location, also offering plenty of lively night life, cultural and theatrical events and an extensive range of restaurants.
3. Jerash: An ancient Roman city, one of the best-preserved in the Middle East. The city’s golden age came under Roman rule. Jerash reveals paved and colonnaded streets, soaring hilltop temples, handsome theatres and city walls pierced by towers and gates.
4. Umm Qais: An ancient Roman city with stunning views of the Golan Heights.
5. Madaba: A town famous for its Byzantine-era mosaics and historic sites and has Archaeological Park, Museums and churches.
6. Biblical Jordan: Biblical Jordan, also known as the Holy Land, is a region that holds great spiritual significance for Jews, Christians, and Muslims. The country of Jordan is home to numerous biblical sites. Baptism site/ Bethany, where Jesus was baptized by John the Baptist in the river of Jordan. This
land is where God first manifested himself to man. The other sites that visitors can visit in Biblical Jordan are Mount Nebo, Hill of Elijah, Mukawir, Anjara, Umm Ar- Rasas, Lot’s Cave, Umm Al-jimal and Tabaqat Fahl are well-known sites in Biblical Jordan.
1. Wadi Rum: A breathtaking desert valley known for its unique landscapes and Bedouin culture and tourists can enjoy various activities such as camel ride, aero sport activities and also experience a breathtaking view of natural rock formation from a hot air balloon.
2. Dead Sea: The lowest point on Earth, famous for its therapeutic waters and stunning scenery. Relax in the gently lapping waters and be amazed that you can’t sink! It is the largest natural spa on the earth that gives you a soothing massage and the well-known healing powers of minerals from the sea’s muddy floor that treat many skin diseases.
3. Aqaba: A coastal city with pristine beaches, coral reefs, and a rich history. Contrasting the rose -coloured desert to the north, the indigo- coloured deep water lies just off the shore in Aqaba. As in Aqaba tourists can explore scuba diving, Aqaba Marine Science Station, Birds Observatory, Archaeological Museum and Aqaba Fort.
4. Azraq Wetland Reserve: Azraq is a unique wetland oasis located in the heart of the semiarid Jordanian Eastern Desert, one of a number of beautiful nature reserves. Its attractions include several natural and ancient built pools, a seasonally flooded marshland, and a large mudflat known as Qa’a Al-Azraq.
5. Mujib Nature Reserve: The Mujib Nature Reserve in Jordan is a true natural wonder. Located in the Dead Sea Region, it's the lowest

nature reserve in the world, with its spectacular array of scenery near the east coast of the Dead Sea. Mujib has five major trails, three river trails and two dry land trails and visitors can explore the reserve through various hiking trails, including the Siq Trail, Canyon Trail, Malaqi Trail, and Ibex Trail. These trails offer breathtaking views of the canyon and the surrounding landscape. The reserve is also an important stopover for migratory birds, making it a paradise for birdwatchers. Its unique landscape and biodiversity make it a truly unforgettable experience.
6. Dana Biosphere Reserve: The Dana Biosphere Reserve is a world of natural treasures covering 208 sq km. A chain of valleys and mountains extending from top of the Jordan Rift valley down to the desert lowlands of Wadi Araba, the Reserve contains a remarkable diversity of landscape. There are several hiking trails that interest both casual and dedicated hikers.

1. Bedouin Hospitality: Experience traditional Bedouin culture by staying in a camp or sharing a meal with a local family.
2. Henna Night: Participate in a traditional henna ceremony, a significant part of Jordanian weddings.
3. Arabic Coffee and Tea: Learn about the importance of coffee and tea in Jordanian culture and enjoy a traditional coffee or tea ceremony.
4. Local Cuisine: Savor traditional Jordanian dishes like mansaf, kebabs, and falafel.
1. Jerash Festival: A cultural festival celebrating music, dance, and theatre in the ancient city of Jerash.
2. Aqaba Festival: A festival showcasing Aqaba's rich history, culture, and natural beauty.
3. Amman International Film Festival: A festival featuring a diverse selection of local and international films.
These are just a few of the many
attractions and experiences that Jordan has to offer. Whether you're interested in history, culture, nature, or adventure, Jordan is a destination that is sure to captivate and inspire.
For centuries Jordan has been a bridge between Europe, Asia and The Middle East. This influx and mixing of people over the centuries have contributed to a diverse food culture. Many vegetarian dishes, such as hummus, baba ghanoush, tabbouleh, falafel and all share the same Arabic and Mediterranean culinary roots.
The traditional Jordanian breakfast is a bowl of hot fuul (boiled fava beans mashed with lemon juice, olive oil and chopped chilis), and mopped up with fresh-baked pita.
And humus which is made from ground chickpeas and Tahini decorated with olive oil and Sumac and mixed with lemon juice.
The staple street snack in the Middle East is falafel, small balls of a spiced chickpea paste deep-fried and served stuffed into pita, along with some salad, tahini, and optional hot sauce. Up and down the country you’ll also find shawarma stands.
Jordanian cuisine relies heavily on fresh, seasonal ingredients, particularly vegetables, herbs& Spicesas Za’atar (a blend of herbs and spices), sumac, garlic, onion, tomato sauce, and lemon are common Flavors, olives, olive oil, dates and fruits which mainly rich in vegetarian diet. Visitors can indulge in a variety of traditional dishes. These culinary delights offer a glimpse into Jordan's rich cultural heritage and are a must-try for any visitor such as:
Mansaf: The national dish of Jordan, Mansaf is a hearty meal consisting of lamb cooked in a sauce made from fermented dried yogurt (jameed), served over rice or bulgur.
Maqluba: Meaning "upside-down," Maqluba is a dish where rice, vegetables (like potatoes and eggplant), and meat (lamb or chicken) are cooked together and then flipped over onto a plate.
Zarb: A Bedouin dish cooked slowly in an underground pit, often featuring lamb, goat, or chicken with rice and
root vegetables.
Knafeh: A sweet pastry dessert, often made with layers of crispy pastry, cheese, and soaked in syrup.
Adventure Tourism in Jordan: Desert Safaris, Rock Climbing and Diving in the Red Sea
Jordan offers varied adventure tourism activities that cater to different interests and skill levels. Desert Safaris in Wadi Rum allow visitors to explore the majestic sandstone landscapes by camel, horse, or 4x4 vehicle. Rock Climbing enthusiasts can tackle the challenging routes in Wadi Rum, while Diving and Snorkeling in the Red Sea, off the coast of Aqaba, provide a glimpse into the vibrant marine life. Other popular activities include:
Jordan offers a thrilling mix of adventure and history. Visitors can hike stunning routes like the Jordan Trail or trek across the dramatic landscapes of Wadi Rum. Canyoning, rock climbing, camel and horse riding add to the excitement, while Aqaba’s Red Sea invites snorkeling and scuba diving amid vibrant marine life. Paragliding and skydiving provide breathtaking aerial views of the country’s beauty. Alongside these adventures, Jordan’s ancient historical sites draw history lovers from across the globe.
Jordan effectively showcases its rich historical legacy, especially at iconic sites like Petra and Jerash, to draw history enthusiasts from across the world. The country focuses on preserving and restoring ancient structures to maintain their authenticity, while expert-guided tours offer deeper insights into their cultural and archaeological importance. Cultural events, festivals, and historical reenactments bring the past alive for visitors. Through digital storytelling using Virtual Reality and Augmented Reality, Jordan recreates ancient civilisations in an engaging way. International collaborations with museums and research institutions further amplify its heritage, strengthening Jordan’s reputation as a leading cultural and historical destination.



SHRI H.D. KUMARASWAMY
UNION MINISTER FOR STEEL & HEAVY INDUSTRIES
A Member of Parliament since 1996 and fivetime MLA, Shri H. D. Kumaraswamy represents Karnataka’s Mandya constituency. Having previously served as Karnataka’s CM & Minister of Public Works, he has brought in massive developmental initiatives in his areas. As Union Minister for Steel & Heavy Industries, he is driving a historic shift in steel & electric mobility. Under his leadership, India is promoting green and specialty steel production and speeding up electric vehicle adoption
BY RICHA SANG
Q: Hon’ble Minister Sir, the rapidly expanding EV sector of India is a crucial component for achieving the Hon’ble PM’s vision for a Viksit Bharat by 2047. Under your visionary leadership, how is the Ministry of Heavy Industries giving a boost to the sector?
A. Under the leadership of Hon’ble Prime Minister Shri Narendra Modi avaru, India is steadily advancing towards self-reliance and achieving Net-Zero emissions, with the EV sector playing a key role. Alongside our focus on solar, wind, and other renewable energy sources, the government is committed to accelerating clean mobility by promoting EV adoption across the automobile industry. The Ministry of Heavy Industries (MHI) is spearheading this transition through key initiatives such as the PLI for Advanced Chemistry Cell (ACC), PLI for Automobiles and Auto Components, Payment Security Mechanism scheme, and PM-eDRIVE scheme.
1. The PLI Scheme for ACC promotes domestic manufacturing of advanced battery technologies, with 30 GWh capacity already awarded under two tranches and a total outlay of over ₹18,000 crore. Indigenous production is set to begin soon, potentially saving ₹2–2.5 lakh crore in oil imports while boosting renewables in the national grid.
2. The PLI Scheme for Automobiles and Auto Components, with an outlay of ₹25,938 crore, supports both demandand supply-side adoption of EVs. Over a five-year period, it is projected to attract
SHRI H.D. KUMARASWAMY
investments of ₹42,500 crore, generate 1,48,147 jobs, and achieve incremental sales of ₹2,31,500 crore.
3. The PM-eDRIVE Scheme, launched after the successful implementation of FAME I & II, aims to accelerate EV adoption across segments with an outlay of ₹10,900 crore over two years. It supports 24.79 lakh electric two-wheelers, 3.16 lakh electric threewheelers, 14,028 eBuses, and dedicated allocations of ₹500 crore each for electric ambulances and trucks. To address range anxiety, ₹2,000 crore is earmarked for public charging infrastructure, targeting installation of over 22,100 fast chargers for e-4Ws, 1,800 for e-buses, and 48,400 for e-2Ws and e-3Ws.
4. The PM-eBus Sewa-PSM scheme, with an outlay of ₹3,435.33 crore, will support deployment of over 38,000 electric buses from FY 2024-25 to FY 2028-29.
These initiatives collectively aim to enable India to leapfrog to a cleaner, greener, and more efficient electric mobility ecosystem.
Q. Please state some of the ways in which the steel sector is contributing to India’s self-reliance goals, particularly in defence & infrastructure sectors.
A. Under the leadership of Hon’ble PM Shri Narendra Modi avaru, our steel sector has become a cornerstone of Atmanirbhar Bharat and Viksit Bharat 2047. The Government’s Production Linked Incentive (PLI) Scheme has drawn over ₹44,000 crore in investments, creating ~80,000 jobs and reducing import reliance in defence, automotive, and energy. The enhanced PLI 1.1 (Jan 2025) secured ₹17,000 crore from 25 firms, boosting CRGO steel for power infrastructure. Indian steel now drives Bharatmala, Sagarmala, metro, high-speed corridors, and border projects.
Q: India has set a target for 300 million tonnes steel production by 2030. What all strategies is your Ministry employing to secure this substantial investment?
A. India’s National Steel Policy targets 300 million tonnes by 2030, solidifying its rank as the world’s second-largest producer. The Ministry ensures raw material security, rationalises duties, promotes FTAs, and develops steel hubs like Kalinganagar and Angul. ₹11.21 lakh crore infrastructure investment and PM GatiShakti enhance demand and logistics. Defence projects, using indigenous steel under DMI&SP Policy, highlight self-reliance and sustainable growth.
Q. Sir, India’s commitment to green and clean public transportation is commendable. Could you share the roadmap for ensuring the timely delivery, operational readiness, and local manufacturing support for these electric buses, particularly from the lens of job creation and Atmanirbhar Bharat?
A. Aligned with India’s 2070 net-zero goal, the Ministry is driving green steel production through the world’s first Green Steel Taxonomy. Initiatives include hydrogen-based pilots, a National Mission on Green Steel, and a Green Steel Public Procurement Policy. SRTMI fosters innovation in advanced and cleaner steelmaking, collaborating nationally and internationally. Global partnerships in green hydrogen, CCUS, and emerging technologies strengthen sustainable practices, balancing industrial growth with environmental responsibility and positioning India as a leader in a resilient, future-ready steel sector.
Q. Under your guidance, how does the Ministry of Steel plan to address the need for a skilled workforce in both
“THE MINISTRY OF STEEL PROMOTES GREEN STEEL VIA THE PLI SCHEME FOR SPECIALTY STEEL, LINKING INCENTIVES TO LOW-EMISSION TECHNOLOGY, WHILE ENCOURAGING A CIRCULAR ECONOMY AND CLEANER PRODUCTION TECHNIQUES”

traditional and green steel manufacturing technologies?
A. Under the leadership of Hon’ble PM Shri Narendra Modi avaru, the Ministry of Steel is prioritising skilling and reskilling to build a future-ready workforce for both traditional and green steel manufacturing. Collaborations with NSDC, IITs, IISc, and industry partners are creating specialised training in hydrogen steelmaking, carbon capture, and energy-efficient technologies. Initiatives like the Green Steel Centre of Excellence, NISST, and BPNSI programs aim to prepare India’s workforce for sustainable manufacturing, green mobility, and the clean energy transition, supporting the Skill India Mission and PLI Scheme.
Q. Sir, how does your Ministry plan to

incentivise the adoption of green steel production methods among domestic steelmakers? Kindly elaborate on the key initiatives undertaken to support traditional steel manufacturers, particularly MSMEs, in adapting to these new green norms and technologies.
A. The Ministry of Steel is promoting green steel through the PLI Scheme for Specialty Steel, linking incentives to low-emission technology adoption. It also encourages a circular economy, scrap recycling, and energy-efficient, cleaner production methods. We are supporting MSMEs and secondary producers through training, awareness programs, and easier access to green financing. The Green Steel Taxonomy sets emissions benchmarks, guiding phased adoption of green technologies while
ensuring competitiveness and a sustainable transition in the steel sector.
Q. Sir, the recently launched Green Steel Taxonomy has placed India on the global map as a pioneer in sustainable steel production. Please throw light on how this taxonomy will transform the domestic steel sector.
A. In line with the Hon’ble PM Shri Narendra Modi avaru’s vision of a sustainable and Aatmanirbhar Bharat, the Green Steel Taxonomy establishes robust, science-based standards to classify and certify low-carbon steel. By defining clear thresholds and promoting green technologies, it facilitates the creation of a credible green steel market aligned with global environmental norms.
Q. Sir, please state how your Ministry is addressing environmental/logistical challenges hindering the activation of unused Greenfield iron ore mines.
A. The Ministry of Steel, in coordination with the Ministry of Environment Forest and Climate Change, the Ministry of New & Renewable Energy, the Ministry of Mines & State Governments, is addressing environmental and logistical challenges by fast-tracking clearances, developing slurry pipelines, rail, and road networks, and promoting private sector participation in mining. Digitised single-window clearance systems are being implemented to streamline approvals, enhance transparency, and reduce transport costs.
Q. Sir, please share how is your Ministry leveraging global collaborations to bring innovation and investment to India’s steel & heavy industries sector?
A. The GoI is advancing clean energy in steelmaking through strong bilateral and multilateral partnerships. Aligned with the Hon’ble PM’s vision of a green and globally competitive industrial sector, The Ministry of Steel is fostering global collaborations to drive innovation, technology transfer, and sustainable investment, focusing on circular economy, renewable energy, green hydrogen steelmaking, CCUS, and emerging technologies. These partnerships support R&D and help transition India’s steel industry toward a cleaner and globally competitive future.
Q. Sir, given the dual challenge of decarbonisation and economic growth, how is your Ministry supporting R&D, innovation, and technology transfer in the steel and heavy industries sectors?
A. To balance decarbonisation with economic growth, we are actively promoting R&D, innovation, and technology transfer through the Steel Research & Technology Mission of India (SRTMI). It supports projects in steelmaking, technology upgradation, CCUS, and energy efficiency, collaborating with IITs, IISc, and industry partners to develop low-carbon technologies. Schemes like the PLI for Specialty Steel further encourage sustainable manufacturing, building a globally competitive steel sector in line with Atmanirbhar Bharat and green growth.

SHRI SARBANANDA SONOWAL MINISTER OF PORTS, SHIPPING & WATERWAYS
Union Minister Shri Sarbananda Sonowal, a senior BJP leader and former Assam CM, holds the key portfolios of Ports, Shipping & Waterways & AYUSH. Elected to the 18th Lok Sabha from Dibrugarh, he has transformed India’s maritime sector under PM Narendra Modi’s guidance. His leadership has doubled port capacity, reduced vessel turnaround time, boosted inland waterway cargo by 700%, and launched major transshipment hubs like Vadhavan and Galathea Bay, advancing India’s goal of becoming a global maritime superpower
BY RICHA SANG
Q. Hon’ble Minister Sir, the vision of Viksit Bharat by 2047 hinges on robust infrastructure and connectivity, especially through our maritime and inland waterways. Please share how the Ministry of Ports, Shipping & Waterways, under your stewardship, is contributing towards this national mission.
A. India’s maritime sector is advancing the vision of Viksit Bharat 2047 through initiatives like MIV 2030 and MAKV 2047, driving major growth in ports, shipping, and waterways. Major ports have nearly doubled cargo capacity, increased traffic by 47%, and improved efficiency with 50% faster turnaround and 47% higher OSBD. The Sagarmala programme, with projects worth over ₹ 5.7 lakh crore, is modernising ports and strengthening coastal and inland connectivity.
The Ministry is also developing new ports such as Vadhvan Port with an investment of INR 76,000 crore, which is set to be India’s largest deepdraft container port; it will handle over 23 million TEUs annually, effectively doubling our nation’s container handling capacity. Another important project is the Galathea Bay Transshipment Hub being developed at a cost of around INR 44,000 crore with a capacity to handle over 16 million TEUs annually. These projects are enhancing India’s maritime infrastructure and global connectivity.
Towards coastal shipping, the coastal cargo has increased significantly and has
SHRI SARBANANDA SONOWAL
shown an increase of more than 2.2 times in the last decade.
Cargo movement through inland waterways has increased from 18 million tonnes in 2013–14 to 146 million tonnes in 2024–25, registering a remarkable 700% growth. Targets are set at 200 million tonnes by 2030 and 500 million by 2047, supported by Blue Economy initiatives, revitalised river routes, crossborder trade corridors, and multimodal logistics integration.
Launched in December 2024, the Jalvahak Scheme promotes cargo movement on National Waterways—NW1, NW-2 and NW-16—offering up to 35% reimbursement for transport over 300 km. Under MAKV 2047, India aims to be among the top 10 in ship ownership and shipbuilding by 2030, and top 5 by 2047. The ₹ 25,000 crore Maritime Development Fund supports long-term financing, with 49% from the Government and the rest from ports and private players.
SBFAP 2.0, the successor to the Shipbuilding Financial Assistance Policy (expiring 2026), provides direct financial subsidies to help Indian shipyards overcome operational cost disadvantages compared to foreign yards with government support. It aims to ensure full utilisation of India’s existing shipbuilding capacity of 400,000–500,000 GT and enable Indian buyers to procure locally. Sustainability is a core focus, with initiatives such as Harit Sagar Guidelines, Green Hydrogen Hubs, the Green Tug Transition Programme, and the Harit Nauka initiative promoting green shipping and renewable energy adoption across ports.
We are also making constant efforts to develop new maritime trade routes to reduce dependency on conventional ones. The India-Middle East-Europe Economic Corridor (IMEC) connects Indian ports
with the UAE, Saudi Arabia, Israel, and Europe, while the International NorthSouth Transport Corridor (INSTC) links India with Central Asia, Russia, and Europe via Iran. These routes will enhance connectivity, reduce transit time and costs, and strengthen India’s global maritime position. Together, these efforts build a future-ready, competitive, and environmentally responsible maritime sector, aligned with India’s vision of a developed nation by 2047.
Q: Sir, India has significantly increased its National Waterways from 5 to 111 under your dynamic leadership. Please shed light on the strategies through which your Ministry ensures that these inland waterways are efficiently integrated into the national logistics ecosystem. What role do they play in reducing transport costs and carbon emissions?
A: India’s expansion from 5 to 111 National Waterways is transforming logistics by promoting cleaner, costeffective inland transport. Key initiatives like JMVP, PM Gati Shakti and the National Logistics Policy are improving multimodal connectivity, cutting logistics costs, and boosting regional trade efficiency to support Viksit Bharat. Key strategies include developing fairways under JMVP to maintain Least Available Depth standards on NW-1, strengthening institutional support through the IWDC and stakeholder summits, and using digital tools like CAR-D, Vessel Tracker and PANI to deliver real-time data on cargo movement, navigation and waterway infrastructure.
Green initiatives such as Harit Nauka Guidelines, hybrid electric catamarans and upcoming hydrogen-fuelled vessels are lowering carbon intensity on major National Waterways. Connectivity has
“INDIA’S PORTS ARE UNDERGOING A MAJOR TRANSFORMATION TO MATCH THE PACE OF ECONOMIC GROWTH. THE MINISTRY HAS ROLLED OUT SEVERAL REFORMS AND INNOVATION TO MAKE PORT OPERATIONS FASTER, SMARTER, AND GLOBALLY COMPETITIVE“

improved through Ro-Ro and ferry services on routes like NW-1 and NW-2, easing road congestion and boosting lastmile access. Under MIV 2030 and MAKV 2047, the Ministry aims to raise Inland Water Transport’s modal share in line with India’s Net Zero commitments. IWT offers a cleaner, more economical alternative to road and rail, ideal for bulk cargo like coal, cement, grains and fertilisers, while requiring less maintenance and reducing long-term logistics costs.
Q: Given the turbulence in global trade due to conflicts and shifting geopolitical alliances, you recently emphasised the need to explore new sea routes. Please highlight the initiatives your Ministry is taking to identify and operationalise these

alternate routes to ensure uninterrupted supply chains.
A: Global uncertainties have highlighted the need for India to secure its trade routes and supply chains. To reduce dependence on vulnerable chokepoints, the Ministry is developing alternate connectivity corridors. The India-Middle East-Europe Economic Corridor (IMEC) will link Indian ports with the UAE, Saudi Arabia, Israel, and Europe, enabling cargo movement up to 40% faster than via the Suez Canal. Work on unified customs processes and digital platforms are underway to ease operations.
The International North-South Transport Corridor is strengthening India’s connectivity with Central Asia, Russia, and Europe, cutting transit time
and logistics costs significantly. India’s long-term investment in Chabahar Port supports this network. Along with IMEC and diversified imports, it builds resilient, secure, and efficient trade routes that enhance India’s economic growth and global influence.
Q: Sir, you recently highlighted the importance of enhancing foreign collaborations in India’s shipping sector. Please share how these collaborations will enhance domestic manufacturing, shipbuilding, and port operations.
A: The Union Budget 2025 of GoI is giving strong push to its maritime potential, particularly in shipbuilding. (i) The Union Budget 2025 proposes a Maritime Development Fund (MDF) to
meet the sector’s financing needs through competitive, long-term equity and debt support. With an initial corpus of about ₹ 25,000 crore, MDF will promote shipping, port-led industrialisation, maritime clusters, inland waterways and green transition. International institutions are being encouraged to invest, with the Ministry targeting ₹ 1.5 lakh crore in investments by 2030.
(ii) States including Gujarat, Maharashtra, Tamil Nadu, Andhra Pradesh and Odisha plan new shipbuilding clusters, while India is encouraging foreign shipping companies and investors to participate in these greenfield ventures.
(iii) On 4th July 2025, Cochin Shipyard Limited signed an MoU with South Korea’s HD Korea Shipbuilding & Offshore Engineering (KSOE) for long-term collaboration. The partnership focuses on joint shipbuilding opportunities in India and abroad, sharing technical expertise to meet global standards, and implementing initiatives to enhance productivity and capacity utilisation.
Q: Sir, as India races to become the world’s third-largest economy by 2029, please state the key reforms and innovations your Ministry is implementing to make Indian ports more efficient, digitally enabled, and globally competitive in terms of turnaround time and cargo handling capacity.
A: India’s ports are being modernised under Sagarmala with upgraded infrastructure, connectivity, automation, and smart port initiatives. Digital platforms and standardised processes like ONOP are boosting efficiency, reducing paperwork, and improving turnaround times. As a result, major ports have nearly doubled cargo capacity and cut TAT by about 50%, making them globally competitive. The cargo handling capacity at major ports has nearly doubled in the last decade, from 873 MTPA to 1681 MTPA, and continues to grow.
Green initiatives are also being prioritised through initiatives like Harit Sagar, renewable energy adoption, and the Green Tug Transition Programme, aiming for 60% clean energy use by 2030. Additionally, expanded PPP participation and berth mechanisation are boosting capacity, efficiency, and global competitiveness of Indian ports.

SMT SAVITRI THAKUR
UNION MINISTER OF STATE FOR WOMEN AND CHILD DEVELOPMENT OF INDIA
Smt. Savitri Thakur, a dedicated member of the BJP, was appointed as Union Minister of State for Women & Child Development in June 2024. Elected to the 18th Lok Sabha from the Dhar constituency in Madhya Pradesh, she brings a wealth of experience from her grassroots work in empowering tribal women through selfhelp groups, skill training, & socio-economic initiatives
BY RICHA SANG
Q. Ma’am, as we move towards the vision of Viksit Bharat by 2047, please state how your Ministry is working to strengthen and expand crucial programmes like Poshan 2.0 and Mission Saksham Anganwadi to ensure better nutrition, education, and care for our children?
A. POSHAN Abhiyaan, under Mission Saksham Anganwadi and POSHAN 2.0, addresses maternal and child malnutrition across all States, Union Territories, aspirational districts, North-Eastern regions, and tribal areas, ensuring children (0–6 years), pregnant and lactating women, and adolescent girls access nutrition and health services without barriers. Revised Supplementary Nutrition norms promote balanced diets with diverse nutrients, fortified rice, millets, and region-specific diet charts. Poshan Vatikas (nutrition gardens) provide locally grown fruits and vegetables. Mission Saksham Anganwadi modernises centres with improved infrastructure, trained workers, and integrated ECCE, thus promoting healthy growth, cognitive development, and overall well-being, contributing to India’s vision of Viksit Bharat 2047.
Q. Ma’am, India is working towards a women-led development model. Please share how your Ministry is collaborating with other departments like Rural Development and Panchayati Raj to support women through entrepreneurship, self-help groups, and schemes like Mission Shakti, so they can
SMT SAVITRI THAKUR
play a powerful role in building a Viksit Bharat?
A. In line with the Prime Minister’s vision of Viksit Bharat@2047 and the Government’s commitment to womenled development, the Ministry of Women and Child Development (MWCD), in collaboration with the Ministry of Skill Development and Entrepreneurship (MSDE), launched the pilot initiative NAVYA – Nurturing Aspirations through Vocational Training for Young Adolescent Girls. NAVYA targets girls aged 16–18 with at least a Class 10 qualification, providing vocational training in non-traditional job roles. Implemented across 27 districts in 19 States, including Aspirational and NorthEastern districts, the initiative focuses on reaching underserved regions and vulnerable populations. It aims to empower adolescent girls with skills, confidence, and opportunities, enabling them to become catalysts in India’s journey towards a developed, self-reliant, and inclusive future. Further, under Mission Shakti, the Ministry provides a unified framework for women’s safety, security, and empowerment through its sub-schemes Sambal (protection) and Samarthya (economic inclusion). Collaborations with the Ministry of Rural Development link women with SHGs under DAY-NRLM to promote entrepreneurship, financial inclusion, and sustainable livelihoods. Partnering with the Ministry of Panchayati Raj strengthens women’s leadership at the grassroots, fostering effective participation in local governance. These initiatives collectively create an ecosystem where women are not only beneficiaries but active drivers of India’s growth.
Q. With initiatives like Ab Koi Bahana Nahi and Nayi Chetna, your Ministry is pushing for greater community-led
participation in women’s empowerment. Please shed light on the measures being undertaken by your Ministry to engage local governance bodies like Panchayati Raj Institutions and Self-Help Groups and amplify these efforts on the ground?
A. Under the vision of Viksit Bharat@2047 and the Government’s focus on women-led development, the Ministry of Women and Child Development (MWCD) is driving community-driven empowerment through several flagship initiatives. Campaigns like “Nayi Chetna” and “Ab Koi Bahana Nahi” are mobilising Self-Help Groups (SHGs), Panchayati Raj Institutions (PRIs), and community leaders to address gender-based violence, promote women’s rights, and foster behavioural change. Nayi Chetna, implemented under the Deendayal Antyodaya Yojana – National Rural Livelihoods Mission (DAY–NRLM), has executed over nine lakh community-led activities across the country, enabling SHG women to act as gender champions in their villages. Similarly, “Ab Koi Bahana Nahi”, launched in collaboration with MoRD and UN Women, reinforces zero-tolerance for violence against women and spreads awareness of rights and support systems.
To strengthen grassroots convergence, MWCD launched Nayi Chetna 3.0, supported by an inter-ministerial advisory including the Ministry of Panchayati Raj, and inaugurated 227 new Gender Resource Centres (GRCs) across 13 States. These centres serve as local hubs for awareness, referral, and capacity building, turning community participation into a movement for women’s safety and empowerment.

“UNDER THE VISION OF VIKSIT BHARAT@2047 AND THE GOVERNMENT’S FOCUS ON WOMENLED DEVELOPMENT, THE MINISTRY OF WOMEN & CHILD DEVELOPMENT (MWCD) IS DRIVING COMMUNITY-DRIVEN EMPOWERMENT THROUGH SEVERAL FLAGSHIP INITIATIVES”
In addition to safety initiatives, the Ministry is strengthening early childhood development through the “Poshan Bhi Padhai Bhi” programme under Saksham Anganwadi and Mission Poshan 2.0, aimed at children from birth to six years. The “Navchetna” framework (birth to three years) and “Aadharshila” curriculum (three to six years) focus on holistic child development, inclusive practices for Divyang children, and empowering Anganwadi workers with knowledge and tools. Training is being delivered through a two-tier model via the Savitribai Phule National Institute of Women and Child Development, emphasising play-based, activity-oriented learning, monthly ECCE days, and community engagement through DIY toy workshops.
Under Mission Shakti, MWCD provides
a unified framework for women’s safety, security, and empowerment through schemes like Sambal (protection), Samarthya (economic inclusion), Shakti Sadan, and Nari Adalats. Women Helplines (181), One Stop Centres (OSCs), and Women Help Desks at police stations provide 24x7 support for medical, legal, counselling, and shelter needs. The Mission Shakti Portal, launched in January 2025, offers integrated access to support and rehabilitation services.
To strengthen legal protection, the Government enacted three laws – Bharatiya Nyaya Sanhita, Bharatiya Nagarik Suraksha Sanhita, and Bharatiya Sakshya Adhiniyam – effective from 1st July 2024, consolidating provisions related to crimes against women and introducing stringent penalties for gang rape, sexual assault, child exploitation, and trafficking. Through these measures, MWCD is creating an enabling ecosystem where women are not merely beneficiaries but active drivers of change, contributing meaningfully to a self-reliant, inclusive, and women-led Viksit Bharat.
Q. Ma’am, fast-track special courts and support systems play a crucial role in ensuring justice for women and children. Please share how your Ministry plans to strengthen judicial and support frameworks to create a safer and more just India by 2047?
A. The Government places the highest priority on ensuring the safety, security, and nutrition of children through legislative, institutional, and technological interventions. To safeguard children against sexual abuse and harassment, the Protection of Children from Sexual Offences (POCSO) Act, 2012, defines a child as anyone below 18 years and was amended in 2019 to introduce stringent punishments, including the death penalty, to deter perpetrators. The POCSO Rules, 2020, notified by the Ministry of Women and Child Development (MWCD), further protect children from exploitation and violence. In support of timely justice, the Department of Justice, under the Criminal Law (Amendment) Act, 2018, finalised a scheme for establishing Fast Track Special Courts (FTSCs) to expedite trials of rape and POCSO cases across India.
To address child malnutrition, the Ministry implements POSHAN Abhiyaan
under Mission Saksham Anganwadi and Poshan 2.0, ensuring universal access to nutrition and health services for children aged 0–6 years, pregnant and lactating women, and adolescent girls across all States and Union Territories. Special focus is given to vulnerable communities through convergence with initiatives like PM JANMAN for Particularly Vulnerable Tribal Groups (PVTGs) and the Dharti Aaba Janjati Gram Unnat Abhiyan (DAJGUA), which together support the construction of new Anganwadi Centres and upgradation of existing facilities in tribal-majority areas, reducing regional inequities.
The Poshan Tracker App, covering 14 lakh Anganwadi Centres and nearly 10 crore beneficiaries, is a real-time governance tool with geotagging, heat maps, migration tracking, CMAM, RCH, and UWIN integration in 24 languages, enabling continuous monitoring of stunting, wasting, and underweight for timely interventions. Additionally, the Suposhit Gram Panchayat Abhiyaan, launched by the Hon’ble PM in December 2024, identifies and rewards 1,000 Gram Panchayats for exemplary grassroots work in maternal and child nutrition, thereby promoting community-led progress and equitable nutritional outcomes across India.
Q. ’Ma’am, please share how your Ministry is addressing technological challenges such as connectivity gaps, frequent application updates, and data syncing issues, especially in remote and hilly regions, to ensure seamless implementation of Poshan Abhiyaan?
A. The Ministry of Women and Child Development is extensively leveraging technology and data through the Poshan Tracker App, which functions as a realtime governance tool covering over 14 lakh Anganwadi Centres and nearly 10 crore beneficiaries. The app captures near realtime data on growth monitoring, service delivery, attendance, and home visits, while also integrating features such as geotagging, heat maps,migration tracking, and CMAM (Community-based Management of Acute Malnutrition) modules. Integration with platforms like RCH and UWIN enables convergence of health and nutrition data. Available in 24 languages, the Tracker allows for dynamic identification of highburden pockets, continuous monitoring
of stunting, wasting. and underweight prevalence, and timely course correction by States and UTs.
Through this combined approach of universal coverage, region-specific strategies, convergence with tribal development missions, and real-time digital monitoring, the Ministry is ensuring equitable nutritional outcomes for women and children across all socio-economic and regional categories.
Q. Over-nutrition and poor dietary habits are emerging as new health concerns among Indian children. Please share some of the strategies through which your Ministry plans to promote nutritional awareness through campaigns like Poshan Pakhwada to build a ‘healthfocused environment’ for our future citizens?
A. The Ministry of Women and Child Development has revised Supplementary Nutrition, moving beyond caloriespecific guidelines to promote balanced diets emphasising diet diversity, quality protein, healthy fats, and seven essential micronutrients—Calcium, Zinc, Iron, Dietary Folate, Vitamin-A, Vitamin-B6, and Vitamin B-12. Fortified rice is supplied to Anganwadi Centres to combat anemia, and millets are included weekly in meals and take-home rations, prioritising locally available nutritious foods. Six regionwise diet charts have been developed to encourage regional diet diversity, and Poshan Vatikas ensure access to fresh fruits and vegetables while strengthening community engagement.
In 2025, the 7th Poshan Pakhwada (April 8–22) focused on maternal and infant nutrition, digital access, and combating childhood obesity through outcome-based interventions. The 8th Rashtriya Poshan Maah, launched on 17th September under ‘Swasth Nari, Sashakt Parivaar,’ highlighted women’s health and family empowerment. Additional activities promoted antenatal care, balanced diets, hydration, and Poshan Tracker registration. Over 14 crore initiatives spanned six pillars: childhood obesity, ECCE, IYCF, Men-streaming, Vocal for Local, and convergence/digitisation, involving fathers, male caregivers, and communities. These efforts under Mission Saksham Anganwadi and Poshan 2.0 aim to achieve a Suposhit Viksit Bharat by 2047.

About
Mr. Rajasekhar Reddy
Mr. Rajasekhar Reddy, the visionary behind Group, brings over 15 years of expertise in fintech consulting. His deep understanding of financial technology, combined with a passion for innovation, has been instrumental in shaping LSSR into a trusted partner for businesses worldwide.
LSSR Group is a leader in fintech consulting, offering a range of services designed to help businesses thrive in the fast-evolving financial technology landscape.
Unlock the full potential of your brokerage with our expert consulting. Brokerage Technology
Optimize & aggregate CFD liquidity with our strategic consulting in various financial instruments.
Drive growth for your fintech startup with targeted marketing solutions. Growth Marketing
D’Rapport Ampang – Retail, Block B, Level 2U, Unit 2U-09, Jalan Ampang, Next To Korean Embassy, 55000, Kuala Lumpur, Malaysia
Revolutionize digital assets with OTC trading, liquidity, and Web 3 services. Digital Assets
Expand your business internationally with our comprehensive corporate services. Corporate Services
Corporate Address: +60
Phone:

The best part of humanity is still very much alive. It lives in the forward-thinking leaders who choose courage over comfort, fairness over shortcuts, and people over their own interests. What’s more, they see possibilities where others see dead ends, keep going when quitting would be easier, and measure success by smiles as much as revenue. That’s the kind of leadership that keeps humanity worth betting on. AsiaOne Magazine celebrates the Global Leaders of the Year 2025. These are the restless builders who refuse to inherit a broken world and are busy constructing one that actually works for everyone. They make the future feel like a promise instead of a burden
















Growing up during a period of remarkable transformation in the UAE, Dr. Al Jaber witnessed the nation’s remarkable rise under visionary leadership, which shaped his belief in progress through innovation and responsible development. A well-rounded leader, he holds a Bachelor’s degree in Chemical Engineering from the University of Southern California, an MBA from UAE University, and a PhD in Business and Economics from Coventry University. By leveraging engineering, strategy, and sustainability, he has led ADNOC through global energy transitions. As he has often says, “The world needs more energy with fewer emissions—this is the fundamental equation of our time.”
Dr. Al Jaber assumed the role of ADNOC’s CEO in 2016, marking a major turning point in the company’s 50-year history. Amid global energy market volatility, technological disruption, and accelerating energy transitions, his leadership provided a clear and strategic direction. He launched an integrated transformation programme, emphasising efficiency, performance, and economic returns, while maintaining ADNOC’s role as a global energy pillar. A strong proponent of modernisation, he championed advanced technologies such as AI, digital twins, predictive analytics and machine learning. Additionally, the establishment of the Panorama Digital Command Center enabled real-time operational visibility and smarter decisionmaking. Under his stewardship, the company enhanced global competitiveness, boosted downstream and petrochemicals production, and expanded strategic partnerships across Asia, Europe, and North America.
Dr. Al Jaber’s leadership philosophy is driven by long-term resilience. As he often emphasises, “We must be agile, we must be ambitious, and we must always be prepared to lead from the front.” His approach has positioned ADNOC among the world’s most progressive national oil companies, successfully balancing growth, sustainability and long-term energy security.
A crucial aspect of Dr. Al Jaber’s career is his commitment to sustainability. As the UAE’s Special Envoy for Climate Change and President of COP28, he has championed practical, inclusive, and scalable climate solutions. Under his leadership, ADNOC

DR. SULTAN AHMED AL JABER
Dr. Sultan Ahmed Al Jaber, Managing Director and Group CEO of ADNOC, is a dynamic and visionary leader dedicated to shaping a secure, inclusive and progressive energy future. Under his exemplary leadership, ADNOC has evolved into a technologically advanced global energy major, driven by innovation, sustainability and operational excellence. A forward-thinking leader, he strongly champions talent development and value creation. Dr. Al Jaber also serves as the UAE’s Minister of Industry and Advanced Technology, supporting national growth and long-term economic resilience for the nation and future generations alike globally
BY MONALISA CHOUDHURY
pledged net-zero emissions by 2045, reduced methane emissions, expanded carbon capture, and integrated renewables.
Other than ADNOC, Dr. Al Jaber, as founding CEO and now Chairman of Masdar, has turned the company into a leading global renewable energy company operating in over 40 countries, making Masdar a symbol of the UAE’s commitment to clean energy and carbon-neutral growth. He often says, “We need to come together around practical solutions—ones that raise ambition, cut emissions, and create real economic opportunities.” His passion, clarity, and optimism continue to inspire and influence global climate strategies, showing that meaningful change is possible when vision is paired with determination.
Under Dr. Al Jaber’s leadership, ADNOC has diversified into sectors like petrochemicals, refining, logistics, clean energy, and international partnerships. He expanded
the Ruwais Industrial Complex into a worldclass hub and launched the In-Country Value (ICV) programme, boosting the UAE economy, supporting local businesses, and creating jobs for Emirati youth. Overseeing key IPOs and strategic investments, he enhanced transparency and investor confidence, strengthening ADNOC’s role as a global economic driver and contributing significantly to the UAE’s broader development goals. Dr. Al Jaber believes that “Diversification strengthens nations, empowers industries, and secures longterm prosperity.” Guided by this vision, he has transformed ADNOC into a diversified energy and industrial leader.
The global energy sector has faced immense turbulence, from fluctuating crude prices to geopolitical shifts and unprecedented disruptions during the COVID-19 pandemic. Dr. Al Jaber navigated these challenges boldly with his foresight and calm resolve.
“DR. AL JABER’S INCREDIBLE JOURNEY EXEMPLIFIES PURPOSEFUL LEADERSHIP, DRIVEN BY HIS STRONG VALUES, CLEAR VISION, AND RELENTLESS COMMITMENT, DEDICATED TO BUILDING A STRONG & RESILIENT FUTURE FOR THE UAE & THE WORLD”
He ensured ADNOC’s operations continued uninterrupted, maintained supply reliability to international partners, and strengthened crisis-response measures across all ADNOC entities.
During the pandemic, he adhered to strict health protocols, ensured employee safety, and prioritised operational continuity, highlighting his value-driven leadership. Simultaneously, he accelerated digital transformation, increasing adoption of remote monitoring, automated systems, and robotics to maintain operational efficiency. By doing so, Dr. Al Jaber has repeatedly demonstrated his ability to convert adversity into lucrative opportunities. “Resilience comes not from avoiding challenges, but from meeting them with conviction and purpose,” he affirms. His leadership during periods of global uncertainty underscored ADNOC’s reputation as one of the most reliable and stable energy providers in the world.
Dr. Al Jaber’s contributions have earned worldwide recognition. He has been featured among the world’s most influential energy leaders by TIME Magazine, Financial Times, and Fortune. He received the UN Champions of the Earth Award, the Energy Executive of the Year Award, and numerous honors from international energy, climate, and economic organizations. His leadership at COP28 resulted in historic global agreements that united the nations around a balanced, equitable, and actionable climate pathway. His global influence extends beyond awards. He serves on several boards, government committees and international councils, where his thought leadership actively shapes global discussions across energy, climate, technology and economic development
Dr. Al Jaber stands apart for his visionary thinking, scientific rigour and national commitment. Under his inspiring leadership, ADNOC has emerged as a world-leading energy enterprise, known for its efficiency and sustainability, while remaining closely aligned with humanity’s need for shared prosperity and responsible environmental stewardship.
Born into the illustrious Bajaj family and raised in an environment driven by entrepreneurship and service to society, Rajiv Bajaj developed an early understanding of the automotive sector. He graduated in Mechanical Engineering from the University of Pune and later earned a Master’s in Manufacturing Systems Engineering from the University of Warwick, the UK. When he joined Bajaj Auto in 1990, India was on the cusp of economic liberalisation. The leader saw an opportunity not only to reinvent Bajaj Auto but also to redefine the very identity of Indian motorcycles. His simple yet profound belief was: “We must make fewer products, but make them better than anyone else.”
This principle has guided his journey in building Bajaj Auto into one of the world’s most respected and admired motorcycle brands.
When Rajiv Bajaj took over as Managing Director in 2005, he stepped into an opportunity to reshape Bajaj Auto’s future. One of his first bold moves was to pivot the company’s focus from scooters to motorcycles, a shift that many thought was risky. But his confidence in market insight and engineering innovation turned that risk into a game-changing strategy, positioning Bajaj Auto as a global motorcycle specialist. He led the development of iconic brands such as Pulsar, Discover, Avenger, and Platina, each of which redefined consumer expectations in their respective segments. The launch of the Pulsar in 2001, particularly, revolutionised India’s motorcycle market, introducing performance biking to a generation of young Indians. The Pulsar became not just a motorcycle but a cultural phenomenon, symbolising speed, style, and self-expression.
Under his leadership, Bajaj Auto embraced a philosophy of “design-led engineering,” focusing on robust engines, advanced performance, and emotionally resonant product design. As Rajiv Bajaj says, “A good product is the best form of marketing.” It highlights that real brand equity comes from engineering excellence rather than advertising rhetoric.
While many Indian companies sought to grow domestically, Rajiv Bajaj envisioned a future where Indian motorcycles would dominate world markets. He restructured Bajaj Auto

RAJIV BAJAJ
Rajiv Bajaj, the Managing Director of Bajaj Auto, is a dynamic leader known for his clarity of thought, strong conviction in values, and commitment to engineering excellence. His stellar stewardship has fortified India’s position on the global automotive map and transformed Bajaj Auto into one of the most respected names in mobility. Under his direction, the company has evolved from a traditional scooter maker into one of the world’s most formidable motorcycle brands, earning admiration across more than 70 countries with strong exports and international presence. His leadership has also driven company’s resurgence in electric mobility
BY MONALISA CHOUDHURY
as a global export-driven company. Today, Bajaj is India’s largest motorcycle exporter, with a presence in over 70+ countries and leadership positions across Africa, Latin America, and Southeast Asia. Global partnerships have been a key part of Bajaj Auto’s journey under Rajiv Bajaj. In 2007, he took a bold step by forming a landmark equity and technical partnership with Austria’s KTM. This collaboration eventually led to a majority stake acquisition. It gave birth to high-performance motorcycles like the KTM Duke and RC series, built in India and shipped across the globe.
Similarly, Bajaj’s alliance with Triumph Motorcycles UK has opened new horizons in the mid-capacity motorcycle segment. The Triumph Speed 400 and Scrambler 400X, co-developed and manufactured at Bajaj’s Chakan plant, have been lauded globally for offering international quality at accessible prices. These collaborations reflect Rajiv Bajaj’s strategic thinking of combining Indian efficiency with world-class engineering.
Rajiv Bajaj has consistently championed innovation to drive his company’s growth. He believes in creating platforms rather than standalone products, allowing Bajaj to develop multiple models from shared foundations while optimising cost, performance, and time-to-market. This modular approach has become a benchmark in India’s automotive sector.
In recent years, Rajiv Bajaj has steered Bajaj Auto into the next era of mobility through electric vehicles. The revival of the legendary Chetak brand as an electric scooter has been an important step towards sustainable transportation. Chetak EV is known for its metal body, sophisticated design, and superior battery architecture, representing Bajaj’s shift towards longterm sustainability and green innovation.
A forward-thinking leader, Rajiv Bajaj’s philosophy highlights responsible engineering. “Sustainable mobility is not about racing toward technology. It is about
“RAJIV BAJAJ HAS GUIDED BAJAJ AUTO INTO THE NEXT ERA OF MOBILITY WITH A STRONG PUSH TOWARD E-VEHICLES. REVIVING THE LEGENDARY CHETAK BRAND AS AN E-SCOOTER HAS PROVEN TO BE A STRATEGIC LEAP TOWARD SUSTAINABLE TRANSPORTATION”
building what is safe, reliable, and meaningful for society,” he says. This approach ensures that Bajaj Auto’s electric mobility initiatives are not driven merely by trends, but through results-driven strategies.
A multifaceted leader, Rajiv Bajaj is deeply influenced by homeopathy, yoga, and holistic organisational principles. He values clarity over complexity, long-term thinking over short-term fixes, and transparent communication over corporate jargon He often states, “Confusion kills companies; clarity builds them.” His leadership style is driven by discipline with empowerment. He has created a healthy culture where teams are encouraged to experiment, question, innovate, and simplify. What’s more, his intellectual approach extends to every part of the company, from product development and marketing to manufacturing and customer experience.
Bajaj Auto’s state-of-the-art manufacturing plants in Chakan, Waluj, and Pantnagar reflect this culture of precision, productivity, and performance. The company’s “3G Model”—Global Brand, Global Manufacturing, Global Distribution— has become a blueprint for Indian automotive companies aspiring to compete internationally.
Rajiv Bajaj has been honoured with several distinguished awards that celebrate his visionary leadership and transformational impact on the global two-wheeler industry. In 2024, the leader was conferred on India Business Leader Awards by CNBC TV18 and Outstanding Company of the Year award. In 2017, Business Standard conferred upon him the CEO of the Year Award, celebrating his excellence in engineering-led growth, international partnerships, and categorydefining product development. He was also felicitated with the CNBC-TV18 India Business Leader Award in 2014, for his crucial role in building Bajaj into India’s largest motorcycle exporter. Collectively, these prestigious accolades reflect his significant contributions to mobility, industry innovation, and strengthening India’s position in global manufacturing.
Born into a middle-class family in Mumbai, Mr. Kotak’s early life was marked by a strong emphasis on education, discipline, and integrity. He attended Hindi Vidya Bhavan for his schooling and went on to earn a bachelor’s degree from Sydenham College. Drawn to numbers and finance, he pursued a postgraduate degree in management (MMS) from the Jamnalal Bajaj Institute of Management Studies in 1982, which laid the foundation for his entry into the financial world. His formative years instilled in him a deep understanding of responsibility, hard work, and progressive thinking. These traits have guided him throughout his illustrious career.
Mr. Kotak’s professional journey began shortly after his MBA when, in 1985, he founded Kotak Capital Management Finance Ltd. Working out of a modest 300-squarefoot office in Mumbai’s Fort area, with seed capital borrowed from friends and family, he took his first steps towards what eventually evolved into a noteworthy and influential entrepreneurial venture. The company started with bill discounting and slowly expanded into investment banking, stockbroking, mutual funds, car finance, and insurance.
A landmark moment in Mr. Kotak’s career came in March 2003, when his firm became the first non-banking financial company (NBFC) in India to secure a full banking license. This milestone marked the birth of Kotak Mahindra Bank, which eventually became one of India’s most trusted private-sector banks. From those modest beginnings, his vision and longterm thinking transformed a small financial firm into a financial hub. His emphasis on creating a robust institution, rather than seeking short-term gains, laid a foundation for decades of sustained growth.
Over the years, Kotak Mahindra Bank has evolved into a leading force in India’s banking sector. As of March 2025, the bank operates over 2,148 branches across India and abroad, with total assets of ₹6,93,624 crore and a loan book of ₹4,86,166 crore. In FY 2024–25, the bank reported a net profit of ₹18,213 crore, reflecting its strong financial health and operational excellence. Even after stepping down as MD & CEO in September 2023, Mr. Kotak plays a crucial role as Chairman of the Board and nonexecutive director, guiding the bank’s long-

Mr. Uday Kotak, one of India’s most visionary bankers, exemplifies how ambition, discipline, and perseverance can turn dreams into reality. Known for his sharp financial acumen, Mr. Kotak has transformed India’s banking sector through his entrepreneurial spirit. From humble beginnings in Mumbai, he rose to establish Kotak Mahindra Bank, a symbol of trust, resilience, and long-term growth in the financial sector. His journey is a saga of grit and determination, inspiring countless aspiring entrepreneurs across the country. Today, his legacy stands as a reminder that passion paired with purpose can reshape an entire industry
BY MONALISA CHOUDHURY
UDAY KOTAK term strategy, governance, and overall vision.
A key aspect of Kotak Mahindra Bank’s success has been his forward-looking approach. Under Mr. Kotak’s leadership, the bank embraced a “digital-first” strategy by investing in technology to improve efficiency, enhance customer experience, and expand retail banking. He consistently emphasised the importance of leveraging innovation with trust, ensuring that growth did not come at the expense of relationshipbased banking. This philosophy guides the bank even today, thus helping it stay agile, customer-centric, and technologically forward.
Apart from banking, Mr. Kotak has been an influential figure in India’s financial sector and economic policy space. His stature and expertise allow him to contribute to thought leadership, policy-making, and industry reforms. In August 2025, he was honoured
with the IAA Business Leader of the Year award for his active contribution to India’s banking transformation, financial inclusion, and corporate governance. The accolade highlights the fact that even after stepping down from executive management, Mr. Kotak’s vision continues to shape India’s financial narrative.
Throughout his illustrious career, Mr. Kotak has received numerous awards for his exceptional leadership and entrepreneurial achievements. In 2023, he was honoured with the Lifetime Achievement Award at CNBC-TV18’s India Business Leader Awards (IBLA), acknowledging over three decades of institution building and ethical banking. Globally, he was recognised as Ernst & Young’s World Entrepreneur of the Year in 2014. This award placed him among the world’s most accomplished business visionaries. Other notable accolades include the Economic Times Business Leader of the
“UDAY KOTAK CHAMPIONS LONG-TERM VISION AND FINANCIAL CONTINUITY, PRIORITISING GOVERNANCE, INVESTOR TRUST, AND INNOVATION TO ENSURE KOTAK MAHINDRA BANK NOT ONLY THRIVES BUT LEADS CONFIDENTLY AMID INDIA’S EVOLVING ECONOMIC AND REGULATORY LANDSCAPE”
Year (2015) and the Business Today Best CEO (Banking Sector) award (2019), all reflecting his commitment to excellence, governance, and national economic development.
Mr. Kotak’s journey demonstrates the power of disciplined ambition and longterm vision. From a tiny 300-squarefoot office in Mumbai to leading one of India’s largest and most respected banks, his path demonstrates that resilience, prudence, and purpose can overcome even the most daunting challenges. His success story serves as an inspiration not only to aspiring entrepreneurs but also to anyone who believes in creating lasting value through dedication, innovation, and integrity. His focus on sustainable growth and empowering future leaders further amplifies the depth of his extraordinary professional journey.
Even after stepping back from day-today management, he continues to play a meaningful role in influencing India’s financial sector. Through his guidance, governance oversight, and advocacy for a banking system that is inclusive, modern, and resilient, he ensures that Kotak Mahindra Bank remains well-prepared for the future. At a time when India is navigating global economic uncertainties, rapid technological shifts, and evolving policy frameworks, leaders like Mr. Kotak offer the stability, foresight, and confidence needed for steady and long-term progress. His presence and perspective continue to inspire the industry and reinforce the importance of responsible, forward-looking leadership.
Today, Mr. Kotak is more than a banker or entrepreneur; he is an icon of visionary leadership, ethical governance, and transformative impact. His legacy is not merely in the numbers or profits but in the trust, innovation, and values he has embedded into the very fabric of Indian banking. From humble beginnings to global recognition, his success story inspires generations by showing that with vision, integrity, and relentless pursuit of excellence, remarkable achievements are always within reach.
Often referred to as a ‘model investor’, Mr. Ashish has brought more than just capital to Uganda. His investments have created jobs, introduced advanced technologies, and supported skills development—all in line with the country’s FDI goals.
Born into a business-oriented family in India, Mr. Ashish grew up surrounded by trade and enterprise. His father ran successful ventures in manufacturing and exports, which gave young Ashish an early education in business. An alumnus of Harvard Business School, after studying management, he actively participated in the family’s textile and commodity businesses across India and the UAE. His independent research into emerging markets eventually led him to Africa, where Uganda stood out for its stability, resources, and opportunities in manufacturing and agro-processing.
Mr. Ashish’s first encounter with Uganda was unforgettable. Driving from Entebbe to Jinja, he was captivated by the lush Mabira Forest. He later said the experience made him feel a deep connection to the country. Unlike investors seeking quick profits, he chose a patient approach, taking time to understand local needs and policies. His efforts were supported by government initiatives, such as tax incentives and business registration reforms, as well as guidance from officials like Minister Evelyn Anite, who personally encouraged his entry into the country’s industrial sector.
In December 2015, Mr. Ashish launched Modern Distillers Ltd., his first Ugandan venture. The ethanol production facility became operational in 2017, using local sugarcane to produce high-quality alcohol for domestic use and export. Apart from building a factory, the leader invested in training local workers and introducing modern technology, ensuring that the benefits extended to the community and built long-term capacity.
The success of Modern Distillers encouraged Mr. Ashish to move quickly into other sectors. He established Modern Gas in 2018 to produce carbon dioxide for beverages and industrial use, followed by Modern Aluminium in 2019, which allowed construction companies to source aluminium profiles locally instead of relying on imports. That same year, he founded Modern Organic

ASHISH MONPARA
Mr. Ashish Monpara, the Chairman and Founder of the Modern Group, is one of Uganda’s most influential industrial leaders who has been reshaping the country’s manufacturing sector through bold and sustained investments. An entrepreneur with roots in India, Mr. Ashish is inspired by self-made visionaries. He believes that ambitious dreams and hard work can transform lives significantly. Today, he stands as one of Uganda’s most enterprising industrialists, a first-generation businessman who bet on a country overlooked by many
BY MONALISA CHOUDHURY
Fertilisers, which uses organic waste to provide farmers with eco-friendly solutions that improve soil health.
When the COVID-19 pandemic struck in 2020, Mr. Ashish launched Modern Sanitizer, which not only met the urgent demand for hygiene products but also created job opportunities for women and young people in Mbiko. Later that year, he opened Modern Tiles in Njeru, Buikwe District, a facility that produces 49,000 square meters of tiles daily, the largest of its kind in eastern and central Africa. It employs 500 Ugandans directly, and controls nearly half of the domestic market while also exporting to Kenya and other regional markets. Modern Tiles has been honoured with several international awards, including recognition at the Abu Dhabi Investment Congress 2023 as the Best Investment in Africa.
During the pandemic, while many industries shut down, the Modern Group, led by Mr.
Ashish, continued operating at 50% capacity. Workers were housed on-site and provided with food and accommodation. This bold move not only kept the business going but also allowed the group to open two new factories during lockdown.
Mr. Ashish’s greatest impact has come in sugar production. In 2021, he launched Kidera Sugar in Buyende District by setting up a facility with a crushing capacity of 2,500 tons of cane per day. This Greenfield project was designed as a closed-loop operation, using by-products to create ethanol and fertilisers, which minimised waste and created additional revenue streams. In 2023, he took a bold step by acquiring and refurbishing the historic Kaliro Sugar Factory under the government’s privatisation program. The revamped plant was commissioned in August 2025 with an initial capacity of 7,500 tons per day, with plans to scale to 20,000 TCD within five
“AT THE AGE OF 42, MR. ASHISH HAS BUILT THE MODERN GROUP OF INDUSTRIES INTO A HUB THAT HAS INVESTED OVER $850 MILLION IN UGANDA’S ECONOMY. IN LESS THAN A DECADE, HE HAS TRANSFORMED A SINGLE VENTURE INTO A DIVERSIFIED EMPIRE OF 11 COMPANIES”
years. When fully operational, it will produce nearly a million tons of sugar annually. President Yoweri Museveni attended the launch and hailed it as a milestone for Uganda’s industrial progress, praising its role in supporting farmers and strengthening rural economies. Mr. Ashish pledged the project would empower smallholder farmers through out-grower schemes. Additionally, the Modern Group recently added Kassanda Sugar to its portfolio, solidifying its status as East Africa’s leading sugar producer.
With total investments exceeding $700 million, the Modern Group now operates 11 companies spanning alcohol distilling, gas production, aluminium, tiles, fertilisers, sanitisers, and sugar. In 2022, the group launched luxury spirits for export to the US and Asia — a global first. Likewise, Modern Power, introduced in 2023, addresses Uganda’s growing demand for energy, while major new projects include a $200 million iron ore steel plant in Muko and a $100 million vaccine manufacturing facility. The group employs 20,000 employees directly and indirectly through its supply chains, and contributes over UGX 12.5 billion annually in taxes to Uganda Revenue Authority.
For Mr. Ashish, Uganda represents more than a business destination; it is a second home. His long-term goal is to expand Kaliro Sugar to 30,000 TCD, grow the group’s steel production capacity, and create 10,000 jobs within five years. At the 2025 India-Africa Conclave, he encouraged Indian investors to explore Uganda’s potential, citing its favourable business climate.
Mr. Ashish is celebrated for his communityfocused leadership at the Modern Group. Under his guidance, the company has enhanced local infrastructure by building roads, installing boreholes upgraded to solar systems, and constructing fully equipped classrooms in Njeru, Buikwe District. The leader prioritises local employment, with Ugandans making up 95% of the workforce, and has initiated training programs in Buyende and Kaliro to help farmers increase sugarcane yields, thereby boosting incomes and promoting rural development.
Aseasoned entrepreneur with an unshakeable belief in holistic living, Mr. Clayton founded The ROOT Brands in 2020 with the mission of revolutionising how people detoxify, heal, and thrive. Through his brand, he aims to offer a unique, researchbacked path to detoxification and holistic selfcare. Based in Nashville, the nutraceutical and lifestyle company stands as a global wellness brand that adheres to a human-cantered approach to health.
Raised in southwest Washington, Mr. Clayton grew up in a veterinary environment. He developed a fascination for biology and integrative therapies at a remarkably young age. His early exposure to the study of bacteria and parasites inspired a lifelong curiosity about the intricate balance of health. With a humanities degree in communications, business, and kinesiology, he utilised his love for science and innovation into a meaningful purpose of helping people understand their body’s true potential.
Over the years, the thoughtful leader has developed innovative business models in healthcare, particularly in analytical testing and chronic disease prevention. His work has helped medical practices identify early signs of conditions like diabetes, obesity, and heart disease, besides ensuring better outcomes through timely intervention. His extensive experience, from product formulation to consulting and distribution, has strengthened the foundation on which The ROOT Brands now thrives.
The ROOT Brands was born out of Mr. Clayton’s passion to challenge conventional wellness methods. His approach is grounded in simplicity and authenticity. A prudent leader, he focusses on what truly works rather than what merely trends. Together with his wife, Dr. Christina Rahm, the brand’s Chairman and Chief Scientist, he has built the company around four essential principles of simplicity, integrity, authenticity, and education. The couple’s shared mission is to address the root cause of health issues, be it toxins, stress, or emotional imbalance, and provide people with safe, natural, and effective tools to restore balance. They merge scientific research with nature’s wisdom to deliver products that eliminate harmful substances from the body and enhance its overall performance.
Through this thoughtful approach, Mr. Clayton and Dr. Christina have become trusted figures in global wellness. Their commitment to purity and transparency resonates with

CLAYTON THOMAS
Mr. Clayton Thomas, CEO and Co-founder of The ROOT Brands, has spent over 25 years transforming the way people view health and wellness. By leveraging science and innovation, he is on a mission to help and empower individuals to “get to the root” of their health concerns. Mr. Clayton’s journey is a movement driven by empathy, education, and empowerment. His efforts with The ROOT Brands demonstrate how science, integrity, and purpose can come together to create meaningful change. Through innovation and a strong focus on natural health, he is redefining how we understand and practice healthy living in today’s busy world
BY MONALISA CHOUDHURY
people seeking genuine, sustainable solutions to health challenges.
Mr. Clayton’s commitment to quality is uncompromising. Under his direction, every product that bears The ROOT name goes through a meticulous process of sourcing, testing, and refinement. He has partnered with leading laboratories across the USA and he sources premium ingredients from trusted global suppliers to maintain the brand’s gold standard. Each product is manufactured in specialised facilities in Texas, New York, Florida, Las Vegas, and Utah, adhering to standards that exceed even pharmaceutical benchmarks. Every batch undergoes rigorous quality checks to ensure potency, safety, and consistency.
Mr. Clayton’s personal philosophy is “If it isn’t clean, it doesn’t count.” This belief drives him to personally oversee each step of the process, from sourcing to packaging, ensuring that every product remains true to
the company’s core promise of purity with purpose. This transparency and accountability have earned the trust of customers across continents.
Under Mr. Clayton’s leadership, The ROOT Brands has evolved from a passionate idea into a thriving international enterprise. Today, the company’s products are available in over 67 countries, and its expansion continues at a remarkable pace. The brand is actively building new presences across Asia, the Middle East, and South America, with particular growth in Japan, Colombia, Indonesia, Mexico, and Turkey. This expansion is not just about business; it reflects his mission to make holistic wellness accessible to everyone, everywhere.
“It’s truly fulfilling to see The ROOT Brands touch lives across the globe,” says Mr. Clayton. “Everyone deserves access to the knowledge and tools needed to live their healthiest life,” he adds.
“MR. CLAYTON’S RELENTLESS PURSUIT OF EXCELLENCE HAS TURNED THE ROOT BRANDS INTO A GLOBAL SYMBOL OF TRUST AND EFFICACY. ROOT PRODUCTS ARE GMO-FREE, CRUELTY-FREE AND WHEAT-FREE AND ALIGN WITH MODERN ETHICAL AND DIETARY PREFERENCES THAT PEOPLE VALUE”
A true multitasker, Mr. Clayton’s work extends far beyond product development. He cofounded ROOT Wellness, a social sharing community that connects people through a shared commitment to health. The platform is transforming how wellness products are marketed, besides emphasising authenticity and engagement rather than traditional advertising.
ROOT Wellness features a variety of lifestyle products, from Rahm Roast coffee to Ella Pure Organic Beauty, that promote both physical and emotional balance. These offerings reflect Mr. Clayton’s philosophy of holistic living, where wellness is not limited to the body but also nurtures the mind and spirit. Beyond entrepreneurship, the versatile leader also connects with audiences through “The Green Edition,” a TV show centred on health and wellness that educates viewers on nutrition, mindfulness, and mental health. Each episode features conversations with experts who inspire people to embrace holistic habits and live consciously. His ability to combine scientific insight with relatable communication has made him a respected voice in global wellness circles.
Under Mr. Clayton’s guidance, The ROOT Brands actively promotes social responsibility by emphasising environmental preservation and animal welfare. The company integrates sustainability into every layer of its operations, from ethical sourcing to eco-friendly packaging. He believes that wellness should never come at the expense of the planet. Through initiatives that support clean living and community empowerment, he ensures his brand’s growth positively impacts people and nature.
Mr. Clayton was recognised as the Top Global Entrepreneur of the Year 2025 by the International Association of Top Professionals (IAOTP), for his exceptional leadership, dedication, and commitment to the industry. He was also featured in Exeleon Magazine, which highlighted his achievements and offered a glimpse into the promising future of ROOT Brands under his stewardship.
For over three decades, Mr. Musalekar has shaped his journey across continents and cultures, guided by the belief that real leadership must have a soul. Today, as the head of one of the most respected industrial and technology groups, he champions innovation, integrity and inclusion. He reminds everyone around him that when progress is driven by purpose, it becomes truly transformative.
Mr. Musalekar began his professional journey at OTIS as a graduate engineer trainee. The formative years spent on the shop floor and in the field taught him discipline, humility, and the importance of perseverance. His rise through leadership ranks was driven not by ambition alone, but by a constant desire to learn and understand not just how things work, but why people work the way they do.
Mr. Musalekar believes that true success comes from harmony, not hierarchy. To him, leadership is about trusting, respecting, and empowering people so that they can bring out their best. His style is defined by empathy and collaboration, and over the years, he has built an environment where every voice is valued and everyone feels inspired to grow beyond their limits. Having worked in diverse business environments, from Japan and China to Europe and the United States, he has come to see diversity as a wellspring of creativity. Also, his global experience has taught him that understanding different perspectives is key to connecting vision with execution.
He often reminds others that growth needs a soul, because numbers alone don’t tell the full story; it is the people behind them who truly matter. Real leadership, for Mr. Musalekar, is about building progressive organisations where values and vision advance hand in hand.
One of the proudest milestones in Mr. Musalekar’s career has been the transformation of LUMEL S.A., a Polish company under the Rishabh Group. When he took the helm in 2013, LUMEL was a respected name with a strong legacy but limited global visibility. Seeing its true potential, he set out to make it a world-class company known for precision, innovation, and sustainability. He spearheaded a comprehensive modernisation of operations, the digitalisation of production processes, and the strengthening of R&D capabilities. Through his efforts, LUMEL not only grew in performance but also in vision. Under his guidance, the brand’s products reached over

Mr. Dinesh Musalekar, Group CEO and Executive Director of Jaipur-based Rishabh Group of Companies, is a seasoned leader with over three decades of work experience. A people-first leader, Mr. Musalekar believes that true leadership is not about authority, but about nurturing ideas, inspiring teams, and unlocking the potential in others. His success saga reflects vision, dedication, and the ability to turn challenges into opportunities. His story is one of meaningful impact and a commitment to building companies that not only succeed, but also inspire and uplift those within them
BY MONALISA CHOUDHURY
70 countries, new partnerships flourished, and exports soared. Yet beyond technological and commercial milestones, what truly stands out is the cultural renewal he inspired. He focused not only on systems and processes but also on the people. The progressive leader turned LUMEL into a place where employees take pride in their work, creativity is celebrated, and teamwork drives every achievement.
Mr. Musalekar credits his family for being his greatest pillar of strength, whose relentless faith and support have kept him grounded through the many transitions of his career. He also finds inspiration in his colleagues who teach him about resilience, innovation, and humanity. A humble leader, he believes that his success has never been a solitary achievement but the sum of many shared efforts.
Mr. Musalekar firmly believes that the future belongs to organisations that balance innovation with responsibility. Under his stewardship, the Rishabh Group has embraced
digital transformation, automation, and artificial intelligence to build smarter, more agile, and sustainable operations.
Looking ahead, his long-term vision is to position the Rishabh Group as a global leader in green energy technologies, precision measurement, and smart manufacturing. The Group, under his direction, invests heavily in R&D, renewable energy, advanced materials, as well as in people. Mr. Musalekar maintains that human capital is the most valuable investment any enterprise can make.
Under Mr. Musalekar’s guidance, Rishabh Group has implemented wide-ranging CSR initiatives focused on sustainability, education, and community welfare. From reducing carbon emissions and investing in renewable energy to supporting local schools and healthcare projects, the company consistently seeks to create value that extends beyond profit.
The Rishabh Green Initiative is one such example; it is a long-term program dedicated
“KNOWN FOR PROMOTING INNOVATION AND SUPPORTING SUSTAINABLE GROWTH, MR. MUSALEKAR BELIEVES IN EMPOWERING HIS TEAMS FOR ACHIEVING EXCELLENCE AND SHAPING FUTURE-READY LEADERS WHI CAN MAKE A DIFFERENCE”
to resource optimisation, waste reduction, and environmental awareness. The Group also partners with universities and technical institutes to promote research and skill development, helping to shape the next generation of engineers and innovators.
Mr. Musalekar is a strong advocate for gender equality and inclusion. He champions greater opportunities for women in technology and manufacturing, believing that an inclusive workplace is not just fair, but also sparks creativity. To him, leadership is truly meaningful only when it empowers and uplifts others.
For Mr. Musalekar, sound corporate governance is key to success. He leads with transparency, ethics, and accountability, backed by management systems that are data-driven and compliant, and people-focused. He encourages open communication at all levels and makes sure integrity guides every decision. This dedication to ethical conduct has built trust across the Rishabh Group’s global network, besides keeping the company’s growth steady, sustainable, and principled.
Reflecting on his journey, Mr. Musalekar sees not a list of accomplishments, but a story of relationships, experiences, and shared triumphs. From his early engineering days in India to leading global teams across five continents, his path reflects a belief that leadership, when rooted in empathy and vision, can transcend borders.
Mr. Musalekar’s leadership and vision have earned him numerous prestigious awards and recognitions throughout his career. He was honoured with Indian Achievers’ Award 2020-21 for Business Leadership by the Indian Achievers’ Forum and Achievers’ World for his outstanding contributions to the business landscape. In Poland, he received the “Gold Medal,” the highest civilian award from the Mayor of Zielona Góra, for his role in transforming and expanding Lumel and creating a positive impact on the city. Additionally, he was named “Personality of the Year 2020” in the Business category by Polska Press Grupa for his consistent excellence, global influence, and steadfast commitment to driving innovation and growth.
Dr. Rahm’s remarkable journey began with an impressive academic background. She studied at Cornell University and Harvard University, where she explored subjects ranging from nanotechnology and pharmaceutical management to nutrition, education, and philosophy. This broad academic foundation gave her a deep understanding of how science relates to human behaviour. Her educational path also includes degrees from the University of South Alabama, where she earned her Bachelor’s in Criminal Justice and a Master’s in Rehabilitation Counselling. Later, she pursued multiple doctorates in fields such as Counselling Psychology, Health Care Business, and Medical Research Sciences. Each degree reflects her belief that learning is not just about personal achievement but about gaining the tools to improve lives.
Dr. Rahm’s professional career is built on that same philosophy. Her early work in the pharmaceutical and nutraceutical industries gave her valuable experience with some of the world’s leading healthcare companies, including Janssen, Johnson & Johnson, Biogen, UCB, Bristol Myers Squibb, and Alexion. These roles helped her develop a global perspective on science and business, besides deepening her awareness of how health challenges affect individuals and communities differently.
Driven by her vision to create a healthier world, Dr. Christina Rahm founded DRC Ventures, a company that brings together 12 different businesses across various sectors to promote innovation in human health and environmental care. Through this platform, she has developed and guided companies addressing key global challenges in healthcare, nutrition, and technology. Under her leadership, DRC Ventures has launched pioneering brands such as Envirem, which works to reduce environmental health risks, and Rahm Roast, a special coffee blend made with detoxifying ingredients. Her ventures also include Ella Pure Beauty, known for its natural, cruelty-free skincare and makeup, and Merci Dupre Clothiers, which focuses on sustainable, toxin-free fabrics. Through House of Rahm, she encourages conversations around politics, fashion, and culture, while her podcast platform, Under the Red Chandelier, creatively connects science with art and style. Her concern for well-being even extends to animals through

DR. CHRISTINA RAHM
Dr. Christina Rahm’s journey is a story of courage, compassion, and a belief in the power of science to heal people and the planet. As Founder of DRC Ventures and The ROOT Brands, she has built a legacy rooted in innovation and empathy. A scientist, entrepreneur, author, patent innovator, and humanitarian, Dr. Rahm lives by the principle that success comes from helping others while staying true to one’s purpose. Known for her honest and heartfelt speeches, Dr. Rahm inspires with her integrity, practical wisdom, and the conviction that learning from failure is the key to meaningful impact
BY MONALISA CHOUDHURY
Bill and Co by DRC, which offers premium nutraceuticals for pets.
THE ROOT OF WELLNESS
Another milestone in her journey is The ROOT Brands, a global wellness company present in over 60 countries. The ROOT Brands encourages people to live cleaner and healthier lives by focusing on natural detoxification and nutrition. As Chief Science Officer, Dr. Rahm leads research and product development to support natural detoxification and nutrition.
TURNING PAIN INTO POWER
Behind these accomplishments, however, is a story of immense personal resilience. In her twenties, Dr. Rahm faced a lifethreatening battle with Lyme disease, followed by a brain tumour and several bouts of cancer in her thirties. These experiences tested her strength and transformed her perspective on life. Instead of giving up, she chose to dedicate her survival to helping
others live fuller, healthier lives. She wrote Cure the Causes Cookbook and Be Your Own Inspiration to share not only her scientific knowledge but also the wisdom she gained through personal experience. Through these books, she encourages people to embrace change, find their passions, and live in alignment with their values.
Dr. Rahm’s compassion doesn’t stop with her writing or business ventures. Her heart for service shines through the Rahm Foundation, which she founded to support women, children, and peace-building initiatives around the world. The foundation has donated over $500,000 to educational, environmental, and humanitarian causes to date. It has provided scholarships to students, created mentorship programs, and supported local and international organisations focused on empowerment.
Dr. Rahm’s philanthropic activities extends across continents—from Tennessee, where
“IN A WORLD THAT OFTEN CELEBRATES AMBITION OVER EMPATHY, DR. CHRISTINA RAHM REMINDS US THAT TRUE ESSENCE OF LEADERSHIP LIES IN COMBINING INTELLECT WITH KINDNESS. HER SUCCESS STORY SERVES AS A REMINDER THAT HEALLING THE WORLD BEGINS WITH THE COURAGE TO CARE”
she has supported Tennessee Voices for Children, to several countries in Africa, where she works closely with programs such as Korah Kids, Rudolph College, Grace Bible University, and The Treasured Foundation. These initiatives help women and children gain access to education and vocational training, giving them the means to achieve independence and escape poverty. During the pandemic, she personally contributed to schools and shelters in Korah, Ethiopia, providing musical equipment and educational resources. Her work reflects a deep belief that empowering women and children creates stronger, more compassionate communities.
Dr. Rahm also plays an active role in global advocacy. She serves as the Tennessee CoChair for the United Nations Women for Peace Association and as the U.S. Ambassador for the European Women’s Association. In both roles, she promotes equality, education, and opportunity for women worldwide.
Dr. Rahm’s work has earned global recognition for its impact and innovation. She has received several prestigious awards over the years, including the Empowered Woman Award from the International Association of Top Professionals for her exceptional leadership and passion for her field. She was also honoured with the 2023 Medical Science Innovation Award at the World Changers Summit. the NetworkKarriere Product Innovation Award, the European Award for Best Products in 2018, and the Nashville Healthcare Hero Award 2014. She was also named one of the Enterprising Women of the Year in 2012. In addition, Business Leader magazine recognised her as a Top Entrepreneur for her strong business vision and success.
Yet despite the accolades, she remains grounded in humility and purpose. Her career in scientific research continues to make waves, with several filed patents to her name. These include innovations in environmental filtration, protective skin coatings, detoxification methods, and nutritional supplement formulations. Each one is a reflection of her scientific curiosity and her commitment to making the world a safer and healthier place.
Ascholar by qualification and a leader by conviction, Dr. Sharma holds a B.E. in Computer Science and Engineering (First Class with Distinction) from Visvesvaraya Technological University, Karnataka. She has also been honoured with an Honorary Doctoral Degree from the Commonwealth University, USA, and a D.Litt. (Honorary Degree) in Education Management from The Thames International University on 17th February 2024. Her academic insights are driven by practical wisdom, which allows her to bridge the gap between traditional education systems and the dynamic needs of global industries. This unique ability has made her one of the most respected education leaders in the country.
Dr. Sharma’s passion for education began early in life, shaped by the guidance of her mentor, Dr. B. R. Shetty, and the values instilled by her parents. “They taught me that discipline, humility, and empathy are the foundation of true leadership,” she recalls. Even as a young student, she viewed education as a means to transform lives. During her higher studies, she began to notice something that stayed with her. Many talented students were not limited by their abilities, but by the lack of opportunity, guidance, and encouragement. That experience strengthened her belief that education should help students grow beyond academics. It should empower them to think critically, act ethically, and contribute meaningfully to society. To achieve this, she encourages interdisciplinary programs that integrate technology, management, and social sciences to prepare students to excel in corporate and entrepreneurial paths. She also inspires entrepreneurial thinking among students by organising start-up mentorship programs, hackathons, and business incubation challenges.
Taking on the role of CEO at BGI was both a calling and a challenge for Dr. Sharma. She saw immense potential in Brindavan — an institution with a strong foundation and a clear vision to nurture future leaders. What motivated her most was the opportunity to turn that vision into an educational experience that went beyond academics. “I wanted to create a space where knowledge meets innovation and values,” she says. Under her leadership, BGI has evolved into a thriving hub of holistic education, which nurtures confidence, creativity, and compassion in equal measure.

DR. SHRUTI SHARMA
Dr. Shruti Sharma, CEO of Brindavan Group of Institutions (BGI) believes that education is not just about degrees, but about dignity, dreams, and direction. A change-maker with a purpose-driven vision, Dr. Sharma has transformed BGI into a dynamic centre of learning that not only imparts knowledge but also inspires curiosity and creativity. A true leader, she aims to transform education into an instrument of empowerment, equity, and progress. At the same time, she he inspires students to become responsible and socially engaged leaders of tomorrow. Her success saga inspires generations to dream big and act boldly
BY MONALISA CHOUDHURY
DRIVING INNOVATION IN EDUCATION
Dr. Sharma believes in the power of researchdriven education. Under her leadership, BGI has built a stronger research culture to encourage interdisciplinary studies, support faculty development, and motivate scholars to publish in reputed national and international journals. By introducing outcome-based learning models and skilloriented workshops, she has aligned academic goals with industry expectations.
Her thoughtful initiatives have led to the establishment of several Centres of Excellence that focus on entrepreneurship, innovation, and digital transformation. These centres also help students turn their creative potential into real-world solutions. Her belief that education must evolve with time has helped BGI remain relevant, dynamic, and competitive in the modern academic arena.
Under Dr. Sharma’s direction, BGI is also expanding its global reach through international tie-ups, student exchange
programs, and collaborations with foreign universities. She aims to provide her students with global exposure while keeping education rooted in Indian values. She often emphasises that education should prepare individuals to adapt and contribute meaningfully to any part of the world, without losing their sense of identity and ethics.
As a forward-thinking leader, Dr. Sharma has been an active advocate of India’s National Education Policy (NEP) 2020. Under her leadership, BGI has restructured its academic framework to promote multidisciplinary and skill-based learning.
The introduction of credit-based systems, research projects, and industry-linked internships has helped students gain realworld exposure. “We integrate ethics, technology, and sustainability into every program,” she explains. “Our aim is to produce responsible global citizens who can
“DR. SHARMA’S LEADERSHIP STYLE REFLECTS EMPATHY, CLARITY, AND DISCIPLINE. SHE LEADS FROM THE FRONT AND SETS AMBITIOUS GOALS WHILE GUIDING HER TEAMS WITH COMPASSION AND TRUST. HER LEADERSHIP PHILOSOPHY IS DRIVEN BY INCLUSIVITY AND EMPOWERMENT”
contribute to the vision of Viksit Bharat.”
Dr. Sharma’s leadership philosophy is driven by inclusivity and empowerment. She has introduced merit-based scholarships, women empowerment initiatives, and mentorship programs to ensure opportunities reach every deserving student. Her focus on diversity in thought, culture, and participation has helped BGI attract students from across India and abroad, thus making it a truly global learning destination.
Dr. Sharma has embedded sustainability into BGI’s core values. Under her guidance, the group has launched green campus initiatives such as rainwater harvesting, solar energy systems, and waste segregation drives. She also encourages her students to participate in community development programs, thus making social responsibility an active part of education.
Additionally, in collaboration with NGOs and government bodies, she has initiated outreach programs focused on rural education, women’s skill training, and digital literacy. These efforts reflect her belief that education’s true purpose lies in improving lives and empowering communities.
Dr. Sharma is easily approachable to her students, faculty, and staff. According to her, great institutions are built by great teams; therefore, with a strong emphasis on professional growth, training, and motivation, she has nurtured a cohesive and performance-driven culture at BGI.
Dr. Sharma’s outstanding contributions have earned her numerous national and international recognitions. She has been honoured with the Most Admired CEO of the Year Award and the World Leading Leader Award at the British Parliament. In 2024, she received the Youth Icon Award – Sirmaur Ratan for her exemplary role in education and leadership. Her efforts were further celebrated when she was conferred with the Karnataka Ratna Award during the Karnataka Rajyotsava celebrations.
Growing up in India, Dushyant struggled with a severe stammer. Speaking a single sentence in public felt like climbing a mountain. As a teenager, he spiraled into addiction — alcohol, drugs, and chain smoking. “I was a drug addict, I was an alcoholic, and a chain smoker. By the age of 19, I was thrown out of my own home,” he recalls. Homeless, rejected, and alone, he took up work as a waiter simply to survive. Those years were far from glamorous, but they built something more valuable for him than comfort. “Each table I served, each order I took, was teaching me something bigger — how to serve people. That later became the principle of my life and leadership,” he says. From that foundation of humility and discipline, he began rebuilding his life. He joined Xerox as an entry-level salesperson and rose to the position of Sales Manager through sheer persistence. Yet even in corporate success, he felt an inner void — a deeper purpose calling him forward.
His life changed when he encountered The Art of Living Foundation and its founder, Gurudev Sri Sri Ravi Shankar. Through meditation, breathing practices, and the philosophy of selfless service, he not only overcame addiction but found a mission anchored in compassion. “Alcohol only gives empty promises of joy and never delivers. Through meditation and service, I found the joy that doesn’t fade,” he explains. He spent years teaching stress management in prisons, supporting inner-city communities, and guiding thousands in workshops on mental well-being. Service, he discovered, had the power to transform individuals and entire societies. This calling eventually led him to Jamaica in 2012, where he began volunteering with at-risk youth and inmates. He had no idea that this island would become the birthplace of his greatest chapter.
By 2015, after years of humanitarian work, Dushyant faced a hard truth: he had run out of personal funds. “Charity cannot happen from an empty bowl,” he reflects. His passion to serve was limitless; but his resources weren’t. What he needed was not charity, but sustainability. A platform that could fund service for generations. “I never wanted to do business. I wanted to

DUSHYANT SAVADIA
From struggle to service, from stammering to the skies — the life of Dushyant Savadia, Founder and CEO of Amber Group Limited, reads like a modern epic. Today he is celebrated as a global entrepreneur, humanitarian, licensed pilot, and one of the Caribbean’s most visionary technology leaders. Yet the road he traveled to reach this point is a powerful reminder that true leadership is not born from privilege, but from the courage to rise after every fall. His story is not just one of achievement, but of transformation. What makes it unforgettable is not the scale of his success, but the heart behind it
BY MONALISA CHOUDHURY
serve. The only chance I had was to create a vehicle that could fund this passion to serve.” With that vision, Amber Group Limited was born in a small 200 sq. ft. office in Kingston. What began with a loan and a dream soon expanded into one of the Caribbean’s most dynamic technology conglomerates, spanning 14 business lines across over 100 countries — from fintech to mobility, IoT, cybersecurity, aviation, edtech, and media. Among its flagship companies is Amber Connect, an AI-powered vehicle security and fleet management platform. What began as a simple tracker evolved into a globally trusted technology with predictive AI, real-time monitoring, and smart interventions redefining safety and mobility. Amber Group’s meteoric rise is not a story of business ambition but of service fueling innovation. “We’re not just building businesses. We’re building nations.”
In every national crisis of the last decade, one
pattern has remained constant: Dushyant Savadia and his team were there. When the pandemic shut the world down, Amber built JamCOVID in days — the platform that safely reopened borders for multiple countries, reunited families, and revived the economy when it mattered most. And when Hurricane Melissa devastated Jamaica a month ago, Amber moved just as quickly. The team built Jamaica’s official Melissa Relief Management Platform, ensuring transparent donations, real-time tracking, organized national response, and direct support for affected families. Each time Jamaica faced a defining moment, Dushyant Savadia and his team stepped forward — with speed, compassion, and solutions that helped the country stand back up.
If Amber is an empire, its foundation is humanitarianism. Dushyant ensures
“MR. DUSHYANT EXEMPLIFIES HOW RESILIENCE AND PURPOSE CAN CREATE IMPACT. FROM MODEST BEGINNINGS, HE BUILT A GLOBAL TECHNOLOGY POWERHOUSE WHILE CHAMPIONING EDUCATION, SOCIAL CHANGE, AND EMPOWERMENT FOR YOUNG PEOPLE ACROSS COMMUNITIES”
that 80% of the company’s net profits are reinvested into communities, youth empowerment, and education. The Amber HEART Coding Academy has already fully funded the training of more than 600 Jamaican youth in software development, guaranteeing each graduate employment upon completion. It has transformed lives, families, and communities — creating a new generation of tech leaders. Amber also funds the education of its employees’ children globally, a groundbreaking model of corporate responsibility.
In education, Amber’s impact expands further. The company launched Jamaica’s first AI Learning Platform, soon to be rolled out across all primary and secondary schools — revolutionizing the classroom with personalized, adaptive learning that bridges the digital divide.
Despite a childhood stammer that once crippled his ability to speak, Dushyant eventually fulfilled a lifelong dream: becoming a licensed pilot. “When I take off in a plane, I often remember the boy who couldn’t even speak a sentence without stammering. If that boy can one day fly an aircraft, then nothing is impossible.” Known for calling himself the “Chief Enthusiasm Officer”, he believes leadership is measured not by control, but by purpose, optimism, and the energy one brings to uplift others.
From homelessness at 19 to becoming a multimillionaire entrepreneur; from addiction to meditation; from stammering youth to global keynote speaker; from serving tables to serving nations — Dushyant Savadia’s journey is a testament to reinvention. But more importantly, it is a testament to service. “To anyone searching for purpose and joy, my advice is simple: rechannel your energy and associate yourself with a higher cause. That’s where real happiness lies.” In every product Amber builds, every child educated, every community supported, and every disaster endured — his philosophy lives on: Business can be both profitable and profoundly good for society.
Afirst-generation entrepreneur with humble roots and a deeply held institution-building ethos, PSG Tech alumnus Mr. Maran founded KaarTech in 2005 and was later joined by three cofounders who shared his values. Under his leadership, the company has scaled into a 1000+ crore INR enterprise with a presence in more than 15 countries, a 2,500-member workforce and over 3,200 project engagements, earning recognition including South India’s CEO of the Year 2025 and CII Entrepreneur of the Year 2023. As he shapes the organisation’s next chapter, he is anchoring enterprise transformation in AI-augmented human judgment and driving a decisive shift from ERP services to outcome-driven operating systems.
KaarTech’s growth reflects Mr. Maran’s commitment to building a timeless institution anchored in discipline and execution excellence. The company has established a differentiated position in the global SAP market, delivering largescale S/4HANA programs and complex cloud transformations. His emphasis on tangible outcomes has democratised and productised SAP execution, supported by project-management rigor, governance and a clear understanding of enterprise complexity. This has shifted the firm from traditional services to an engineered, outcome-driven model of transformation. As KaarTech advances toward IPO readiness and its billion-dollar vision, it is strengthening leadership depth and talent density. A select 1% cohort is being groomed as future business owners, advancing outcome-based contracting. This governance-anchored model enabled resilience through the 2017 oil crisis, COVID and ongoing geopolitical shifts.
KaarTech’s global strategy is entering a decisive phase as the company expands beyond SAP into high-value adjacencies and shifts its operating model from SaaS to Service as Software, where engineered delivery and measurable outcomes take precedence over effort based execution. Guided by Mr. Maran’s expansion thesis, the next horizon focuses on three strategic markets

MARAN NAGARAJAN
Mr. Maran Nagarajan is a first-generation entrepreneur with a deeply rooted institution-building ethos, having scaled KaarTech into a 1,000-crore INR enterprise with a footprint across more than 15 countries. He has reshaped the firm’s operating model by transforming SAP execution into a disciplined, productized system anchored in governance, project-management rigor and clarity amid enterprise complexity. As KaarTech moves toward its IPO and billion-dollar ambition, he is embedding outcome-based contracting, strengthening next-generation leadership and architecting an AI-led Enterprise Operating System that unifies ERP, AI and data to deliver measurable, scalable business outcomes
BY MONALISA CHOUDHURY
supported by a strengthened S/4HANA foundation and growing capabilities in AI, Salesforce, and ServiceNow, along with the institutionalisation of AI across consulting and delivery. In the Middle East and North Africa, KaarTech is extending its leadership in oil and gas transformation while moving into public sector programs, government entities and Vision 2030 initiatives. Engagements with conglomerates, ministries and treasury governed IT budgets that emphasise In Country Value position the company as a strategic partner in a region undergoing accelerated economic transformation. In North America, the strategy is sharply verticalised. KaarTech is expanding its MENA proven execution strength into the Houston and Texas energy corridor and entering multi chain retail, food and beverage and mid market enterprises with Fortune scale ambitions. Growth is driven by selective inorganic expansion, acqui-hiring and capability development in commerce and data. Across Europe,
the company focuses on enterprises with significant operational complexity, including aerospace, defense, telecom and downstream petroleum, sectors that depend on predictable engineered execution aligned with KaarTech’s productised SAP model. KaarTech’s global posture is supported by two significant moves, the acquisition of a U.S.-based customer experience company and the securing of ₹250 crore in private equity funding, both of which strengthened its ability to align ambition with execution. As the company prepares for another round of private equity investment, its service-assoftware, outcome-driven model is setting the foundation for the next phase of global scale.
Employee experience sits at the center of Mr. Maran’s operating philosophy, reflected in the systems and governance practices he has institutionalised across KaarTech.
“MR. MARAN IS DRIVING KAARTECH’S SHIFT INTO AN OUTCOMELED ENTERPRISE OPERATING SYSTEM, DEPLOYING FORWARD ENGINEERING TEAMS, CODIFIED BLUEPRINTS AND INTELLIGENT AGENTS TO UNIFY ERP, AI AND DATA AND ENABLE DIRECT, MEASURABLE TOPLINE OR BOTTOM-LINE IMPACT”
He has established audit, compliance and risk committees, introduced company-wide OKRs and ensured transparent reporting on gross margins, PBT and utilisation. His emphasis on whistleblower protection, open leadership forums and regular audits reinforces integrity and accountability. This governance discipline is paired with a strong people focus. KaarTech’s inclusive, learning-driven culture, reflected in its Great Place to Work score of 89, is supported by structured development pathways that have advanced more than 2,500 employees.
Mr. Maran’s worldview is shaped by a childhood centered on education and sustainability, influenced by a professor father and a mother devoted to organic farming. He brings integrity, discipline and long-term orientation to leadership, drawing inspiration from institutionbuilders and leaders such as Narayana Murthy, Anna and Kalaignar. His values guide his social commitment through Kaar Arakattalai, a not-for-profit that provides scholarships, learning support and community uplift programs for more than 11,200 underprivileged children. They also inform KaarTech’s sustainability agenda, from Green IT adoption to ESG and carbon accounting in SAP-led programs.
Mr. Maran envisions KaarTech’s next chapter as a shift from ERP consulting to an outcomedriven Enterprise Operating System that redefines how transformation is executed. He is designing a model where Forward Deployed Engineering teams, supported by deployable blueprints and intelligent agents, accelerate delivery, reduce execution risk and enable impact-based pricing. AI serves as the intelligence layer within this model, amplifying human judgment by providing employees co-pilots, offering customers AI-enabled control towers and enabling programs to navigate legacy complexity. By unifying ERP, AI and data, he aims to deliver orchestrated, measurable transformations tied directly to topline or bottom-line results.
Growing up on a farm in Fiji, Prof, Naidu observed how closely human wellbeing is tied to the land and water. He understood at a young age that healthy soil and clean water are essential for strong communities, while polluted or poorly managed environments put people’s livelihoods at risk. These early experiences inspired his passion for environmental science and motivated him to pursue practical, science-driven solutions to ecological challenges. “My motivation came from seeing how closely human wellbeing depends on the environment, and I built my standing through integrity, collaboration, and solution-focused science,” he reflects.
Prof. Naidu’s career has been guided by scientific integrity, community responsibility, and socially beneficial innovation, forged through senior scientific leadership at Australia’s national science agency, CSIRO— where he rose to Chief Research Scientist at an unusually early stage—followed by the establishment of a centre of research excellence at the University of South Australia and his subsequent appointment as a Distinguished Professor at the University of Newcastle. These experiences laid the foundation for crcCARE, a research organisation designed not just to conduct experiments but to deliver tangible solutions for industry, regulators, and communities alike. crcCARE’s mission revolves around technical and scientific rigour, practical application, and partnerships that translate research into real-world impact..
A goals-driven leader, Prof. Naidu’s shortterm goal for his organisation is to advance next-generation remediation technologies, strengthening industry and government partnerships, and providing evidence-based guidance to support regulatory decisions. In the long term, he aims to make crcCARE a global leader in soil health, sustainable remediation, and emerging contaminant management, while expanding its planetCARE Academy to deliver environmental training and capacity-building worldwide. “I shaped crcCARE around honesty in science, responsibility to community, and innovation that protects people and the environment. Our long-term goal is to secure and extend crcCARE’s role as a globally leading centre of excellence, shaping the future of sustainable remediation and environmental protection,”

RAVI NAIDU
Professor Ravi Naidu, Managing Director and CEO of crcCARE, has emerged as a global authority in environmental remediation. The seasoned leader’s journey epitomises a remarkable saga of vision and perseverence. From humble beginnings on a small Fijian farm, he has ascended to global prominence, steering one of the world’s most esteemed environmental research organisations. Renowned for his steadfast commitment to rigorous science that safeguards both human health and the environment, his success story speaks of perseverance, sagacity, and transformative impact on ecological sustainability
BY MONALISA CHOUDHURY
he says. crcCARE, under his direction, operates across several critical functional areas, addressing some of the most urgent environmental issues of our time. These include contaminated site assessment, associated risks and remediation, PFAS and emerging contaminant management, soil health and sustainable land management, groundwater protection, and environmental risk assessment. Capacity-building is another central focus, with programs such as the planetCARE Academy and global masterclasses designed to train the next generation of environmental leaders.
According to Prof. Ravi Naidu, crcCARE stands out for its ability to integrate research, technology, policy, and industry collaboration under one umbrella. Unlike organisations that focus solely on academic outputs, crcCARE translates science into practical, cost-effective solutions that can be deployed immediately. Its international network ensures access to world-class expertise, while multidisciplinary teams of chemists,
soil scientists, engineers, toxicologists, and data specialists provide holistic solutions to complex environmental challenges.
MENTORSHIP
Prof. Naidu has guided over 70 PhD graduates and hundreds of early-career researchers, many of whom now occupy influential roles in government, academia, and industry worldwide. His work extends beyond research to global initiatives, including collaborations with the FAO, UNEP, and various international soil health programs, reinforcing the influence of science on policy and practice.
Prof. Naidu is a rare scientist who seamlessly integrates world-class research with tangible outcomes, working at the interface of industry and policy to help organisations balance growth with environmental responsibility. By demonstrating the long-term benefits of remediation and sustainability, he has successfully encouraged industries to invest in environmental protection. Programs like Australia’s Cooperative Research Centres
“MY MOTIVATION TO BUILD crcCARE CAME FROM SEEING HOW CLOSELY THE WELL-BEING OF MANKIND DEPENDS ON THE ENVIRONMENT, AND I BUILT MY STANDING THROUGH INTEGRITY, INDUSTRY COLLABORATIONS, AND SOLUTION-FOCUSED SCIENTIFIC WORK”
model have enabled crcCARE to raise substantial funds through collaborative projects aligning industry, government, and research objectives. Under his guidance, crcCARE has developed advanced technologies with the potential to change environmental outcomes across the AsiaPacific and beyond. The organisation has pioneered solutions for breaking down PFAS chemicals—persistent fluorochemicals found in non-stick cookware and firefighting foams—into non-toxic substances. Similarly, innovative approaches for cleaning up toxic metal contamination in soil and groundwater are being deployed in multiple countries. These cost-effective solutions are also adaptable for small farms and communities in developing nations. He works to introduce environmental science concepts into academic curricula and runs competitions for school students to spark early interest in sustainability. By mentoring young researchers and training professionals worldwide, he is nurturing a new generation of environmental leaders. He urges future environmental scientists to prioritise sustainability and embrace their responsibilities earnestly. “The sustainability of the environment very much relies on how seriously they take the environment and what they can do,” he stresses.
Prof. Naidu has been named a Highly Cited Researcher by Clarivate every year since 2019, placing him among the top 1% of environmental scientists globally. His work has been recognised through numerous prestigious international honours, including the World Soil Prize awarded by the UN Food and Agriculture Organization for outstanding contributions to soil health and sustainable land management. He is also a Fellow of the National Science Academies of Australia, India, and New Zealand, a recipient of the Mahatma Gandhi Sanman Award, and has been elected to numerous leading scientific societies in recognition of his scientific leadership and global impact. Under his leadership, crcCARE has also received numerous accolades for its pioneering research in PFAS remediation, emerging contaminant management, and environmental training, with its technologies and capacity-building initiatives gaining global recognition.
When Dr. Santosh assumed his role at Kansai Plascon Uganda Limited, he embarked on a journey that required steady hands and an open mind. Uganda’s business environment, with its infrastructural constraints, currency fluctuations, and supply chain uncertainties, demanded more than standard strategies. He soon realised that long-lasting progress would require building strong relationships across cultures and experiences. “Over the last 23 years with Kansai Plascon Uganda, my Indian roots have given me both strength and flexibility; these qualities became vital in adapting to Uganda’s unique business environment,” he reflects.
From the start, the leader prioritised presence and consistency over rigid policies. Immersing himself in day-today operations, from the factory floor to customer interactions, he built trust through action. During the COVID-19 pandemic, this approach proved crucial. While markets wavered and logistics faced interruptions, he guided his team with calm, empathy, and decisive action, ensuring continuity while keeping confidence intact.
For Dr. Santosh, leadership is not theoretical. It is lived and practiced daily. “I measure success not by personal milestones but by how many others I help to realise their potential,” he explains. The leader champions an environment where autonomy is a right, not a reward. He encourages his employees to take decisions, question norms, and explore beyond traditional role boundaries. Mentorship, resources, and psychological safety form the scaffolding for all achievements. He encouraged his staff to make decisions, voice ideas, and experiment without fear of failure. This approach has also helped Kansai Plascon become East Africa’s largest paint company, driven by a workforce that balances local insight with global standards.
This transformation is also driven by his emphasis on skill development. The leader invests in learning opportunities for his employees, both in-house and through collaborations. Partnerships with organisations such as Perk of the Job in the UK provide access to e-learning platforms and practical training. Additionally, cross-department rotations, mentorship programmes, and international exposure broaden expertise and prepare employees for future challenges.

DR. SANTOSH GUMTE
Dr. Santosh Gumte, Managing Director of Kansai Plascon Uganda Limited, has charted a remarkable saga of leadership driven by empathy, resilience, and inclusivity. Since taking the helm, he has reshaped the company into a peopledriven pillar where trust, operational efficiency, and purposeful engagement are lived realities. His leadership saga is one of empowering others, where every initiative is designed to nurture talent, promote collaboration, and drive sustainable growth. “Leadership is less about authority and more about creating the conditions for others to excel,” he says
BY MONALISA CHOUDHURY
At Kansai Plascon, career growth encompasses much more than technical skills. Dr. Santosh ensures progression is flexible, based on individual strengths, team needs, and strategic objectives. He consistently encourages his employees to take initiative, contribute beyond their immediate roles, and align personal growth with organisational goals. By doing so, the leader has built a culture where responsibility, recognition, and performance thrive together.
Under the leadership of Dr. Santosh, Kansai Plascon dedicates approximately UGX 2 billion every year to community programmes aimed at enhancing skills, creating opportunities, and restoring dignity. Its painter training initiative alone empowers around 10,000 individuals annually across Uganda and neighbouring countries, equipping them with practical skills to secure sustainable livelihoods. Apart from this, the company contributes significantly to
public infrastructure, offers paint donations and technical expertise to schools, hospitals, places of worship, and community spaces, thereby improving both functionality and aesthetic appeal.
Sports and cultural development are also an integral part of his CSR initiatives, with collaborations involving the Uganda Olympic Committee, local athletes, and regional kingdoms through tree planting, health drives, and heritage restoration, fostering talent, wellness, and social cohesion.
Through his company, the benevolent leader supports infrastructure development by setting up regional centres for painters’ associations with equipment and guidance. Additionally, partnerships with architects and designers improve industry standards and create professional growth opportunities.
Dr. Santosh prioritises diversity and inclusion. Under his guidance, Kansai Plascon actively recruits talent from
“UNDER DR. SANTOSH’S LEADERSHIP, KANSAI PLASCON HAS WITNESSED REMARKABLE GROWTH. THE COMPANY STRICTLY ADHERES TO UGANDA NATIONAL BUREAU OF STANDARDS, NEMA, AND ISO REQUIREMENTS TO DELIVER SAFE, HIGH-QUALITY, AND DURABLE RESULTS”
different backgrounds, ensuring men and women hold leadership and key operational roles. This approach encourages creativity, integrity, and consistent performance while maintaining fairness and respect. His leadership philosophy is shaped by humility and experience, with early lessons from home and cross-cultural interactions in Uganda teaching him that true strength comes from amplifying others’ potential. Even mistakes, such as an operational error at the Namanve plant, became opportunities for learning, and demonstrated that innovation thrives when pride is set aside and teams are empowered to find effective solutions.
Dr. Santosh is clear about the priorities for the next generation of African business leaders. He emphasises that empowerment is essential, not optional. According to him, investing in people, promoting inclusive cultures, supporting community-focused initiatives, and listening carefully are crucial to building sustainable organisations. “True success comes when teams feel valued, capable, and motivated to contribute meaningfully,” he says.
At Kansai Plascon, every initiative, whether training programmes, social projects, or industry engagement, is treated as a lever for long-term transformation. Profit and purpose go hand in hand, with empowerment acting as a catalyst that creates lasting opportunities for employees, communities, and the wider economy.
Dr. Santosh’s dedication and business acumen have earned him several awards and accolades. He was recognised by the Indian Business Forum, Kampala, for his exceptional contributions to social development through CSR initiatives and sports sponsorships. He was also listed among Africa’s 10 Most Empowering Business Leaders. Under his stewardship, Kansai Plascon received the prestigious Paint Company of the Year award from KACITA. The leader has recently graduated with a Doctorate in Strategic Management, further strengthening his expertise and strategic vision in driving business growth and impact.
SHEKHAR NATARAJAN

Long before artificial intelligence became a public obsession, Chandrashekar “Shekhar” Natarajan was already designing the systems that learned, adapted, and made decisions at scale. Growing up in a family of 8, in a single room home in the slums of south-central India, Natarajan experienced an environment where formal infrastructure was unreliable and systems often failed under pressure. When monsoons flooded the streets, there was no expectation that help would arrive on schedule. But the world didn’t grind to a halt; instead, need and ingenuity reigned. Neighbours worked together to solve problems through improvisation rather than process
BY MONALISA CHOUDHURY
His father worked by riding his bicycle across the city to deliver telegrams.
A telegram often meant urgent news: a death in the family, a medical emergency, or a money order sent home. To do his job, he navigated dense neighbourhoods and learned to read people before speaking. Many recipients could not read the telegram themselves, so he read the messages with care and kindness. Accuracy and efficiency mattered but so did how the message was delivered.
Years later, when Natarajan would try to explain why logistics felt personal rather than technical, he would return to moments like that. Long before he encountered the term, he learned that moving information or goods carried weight. Delivery involved judgment, meaning, and accountability.
Those lessons resurfaced as his career progressed, from factory floors to executive offices to the design of artificial intelligence systems.
India exposed Natarajan to large-scale coordination early in life. Scarcity made efficiency necessary, but it also made cooperation unavoidable. Informal networks filled the gaps where official systems fell short. Shared transport, shared labour, and shared responsibility were common features of daily life.
He watched supply chains in action. Take, for example, the Mumbai dabbawallas who, every day, deliver thousands of homecooked meals across the city via handcart and bicycles, with near-perfect accuracy. The system relies on people rather than software.
Systems like these reinforced an idea that stayed with him for years: well-designed systems work when people understand how to adapt them. Human judgment was not a flaw to be eliminated. It was the mechanism that allowed systems to function under uncertainty.
If his father demonstrated how systems move, Natarajan’s mother showed him how systems can change. She left school early to help raise her orphaned sisters and learned firsthand how rigid rules can limit opportunity. When a policy restricted admission to the city’s top school to two children per family, Natarajan’s two older brothers were accepted, but he was not.
For nearly a year, Natarajan’s mother returned to the education minister’s office each morning, timing her visits to coincide with his routine. With pressure, the decision was reversed and he was admitted, but the tuition—thirty rupees—was more than the family could spare.
So his mother pawned a silver toe ring that symbolised her marriage to cover the
“NATARAJAN IS REDEFINING INTELLIGENCE BY EMBEDDING HUMAN JUDGMENT, ACCOUNTABILITY, AND ETHICAL DESIGN INTO ENTERPRISE SYSTEMS. THROUGH LEADERSHIP AT ORCHESTRO, HE CHAMPIONS TRUSTED, TRANSPARENT INTELLIGENCE DELIVERING ENDURING SOCIETAL IMPACT”
cost.
The episode stayed with him longer than most decisions made on paper. It showed Natarajan that systems are not immovable. Persistence, restraint, and care can reshape them, even when resources are limited.
Years later, as Natarajan studied industrial engineering at Georgia Tech and began building complex operational systems, that lesson remained relevant. Efficiency and scale mattered, but so did fairness, access, and discretion.
Natarajan built his career inside global enterprises that managed vast, complex supply chains. He worked on routing decisions, warehouse optimisation, workforce planning, and carrier selection long before artificial intelligence became mainstream.
Over time, these systems began making more decisions autonomously. Models inferred outcomes and recommended actions with growing confidence, steadily narrowing the role of human judgment.
He did not object to automation itself. What concerned him was the steady shift toward systems that replaced judgment instead of supporting it. Logistics was simply where the problem surfaced first. The deeper flaw was architectural: Intelligent systems were scaling capability without accountability.
That concern crystallised during a visit to a large distribution center in the United States.
By then, Natarajan held a senior leadership role. Instead of observing from an office, he chose to work alongside frontline staff.
One day, a woman was assigned to give him a tour of the factory floor. She was a single mother of two who walked nearly 14 miles of conveyor belts each shift as a supervisor. But her primary concern wasn’t productivity metrics. It was her children.
Phones were prohibited on the warehouse floor. If something happened at school, she would not know until her break.
Natarajan carried two phones—one for work, one for family. No one questioned it. The contrast was difficult to ignore. The system relied on her speed, precision, and
problem-solving ability, yet did not trust her with a device that allowed her to respond to emergencies involving her children. The policy was designed for control rather than context.
That experience sharpened a question that would define his thinking: why do intelligent systems demand accountability from people while stripping away their agency?
Within technology circles, inefficiency is often attributed to human behavior. From Natarajan’s perspective, that framing misses the point. The real risk lies in systems that treat people as noise rather than signal.
Supply chains function because people intervene when systems fail. Drivers reroute shipments based on local knowledge. Warehouse leads adjust workflows when software breaks down. Operations teams coordinate through informal channels when official tools fall short. These actions rarely appear in dashboards, but they prevent disruptions from escalating.
Machines excel at precision, but people excel at adaptation. When systems are designed without acknowledging that distinction, performance suffers.
With degrees from Georgia Tech and Harvard, Natarajan went on to hold senior leadership roles at PepsiCo, The Walt Disney Company, Walmart, and Target. By the time he founded Orchestro in 2023, Natarajan had shifted his focus from optimising efficiency to rethinking what intelligence itself should mean.
He observed a recurring pattern across industries: Current AI optimises for what we can build—scale, speed, impressive demonstrations—producing systems that dazzle in controlled settings yet cannot deploy where human dignity matters most. Regulated industries are blocked by opacity, mission-critical applications halted by stochasticity, enterprises paralysed by irreproducibility wherever decisions affect human welfare and regulatory oversight is mandatory. The architecture is fundamentally flawed: compression destroys the context
that enables understanding, monolithic transformers waste computational resources on every task, and ethics applied as afterthought creates permanent tension between capability and alignment.
That realisation led him to articulate what he calls Angelic Intelligence—a universal design layer intended to embed judgment, restraint, and moral reasoning into intelligent systems from the start. The Angelic Intelligence framework inverts this paradigm across ten dimensions—preservation over compression, heterogeneous agents over uniformity, native virtues over posthoc constraints—producing transparent, deterministic, enterprise-ready systems deployable in any regulated context where current AI is blocked.
“We stand at a choice Silicon Valley’s quarterly imperatives rarely permit,” Natarajan states. “Continue refining systems built on speed without safety or rebuild on foundations where human flourishing is embedded directly into the mathematics, measured over generations rather than quarters, optimised as the primary objective rather than applied as afterthought.”
Artificial intelligence now shapes decisions across industries measured in trillions of dollars and profound human consequence. Logistics offers a visible example, but the same weaknesses appear wherever systems operate without transparency or accountability.
Natarajan believes the next phase of AI will depend on shared intelligence — systems that allow local context and human judgment to inform decisions rather than concentrating authority in opaque models.
In this model, exceptions are not errors. They are evidence. Human overrides become signals for learning rather than failures to suppress.
AsiaOne’s recognition places Natarajan among prominent global leaders from government and industry. But for someone who watched his father deliver telegrams on a bicycle and his mother reshape
“NATARAJAN HAS PIONEERED ‘ANGELIC INTELLIGENCE,’ A REVOLUTIONARY FRAMEWORK THAT EMBEDS MORAL REASONING DIRECTLY INTO AI. DRAWING ON HIS EXECUTIVE LEADERSHIP, HE HAS SUCCESSFULLY REDESIGNED INTELLIGENT SYSTEMS TO SUPPORT HUMAN JUDGMENT RATHER THAN REPLACE IT”

bureaucratic systems with nothing but persistence, the acknowledgment carries a particular resonance.
The recognition reflects not only the scale of his work, but a willingness to question how intelligence should be designed before it is deployed at civilisational scale. In an industry racing toward capability, he argues for pausing to ask: capability for what purpose, and at what human cost?
This is not abstract philosophy. Every day, AI systems make decisions that affect whether someone receives a loan, gets hired, qualifies for parole, or receives medical treatment. These systems operate at speeds that eliminate human review and at scales that multiply bias. Natarajan’s question cuts through the technological enthusiasm: if we cannot explain how a decision was made, do we have the right to make it?
The principles guiding his work trace back to those early lessons. From his father, he learned that delivery requires care, especially when messages are difficult. From his mother, he learned that rigid systems can be reshaped through patience and resolve. From that woman walking fourteen miles a day without a phone, he learned that dignity and trust are not benefits to grant workers when convenient—they are operational requirements for systems that actually work.
Every morning at 4 AM, Natarajan practices classical Indian painting in his studio. It’s the same discipline his grandfather taught him—precise brushwork, patient layering, attention to detail that cannot be rushed. One stroke at a time, building something meant to last.
His five-year-old son sometimes wakes early and watches from the doorway. He doesn’t ask about AI architectures or enterprise deployment. He asks simpler

questions: “Why do you wake up so early? Why does it take so long?”
Natarajan’s answer is always the same: “Because some things can’t be rushed. Because we’re building for you.”
That tension—between the patient work of building things that endure and the pressure to ship things that scale—defines the current moment in artificial intelligence. Silicon Valley measures success in quarters.
Natarajan measures it in generations.
Current AI asks: “Can we build it?” Angelic Intelligence asks: “Should we build it, and if so, how do we build it to last?” The difference determines whether we optimise for quarterly earnings or generational impact. Whether we treat ethics as compliance checkbox or computational foundation.
This is why Natarajan describes his work as building “with love, not speed.”
Love, in this context, is not sentiment—it is the rigorous commitment to designing systems that preserve human agency rather than replace it. That augment judgment rather than eliminate it. That succeed not by removing people from decisions, but by giving them better tools to make those decisions well.
As AI systems move from recommendation to action, the stakes compound exponentially. Autonomous vehicles, predictive policing, credit algorithms, medical diagnostics— systems making thousands of decisions per second, each affecting human lives. Systems that cannot pause, reflect, or account for consequence will inevitably optimise in the wrong direction when stakes are highest.
The future of Artificial Intelligence will belong to systems that understand when restraint matters most. When to recommend versus decide. When to assist versus replace. When to optimise versus preserve. These distinctions require embedding human values not as safety features to add later, but as architectural foundations to build upon from the start.
Natarajan’s mother pawned her wedding ring so he could attend school. His father read telegrams with compassion to people who couldn’t read them themselves. Every morning, he wakes before dawn to practice an art form that cannot be automated, cannot be optimised, and cannot be rushed.
Decades later, their son is building intelligence systems for a world where algorithms make decisions his parents’ generation would never have imagined possible.
The question that drives his work—the question his five-year-old asks from the doorway each morning—is whether those systems will be built with the patience required to make them worthy of the world his son will inherit.
Angelic Intelligence is his answer: a framework for systems that last not because they are unbreakable, but because they bend the way his mother’s persistence bent systems—with care, with purpose, and with the understanding that the hardest problems cannot be solved in a quarter. They require the discipline of 4 AM painting sessions. They require building for the child watching from the doorway.
What distinguishes Mr. Mishra is not the number of ventures he leads, but the nature of the systems he builds. His significance stems from the challenges he chooses to embrace. Unlike many business leaders operating within stable markets, his strength lies in steering through fragmented markets with evolving institutions. He is an expert in navigating fragile markets where regulations are evolving and trust must be earned daily. This ability to translate complexity into functional, scalable frameworks positions him as a true global leader. Across multiple jurisdictions, Mr. Mishra has played a quiet but consequential role in building governance-led operating systems, bringing compliance discipline to emerging technologies, structuring capital deployment in high-risk markets, and aligning enterprise growth with policy and regulatory realities. His remarkable efforts have enabled organisations, governments, and SMEs to function credibly within global frameworks, thereby making his impact systemic rather than episodic. It is this ability to impose order, continuity, and institutional credibility in volatile context that places the leader’s outstanding contributions firmly at a global level.
Before founding Octagon International FZCO, Mr. Mishra held senior leadership roles at International Business Systems (MEA) and Redington Gulf (Africa). In these roles, he led large-scale operations across the Middle East & Africa. These roles placed him at the frontline of emerging markets that required not just operational excellence but institutional thinking, aligning global technology frameworks with local compliance, procurement realities, and geopolitical sensitivities. It was here that his reputation as a systems-level leader took shape.
In 2013, Mr. Mishra founded Octagon Ventures to nurture early-stage startups through capital infusion, mentorship, and strategic guidance. His investment portfolio spans fintech, blockchain, legal tech, AI, edtech, and consumer services, reflecting both a curiosity about emerging ideas and a discipline in choosing ventures with sustainable potential.
Under his quintessential leadership, Octagon International evolved from a regional IT distributor into a multi-vertical global enterprise spanning IT hardware,

SUKANT MISHRA
A veteran of multiple sectors, Mr. Sukant Mishra serves as the Managing Director of the UAE-based Octagon International FZCO, a fast-growing independent wholesale distributor of IT products, founded in 2006. A forward-thinking leader, his 25-year saga across continents and industries places him firmly in the top echelon and uppermost tier of contemporary business leadership. Through calibrated expansion, capability-building, and cross-sector collaboration, Mr. Mishra has driven numerous enterprises toward the acme of excellence and emerged as a truly global leader defined by foresight, governance, and enduring value creation
BY MONALISA CHOUDHURY
ERP, electronics, fintech, and enterprise solutions. Today, the company serves governments, system integrators, and private corporations across the Gulf, Africa, and South Asia. Its growth reflects a disciplined focus on governance, risk management, and long-term partnerships rather than opportunistic expansion.
Over the years, Mr. Mishra has worn multiple hats as a founder, chairman, investor, and board advisor. As Chairman of Octagon International Holdings UK, he leads long-term cross-border value creation. At Infinity Worldwide UAE, he has revived and restructured businesses navigating difficult market cycles. Additionally, through Systematix FZCO, he oversees AI-led enterprise intelligence and automation solutions. Likewise, through Prajñ ā Consultancy, he advises mid-sized and international firms on legal compliance and governance,
bridging gaps between markets in India and the UAE.
Mr. Mishra’s approach to technology is grounded and purposeful. He views AI, blockchain, ERP, and automation not as buzzwords, but as practical tools to solve real-world problems. Across ventures such as Locus AI, Finometric Solutions, Aqua Systems, APSL, and Waith Inc., he focuses on applying AI, blockchain, ERP, and automation to real-world challenges. His work addresses data security for enterprises, blockchain compliance frameworks, AI-driven logistics optimisation, and digital transformation for SMEs across India, the UAE, North America, and Europe.
Mr. Mishra also plays an active role in policy dialogue and national development. As an advisor to the MSME Council, he
“DEMONSTRATING SHARP STRATEGIC VISION & CONSISTENT LEADERSHIP EXCELLENCE, MR. MISHRA HAS EARNED HIS PLACE AMONG THE CRÈME DE LA CRÈME OF GLOBAL BUSINESS LEADERS. HE IS ADMIRED FOR DRIVING GROWTH, INNOVATION, AND INSTITUTIONAL CREDIBILITY OVER DECADES”
collaborates with government and industry stakeholders to accelerate digitisation, strengthen entrepreneurship, and expand SME participation in global value chains. He actively supports national initiatives such as Viksit Bharat, Startup India, and Digital India to contribute both strategic insight and executional depth.
Beyond corporate leadership, Mr. Mishra’s philanthropic work has had a tangible impact. His social impact mirrors the same systems-driven approach. He has personally funded over a thousand dialysis treatments in India. Through the Vidya & Child initiative, he supports education and mentorship for underprivileged children. His long-standing association with the Red Cross Cancer Aid Program ensures continued care for patients in recovery.
Mr. Mishra’s contributions have been widely and enthusiastically recognised through several prestigious, highly coveted, and industry-defining awards, including the Asia Business Leader Award and Outstanding Entrepreneur of the Year. These awards reflect not only business success but also long-term value creation. Under his stellar leadership, his organisation has been acknowledged among the Most Innovative Companies of the Year.
Other than his remarkable corporate achievements, Mr. Mishra has played a substantial role in strengthening India’s MSME ecosystem. The Gujarat Chamber of Commerce has formally recognised the leader’s exemplary efforts in supporting SMEs, particularly through capacity building, industry formalisation, and initiatives that promote long-term, sustainable growth and development.
Featured in Entrepreneur.com’s “Follow the Leader” series, and regularly appearing on ET Now, Times Now, and ZEE TV, Mr. Mishra stands out not for visibility alone, but for institutional credibility built over decades of visionary leadership and consistent business excellence. His work has inspired a new generation of entrepreneurs, besides setting benchmarks in both innovation and responsible leadership.
In an era defined by volatility and complexity, Mr. Sandhu exemplifies a leadership style that is both inspiring and enduring. His impact stretches across sectors and regions, uniting purpose with performance in everything he does.
Over the years, Mr. Sandhu has built a legacy grounded in precision, discretion, and disciplined execution. Whether improving regulations, mentoring future leaders, or developing modern learning solutions, he has shaped both institutional practices and the principles behind them. The leader’s journey began in the corridors of academia, but it didn’t take long before he became a prominent figure in national policy forums and business leadership circles. With advanced qualifications in law, cybersecurity, and education, among many others, he built a foundation that was as multidimensional as it was future-ready.
Before establishing himself as a top-tier business leader, Mr. Sandhu served in key roles at prominent organisations, including ASQA (Australian Skills Quality Authority), where he contributed to maintaining business systems, and the Department of Education and Training (DET). He also worked with Navitas, a global leader in education services, and the Australian Catholic University (ACU), where he supported academic and institutional excellence. Additionally, he lent expertise to several other multi-billiondollar organisations, playing a pivotal role in driving growth, compliance, and operational success.
With Career Calling International and CAQA, the leader has developed smart systems, risk management tools, and AIdriven solutions to help organisations thrive in complex environments while remaining ethical and sustainable. By integrating Gen AI, cybersecurity, and advanced risk management into his offerings, he aims to stay ahead of industry trends and keep his ventures at the forefront of innovation.
In his current role, Mr. Sandhu brings exceptional precision and people-first leadership to the table. His ventures offer end-to-end solutions for educational institutions, from curriculum development and RTO setup, to audit preparation and professional training. What sets him apart is his commitment to building platforms, not just products.
As an innovation-driven leader, Mr. Sandhu has structured his organisations

SUKH SANDHU
Mr. Sukh Sandhu, the CEO of Career Calling International and CAQA, is a revered figure across Australia’s education, compliance, and entrepreneurial arenas. With over 30 years of experience in education, compliance, policy, and innovation, his success story exemplifies smart and forward-thinking leadership. A trusted strategist, compliance expert, and educational visionary, Mr. Sandhu’s career exemplifies how silent reformers often spark the loudest revolutions. The wellversed serial entrepreneur has earned numerous prestigious accolades that mirror his dynamic career
BY MONALISA CHOUDHURY
impeccably to outlast trends, focusing on long-term growth rather than short-term gains. Whether working with educational institutions or developing policy templates widely adopted across the sector, he consistently positions himself and his clients well ahead of others. His influence extends beyond major cities. Under his guidance, Career Calling International has worked with providers in remote areas to make sure quality education is accessible everywhere. This expansive footprint reflects his unwavering belief in inclusive excellence without compromise.
As the architect behind numerous audit systems, national compliance frameworks, and bespoke training modules, Mr. Sandhu has led the shift from reactive compliance to proactive quality management. His work has shaped the operational models of countless RTOs (Registered Training Organisations) and CRICOS providers, many of whom
now follow the templates and protocols his companies have designed. Government bodies often turn to him for expert guidance, which reflects his strong standing in the field. Through workshops, reports, and public talks, Mr. Sandhu has worked to improve standards across the sector, thereby promoting a culture that values both integrity and innovation.
Mr. Sandhu’s vision for the future is built on three core values: doing things with integrity, designing with innovation, and reaching people through inclusion. With a strong sense of ethics and a clear vision, he is helping shape the next wave of changemakers. The leader firmly holds that real change doesn’t start with technology or people alone. It happens when they work hand in hand. Guided by this belief, he has built platforms to improve compliance, enhance learning, and help organisations stay ahead.
“MR. SANDHU’S VISION FOR THE FUTURE IS BUILT ON THREE CORE VALUES: DOING THINGS WITH INTEGRITY, DESIGNING WITH INNOVATION, AND REACHING PEOPLE THROUGH INCLUSION. WITH A STRONG SENSE OF ETHICS AND A CLEAR VISION, HE IS HELPING SHAPE THE NEXT WAVE OF CHANGE-MAKERS”
Behind every innovation is Mr. Sandhu’s genuine care for people. Those who have worked with him consistently note his open-minded approach and trustbased leadership. He stays calm, clear, and supportive while mentoring young professionals, advising policymakers, or guiding senior educators.
His leadership is not only effective, but also leaves a lasting impact. Many of those he has mentored went on to build successful businesses of their own, often stating that they wouldn’t have achieved their success without his support during crucial moments in their journey.
While many leaders aim for slow, steady progress, Mr. Sandhu thinks on a much bigger scale. In the coming years, he aims to utilise AI to enhance education, develop smarter compliance tools, and make quality assurance training more accessible throughout the Asia-Pacific region.
Mr. Sandhu’s work has earned widespread recognition across leading industry platforms. He has been featured in top publications and honoured for his excellence in compliance, education, and leadership. His consistent impact can be seen in his association with high-performing executives and thought leaders.
A proactive leader, Mr. Sandhu refuses to rest on past laurels. He leads with a clear intent to stay ahead by driving progress in evolving standards, emerging technologies, and the changing needs of learners and institutions. Recently, he was named among the Top 10 Empowering Business Leaders to Watch in 2025 by Time Iconic Magazine. His selection as a Forbes Business Council Member in 2025 highlights his impact on multimillion-dollar projects across the four continents.
His other distinctions include Business Leader of the Year, Asia Pacific CEO of the Year, and recognition among the Top 121 Educators globally. Mr. Sandhu has also contributed as Editor of The VET Sector, authored thousands of articles and creative works, and launched cutting-edge programs in AI and workforce development. As a prolific writer, the versatile leader has composed over 35,000 poems and 550 stories.

These outcomes don’t come from artificial intelligence alone. They come from how publishing work is designed, governed, and experienced, by publishers, authors, and partners.









When Publisher Experience is thoughtfully designed, it strengthens Operational Excellence. And when those same flows extend outward, Author Experience improves, without adding friction. Lumina Datamatics helps publishers embed artificial intelligence within publishing workflows, where governance, quality, accessibility, and human expertise are built in from the start.
About Lumina Datamatics:
Globally, 8 of the top 10 academic publishers and 3 of the top 5 ecommerce retailers trust Lumina Datamatics as their strategic partner in providing content, analytics, and technology solutions. Lumina Datamatics’ expert solutions comprise in-house platforms, partnerships with global technology leaders, and more than 7,000+ professionals across Germany, India, Philippines, UK and United States. Our clients have reduced time-to-market, optimized business processes, operational efficiencies, and improved competitiveness.
Mr Bala V. Sathyanarayanan’s career reflects purpose and deep respect for people. As Chairman of Balmer Lawrie–Van Leer and EVP & CHRO at Greif, Inc., the industry veteran has built organisations where performance aligns with empathy, service-driven leadership, accountability, and diverse global operations
Mr. Sathyanarayanan’s academic path spans an Engineering degree, an MBA from the University of Madras, a Master of Human Resource Management from Rutgers University, and completion of the Advanced Management Program at Harvard Business School. His academic brilliance and international exposure equips him to guide enterprises with both intellect and sensitivity.
Across industries, his stewardship has encouraged cultures where individuals understand their purpose and their contribution. At Greif, he has helped steer a multi-year cultural shift across 40 plus countries, during which engagement outcomes have advanced into the upper quartiles globally. His leadership framework, the 3C model of Clarity, Care, and Consistency, anchors his philosophy.
He explains that clarity links intentions to action, care signals belonging, and consistency cultivates trust. His style includes working alongside teams, demonstrating the standards he expects, and reinforcing the belief that recognition and accountability are tributaries of the same current. Under his influence, Greif strengthened its talent priorities, expanded analytical capabilities, and developed a diversity, equity, and inclusion (DEI) structure that enables individuals to contribute authentically.
Mr. Sathynarayanan’s professional path spans prominent organisations, including Hewlett-Packard, Coca-Cola, Avaya, United Technologies, and Xerox Corporation. In each setting, he balanced strategic reasoning with the capacity to understand how people respond to change. As Chairman of Balmer Lawrie – Van Leer Ltd., he supports governance that prizes integrity and responsible expansion. He also participates in boards such as the Gartner CHRO Global Leadership Board, the Centre on Executive Compensation, and the Columbus Council on World Affairs, contributing insights on workforce dynamics, ethics, and organisational adjustments. For

many, his example illustrates that achievement is not a finish line but a continuous progression shaped by service.
Mr. Sathyanarayanan’s perspective on leadership extends beyond earnings, asserting that sustainability is a core business necessity. Under his leadership, circular economy ideas have been woven into Greif’s operations, and ongoing work has reduced the company’s environmental footprint. Leadership expectations now align directly with ESG targets, strengthening transparency, oversight, and measurable outcomes.
He advocates for board structures that encourage inclusive thought and reinforce standards for safety, compliance, and principled decision-making. These practices have advanced Greif and Balmer Lawrie – Van Leer as reference points for industrial organisations seeking to align commercial goals with societal expectations.
Mr. Sathyanarayanan’s early experiences taught him resilience and humility, and reinforced his belief that true leadership involves helping others identify their capabilities. Looking ahead, he aims to build institutions driven by empathy, creativity, and sustainable thinking. He guides future leaders to be both digitally skilled and emotionally aware, knowing that real, lasting progress comes from balancing the two. Through the steady application of clarity, care, and consistency, he continues to broaden the meaning of leading with purpose in a world that is constantly reshaped by new expectations.
APh.D. from IIM Ahmedabad and an M.A. (Gold Medallist) with an M.Phil. from Delhi University form the academic foundation of Dr. Verma’s career. His earlier responsibilities at Nirma University, IIM Ranchi, IMI Delhi, and MDI Gurgaon allowed him to guide academic processes, strengthen industry relationships, and contribute to institutional planning.
At FORE, Dr. Verma encourages a learning environment that blends academic rigor with practical engagement. Students get the opportunity to participate in curricular, co-curricular, and extracurricular activities that broaden their competencies. His ongoing contributions to research ensure that the classroom incorporates contemporary developments and relevant insights.
Training is a core element of Dr. Verma’s professional identity. More than one hundred workshops have been conducted for senior and middle-level managers across major PSUs, scheduled banks, and multinational subsidiaries. Sessions have covered leadership, negotiation, conflict management, and team effectiveness.
Consulting engagements with BrahMos Aerospace, Union Bank of India, Nestle India, Siemens Power, Star TV–National Geographic Channel, SMEC India, Kampsax, Lanco Infratech, the Government of Jharkhand, and the World Bank reflect the breadth of organisational challenges addressed by Dr. Verma.
Authorship is an important part of Dr. Verma’s professional journey. His books include Role of Board: Building Competitive Edge* (with Dr Pritam Singh and Asha Bhandarker), Riding the New Tide, Towards the Next Orbit, Organizing and Managing in the Era of Globalization, and Towards Boundary-less HR. In addition, he has published over twenty research papers in edited books and international journals. His presentations at global academic platforms such as AOM, APROS, EGOS, IHRM, and ISA reflect his active and sustained engagement with the international scholarly community.
Dr. Verma also plays an active role in national and international standard-setting initiatives. He serves as a principal member of the HR and Innovations Committee at the Bureau of Indian Standards, contributes to ISO’s working group on HR and innovation
Dr. Subir Verma, Director of FORE School of Management, New Delhi, brings over three decades of experience in research, teaching, training, and consulting across respected institutions in India and abroad. His work in leadership development, team building, and change management has contributed meaningfully to the institution’s academic stature
management in Geneva, and reviews accreditation applications for AMDISA-SAQS.
Dr. Verma’s contributions have been widely recognised through several honours and awards. These include the Dr. Karan Singh Gold Medal, Prof C J Chacko Prize, and the Kirori Mal College Merit Certificate. He has also received UGC Junior and Senior Research Fellowships, the AICTE Award for Research with travel to South Africa, and the Club Internationale Award in Paris for excellence in research and teaching.
Dr. Verma encourages initiative, inquiry, and skill development that benefit both individuals and organisations. By linking researchbased insights with practical application, the forward-thinking leader motivates learners to explore ideas, strengthen systems, and drive sustainable, long-term impact, thereby nurturing a culture of thoughtful learning and meaningful organisational growth.

Mr. Bakir’s professional journey began in 1990 with a residential project in Rajkot, Gujarat. The project’s success laid the foundation for Crystal Group, laying the first brick for a company that eventually became a leading player in India’s real estate and infrastructure growth. With growing ambition and market demand, Crystal Group diversified into commercial and retail development. Gradually, it created landmark destinations such as Crystal Mall in Rajkot and another in Jamnagar. These early projects quickly became household names across Gujarat and drew significant footfalls from shoppers of all segments. They soon emerged as preferred retail destinations, attracting prominent Indian brands and leading international retailers, thus setting new benchmarks for commercial development in the region.
The group’s early diversification proved a masterstroke for Mr. Bakir, but the real turning point came when he identified industrial and logistics infrastructure as the next major driver of India’s economic growth. While others continued to focus on conventional real estate, he made bold bets on this sector that soon became integral to India’s broader industrial ambitions. Reflecting on this decision, Mr. Bakir says, “Infrastructure is not just about building assets; it is about enabling industries to grow, scale, and compete globally.” This foresight resulted in the formation of Crystal Industrial & Logistics Parks, now regarded as one of the most progressive platforms supporting India’s industrial ambitions.
Under Mr. Bakir’s leadership, Crystal Industrial & Logistics Parks has emerged as a modern and industry-ready solution for India’s expanding manufacturing and warehousing needs. Today, these parks support a wide spectrum of sectors, including e-commerce, electric mobility, renewable energy, automobile, consumer electronics, and 3PL service providers.
Attracting foreign direct investment into India’s industrial real estate ecosystem has been one of his standout achievements. Partnerships with global funds, such as IndoSpace and ESR, have brought international capital, advanced expertise, and global best practices into the country, besides creating spaces that meet the exacting requirements of multinational corporations. Over 70 leading brands, including Amazon, Reliance, TATA Gotion,

BAKIR GANDHI
Mr. Bakir Gandhi’s saga reads like the steady unfolding of a purposeful mission that is firm in conviction, and resolute in outcome. From his modest beginning in Rajkot to building nation-spanning industrial and logistics hubs, his journey shows how clear purpose and long-term thinking can reshape entire sectors. As the Chairman & Managing Director of Crystal Group, Mr. Bakir has built a formidable enterprise that supports industries, generates employment, and strengthens the country’s economic rhythm with unswerving commitment and long-term national vision
BY MONALISA CHOUDHURY
and Cars24 have chosen Crystal facilities for their operations. Besides providing millions of square feet of industrial and warehousing space, these parks have generated employment, enhanced regional infrastructure, and contributed significantly to India’s GDP and the “Make in India” initiative.
Crystal Industrial & Logistics Parks now operate across key centres such as Ahmedabad (Sanand, Bavla, Bagodara), which serve as flagship parks with clients like Amazon, TATA Gotion, and Cars24. In Mumbai and Bhiwandi, the parks connect India’s financial capital with crucial supply chains. In Bengaluru, they support techdriven production and e-commerce, while in Chennai and other parts of Tamil Nadu, they back automobile and electronics hubs. The parks in Delhi NCR add capacity to one of India’s busiest industrial belts. Each park is equipped with well-planned internal roads, smart connectivity to ports and airports, 50 MW solar installations, CETP-based waste
management systems, and built-to-suit units for global clients. The emphasis on environmentally friendly construction has helped Crystal Group consistently exceed expectations in a sector that demands precision and reliability.
A visionary leader, Mr. Bakir firmly believes that modern infrastructure should never come at the expense of the environment. By incorporating eco-conscious features, such as rooftop solar panels, storm water harvesting systems and expansive green zones across its parks, along with forwardthinking design elements, the thoughtful leader ensures Crystal Group’s projects are not only commercially successful but also environmentally responsible and socially impactful. His vision aligns with global best practices and demonstrates that infrastructure development and sustainable growth can go hand in hand. Sustainability guides every decision he makes.
“SUSTAINABLE DEVELOPMENT IS NO LONGER A CHOICE BUT A RESPONSIBILITY. THE INFRASTRUCTURE WE BUILD TODAY MUST SERVE BOTH BUSINESSES AND THE ENVIRONMENT FOR DECADES TO COME. THAT’S WHY WE ENSURE ECO-CONSCIOUS DESIGN IS EMBEDDED INTO EVERY DEVELOPMENT BY CRYSTAL GROUP ”
Every extraordinary journey comes with hurdles, and Mr. Bakir’s has been no exception. The post-pandemic years brought new challenges, including land scarcity, rising costs, and a liquidity crunch. But he has faced them with calmness, patience, and a readiness to adapt. His focus has always been on driving long-term value, not quick gains. Under his guidance, Crystal Group stayed ahead of the curve by focusing on built-to-suit solutions, thereby enhancing operational efficiency and building strong collaboration with industry partners. These outstanding capabilities have enabled the group to remain well-positioned even amid a rapidly evolving market.
Mr. Bakir is now focused on expanding in Bengaluru while simultaneously planning new projects in Delhi-NCR and Pune. With growing demand for electronics, FMCG, and spare-parts warehousing, he is strengthening Crystal Group and engaging with key e-commerce players to explore capacity expansion across India. As India advances toward a global manufacturing hub, he is also gearing up for global expansion through cross-border industrial corridors. His aim is to connect India’s manufacturing capabilities with global trade routes, besides providing Indian industries with seamless access to international markets. This approach will support India’s economic goals while creating opportunities for global companies seeking efficient production and distribution hubs.
Mr. Bakir’s charismatic leadership inspires a culture of high engagement and exceptional performance. Under his leadership, Crystal Group has been recognised as the “Most Emerging Brand in Industrial & Logistics Parks” for its excellence in delivering modern infrastructure with speed, perfection, and precision. Mr. Bakir himself has been honoured with a leadership award for his vision, sharp thinking, and steadfast commitment, which have significantly elevated Gujarat and India firmly on the global warehousing map.
Born and raised in Mumbai, Dr. Vadlamani was always curious and determined to chart her own path. She earned her degree in Electrical and Electronics Engineering and later gained nearly three decades of experience in the global pharmaceutical market. Her journey was not without challenges. Working in a male-dominated industry and taking on the risks of entrepreneurship tested her at every step. But each challenge only made her stronger and more determined to give her best. From managing family responsibilities to leading a global enterprise, she has balanced it all with grace.
When Dr. Satya Vadlamani founded Murli Krishna Pharma in 2003, she laid the foundation for an enterprise that combines science, ethics, and compassion. With over two decades of experience in the pharmaceutical sector, she brought together innovation and integrity to address some of India’s most pressing health challenges. Her aim has always been to improve lives, not just profit margins.
Under Dr. Vadlamani’s stewardship, Murli Krishna Pharma quickly became one of India’s trusted names in novel drug delivery systems. Her leadership style is defined by focus, empathy, and a deep sense of responsibility. She believes that businesses should serve society as much as they serve shareholders. She goes the extra mile to keep her company at the forefront of developing advanced healthcare solutions that are both affordable and effective, especially for people living in underserved regions.
One of Murli Krishna Pharma’s most significant innovations is its pioneering work in combating anaemia, a widespread health issue in India. Its transdermal iron formulation has changed how anaemia is treated. Unlike traditional oral supplements that can cause gastrointestinal side effects and offer limited absorption, this new formulation delivers iron through the skin, ensuring up to 70% bioavailability. Within 45 days, it can raise haemoglobin levels by 1.5 to 2 units, which is a remarkable achievement in medical science. This product not only enhances physical energy and mental clarity in patients but also represents a major leap in patient-friendly care.
Through such innovation, Dr. Vadlamani has positioned her company as a strong ally in India’s national health initiatives. Her work aligns closely with the government’s

DR. SATYA VADLAMANI
Dr. Satya Vadlamani’s life is a remarkable example of how solid determination can build a saga of inspirational leadership. From her early struggles to her position as Chairperson and Managing Director of Murli Krishna Pharma Pvt. Ltd., she has built success driven by values, empathy, and courage. Today, the company stands tall as a symbol of Indian innovation and social enterprise, and celebrated for its focus on novel drug delivery systems, eithical business practices, and incluive growth. For Dr. Vadlamani, success is not measured by financial milestones alone but by the lives touched through her work
BY MONALISA CHOUDHURY
‘Anaemia Mukht Bharat’ mission, which reflects her belief that private enterprise can play a powerful role in solving public health challenges. By integrating modern technology with social responsibility, she ensures that her company’s growth directly contributes to improving the nation’s wellbeing.
Dr. Vadlamani’s colleagues describe her as both compassionate and disciplined. These traits have helped her build lasting relationships with employees, clients, and partners alike. She is also a good listener and believes in leading by example. Her leadership philosophy revolves around empowering people to think independently and take ownership of their work.
Dr. Vadlamani’s idea of development extends far beyond healthcare. She firmly believes that real progress happens only when economic growth uplifts everyone, especially those in rural and semi-urban
areas. Through Murli Krishna Pharma, she has created numerous employment opportunities for both skilled and unskilled workers. Her initiatives in rural job creation, education, and skills training have given new hope to thousands of families who once had limited opportunities.
Dr. Vadlamani actively promotes gender equality, not just within her organisation but as a national cause. At Murli Krishna Pharma, women play an integral role across departments, from production and research to administration and leadership. She has also introduced mentorship programs to help women rise into leadership roles, ensuring that ambition is backed by opportunity. Throughout her journey, she has inspired many young women to believe that leadership is not defined by titles but by purpose. For her, empowering women is not just about fairness but about exploring the immense potential that women bring to
“A LIFELONG LEARNER, DR. VADLAMANI BELIEVES THAT EDUCATION IS THE FOUNDATION OF EMPOWERMENT. TO THAT END, SHE COLLABORATES WITH ACADEMIC INSTITUTIONS TO PROVIDE SCHOLARSHIPS, RESOURCES, AND INFRASTRUCTURE SUPPORT FOR CHILDREN IN RURAL AREAS”
every field.
Dr. Vadlamani has also been engaged in supporting farmers. She understands the financial constraints they face and the importance of creating systems that ensure stability and fair returns. Under her direction, Murli Krishna Pharma has launched programs that connect farmers directly with markets, reducing their dependence on intermediaries. The company also helps farmers access affordable credit and modern agricultural technologies. These initiatives not only boost rural incomes but also encourage sustainable agricultural practices that benefit communities for generations to come.
She says, “A developed India cannot be built by a few; it must be built by all.” This belief drives her constant efforts to create inclusive spaces where every individual, regardless of background, can participate in the nation’s progress. Her social philosophy centres on building systems that provide basic needs, such as food, housing, healthcare, and education, so that people can live with dignity and purpose.
Dr. Vadlamani views sustainability as a moral duty rather than a choice. At Murli Krishna Pharma, she has introduced ecofriendly manufacturing practices and green investments to reduce the company’s carbon footprint. Under her guidance, the company has also undertaken several community initiatives, including tree plantation drives, waste reduction programs, and environmental awareness campaigns. Her focus on green energy and responsible waste management has enhanced operational efficiency besides setting an example for corporate environmental responsibility.
In 2024, Dr. Vadlamani was honoured with the Ambassador of Change Award by DIISHA, Business Influencer of the Year by IEDRA Global, and the Asia Pacific Anmol Ratan Award. She has also received the Atal Achievement Award 2023 and the Outstanding Leadership Award at the National Awards for Excellence in CSR and Sustainability, among other prestigious honours.
With over18 years in banking, fintech, and consulting, Dr. Mohammad Salem Omaid has built a global reputation for establishing financial systems that can withstand pressure across varied markets. Recognised as a Young Global Leader by the World Economic Forum, Dr. Omaid has built a strong career driven by his resilience and vision
Raised in Afghanistan, Dr. Omaid understood the country’s institutional fragility quite early. This observation shaped his conviction that stable financial infrastructure underpins national progress. His sharp academic strength paired with practical insight drew him into banking, where he quickly drew attention for combining clear analytical ability with an understanding of both people and markets. A bold leader, he used to question outdated processes and steering institutions toward contemporary standards at a time when such shifts met considerable resistance. Senior leadership roles followed as he demonstrated steady judgment during periods of uncertainty and helped broaden the conversation around financial inclusion.
A major milestone in Dr. Omaid’s career came when he served as CEO of Afghanistan’s largest bank. He took charge during a volatile period and worked to strengthen the institution despite significant challenges. Under his leadership, the bank improved transparency, compliance, and risk governance, helping rebuild customer trust and operational stability. As conditions improved, public confidence grew again. The bank became a reliable partner for millions of people, expanding access to formal financial services for communities that previously lacked secure banking options.
At present, Dr. Omaid’s work in the UAE builds on this foundation. As Founder and CEO of iBnk-operated Finmall, he leads a fintech enterprise in Dubai that develops digital pathways for service delivery across the GCC and other regions. The platform functions as a B2B2C marketplace that brings multiple services under one digital framework.
Finmall offers utility payments, travel services, lending, wealth

tools, neo-banking functions, remittances, and compliance solutions in a single environment. Partnerships with MSMEs and business correspondents broaden outreach efficiently and connect customers that mainstream institutions often bypass.
Drawing on his experience in cross-border payments, regulatory systems, and digital strategy, the platform has taken shape as an ecosystem designed to make financial access secure, simplified, and responsive. His role in this work places him among contributors to the UAE’s expanding fintech space.
A seasoned entrepreneur, Dr. Omaid is known for his clarity of thought. He is also regularly invited as a keynote speaker at leading global financial and economic forums. His ability to translate complex financial issues into practical, people-focused insights makes him a respected voice among policymakers, industry leaders, and emerging professionals alike. Alongside his professional responsibilities, Dr. Omaid devotes time to mentoring young professionals and entrepreneurs seeking clarity in a complex sector. The idea that inclusive finance supports broader social advancement continues to influence his work.
Dr. Omaid’s remarkable contributions have brought prestigious recognitions from think tanks, business forums, and industry bodies across multiple regions, including Europe, Asia, the United States, and the Middle East. These acknowledgements point to both his technical expertise and his influence in strengthening financial inclusion, digital capability, and institutional stability.
Since establishing his first enterprise in 1983, Mr. Jajoo has built a diversified business group guided by transparency, accountability, and responsibility—principles that continue to define both his organisations and his leadership style. For him, entrepreneurship has never been about scale alone, but about building institutions that create enduring value for people and communities.
Under Mr. Jajoo’s stewardship, J.K. Jajoo Ventures has expanded across sectors through measured, purpose-led decisions. The group’s early presence in finance and wealth management focused on enabling individuals to achieve financial security through transparent and responsible planning. Over time, the portfolio grew to include industrial packaging through Supreme Packaging Pvt. Ltd. and logistics through KJ Logistics, serving leading corporations such as Birla White Cement. Each diversification was rooted in operational excellence, ethical governance, and long-term partnerships.
In 2010, Mr. Jajoo entered the aviation sector, bringing structure and professionalism to airport ground handling. This led to the launch of BKJ Airports in 2024, now operating across 17 major Indian airports and ranked among India’s top three ground-handling companies.
As Founder & Chairman of Shubhashish Homes, a flagship brand under J.K. Jajoo Ventures, Mr. Jajoo focuses on redefining urban living through sustainability, transparency, and customer-first development. The brand creates eco-conscious, nature-integrated communities that balance contemporary lifestyles with environmental responsibility.
Mr. Jajoo’s belief in responsible leadership extends well beyond the boardroom. In 2001, he founded Jagriti, a non-profit organisation dedicated to education, healthcare, and women’s empowerment. Since its inception, Jagriti has adopted 21 government schools, empowered 33,000+ students, served nearly 9 lakh meals, trained 12,500 women in vocational skills, and supported 9,500 families through its Antim Darshnika service—ensuring dignity during life’s most vulnerable moments. What began as a local initiative in Jaipur has grown into a structured, impact-driven organisation focused on sustainable social change.
Mr. Jajoo’s contributions to industry and society have been acknowledged through numerous honours, including the National Youth Award (2018) from the Hon’ble Prime Minister of India, the London World Book of Records Award (2023) for humanitarian service, the Bhamashah Award for nine consecutive years of government school funding, and the Highest State Civilian Award (2016) for excellence in social service. He has also held prominent leadership roles across civic and industry platforms, including President of Rotary Club Jaipur Midtown, Trustee and Convenor of Jaipur Citizens Forum, Charter Member of TiE, Executive Member of CII, and Co-Chair of the Indian Chamber of Commerce, Rajasthan Chapter (2024–25).
For Mr. Jajoo, leadership is about consistency, credibility, and conscience. He believes businesses should last beyond their founders, and should be built on trust, empathy, and long-term thinking. Grounded yet forward-looking, he nurtures enterprises that strengthen industries, uplift communities, and serve society with purpose.
Mr. J.K. Jajoo is the Founder & Chairman of J.K. Jajoo Ventures and Shubhashish Homes, and a self-made entrepreneur whose four-decade journey reflects disciplined leadership, ethical growth, and a deep commitment to long-term societal impact

IN A WORLD DRIVEN BY NUMBERS AND MILESTONES, LION V.V. KRISHNA REDDY STANDS APART AS SOMEONE WHO TRANSLATES VISION INTO REAL-TIME COMMUNITY IMPACT. HIS JOURNEY FROM A HUMBLE BACKGROUND IN ANDHRA PRADESH TO BECOMING THE FORCE BEHIND DR. SR CHANDRASEKHAR INSTITUTE OF SPEECH AND HEARING (DR. SRCISH), ONE OF INDIA’S MOST RENOWNED INSTITUTIONS FOR SPEECH AND HEARING CARE, IS MARKED BY SUSTAINED EFFORT, STRONG PARTNERSHIPS, AND A PRAGMATIC APPROACH TO SOCIAL RESPONSIBILITY


In an age where sustainable impact is the gold standard, Mr. Reddy’s story reminds us that “it takes a village”, and more importantly, a dedicated leader with a heart of gold and a mind for innovation to turn vision into reality. Born into a family of agriculturalists in Andhra Pradesh, Mr. Reddy began his professional life with a degree in engineering. His career took shape not in predictable corporate confines but through dynamic roles as an educator and later, a scientist with the Defense Research & Development Organisation. His entrepreneurial instincts came to the fore when he founded VARS Builders Pvt. Ltd. in Bengaluru, a venture that gave him the platform to merge business insight with a deeper social purpose. For Mr. Reddy, success has never been an end in itself, but a means to enable broader community development. Since joining the Lions Club in 1995, Mr. Reddy has held several distinguished leadership roles, including Governor of District 324 D6 in 2006–07 and Council Chairman of MD 324 in 2007–08. His community work reached global dimensions when he was elected Director of The International Association of Lions Clubs at the 93rd International Convention in Sydney. These positions served as launching pads for initiatives that have directly improved the lives of thousands, particularly the hearing-impaired and children with communication disorders. As Chairman and Director of DR.SRCISH, Mr. Reddy has reshaped the organisation’s operations by actively involving a wide array of partners—Trustees, Lions International, SBI Foundation, Tech Mahindra Foundation, Cognizant Technologies, Azim Premji Foundation, CSR sponsors, Infosys, Rotary International,NRIs, and multiple donor groups. Through these strategic connections, the Institute significantly expanded its academic and clinical services by adding courses such as BASLP, MASLP, M.Sc. in Audiology, PG diplomas, and research programs affiliated with Bangalore North University and Manipal Academy of Higher Education.
One of his most impactful interventions has been scaling the Institute’s reach into rural and underserved regions. Under his sterling stewardship, DR.SRCISH now operates three mobile outreach units equipped for neonatal screening, speech-
language diagnostics, and therapy. These mobile buses conduct over 290 camps monthly across Karnataka and Andhra Pradesh, touching over 5,000 lives each month. By focusing on regions often overlooked, he has helped the institute become a source of hope and healing for many who lacked access to proper care in Speech and Hearing. Over the years, Mr. Reddy has secured crucial CSR grants, including Rs. 1.41 crore from the State Bank of India Foundation for cutting-edge diagnostic tools, and Rs. 13 lakhs annually from the Tech Mahindra Foundation to support inclusive education programs under the “Sabal Vidhyabhyas” initiative. His support also led to the installation of wireless induction loop systems and the introduction of sign language programs for deaf students and adult learners. In 2025, under his leadership, the Institute received Rs. 2.06 crore from the Azim Premji Foundation for a grassroots-level project covering 234 villages in Tumkur District which aims to prevent and treat hearing and speech disorders in over 15,000 children.
In an age where leadership often means making headlines, Mr. Reddy quietly chooses a different archetype of leadership. His leadership style is one characterised by humility, dedication, and an unrelenting focus on systemic impact. He does not hanker after fleeting visibility but seeks the creation of resilient institutions that transform lives and uplift communities, particularly those often overlooked by traditional frameworks of care. Mr. Reddy believes in inclusive empowerment and practical decisionmaking. He empowers his team to take ownership, besides promoting academic freedom and continuous professional growth. Under his guidance, the Institute has introduced incentives for research publication and reduced fees for Ph.D. candidates. Additionally, by adopting digital client record systems and ensuring up-to-date certifications from NAAC, UGC, RCI, and DSIR, Mr. Reddy has strengthened DR. SRCISH’s foundation for delivering sustainable services. In corporate governance too, the leader’s methods have set a high standard. A dedicated HR executive streamlines administration. Staff are encouraged to attend certified courses and are supported through ongoing training. Parent-teacher meetings are systematically recorded,
enabling data-driven insights into child development. Such internal rigor ensures that the Institute doesn’t rest on its laurels but continually seeks to improve.
Looking ahead, Mr. Reddy’s short-term vision is to enhance the Institute’s clinical infrastructure, introduce newer academic programs, and increase outreach in underrepresented districts. The longterm aim is to establish DR. SRCISH as a global center of excellence—one that leads research, education, and inclusive therapy practices for people with communication disorders.
Mr. Reddy’s steadfast dedication has earned him notable recognition. He was honored with the Vistara Business Excellence Award 2024 for his contribution to speech and hearing education. Earlier, the Economic Growth Foundation acknowledged his role in educational development, while the International Business Council presented the Lifetime Education Excellence Award to DR.SRCISH. Lion Krishna Reddy has received numerous awards Lions Clubs International as its member since 1995. As list goes long to name a few important awards, Recipient of Ambassador of Goodwill Award the highest recognition given by Lions Clubs International. Also, Humanitarian Partner Awardee by Lions Clubs International Foundation. These prestigious awards are proof that focused service, when done right, earns its rightful place.
A benevolent leader, Mr. Reddy leads with heart. From helping students through merit awards to supporting underprivileged children at Sunaad School for the Hearing Impaired, or enabling digital literacy through grants, his work has touched thousands. Driven by a focus on sustainability and impact, he ensures that every decision, from energy-efficient outreach to advanced staff training, supports the delivery of affordable and quality care. As a result of his dedicated efforts, advanced services like newborn hearing screening, stroboscopy, Fiberoptic Endoscopic Evaluation of Swallowing (FEES), and audiological assessments now reach underserved communities
Born on February 1, 1949, Mr. Moazzam showed early signs of brilliance and ambition. Raised with strong moral values, he inherited his exceptional intellect, rigorous discipline, and empathy from his humble parents, particularly his father, Welayet Hossain, a renowned lawyer in Feni, Noakhali District, Bangladesh, admired for his integrity, compassion, and generosity. The qualities he inherited from his father laid the foundation for a life driven by service, strategic thinking, and a relentless passion to uplift the nation. Fluent in Bengali, English, Japanese, and Hindi, Mr. Moazzam embodies a cosmopolitan spirit rooted deeply in national pride.
After graduating from the University of Dhaka, Mr. Moazzam went on to pursue higher studies in Chemistry at Japan’s prestigious Nagoya University in 1968. During his time in Japan, he was greatly inspired by the country’s industrial leaders and their innovative ways, which sharpened his entrepreneurial instincts. Encouraged to make a difference, he started his first venture—an English school. This experience not only honed his business skills but also strengthened his resolve to return to his newly independent country and contribute meaningfully to its growth.
Following Bangladesh’s liberation, Mr. Moazzam returned with ideas and action. One of his first impactful steps was introducing the concept of importing reconditioned cars under the wage earners’ scheme. This idea helped war-ravaged Bangladesh take its first step toward modern mobility. He soon expanded into importing irrigation pumps, microbuses, and small boat engines to support rural connectivity and agriculture. His understanding of the country’s urgent needs turned him into an industrial catalyst during a crucial phase of rebuilding.
In 1975, Mr. Moazzam ventured into an entirely new sector by launching Bangladesh’s first joint venture in deepsea fishing with South Korea. Soon after, he pioneered barter trade with East European countries by bringing in essential items like truck-mounted standby generators, leather, tea, and steel-bodied trucks. Each of his initiatives not only filled critical economic gaps but also opened new pathways for growth, thus strengthening the country’s trade and industrial foundations.
At the core of his vast industrial empire lies the Hosaf Group, a symbol of resilience

MOAZZAM HOSSAIN
Mr. Moazzam Hossain, Chairman of the Hosaf Group in Dhaka, Bangladesh, is a name etched in the saga of Bangladesh’s private sector rise. A self-made industrialist of rare caliber, his story is one of grit, innovation, and relentless pursuit of national development. His journey epitomises purposeful leadership that has continually shaped vital sectors of the country’s economy. Apart from business, he champions sustainable growth, ensuring his enterprises create meaningful impact. At the same time, with his vision and foresight, he goes the extra mile to empower communities
BY MONALISA CHOUDHURY
and achievement in Bangladesh’s business sector. As its founding Chairman, Mr. Moazzam transformed the group into a diversified giant with ventures in power, finance, insurance, manufacturing, and real estate. Under his leadership, the group has built a strong team of over 800 employees committed to performance and integrity.
One of Mr. Moazzam’s landmark achievements was the establishment of a 2x210 MW thermal power plant in Raozan, Chittagong, in 1990, in collaboration with China National Machinery and Equipment Import and Export Corporation (CMC). This project marked a significant step in addressing Bangladesh’s growing electricity shortage and set a benchmark for future energy initiatives. Building on this success, he made another bold move in 2008 by establishing four rental power plants with a combined capacity of 170 MW, providing much-needed relief to the national grid. His commitment to expanding the country’s energy infrastructure continued with the
commissioning of a 113 MW HFO-based plant in 2019, followed by a coal-fired power plant of 2x125 MW, and an additional 275 MW unit, further strengthening Bangladesh’s power generation capacity.
Mr. Moazzam has also contributed immensely to Bangladesh’s industrial modernisation. In the 1980s, he introduced electric, gas, and water meters through joint ventures, which significantly improved utility management. He also embraced environmental responsibility by entering the green tech space with the manufacturing of energy-saving LED lights.
His contributions extend beyond infrastructure and energy. Mr. Moazzam co-founded National Bank Limited, one of the first-generation private banks in Bangladesh, which played a pivotal role in strengthening the country’s financial sector. He also founded Pragati Insurance Limited, a leading non-life insurance company,
“MR. MOAZZAM LEADS HOSAF GROUP WITH A VISION WHERE BUSINESS EXCELLENCE MEETS SOCIAL RESPONSIBILITY. THROUGH DIVERSIFICATION, INNOVATION, AND ENERGY INITIATIVES, HE HAS REDEFINED INDUSTRIES, WHILE SETTING A BENCHMARK FOR RESPONSIBLE LEADERSHIP ”
ensuring the safety of investments and trade. Furthermore, he served as Vice President of the Bangladesh Garments Manufacturers and Exporters Association (BGMEA) from 1981 to 1985, making impactful contributions to one of the country’s largest export industries.
A multifaceted leader, Mr. Moazzam chairs multiple companies, including Hosaf Meter Limited, Hosaf Proficient Energy Limited, and HF Power Limited, while also serving as Managing Director of firms like Energy Prima Limited and Citi Link Apartment Limited. Since education holds a special place in his heart, he founded the National Bank Public School and College to provide quality education from pre-primary to higher secondary levels.
Mr. Moazzam is a philanthropist driven by a genuine desire to uplift others. Over the years, the benevolent leader has built schools such as Bokter Munshi Moazzam Hossain High School and Bhor Bazar Belayet Hossain High School in Feni. These institutions are run with qualified educators and host hundreds of students from underserved communities. He continues to support these schools financially and provides scholarships to meritorious students. His contributions also extend to sports, where he sponsors diverse sporting events across districts to encourage local talent. His objective is to inspire and encourage budding sportsmen and women by providing them with platforms to showcase their talents and contribute to the country’s sporting achievements.
Other than sports, Mr. Moazzam is a committed nature enthusiast. He advocates for the preservation of the environment and the protection of wildlife. Through awareness campaigns and conservation projects, he seeks to build a deeper connection between people and nature.
Despite his vast accomplishments, Mr. Moazzam leads a simple life. He finds joy in gardening, hunting, and playing cricket, table tennis, and golf. His achievements are a reflection of the honesty, courage, and empathy he has held onto throughout his life.
MR. NIRAV DINESH KUMAR SHAH, FOUNDER & MANAGING DIRECTOR OF FAME ADVISORY DMCC, EXEMPLIFIES FORWARD-THINKING LEADERSHIP IN CORPORATE TAX CONSULTING. WITH OVER 30 YEARS OF EXPERTISE, FROM MUMBAI TO HELMING A MARQUEE ADVISORY FIRM IN DUBAI, MR. SHAH’S INNOVATIVE APPROACH HAS TRANSFORMED THE FIELD AND SET NEW BENCHMARKS FOR SUSTAINABLE BUSINESS GROWTH
Mr. Shah began his professional journey with a strong academic foundation. A qualified Chartered Accountant (ACA) from the Institute of Chartered Accountants of India, the well-versed leader earned All India rank 6 in the Inter CA exams and rank 36 in the finals while completing his CA in November 1994. He then spent nearly a decade with KPMG in Mumbai, specialising in international tax and structuring, where he advised pioneering Indian corporates on cross-border transactions. In 2015, armed with global corporate experience and a passion to elevate tax advisory standards in the UAE, he launched FAME Advisory DMCC, his most defining achievement. Initially established as FAME Training Institute in 2014 to upskill finance professionals, the company quickly evolved into a full-scale advisory practice. Under his direction, the firm has grown into one of the UAE’s most respected advisory practices that serve over 1,000 clients across a diverse range of industries. It has earned a solid reputation for its practical, business-first approach to tax and regulatory matters.
Over the years, Mr. Shah’s work has shaped the decisions of multinationals, high-net-worth individuals (HNIs), and complex family enterprises navigating an increasingly transparent and interconnected world. But what truly sets him apart is not just his depth of expertise but his client-first philosophy, unwavering integrity, and his vision for the future of tax advisory. Fame Advisory DMCC specialises in corporate tax advisory, VAT strategy, anti-money laundering strategies, and business structuring—areas that
are critical for companies looking to stay compliant while growing sustainably. Since the introduction of corporate tax in the UAE in 2023, the company, under Mr. Shah’s stewardship, has been at the forefront, helping businesses make sense of the changes and adapt with confidence. Clients value the firm not just for its technical expertise, but for the clarity, guidance, and peace of mind it brings in a fast-changing regulatory environment.
LEADERSHIP STYLE
Mr. Shah’s leadership is defined by agility and foresight. His results-driven mindset and a people-first leadership approach set him apart from others. He describes his style as “servant leadership” focused on empowering clients, mentoring employees, and building a knowledge-driven culture. His client-centric yet compliance-led approach emphasises building rigorous and adaptable advisory processes.
A tech-savvy leader, Mr. Shah believes that technology, decentralisation, and global minimum tax frameworks will define the future of tax advisory. One of his key innovations has been his integration of technology into advisory workflows for streamlining compliance checks, reducing manual errors, and speeding up client onboarding. This internal compliance system is both efficient and tailored to each client’s business needs. “Advisors must embrace technology to stay competitive,” he says, highlighting the growing need for tools that manage information and ensure regulatory alignmnent. This trend is particularly evident among HNIs in the Middle East and Asia, where there


is growing adoption of sophisticated wealth structuring tools like foundations, succession planning vehicles, and insurance, alongside increased involvement of younger generations in asset planning.
Mr. Shah’s leadership philosophy centres on innovation, accountability, and enabling every team member to lead from within.
The humble leader credits his parents for instilling values of integrity and discipline in every aspect of his journey. His mentors, Mr. Pinakin Desai, guided him to uphold ethical standards, while Mr. Pankaj Mehta’s goal-driven approach inspired his strategic mindset. That said, his growth hasn’t only come from the top down; it has come from all directions. “Some of my best lessons have come from clients, peers, friends, and even challenges,” he reflects.
Mr. Shah is steering FAME Advisory toward a tech-driven, sustainable future by enhancing digital capabilities, particularly through AI-powered compliance and risk assessment, aligned with the firm’s broader environmental vision. By digitising over 80% of client workflows and adopting virtual advisory platforms, the firm has cut paper use by 40% annually and reduced travel through virtual advisory platforms. Looking ahead, Mr. Shah plans to build partnerships across the GCC and Southeast Asia to develop expertise suited to local markets, guided by global best practices.
Mr. Shah’s relentless commitment to excellence has been widely recognised and celebrated. Over the past three years, both he and FAME Advisory have received numerous prestigious awards. In 2020, FAME Advisory was named the Best International Tax Firm in the Middle East by the MEA Business Awards for its specialised expertise. In 2021, the firm was honoured with the Excellence in Business Set-Up Services award for its outstanding support to start-ups and international companies entering the UAE market.
A lifelong learner, Mr. Shah regularly attends global seminars, webinars, and peer networks to stay ahead of the curve. Over the years, he has cultivated a knowledge-driven and collaborative culture that emphasises integrity, accountability, and continuous improvement.
Mr. Nitin’s saga is not just about a company’s growth but about shaping India’s digital destiny. Through his efforts in smart cities, enterprise solutions, emerging technologies, and philanthropy, he has demonstrated that business and nationbuilding can go hand in hand.
Mr. Nitin’s professional journey began in 1978 after he completed his engineering at VJTI, Mumbai. At a time when India’s IT ecosystem was in its infancy, he demonstrated remarkable foresight by imagining a digitally connected world. He figured out early that technology could do much more than help businesses — it could transform the way society works. In 1984, with just ₹250 in rent and two employees, he founded Allied Digital Services Limited (ADSL) from a small office in Fort, Mumbai. Over the decades, he scaled the company from a modest start-up to a global systems integrator operating in over 70 countries, thus proving that disciplined execution and strategic vision could drive sustainable growth.
A forward-thinking leader, Mr. Nitin’s approach has always been about delivering measurable outcomes. He has consistently aligned business strategy with India’s national priorities, particularly through the Smart Cities Mission. Under his guidance, Allied Digital has executed over 15 smart city projects, including Pune, Amritsar, Aurangabad, and Lucknow. The Pune Safe City Project, India’s first of its kind, set the benchmark with AI-driven surveillance, centralised command centres, predictive policing, and rapid response systems. For him, smart city solutions are more than technology deployments; they are high-impact initiatives designed to create safer, more efficient urban ecosystems.
Mr. Nitin adheres to a “citizen-first” approach to every project he undertakes. Intelligent traffic management, integrated emergency response, digital kiosks, and environmental monitoring systems are implemented not for the sake of innovation but to enhance the quality of life for residents. He often emphasises that a smart city’s true value is measured by how effectively it serves its citizens, not the number of gadgets deployed. By keeping stakeholders front and centre, he ensures that technology initiatives deliver tangible business and social returns.
Apart from urban development, Mr. Nitin

NITIN SHAH
Mr. Nitin Shah, Chairman and Managing Director of Allied Digital Services Limited (ADSL), is a technocrat focused on delivering measurable results. Over 40 years, he has leveraged advanced technology to create safer cities, smarter enterprises, and empowered communities. Under his leadership, ADSL operates across 70+ countries and is recognised as a global digital powerhouse with over 4000 employees. His leadership in pioneering Smart City projects in numerous cities has set national benchmarks in AI-powered surveillance, predictive policing, and integrated citizen-centric services
BY MONALISA CHOUDHURY
consistently invests in emerging technologies to enhance the capabilities of enterprises and governments. Under his leadership, Allied Digital has expanded its portfolio into cloud services, artificial intelligence, automation, and cyber security. He also played a crucial role in developing Digital Desk+, an IP-led digital service management platform now widely adopted by both enterprises and government agencies. His strategy ensures that Allied Digital remains relevant in a competitive global market while delivering high-value solutions to clients.
The secret behind Mr. Nitin’s enduring success is his talent for turning technology into a tool for scalable change across governance, infrastructure, and enterprise landscapes. For him, technology is an enabler, never an end in itself. Whether implementing AI in urban infrastructure, automating enterprise processes, or fostering skill development in rural India, he focuses on outcomes that generate measurable impact. His work exemplifies how corporate strategy, innovation,
“ALLIED
and social responsibility can coexist to produce both commercial success and societal benefit. Whether implementing AI-driven command centres in cities or creating cloudbased platforms for enterprise efficiency, his work consistently emphasises practical utility and long-term impact. He demonstrates that technology, when applied thoughtfully, can be a powerful lever for systemic improvement.
Another hallmark of Mr. Nitin’s approach is inclusivity. He believes that digital progress should benefit all sections of society, not just urban elites or corporate clients. His programs in rural education, skill development, and digital literacy are designed to bridge the gap between technology access and social opportunity. For him, nation-building is incomplete without inclusive growth, and every initiative undertaken by Allied Digital or his trust reflects that principle.
Considering the importance of digital transformation for public and private
DIGITAL’S CONSISTENT ADVANCEMENT UNDER MR. NITIN’S STEWARDSHIP REFLECTS HIS KEEN BUSINESS SENSE. IN FY25, THE COMPANY RECORDED ITS HIGHEST-EVER REVENUE OF ₹807 CRORE, REPRESENTING AN IMPRESSIVE 17% YEAR-ON-YEAR GROWTH”
institutions alike, Mr. Nitin has positioned Allied Digital as a trusted partner for organisations navigating complex IT ecosystems. His foresight ensures that the company remains agile, continuously innovating to meet evolving market demands. By integrating operational excellence with social purpose, he ensures that Allied Digital contributes to India’s growth story while maintaining a strong global presence.
Leadership for Mr. Nitin is about succession and knowledge transfer. He has mentored dozens of executives, ensuring that the company is equipped with leaders capable of sustaining its growth and mission. He emphasises that the true measure of leadership is not the position one holds but the ability to inspire and prepare others to carry forward the purposedriven agenda. He believes that building strong teams is not just about talent acquisition but about cultivating a culture that aligns with the organisation’s purpose and vision.
Mr. Nitin actively participates in philanthropic activities. Following the personal loss of his wife in 2005, while raising two young children, he became even more deeply committed to social causes. Through the Padma Pragna Trust, he has championed digital literacy initiatives, scholarships, rural education programs, and skill development for underprivileged communities.
A humble leader, Mr. Nitin measures success not in terms of profits but through the creation of safer cities, empowered citizens, and opportunities for India’s youth.
Mr. Nitin has earned several prestigious honours, including CMD of the Year, recognition among Asia’s Most Promising Business Leaders by The Economic Times, and a Lifetime Achievement Award from VJTI. His dedication to social responsibility has been acknowledged through awards like the Mother Teresa Sadbhavana Award and the Jewel of India title by Chitralekha. Despite these many accolades, the leader leads a humble life. He is a vegetarian, a teetotaller, and a non-smoker and embodies the same discipline and values he promotes within his organisation.
With a career spanning over four decades in specialty steel, Mr. Goyal brings to the table both technical depth and commercial acumen. An engineering graduate from BITS Pilani with an MBA in Finance, the leader began his career during a period of accelerating industrial expansion in India. His early career was driven by exposure to complex manufacturing environments and high standards of execution. A significant phase of his professional growth came during his tenure at Jindal Stainless Ltd., where he held senior leadership responsibilities and played a key role in strengthening operations and positioning the company on the global steel map. These experiences reinforced his belief that long-term success depends on precision, high level of discipline, adoption of best practices, and attention to details. A strong advocate of sustainable manufacturing, Mr. Goyal is also a key voice in India’s green steel transition. Through Saarloha, India’s first green steel manufacturing company, he is driving the country’s green steel vision in line with global sustainability goals.
At Kalyani Steels Limited, Mr. Goyal offers focused leadership aimed at strengthening the company’s position as a trusted manufacturer of high-quality specialty steels. Aligned with the Kalyani Group’s strong long-term vision, he emphasises customer centricity, operational excellence, and a culture of continuous improvement. Under his guidance, Kalyani Steels has expanded its capability to serve strategic sectors such as automotive, engineering, energy, defence, aerospace, nuclear, oil & gas, marine and bearings, by developing specialised and high performance steel grades.
Mr. Goyal firmly believes that a steel producer should function as a solution partner to its customers, rather than merely as a material supplier. This belief has shaped the company’s strong focus on research and development, with teams working closely alongside customers to address evolving technical requirements. According to him, benchmarking against global peers, conducting regular internal audits, and maintaining a sharp focus on transparency and accountability are essential to sustaining high operational standards. He also emphasises that lean manufacturing practices and cost leadership are integral to the company’s approach, thus enabling Kalyani Steels to stay profitable, efficient,

R. K. GOYAL
With over four decades of experience in the specialty steel & allied sectors, Mr. R.K. Goyal, Managing Director of Kalyani Steels Limited (KSL), and Director at Saarloha, India’s first green steel manufacturer, exemplifies a leadership saga shaped by industrial momentum and human-centred thinking. Since 2010, he has been steering KSL through innovative initiatives on cost efficiency, competitiveness, and capacity optimisation. Under his guidance, KSL stands as one of India’s most profitable and technologically advanced specialty steel producers. At Saarloha, he is driving India’s green steel revolution using renewable energy and scrap
BY MONALISA CHOUDHURY
and debt-free with large surplus free cash.
A frontline leader by instinct, Mr. Goyal believes in walking the talk, anchoring his leadership in precision, discipline and empowerment while holding teams to uncompromising standards. His guiding mantra is to excel in every endeavour and build organisations defined by excellence, profitability, and customer centricity. As a forward-thinking leader, he encourages a positive and inclusive culture where responsibilities and roles are clearly defined, performance is consistently measured, and innovation is driven across all levels of the organisation, from operations to leadership. By empowering teams with clarity and ownership, he has built a robust organisation that values focus, smart working and shared accountability.
When Mr. Goyal assumed leadership at Kalyani Steels, he initiated a rigorous global
benchmarking exercise, analysing ironmaking, steelmaking, rolling, inspection and material handling processes separately. By identifying the best-performing plants worldwide for each function, his team identified saving opportunities of nearly ₹13,000 per tonne, a substantial figure at the time. What followed was a focused, time-bound execution drive. Nearly half of the identified savings were achieved without major capital investment, while much of the rest came through modest and carefully planned spending.
Over next two to three years, these initiatives transformed the company’s financial performance. Annual profits rose from modest levels to well over ₹200 crore, capacity utilisation reached close to 100%, and productivity improved so much that the effective capacity itself increased. For both KSL & HSL, output grew from about 4.5 lakh tonnes to over 6 lakh tonnes per year.
Mr. Goyal serves as Director at Saarloha
“A PIONEER IN SPECIALTY AND GREEN STEEL, MR. R.K. GOYAL LEADS WITH PRECISION. BY DRIVING KALYANI STEELS’ GLOBAL EXCELLENCE AND SAARLOHA’S LOW-CARBON INNOVATIONS, HE HAS SET NEW BENCHMARKS IN OPERATIONAL EXCELLENCE, EFFICIENCY, QUALITY, AND SUSTAINABILITY ”
Advanced Materials Pvt. Ltd., a pioneering green steel manufacturer. A defining aspect of his leadership has been Saarloha’s early and ambitious entry into low-carbon steelmaking, long before it became a mainstream focus in India.
In 2022, Saarloha launched India’s first green steel brand, Kalyani FeRRESTA, followed by Kalyani FeRRESTA Plus, the company’s first enhanced green steel offering. At Saarloha, he has closely guided the development of green steel solutions, leading to multiple patented innovations in green steel manufacturing.
Under Mr. Goyal’s guidance, Saarloha Advanced Materials achieved a landmark breakthrough. The organisation reduced embedded carbon emissions from the global average of nearly 1.92 tonnes per tonne of steel to an unprecedented 110 kilograms. Building on this achievement, the company has already filed multiple patents in green steel manufacturing. Ongoing innovations and process improvements are expected to reduce embedded emissions even further, potentially reaching as low as 32 kilograms per tonne. This demonstrates Saarloha’s commitment to pioneering low-carbon steel solutions and reflects Mr. Goyal’s dedication to positioning Indian steel industry at the forefront of global quality, innovation, technology, and environmental stewardship. These claims have not gone unnoticed. Global audits and visits by international business leaders and government representatives have validated the company’s processes. Delegations from the US, Germany, Sweden and several global manufacturing firms have visited Saarloha to understand how such low carbon steel is being produced in India. Customers in automotive and engineering sectors have shown interest, especially in Europe, where regulatory pressure on emissions is increasing.
A responsible leader, Mr. Goyal is guided by the philosophy of building future-ready organisations. Through his stellar leadership and dedication at Kalyani Steels, and Saarloha Advanced Materials, he demonstrates that strategic vision, disciplined execution, and innovation can transform Indian steel companies into global benchmarks.
Md. Ramzanul Haque Nihad, Managing Director of Amin Mohammad Group (AMG), has ushered the company into a new phase of growth and sustainable progress. Under his direction, AMG, one of Bangladesh’s leading real estate and construction conglomerates, has transformed skylines and improved lives through its wide-ranging projects
With a Bachelor’s in Commerce from Australia, Mr. Nihad entered the family enterprise with the goal of modernising Amin Mohammad Group (AMG). He began as the Director and advanced to Deputy Managing Director of Amin Mohammad Foundation Limited (AMFL), the Group’s flagship entity, in 2015. At just 34, he stepped into the role of Managing Director of AMG in 2020, carrying forward the legacy of his late father, M. M. Enamul Haque, the company’s Founder and Chairman. Stepping into responsibility during a challenging period, he converted adversity into achievement. With his business acumen and strategic approach, he has emerged as one of Bangladesh’s most dynamic corporate leaders. Under his stewardship, AMG has expanded its reach with 157 completed realestate projects and six major residential cities around Dhaka. His signature development, The Valley Bangladesh, introduces a modern township built on sustainability and community-centric design. By blending global quality standards with eco-friendly planning, he has reinforced AMG’s standing as a leading force in the nation’s real estate sector.
Mr. Nihad has aligned AMG’s capabilities with Bangladesh’s national development agenda. He has guided the company’s diversification into large-scale infrastructure through Amin Mohammad Construction Limited. This division has delivered major assignments, including finishing works for the 3rd Terminal of Hazrat Shahjalal International Airport in Dhaka, in collaboration with Samsung. It has also executed projects for the Local Government and Rural Development Division (LGRD), Local Government Engineering Department (LGED), Public Works Department (PWD), Civil Aviation Authority, and Bangladesh Export Processing Zones Authority (BEPZA). Furthermore, following his father’s departure from the business, he assumed full responsibility for the entire enterprise, including six land development projects.

A humanitarian at heart, Mr. Nihad actively participates in philanthropic activities. He ensures that the company’s growth contributes to real social progress. The Group’s CSR programs include daily meal distribution for underprivileged citizens, donation of medical equipment to hospitals, educational support for public schools, and humanitarian relief for flood-affected communities. He also promotes youth development and healthy lifestyles through sustained backing of sports and cultural events. AMG has sponsored the Savar Army Golf Tournament for 16 consecutive years, supported Bangladesh Premier League (BPL) players, and acted as Platinum Sponsor for youth events at Gulshan Youth Club. He is also involved in professional and social organisations, including Entrepreneurs’ Organisation (EO) Bangladesh, and the Real Estate and Housing Association of Bangladesh (REHAB), where he served as Director.
Mr. Nihad’s leadership has earned both national and international acclaim. The leader was honoured with the Young Asian Entrepreneur Award (2019–20) for his outstanding contributions as a nextgeneration leader. His efforts have earned AMG several prestigious accolades, including the Gyproc Trophy for High-Rise Construction Excellence and the Most Improved Company Award from the Aviation Dhaka Consortium. These awards reflect not only AMG’s superior construction standards but also the company’s consistent growth, innovation, and commitment to excellence under his stewardship.
An industry veteran, Mr. Vasal began his work in education with the purpose of building schools that promote critical thinking, character, and curiosity together. Under Vasal Education, he has established institutions across Punjab known for their quality and relevance. From technology-enabled classrooms to experience-based learning and international immersion programs, each initiative reflects his belief that education must prepare students not only for work but for life. His approach inspires students to think independently, act responsibly, and stay aware of the world beyond their classrooms.
Through collaborations and contemporary learning practices, Mr. Vasal keeps his institutions current and relevant. With a strong focus on digital learning, continuous teacher training, and skillbased education, the leader has enhanced the overall classroom experience while making sure that learning goes beyond textbooks and prepares students for real-life challenges.
Guided by a simple and rooted philosophy, Mr. Vasal firmly believes that education is not just about individual success, but about contributing to the collective progress and well-being of society.
Mr. Vasal views learning as a means to equity and inclusion. His institutions run scholarships and outreach initiatives that extend quality education to children from deprived backgrounds. He also promotes participation in the arts, culture, and sports to help students develop confidence, balance, and the spirit of teamwork. As a true leader, he has championed inclusivity by creating pathways for rural youth to gain employability, self-reliance, and equal opportunity. He focuses on education that equips youth with skills for employment. His initiatives also encourage gender balance, environmental responsibility, and civic awareness, shaping learners who contribute thoughtfully to their communities.
Public welfare has always been an inseparable part of Mr. Vasal’s work in education. His initiatives in community service, staff
Mr. Sanjeev Kumar Vasal, Chairman of Vasal Education, perceives education as the linchpin of societal advancement. He has spent more than twenty years meticulously enhancing Punjab’s learning systems with his insight, compassion, and purpose to uplift communities and expand horizons
support and community development across Punjab demonstrate his belief in education for all as a social responsibility, not a slogan. The same steadiness, integrity, and sense of responsibility that define his leadership in education also guide his approach to public service. His work is marked by humility, ethical strength, and a deep respect for people from all walks of life. Mr. Vasal’s lifelong contributions stand as a testament to how education, when pursued with purpose, compassion, and social consciousness, can positively transform individual lives while strengthening the fabric of the society it serves.
Over the years, Mr. Vasal has received several prestigious awards for his outstanding contributions to the field of education. He was recognised as the Education Titans of the Year by Education Today in 2025. The visionary and purpose-driven leader has also been honoured for Excellence in Academics and Innovation by News18 and Education World. In August 2016, Mr. Vasal was invited as an esteemed guest to Rashtrapati Bhavan, New Delhi, in recognition of his noble contributions to society.

When Mr. Awasthi arrived in Uganda in 2000, he brought with him modest capital, deep technical knowledge from North India’s scrapmelting industry, and a bold dream to build something original. Unlike many others, he chose not to depend on imported scrap or semi-finished goods. Instead, he established Uganda’s only primary steel production operation, starting from virgin iron ore to produce cleaner and stronger steel. This bold move set a new industry standard, one that supports factories, fuels construction, and strengthens local economies across East Africa.
Under the determined leadership of Mr. Awasthi, Tembo Steels has consistently broken new ground in Uganda’s steel industry. Driven by his passion for innovation and national development, the leader personally led the company to achieve several historic milestones. In 2004, he spearheaded the launch of East Africa’s first structural steel mill, thereby setting a precedent for local production. In 2012, driven by his progressive stewardship, Tembo Steels established Africa’s first wire rod mill, marking a major leap in regional industrial capacity. By 2025, under his guidance, the company achieved a global breakthrough by developing and producing low-carbon steel from cast iron, engineered specifically for African conditions.
Mr. Awasthi’s vision went far beyond basic manufacturing. He transformed Tembo Steels into a fully integrated steel manufacturer, covering every critical phase of the production process. Its wide range of products, including TMT bars, wire rods, hollow sections, hot-rolled coils, and structural profiles, forms the backbone of infrastructure across the region. The company also holds the distinction of producing the world’s lightest structural steel profiles, along with specialised steel for automotive and industrial applications.
Recognising the importance of local resources, Mr. Awasthi personally championed the expansion of his company’s manufacturing capabilities. Through his efforts, Tembo Steels now operates two major steel plants in Lugazi and Iganga, with a combined annual capacity of 350,000 metric tons. Never one to settle, Mr. Awasthi once again raised the bar with the launch of

SANJAY AWASTHI
Mr. Sanjay Awasthi, Chairman and Founder of Tembo Steels Uganda Limited, has carved an extraordinary path in Uganda’s steel industry. Under his leadership, Tembo Steels has become a symbol of industrial excellence and social responsibility. With his grit, vision, and genuine care for the country he has called home for over two decades, Mr. Awasthi has built a company that not just manufactures steel but also uplifts communities besides powering East Africa’s growth. His success story reflects the power of dreaming big, working hard, and leaving a meaningful mark on an entire region
BY MONALISA CHOUDHURY
Tembo Steels’ second Direct Reduced Iron (DRI) plant in Kasolo Village. Completed in 2025 and inaugurated by President Yoweri Museveni, this facility adds another 250,000 metric tons of capacity, significantly strengthening Uganda’s industrial selfreliance. The President hailed the project as a national milestone and highlighted it as a clear reflection of Mr. Awasthi’s dedication to harnessing Uganda’s domestic iron ore resources instead of depending on imports — an approach that aligns perfectly with the country’s economic goals.
Mr. Awasthi is a true team player who knows that sustainable success depends on nurturing talent and building strong, capable teams. His leadership philosophy—“Know the path, show the path, and step away from the path”— embodies his commitment to empowerment. He values delegation, places trust in his team, and fosters a culture of innovation. Under his guidance, Tembo
Steels’ management structure rewards initiative, promotes accountability, and supports long-term career growth.
Sustainability lies at the heart of Mr. Awasthi’s vision. Driven by his commitment to cleaner industrial practices, Tembo Steels has successfully reduced carbon emissions by 70% through the adoption of advanced technologies like continuous casting and rolling. Guided by his strong environmental principles, the company’s policies prioritise efficiency, accountability, and minimising ecological impact. These dedicated efforts have earned both Mr. Awasthi and Tembo Steels national and international recognition, thus firmly establishing the company as a pioneer in green steel manufacturing.
Mr. Awasthi also believes in giving back to society. Tembo Steels invests over $150,000 annually in social development projects focused on healthcare, education, and environmental conservation. During the
“BUILDING TEMBO STEELS WAS NEVER JUST ABOUT MAKING STEEL BUT ABOUT FORGING A STRONGER AFRICA THROUGH SELF-RELIANCE AND INNOVATION. OUR VISION IS TO ELEVATE UGANDA FROM A LOCAL PLAYER TO A LEADING FORCE DRIVING GROWTH AND PROSPERITY ACROSS THE CONTINENT”
COVID-19 pandemic, the company provided free medical oxygen and supported hospitals with equipment, surgeries, and treatment programs. These efforts have not only saved lives but also fortified Mr. Awasthi’s standing as a compassionate and responsible business leader.
Human capital development is another area where Mr. Awasthi has made a significant impact. Tembo Steels partners with educational institutions to expose engineering students to real-world industrial processes. This practical exposure helps bridge the gap between classroom learning and hands-on experience. In 2023, the organisation welcomed students and faculty from Makerere University’s College of Engineering, Design, Art, and Technology to its plants to provide them with a firsthand view of modern steel production and enrich their learning experience.
What sets Mr. Awasthi apart is his genuine care for the community. Tembo Steels (U) Ltd employs approximately 3,500 workers both directly and indirectly. They also train locals in valuable skills to boost Uganda’s industrial growth. During the COVID-19 crisis, the leader ensured that Tembo Steels produced and donated free oxygen to hospitals—an effort that saved countless lives. Beyond that, the company spends over $ 350,000 annually on community projects such as health care, education, and environmental efforts.
Mr. Awasthi’s dedication has attracted significant attention . The Uganda Investment Authority has lauded Tembo Steel’s multibillion-shilling investments, and Hon. Diana Mutasingwa formally recognised its community contributions. Tembo Steels now stands as a flagship example of private enterprise aligned with national development priorities.
Looking ahead, Mr. Awasthi envisions Tembo Steels as a continental force in steel manufacturing. Leveraging Uganda’s strategic location within regional blocs like COMESA and the AfCFTA, he plans to expand into emerging African markets. Through this regional integration, the company seeks to address the continent’s growing infrastructure needs while setting new benchmarks in quality and sustainability.
BALANCING TASTE, HEALTH, AND SUSTAINABILITY
Mr. Sankha Biswas, Chief Executive Officer of Nutridor Dairy Manufacturing LLC in Dubai, is a revered figure in the food & beverage sector. With deep expertise in the dairy industry and a global business perspective, he exemplifies entrepreneurial precision through his focus on innovation, operational discipline, and sustained performance
Agraduate of Harvard Business School’s Executive Program in General Management, Mr. Sankha Biswas also holds a degree in Dairy Technology from W.B. Agricultural University, India. As the Founding Member and Chief Executive Officer of Nutridor Dairy Manufacturing LLC, he emphasises a strong commitment to quality, innovation, and the delivery of high-value dairy products worldwide. A subsidiary of Tropical General Investments Group (a global conglomerate operating across Africa, the Middle East, and Asia), Nutridor, under his direction, has built a reputation for producing sustainable, high-quality dairy products for households worldwide. His leadership has helped the company emerge as a major player in the FMCG, dairy, and beverage sectors across Southeast Asia.
Earlier in his career, Mr. Biswas served as Vice President (Operations) at Schreiber Dynamix Dairy India, where his focus on value-added manufacturing helped establish operational benchmarks. His recent appointment to the Board of Directors of the UAE Food & Beverage Business Group by the Dubai Chamber of Commerce and Industry reflects his influence within the region’s food sector.
Product quality and nutritional integrity hold particular importance for Mr. Biswas. To ensure Nutridor’s portfolio meets the highest standards and supports consumer health and safety, he personally oversees research and development initiatives. The company’s formulations retain essential vitamins, proteins, and calcium while reducing sugar and cholesterol through rigorous testing and evaluation. One notable example is Abevia, Nutridor’s cholesterol-lowering evaporated milk brand, which underwent five years of development before its successful launch in the Middle Eastern market.
Mr. Biswas believes in steady and sustainable growth while keeping

the environment in mind. He ensures that business expansion goes hand in hand with ecological responsibility and careful planning. By sourcing a substantial share of the company’s energy from solar power, he has reduced the facility’s carbon footprint while enhancing production systems to minimise material waste. Strategic resource planning and efficient manufacturing methods demonstrate Nutridor’s ongoing commitment to responsible operations and environmental stewardship.
A seasoned leader, Mr. Biswas leads with focussed vision and embraces an inclusive approach for empowering his team. He emphasises developing talent through mentorship and professional encouragement to help individuals reach their potential within a culture of accountability and achievement. His active involvement in community initiatives across the UAE and other regions where Nutridor operates reflects his commitment to social impact through fair employment and local engagement.
Mr. Biswas drives Nutridor’s growth by focusing on wholesome dairy products, backed by research in nutrition and taste, and consistent investment in modern facilities. Under his stellar leadership, the brand has earned the prestigious Superbrands UAE award for three consecutive years, with the most recent accolade in 2025, reflecting the organisation’s commitment to excellence, trust, and industry leadership.
Ar. Rane began his career designing schools, not luxury buildings. A UNESCO award for sustainable school development brought him global attention. Soon, his work expanded internationally, with projects in Muscat and landmarks like the Grand Hyatt adding to his growing reputation. Yet, it was his empathy, sparked by the daily struggles of home-seekers in Mumbai that urged a deeper calling. In 2007, he founded Shantanoo Rane & Associates, followed by RedBrick in 2010, with the goal of creating transparent and thoughtful design solutions. His vision reached its full expression in 2014 with the launch of Roswalt Realty — a brand born out of frustration with a broken housing system and driven by the mission of elevating the quality, accessibility, and integrity of real estate in India.
Ar. Rane isn’t the kind of Chairman who leads from behind. He is out in the field, sketching with his team, talking to future homeowners, and engaging in ground-level dialogue with tenants and buyers alike. His leadership is grounded in empathy and active listening, not just boardroom strategy.
One project that reflects Ar. Rane’s people-first philosophy is Roswalt Zaiden, a redevelopment initiative in Mumbai that involved relocating over 2,000 tenants in just four months. Where others perceived logistical hurdles, the humble leader saw stories and souls. He prioritised empathy over efficiency, ensuring that every transition was dignified, humane, and respectful of the communities he built for. For Ar. Rane, that moment marked the true pinnacle of his career. It wasn’t a glittering launch event or a prestigious award ceremony, but the quiet satisfaction of seeing an old site cleared with dignity and rebuilt on a foundation of trust.
Success, for Ar. Rane, isn’t measured by sales but by the satisfaction of witnessing lives transformed by spaces built with care. His work reflects a deep commitment to quality, innovation, and the human experience behind every structure. The leader is a member of the Council of Architecture, Mumbai, and an Associate Member of the Indian Institute of Architects, which speaks of his professional credibility and committment to his field.
Ar. Shantanoo Vishwanath Rane, Founder & Chairman of Roswalt Realty, is a resolute leader whose design brilliance and human-centric philosophy have made the company a trusted name in India’s realty sector. With his unflinching commitment, he oversees every facet of Roswalt’s projects, from conceptual sketches to project completion
Alongside his successful career in real estate, Ar. Rane expanded his entrepreneurial pursuits into the hospitality sector by cofounding Red Thread Hotels with his wife, Mrs. Shweta Rane, reflecting their shared passion for curated dining experiences.
Ar. Rane has left no stone unturned in his pursuit of excellence. His visionary approach has set new benchmarks in urban development, inspiring the next generation of architects and builders. Under his stewardship, Roswalt Realty was honoured with the prestigious Brand of the Year Award 2025 by BARC Asia. Additionally, it received the Best Realty Brand Award 2025 from ET Edge and The Times Group. These awards demonstrate his company’s consistent excellence in design and innovation. Additionally, the leader’s steadfast dedication and hands-on leadership have earned him the Radio City Business Titans Award in 2022 under the category of the Most Promising Group in SRA & Redevelopment. These achievements are a tribute to the leader’s architectural legacy, commitment to timeless design, and the enduring trust of every family he has served.

Mr. Swetang Sinha, Founder and CEO of Trayak Consultancy, leads with integrity, foresight, and empathy. Believing every challenge holds an opportunity, he develops ventures that generate profit while empowering people and uplifting communities across Africa and Asia, reflecting responsible and inclusive leadership
Aforward-thinking leader, Mr. Swetang’s transition from a corporate professional to an entrepreneur with a social compass illustrates his belief that commerce, when guided by conscience, can drive long-lasting positive change. With extensive experience across ICT, hospitality, real estate, mining, and services, he channeled his expertise into founding Trayak Consultancy, a Zimbabwebased firm designed to bridge opportunities between Africa and Asia and to build a shared ecosystem of collaboration and growth.
Before founding Trayak Consultancy, Mr. Swetang began his professional journey at Pearson Education, one of the world’s leading education and media conglomerates. As a Business Development Executive, he cultivated the ability to identify market needs, design practical solutions, and build meaningful relationships. Later, as the Global Brand Manager for Beckett Media, a US-based multinational, he further strengthened his global business acumen by managing cross-cultural teams and driving brand positioning in competitive environments. These roles were instrumental in shaping his belief that every successful brand must resonate with people and connect emotionally as much as it delivers functionally.
Mr. Swetang credits his father, Dr. Sujit Sinha, as his greatest source of inspiration and life lessons. From his father, he inherited the belief that “wealth lies in people,” a philosophy that drives Trayak Consultancy’s vision and culture.
Mr. Swetang has positioned his firm as a dynamic advisory partner for the Africa and Asia markets. Under his guidance, Trayak Consultancy has executed initiatives ranging from community-based sheep rearing in Zambia to hospitality development in Uganda and real estate projects across six countries. Each reflects his focus on building practical, self-

sustaining systems that strengthen local participation.
Rejecting rigid hierarchies, he promotes dialogue and shared accountability across all levels of the organisation. Through open communication and a conscious effort to reduce structural distance, he has encouraged a workplace where ideas circulate freely and responsibility is collectively owned.
The company assists clients in sectors such as mining, taxation, and ESG compliance, reinforcing the firm’s commitment to ethical and sustainable enterprise. By helping Indian companies recover from disruption and supporting African firms in scaling operations, Mr. Swetang has expanded Trayak Consultancy’s reach while preserving its integrity.
Through Trayak Consultancy, Mr. Swetang supports local employment, youth training, and community-driven projects. He believes that true leadership gains purpose only when it creates opportunities for others. For him, success is measured by the positive chain it sets in motion. Apart from the demands of business life, his family remains his compass, reminding him that the truest form of achievement lies in balance, gratitude, and shared growth.
Those who know Mr. Swetang, describe him as a grounded and thoughtful individual. He listens more than he speaks, observes before acting, and ensures that every decision reflects fairness and foresight. His success story is a reminder that great leaders are not defined by the magnitude of their achievements but by the sincerity of their actions and the lives they touch along the way.
Awell-versed leader, Mr. Aijazuddin holds certifications from the Chartered Insurance Institute (UK) and America’s Health Insurance Plans (USA). Over the years, he has held several senior positions, including Underwriting Manager and CEO, in KSA and India. With over 30 years of industry experience, he has led Acess Meditech to new heights by introducing an AI-powered ERP platform that has revolutionised insurance verticals like property, health, auto, and group life. The leader focusses on people-centric design to empower insurers and policyholders. He also ensures that AMTPL’s solutions are purpose-driven and designed to address real-world industry challenges and liberate insurers from outdated legacy systems. Additionally, by integrating artificial intelligence (AI), predictive analytics, and natural language processing, he has enabled insurers, TPAs, brokers, and aggregators to deliver faster, smarter, and more personalised services.
Mr. Aijazuddin’s innovation-driven leadership has positioned AMTPL as a trusted digital insurance provider. His approach to innovation is deeply tied to delivering long-term impact and meaningful value. By integrating multilingual AI assistants and machine learning tools for fraud detection, he has elevated customer experience and streamlined backend operations, with a strong focus on speed and responsiveness in delivery. He has also redefined client engagement by offering full ownership of ERP systems, from development to delivery and support. Simultaneously, he ensures AMTPL’s ERP systems are aligned with local and global insurance regulatory standards.
Like a true leader, Mr. Aijazuddin inspires his team to think independently while encouraging them to align their thinking with the company’s vision. He maintains an open door policy that encourages team members to share their ideas, challenges, and feedback. He firmly believes that every idea, regardless of scale, adds value to the company.
Sustainability is prioritised and actively promoted under Mr. Aijazuddin’s leadership. It is integrated into every product and process. By digitising workflows and shifting from paper to cloud-based solutions, AMTPL, under his guidance, has significantly reduced its environmental footprint. Likewise, automated and predictive models deployed by the organisation have helped minimise waste and redundancies, thereby allowing smarter resource management.
Mr. Syed Aijazuddin, the CEO at Acess Meditech Private Limited (AMTPL) has scripted a remarkable saga of excellence in the insurance technology sector. His stewardship has propelled the company to the forefront of the MENA region’s InsurTech ecosystem, thereby bringing a global perspective to InsurTech Innovation
Under Mr. Aijazuddin’s direction, AMTPL upholds the highest standards of governance. It has also built a strong presence in the Middle East and Africa, with plans for global expansion. The leader advocates for diversity and inclusion, and believes that only diverse ideas can drive sustainable growth and meaningful innovation. His commitment to responsible technology use and ethical decision-making, driven by a culture of ongoing refinement, has positioned him as a revered thought leader.
Mr. Aijazuddin’s business acumen and forward-thinking vision have earned AMTPL well-deserved industry recognition. The company was honoured as ‘Company of the Year’ by Silicon India for its dominant market presence. Likewise, APAC CIO Outlook acknowledged its innovation by naming it a ‘Top Insurance Tech Solution Provider.’ Additionally, the ‘Insurance ERP Product of the Year’ award from the National Choice Awards solidifies the company’s position as a front-runner in delivering pioneering insurance technology solutions. Looking ahead, he plans to grow AMTPL’s reach globally and establish it as a leading InsurTech provider of scalable ERP systems for while helping clients build sustainable businesses.

CA. Sunil Kumar Aggarwal Founder & Managing Director of Kumar Sunil & Associates (KSA) is a leader with an unshakeable vision. From a humble office in Punjab, he laid the foundation for a firm that now serves India’s top banks, corporates, and multinationals. CA. Sunil Kumar’s journey is a saga of resilience, growth, and relentless pursuit of excellence
CA. Sunil Kumar is a seasoned financial expert specialised in Statutory and Internal Audits, Risk Advisory, Corporate Governance, Tax Audits, IFRS Services, Investigations, and Corporate Financial Advisory. He also holds advanced certifications (DISA, FAFD, and CCA), which indicate his deep commitment to technical expertise and ethical leadership.
The forward-thinking leader is driving KSA toward unprecedented global expansion, with a strategic focus on Southeast Asia, the Middle East, and North America, to further strengthen the firm’s crossborder advisory reach.
With over 39 years of experience, CA. Sunil Kumar has turned every challenge, whether regulatory upheaval, technological disruption, or market volatility, into a stepping stone for growth. His stellar stewardship and results-driven approach have propelled KSA to new heights of success. From ESG audits and forensic accounting to risk management and M&A advisory services, the firm delivers 360-degree solutions tailored to each client’s specific needs. This commitment to customisation sets them apart in a space often crowded with templated services. The leader’s powerful philosophy, “Put your heart in the business and the business in your heart,” has guided KSA through testing times and enabled the firm to earn the trust of clients across the banking, financial services, FMCG, and tech sectors. His ability to lead with heart empowers others to rise above challenges and lead with impact.
CA. Sunil Kumar credits KSA’s success to his passionate team. With over 100 professionals, including 25 Chartered Accountants, he has cultivated a culture of mentorship, continuous learning, and innovation.

His role in shaping a knowledge-driven workforce, forging influential partnerships, and spearheading digital transformation deserves a special mention. By investing in next-gen technologies such as AI and blockchain and emphasising ESG-led growth, he has redefined the standards of excellence and sustainability in cross-border financial advisory.
As the financial landscape grew more complex with digitisation, global transactions, and evolving regulations, CA. Sunil Kumar understood that legacy alone would not suffice. The firm needed new energy — a leadership team that could balance experience with innovation. This transition came naturally with the induction of CA. Aseem Aggarwal and MBA Aakash Aggarwal from Rotman school of Business, Toronto ,who brought their own strengths and insights while upholding the foundational ethos of the firm.
CA. Sunil Kumar advises aspiring entrepreneurs to stay resilient and lead with integrity. These words are the very foundation upon which the values-driven leader has built his legacy. From a modest one-room office to the helm of a nationally acclaimed advisory firm, his journey reflects resilience, clarity of purpose, and values-driven leadership.









The vision of Viksit Bharat is far more than a national aspiration; it is a resolute pledge to realise India’s highest potential in every domain of human progress. This journey reflects the steadfast dedication of countless citizens and the exceptional contributions of visionary leaders who transform collective resolve into enduring reality.
Across economic prosperity, scientific advancement, cultural renaissance, and social equity, India’s rise bears the imprint of determined minds and indomitable spirits. The Viksit Bharat Commitment Award salutes these exemplary individuals from diverse fields whose foresight and perseverance are helping build a stronger, sovereign, and more inclusive nation.
By presenting their inspiring journeys, we pay tribute to the insightful influence they exert on India’s evolving identity and its march toward developed-nation status by 2047. May their selfless efforts serve as inspiration now and in the years ahead, to live with purpose, strength, and service, and keep India moving toward true development
Sadhguru was born in 1957 in Mysore, India. He was a fearless rebel since his childhood. Snake catching and venturing into the wilderness used to be his favourite pastimes in those days. He graduated with a Bachelor’s degree in English from Mysore University. The profound mystic rethought the purpose of his life at the age of 25 after undergoing a spiritual experience. He eventually discovered his true calling and became a yoga teacher. With his ability to make ancient yogic sciences relevant for modern minds, the spiritual leader has transformed how young people view yoga and spirituality. According to him, yoga can help mortals generate happiness from within and mould their destinies.
Sadhguru is known for his sharp intellect, unstoppable passion and dedication to spreading yoga and spirituality among the youth worldwide. His life’s mission is to nurture physical, mental, and spiritual well-being of everyone, driven by his deep experience of the Self, which has enabled him to master the mechanisms of life. Millions of followers worldwide seek his guidance on spirituality, meditation, and the “realm of mysticism.” As a leader, he is credited with creating the historic Dhyanalinga – the mission of three lifetimes. Yet, he says he knows nothing, consults no scriptures, and calls himself an “uneducated” Sadhguru—the true guru by experience, sought by millions for meditation, mysticism, and life guidance.
The spiritual leader has devised a unique set of activities to promote universal values and religious harmony through this meditation technique. His life experience is not based on teaching, philosophy, religion, or belief system. His scientific methods for self-transformation offer a direct and effective alternative to mere customs and rituals. The humble leader says, “The word ‘Sadhguru’ is not a title. It is a description. Sadhguru means’ uneducated Guru.’ I don’t know any scriptures. I come only from my inner experience. The only thing I know is this piece of life from its origin to its ultimate.”
In 1992, Sadhguru founded the Isha Foundation near Coimbatore. With human well-being as its primary objective, the nonprofit organisation operates an ashram and a yoga centre that carries out educational activities. A total of 16 million volunteers support its 300 centres worldwide.

SADHGURU
Indian yoga guru Jagadish Vasudev, popularly known as Sadhguru, is a spiritual visionary who has been teaching yogic sciences across southern India since 1982. His life represents an extraordinary saga of spirituality, selfrealisation, and service to society. A charismatic speaker and influential opinionmaker, Sadhguru has consistently shaped public discourse on wellbeing and consciousness. Recognised among India’s 50 most influential personalities, he is the only Indian to receive three presidential honours, including the prestigious Padma Vibhushan, India’s highest annual civilian honour
BY MONALISA CHOUDHURY
Through Sadhguru, the Isha Foundation is dedicated to exploring the ancient science of yoga in its entirety. The Foundation offers several programmes to help individuals achieve physical, mental and spiritual wellbeing. These programmes have powerful transformational effects on the human body. Among the most crucial flagship programmes he offers to help people gain a balanced life are the Inner Engineering programmes.
A MULTI-TALENTED INDIVIDUAL
Sadhguru’s vision gives him a special place in spirituality, business, environment, and international affairs. He is a voracious writer and has authored two New York Times bestsellers – a rare feat in the publishing genre of spirituality and mysticism. He has a very strong social media and digital media presence. Over 2.44 billion views of his videos on social media in 2021 made him the world’s most popular spiritual guide. In addition to being a delegate to the United Nations Millennium World Peace Summit,
Sadhguru is also a member of the World Council of Religious and Spiritual Leaders and the Alliance for New Humanity. He has been invited to the Australian Leadership Retreat, Tallberg Forum, and Indian Economic Summits 2005-2008. He also attends the World Economic Forum regularly.
A celebratory participant in all aspects of life, Sadhguru’s interests span architecture, visual design, poetry, painting, aviation, driving, sports, and music. His insights have led to the establishment of the Sadhguru Center for a Conscious Planet at Beth Israel Deaconess Medical Center, the teaching hospital of Harvard Medical School. The Yogi believes that insight, integrity and inspiration are the essential attributes of a leader. The wise and witty leader has been interviewed by BBC, Bloomberg, CNBC, CNNfn, and Newsweek International for his understanding of modern social and economic issues. Additionally, the leading national newspapers in India
“SADHGURU HAS UNDERTAKEN MASSIVE ECOLOGICAL INITIATIVES TO DEAL WITH BURNING ISSUES SUCH AS SOIL, WATER AND CLIMATE CHANGE. THERE ARE NOW 3.91 BILLION PEOPLE INVOLVED IN SADHGURU’S SAVE SOIL MOVEMENT, MAKING IT THE LARGEST PEOPLE’S MOVEMENT IN THE WORLD”
regularly publish his insights. His public talks and satsangs (group meditations) regularly draw crowds of over 3,00,000 people.
As an international speaker, Sadhguru is sought after by several prestigious global forums around the world. Aside from human rights, he also addresses issues related to business values, social issues and environmental concerns. He has also spoken at the UN General Assembly, the UNCCD COP15, and other international forums. In addition, he has spoken at institutions such as the World Economic Forum, the World Bank, the House of Lords, the University of Oxford, MIT, Google and Microsoft. The indepth knowledge and incisive approach that Sadhguru brings to current issues and world affairs have made him a constant favourite among his listeners and followers.
Sadhguru carries out several sizeable human service initiatives through the Isha Foundation. To date, the Foundation has assisted 1,32,000 farmers in growing 62 million trees, provided healthcare to 7 million clients in rural areas, and educated over 10,000 rural children. The Foundation and its various initiatives have received worldwide recognition, including Observer status at the UN Environment, membership in the IUCN, accreditation by the UNCCD, and UN Climate Change Compendium inclusion.
Sadhguru has led major ecological initiatives tackling soil, water, and climate issues. He launched Rally for Rivers in 2017, backed by 162 million people, making it the world’s largest environmental campaign. In 2019, he started Cauvery Calling to revive the Cauvery river in South India, aiming to plant 2.42 billion trees over 12 years through agroforestry in the river basin..
During his 30,000-kms motorcycle journey from Europe to Southern India, he inspired citizens, influencers, business and government leaders to prioritise soil revitalisation. There are now 3.91 billion people involved in Sadhguru’s Save Soil movement, making it the largest people’s movement in the world. The movement has so far attracted 81 nations, which is indeed a commendable achievement.
Anish’s quest began far from the spotlight. Raised in an environment where stock markets were considered risky or speculative, he received no formal financial education to lean on. Yet, he compensated for this with a deep sense of curiosity, relentless hard work, and disciplined focus. Driven by the need to take control of his future, he dove into books, backtesting tools, and real market experiences. By doing so, he didn’t just learn to trade but also learned how to teach others to think like traders.
For Anish, the early days were anything but glamorous. He experienced the familiar rollercoaster every independent trader faces—losses, small victories, hard-earned lessons, and countless hours spent honing his strategies. Instead of letting early setbacks discourage him, he embraced them as stepping stones in the learning process. Each setback refined his approach and sharpened his focus on discipline and risk management. Over time, these experiences shaped his powerful trading philosophy: sustainable success comes not from tips or shortcuts, but from a focus on mindset, process, and risk management.
In mid-2020, as the world was adjusting to the global lockdown caused by the COVID-19 pandemic, Anish decided to try something different. He uploaded a YouTube video explaining intraday trading in a way that made sense. No fluff, no fancy jargon—just straight talk. That video didn’t just do well but went viral, striking a chord with thousands.
Soon, his words spread like wildfire and thousands of viewers started subscribing to his channel, not to get rich overnight but to understand the markets in a way they never had before. His calm delivery, straightforward attitude, and ability to speak plainly resonated with a generation weary of flashy gurus and empty promises.
Within years, his YouTube channel transformed from an experimental effort into a vibrant digital classroom with over a million subscribers. Today, with over 2 million followers and counting, Anish has become the go-to guy for anyone who wants to learn trading without the smoke and mirrors. His courses don’t promise miracles but prepare students for the realities of the market.
Anish established Booming Bulls Academy on the belief that financial education

ANISH SINGH THAKUR
As the founder and CEO of Booming Bulls Academy, Mr. Anish Singh Thakur has built more than just a successful business. Through his thoughtful approach to trading and investing, he has emerged as a rare voice of reason and realism. By teaching the importance of managing risk and thinking long-term, the young and dynamic leader has empowered many to take control of their financial futures with confidence. Each lesson delivered by him serves as a pillar of financial empowerment. His journey is not just a success story but a saga of resilience, vision, and unwavering commitment to financial literacy
BY MONALISA CHOUDHURY
should empower, not exploit. Today, the organisation, under his stellar leadership, stands as a trusted source for Indians seeking realistic financial literacy. Also, the organisation has grown to include over 250 employees and has trained more than 35,000 students.
The leader’s mission is to make financial independence attainable for all. His focus on trust and transparency has set a new standard in an industry often plagued by scepticism. While many platforms chase rapid growth through aggressive marketing, he has ensured that Booming Bulls prioritises building trust, clarity, and structure. For many, he is the first person to tell them that “financial freedom isn’t a product but a practice. And that mindset, once developed, can change not just bank accounts, but lives.”
In a digital world where money is often portrayed through luxury, cars, and sensational returns, Anish’s calm voice reminds people of the importance of patience
and clarity. He actively discourages trading as a side hustle or a shortcut. Instead, he treats it as a profession that demands as much discipline and learning as law or medicine. This message is resonating, especially with India’s young, ambitious, and digitally connected population.
Anish’s goal was never just about selling courses; it was about making a meaningful impact. He aimed to establish a space where young Indians, regardless of their background or experience, could feel confident in managing their finances. Whether they wanted to trade full-time or just learn more about finances, Booming Bulls was made to teach discipline, not just share information.
Booming Bulls Academy is now entering a bold new chapter. With the significant growth of the company, Anish is steering his focus from hybrid learning models toward powerful execution on the trading
“ANISH EXEMPLIFIES IMPECCABLE BUSINESS ETIQUETTE THROUGH HIS VISIONARY LEADERSHIP, PROFESSIONALISM, AND STRATEGIC BUSINESS ACUMEN. HIS POISED COMMUNICATION AND ETHICAL INTEGRITY HAVE HELPED HIM DRIVE EXCEPTIONAL BUSINESS RESULTS”
floor. The team is in the process of setting up a fully operational trading floor in Dubai, designed not to teach, but to trade. His long-term objective is to make the leap from retail education to playing in the big leagues of institutional-level trading. This transition involves managing proprietary capital, assembling a team of full-time analysts and traders, and ultimately launching a hedge fund that’s ready to shape the global markets. Although online education will continue to be a part of the offering, the primary focus is shifting gears toward performance-driven results, strategic precision, and establishing a globally competitive trading firm that can compete on the world stage. For Anish, it is a natural progression —he’s always been one to lead by example and let his actions speak louder than words.
When you do things right, people take notice. And that’s exactly what happened. In 2022, Anish was awarded the Millennium Brilliance Award as India’s most impactful stock market trainer. Booming Bulls Academy also bagged the title of Most Trusted Stock Market Learning Platform at the Atal Achievement Awards. The young leader has also been featured in leading publications including The Times of India, Hindustan Times, and Economic Times. But for Anish, awards are just the cherry on top. What matters most is seeing his students stand on their own feet. That’s the real win.
The humble leader stays hands-on by consistently sharing fresh and engaging content, answering questions from followers, and improving the quality of education through the Academy. For him, success isn’t just about crunching numbers or chasing metrics; it is about how many people gain the confidence to take the bull by horns and manage their own money wisely, without falling into the trap of fake promises or get-rich-quick illusions. From a self-taught trader to a trusted educator and now a global player, he has redefined what financial education can be in India. His work has given millions the tools to think differently about money, not as a source of fear or speculation, but as a space for responsibility and lucrative opportunities.
Dr. Vishal holds an MBBS degree from the University of Mumbai and a PhD in Cell Biology and Molecular Genetics from the University of Maryland, USA. He received the prestigious Medical Research Fellowship from “The Walter Reed Army Institute of Research.” His academic and research background have shaped his ability to lead product development in key areas such as Chemically Defined Serum Free Media (CDSFM) for Biopharma, Media for cultivated meat, Bioinks for 3D Bioprinting Lymphocyte Separation Media, and Viral Transport Media.
HiMedia was established in 1974 by his parents, Dr. Gangadhar M. Warke and Mrs. Saroj G. Warke, along with his uncle Mr. Vishnu M. Warke, with a vision of providing affordable, high-quality culture media to researchers across India. Dr. Vishal G. Warke and his wife Dr. Priti V. Warke (Director of Cell Culture & Head of Regulatory Affairs, HiMedia) have been instrumental in broadening the company’s scope and enhancing its global presence. Under their guidance, HiMedia has expanded beyond its earlier domain, by developing a diverse portfolio in cell biology, molecular biology, plant tissue culture, biochemicals, laboratory consumables, and hydroponics solutions. This diversification reflects HiMedia’s keen grasp of evolving scientific needs and commitment to making quality products and solutions accessible to the wider scientific community.
Dr. Vishal emphasises the pivotal role of rigorous research and development (R&D) in sustaining HiMedia’s legacy of innovation. Thus, he invests 16% of the company’s profits into R&D to support innovative projects. A notable example of such investment is the acquisition of the Orbitrap Fusion Tribrid Mass Spectrometer, which has significantly strengthened HiMedia’s expertise in metabolomics, proteomics, and peptidomics. This high-resolution technology helps in accurate identification and quantification of biological compounds, thus contributing to advancements in key areas like proteomics, metabolomics and biomarker research. HiMedia, under his guidance, has also made significant strides in the development of bioscaffolds for 3D bioprinting, enabling possibilities like autologous organ transplantation. Under the stewardship of Dr. Vishal & Dr. Priti, company

DR. VISHAL G. WARKE
Dr. Vishal G. Warke, a qualified MBBS and PhD holder, leads as the Director of Cell Biology and Hydroponics at HiMedia Laboratories Pvt. Ltd, which is a globally trusted brand with a presence in over 150 countries. HiMedia transformed from its modest origins in 1974 as a small microbiology media manufacturer in Mumbai into a leading global provider of advanced bioscience solutions & products. The company offers more than 30,000 SKUs, which empowers the healthcare, pharmaceutical, food and beverage, cosmetic, agriculture, and biopharma sectors
BY MONALISA CHOUDHURY
has also pioneered the development of animal-free media tailored for cultivated meat production, which offers specialised formulations for CHO cells and general cell culture applications. These advanced media are precisely formulated to promote robust cell growth and differentiation without relying on conventional animal serum, thereby reducing production costs while addressing ethical and sustainability concerns associated with conventional serum-based methods. These initiatives collectively align with global objectives to lower carbon emissions and advance ethical food production.
Dr. Vishal’s remarkable achievement is steering HiMedia into the cultivated meat sector. He has led the development as well as large-scale production of cost-effective, serum-free media formulations which are essential for producing high-quality meat without the use of animals. This initiative fosters sustainable food production while
“DR.
advancing innovation, thus establishing HiMedia as one of India’s leading bioscience enterprises with a significant contribution to this rapidly expanding global industry.
In 2020, at the peak of the COVID-19 pandemic, Dr. Vishal & Dr. Priti spearheaded a rapid and large-scale production effort to meet the Indian government’s urgent demand for Viral Transport Medium (VTM) kits. Under their guidance, HiMedia ramped up production of VTM from 0.5 million kits per year to a staggering 1 million kits per day. This swift response played a vital role in strengthening India’s COVID-19 diagnostic efforts and signified HiMedia’s reliability during a national emergency. Prior to that, Dr. Priti led the rapid development of HiViral–VTM within two months during the 2009 H1N1 epidemic, a product which later became crucial for COVID-19 testing nationwide. Further, Dr. Vishal established a cGMP-certified facility in Nashik, thus ensuring HiMedia’s operations adhere to the highest global regulatory standards.
VISHAL EMPOWERS BIOTECH STARTUPS BY OFFERING MENTORSHIP & ACCESS TO HIMEDIA’S INFRASTRUCTURE. HIS COLLABORATIVE APPROACH BRIDGES THE GAP BETWEEN ACADEMIA & INDUSTRIES, ACCELERATING INNOVATION AND BUILDING STRONG PARTNERSHIPS WITH UNIVERSITIES, RESEARCH INSTITUTES, AND EARLY-STAGE COMPANIES”
He further advanced the company’s international footprint by setting up offices and warehouses in the USA and Germany, significantly improving product accessibility and customer support worldwide.
As a champion of innovation, Dr. Vishal mentors numerous biotech startups and provides them access to HiMedia’s infrastructure. His collaboration with earlystage companies helps bring innovative ideas to market quickly. His commitment to multidisciplinary collaboration has enabled him to build strong partnerships with various national and international universities, research institutions, and industrial leaders.
Dr. Vishal’s commitment has brought him as well as HiMedia numerous accolades. In 2023, he received the “Best Innovator for COVID-19 Solutions” award at the BioSpectrum India Excellence Awards and also won the “BIRAC Innovator Award” in 2020. HiMedia was named the ‘Best Company of the Year 2018’ in the ‘Pride of Maharashtra’ awards by the Maharashtra Industrial and Economic Development Association. It was also honored at the Maharashtra State Level in the Biosciences category and was invited to the ‘Make in India Week’ event held in Mumbai in 2016. His work in areas like biosimilar media, T-cell receptors, and systemic lupus erythematosus is also recognised internationally, with over 20 research papers published in high impact journals.
Under his guidance, HiMedia has partnered with the Indian Institute of Technology, Bombay to establish the Wadhwani Research Centre for Bioengineering (WRCB)–HiMedia Bio-Innovation Centre, a state-of-the-art facility dedicated to advancing research and entrepreneurship in healthcare and life sciences. This collaboration has strengthened initiatives such as patent facilitation and deep-tech entrepreneurship fellowships, with a strategic focus on diagnostics, therapeutics, 3D cell culture, cancer biology, and synthetic biology. He also led HiMedia’s donation towards establishing a Regenerative Medicine Research Centre at Sir J.J Hospital, Mumbai, in developing stem cell therapies for eye care.
In an industry often seen as complex and distant for the average policyholder, Mr. Gomes has consistently stressed simplicity and accountability. “In insurance, trust is not built through promises but through consistent action,” he says. His career across insurance and banking, both in India and overseas, has given him a practical understanding of risk, regulation, and customer expectations. At Ageas Federal Life Insurance, he focuses on building a stable, responsible organisation that delivers long-term value to policyholders.
Mr. Gomes’s professional life spans more than 30 years across insurance and banking. His vast experience gives him a rare, balanced view of risk, capital, and customer trust. Early in his career, he played a key role in shaping India’s private life insurance sector as part of the founding teams at HDFC Standard Life and HSBC Canara OBC Life Insurance. These assignments placed him at the heart of a newly liberalised market, where credibility had to be earned policy by policy.
His professional path later took him beyond Indian shores. As Chief Executive Officer of Manulife China Bank in the Philippines and subsequently CEO of Union Assurance PLC in Sri Lanka, he led businesses across varied markets. These roles required close engagement with regulators, partners, and employees, while adapting strategies to local realities. “Different markets teach you different lessons, but the basics of governance and respect for the customer remain the same everywhere,” he explains.
Mr. Gomes also held key regional roles that sharpened his strategic outlook. At Manulife Vietnam, he was responsible for partnership distribution, and at HSBC’s Asia-Pacific headquarters in Hong Kong, he worked on business development initiatives across the region. Reflecting on this phase, he noted, “Working across Asia helped me understand scale, partnerships, and the importance of patience in building institutions.
His association with the Ageas Group deepened when he served as Regional Director, Business Development – India, at Ageas Asia, based in Hong Kong. In this role, he worked on strengthening the group’s India strategy and preparing the organisation for the next phase of growth.

JUDE GOMES
Mr. Jude Gomes, Managing Director and Chief Executive Officer of Ageas Federal Life Insurance, represents a leadership journey closely aligned with the growth of India’s insurance industry. With over three decades of experience, he has consistently demonstrated balanced decision-making, strong governance, and a people-first approach. His career reflects strong institutional understanding, long-term vision, and resilience through market cycles. Above all, he has reinforced the belief that credibility, customer trust, and ethical conduct form the backbone of insurance businesses in India
BY MONALISA CHOUDHURY
“India needs insurers who think long term and invest with conviction,” Mr. Gomes has remarked. His appointment as MD & CEO of Ageas Federal Life Insurance brought this global experience back into an Indian operating context.
DRIVEN BY GOALS
Under his able leadership, Ageas Federal Life Insurance has set clear growth targets. The leader aims to nearly triple the company’s premium income to around ₹ 4,000 crore by 2028 and to enter the top ten life insurers in the country. “Growth will come from widening our distribution and being present where customers actually are,” he said, outlining the company’s expansion plans. The plan rests on widening distribution channels and strengthening the company’s presence across regions, especially beyond metropolitan centres. It is a strategy anchored in reach and relevance rather than headline-grabbing deals.
What sets Mr. Gomes apart is his consistent emphasis on people. He believes that strong organisations are driven by trust, empathy, and open communication, and this belief is reflected in his leadership style. Colleagues often describe him as a leader who listens carefully before he speaks. He takes the time to understand diverse perspectives and ground realities before making decisions. He is known for actively interacting with teams at all levels and closely monitoring operational details. This habit has helped align strategy with reality, ensuring that decisions taken at the top reflect conditions on the ground. His belief in talent development has resulted in strong second-line leadership within the organisations he has led.
Digital adoption and data-led decisionmaking have also gained significant momentum under his stewardship. At Ageas Federal Life Insurance, technology
“A SEASONED INSURANCE LEADER, MR. JUDE GOMES BRINGS TOGETHER GLOBAL EXPERIENCE, PEOPLE-FIRST LEADERSHIP, AND STRONG GOVERNANCE TO BUILD TRUST, ENSURE STABILITY, AND DRIVE RESPONSIBLE AND LONG-TERM GROWTH IN INDIA’S LIFE INSURANCE SECTOR”
is viewed as an enabler of efficiency and transparency, not as a replacement for human judgement. Mr. Gomes has consistently backed strategic investments that improve service delivery, claims management, and customer engagement, while insisting on strong risk controls and ethical marketing practices.
Equally important is his focus on purpose. Mr. Gomes has consistently argued that insurers must play a constructive role in society, especially in a country where financial protection remains uneven. Community engagement, health awareness, and education feature prominently in the company’s outreach efforts. These initiatives are not treated as side projects but as extensions of the organisation’s responsibility to the communities it serves.
As the insurance sector faces tighter regulation and rising customer awareness, Mr. Gomes’s measured leadership style offers stability. He avoids grand claims and places emphasis on governance, execution, and trust. His career reflects an understanding that trust, once lost, is hard to regain, and that long-term credibility matters more than quarterly applause.
Under Mr. Gomes’ leadership, Ageas Federal Life Insurance has strengthened its commitment to inclusive and sustainable growth. The company was honoured with two prestigious recognitions at the FE Green Sarathi Awards 2025, organised by The Financial Express. Ageas Federal Life Insurance received the Sustainable Community Leadership Award and the Community Sustainability Initiatives Award in recognition of its impactful work in empowering adolescent girls across India through focused health and education programmes.
These thoughtful initiatives have been designed to address critical social challenges at the grassroots level, particularly in underserved communities, by improving access to healthcare awareness, education, and life skills for young girls. By investing in their well-being and future potential, the company is contributing to long-term community development and social resilience.
Adual-degree graduate from IIT Delhi, with a B.Tech. and M.Tech. in Computer Science and Mathematics, Mr. Piyush firmly believes that India can develop world-class products for the global market. As one of GlobalLogic’s founding members, he helped grow the company from a small startup into a global enterprise now valued at over $2 billion — a remarkable journey that mirrors his own professional evolution.
Since taking over as Managing Director and APAC Head in April 2023, Mr. Piyush has steered the company through an era of steady expansion. Under his leadership, the APAC business has grown by around 20% year-on-year, even in a challenging market. The GCC region has performed even better, recording over 60% growth annually for three consecutive years.
Under Mr. Piyush’s direction, GlobalLogic has strengthened its presence in Japan, expanded rapidly in Australia and Saudi Arabia, and built a strong pipeline of clients across new markets. He has led office expansions, acquisitions, and client partnerships, keeping the company ahead of industry trends while ensuring delivery excellence.
A forward-thinking leader, Mr. Piyush started investing in technologies such as Generative AI, quantum computing, and the metaverse long before they became mainstream. His early bets have paid off, with GlobalLogic now delivering GenAI solutions to over 50 clients through its inhouse platform, Velocity.ai, supported by a team of more than 3,000 GenAI specialists across APAC. By prioritising collaboration over competition in the GCC, he has strengthened client relationships and driven consistent growth.
Mr. Piyush has also championed industry-academia partnerships through collaborations with eight engineering colleges to co-sponsor advanced technology programs while recruiting top talent. These initiatives reflect his commitment to nurturing the next generation of professionals and preparing the workforce for tomorrow’s digital challenges.
Mr. Piyush describes his leadership style as hands-on, people-focused, and collaborative. He prefers being on the ground with his teams, guiding them by working

PIYUSH JHA
Mr. Piyush Jha, Managing Director at GlobalLogic, has played a significant role in turning the company into one of the world’s leading digital engineering firms. Known for his practical approach and deep understanding of business and technology, he has strengthened operations across India and the APAC region by driving innovation, nurturing talent, and ensuring sustainable growth. His business acumen, balanced leadership style and consistent performance have earned him wide respect across the industry. His success saga reflects a journey of innovation, strategic thinking, and industry-wide influence
BY MONALISA CHOUDHURY
alongside rather than from a distance. This approach has helped build accountability and trust, besides helping teams deliver their best without fear or pressure. Like a true leader, he places people at the centre of organisational success, thereby cultivating a culture of generosity, shared success, and mutual support. His leadership is built around shared success, openness, and empathy, which make him both approachable and respected. Mr. Piyush’s balance of camaraderie and principle has made his leadership both effective and enduring.
Leading GlobalLogic’s India and APAC operations has been a key milestone in his career. From his early days as a founding member to his current leadership role, he has driven digital transformation for Fortune 500 clients worldwide. Post-pandemic, he recognised the untapped potential of Tier 2 and Tier 3 cities such as Nagpur, Ahmedabad, Kochi, and Mahbubnagar. These locations now serve as high-performing delivery hubs, known for exceptional engagement,
low attrition, and consistent quality.
Aligned with India’s vision of Viksit Bharat@2047, Mr. Piyush has emphasised building India as a global R&D and digital engineering hub. Strategic acquisitions and home-grown innovation have strengthened healthcare, MedTech, and embedded software capabilities. Satellite offices in Tier 2 and 3 cities, industry tie-ups, and GenAI programs democratise access, generate employment, and promote inclusive innovation.
Mr. Piyush aims to position GlobalLogic as a value-driven, innovation-first leader on the global stage, with APAC serving as a key growth engine. His strategy revolves around three core priorities. First, he is committed to bold innovation, increasing investment in next-generation technologies, such as GenAI, metaverse applications, quantum computing, embedded systems, and MedTech solutions. Second, he focuses on expanding the company’s reach by scaling delivery capabilities across India
“MR. PIYUSH’S MOTIVATION STEMS FROM A DEEP-SEATED BELIEF IN INDIA’S POTENTIAL. HE DRAWS INSPIRATION FROM THE NATION’S HERITAGE AND BELIEVES TECHNOLOGY OFFERS A UNIQUE OPPORTUNITY
and APAC through a combination of organic growth and strategic acquisitions. Finally, he seeks to create enduring value by delivering outcome-oriented platforms, full-stack innovation, and sustainable solutions that benefit clients, employees, and society alike.
For Mr. Piyush, sustainability is a fundamental business priority. Under his direction, four GlobalLogic offices have achieved zerocarbon certification, and more than 80,000 trees have been planted using the Miyawaki method. Energy-efficient systems, LEEDcertified workspaces, and the phasing out of single-use plastics have all helped shrink the company’s carbon footprint. Initiatives like electric vehicle fleets, the GreenMover app, and Sustainability-as-a-Service platforms reflect his belief that technology and sustainability go hand in hand. GlobalLogic’s strong ESG practices have earned it an EcoVadis Silver Rating, placing it among the top 15% of companies worldwide. The company also uses digital CSR tracking to ensure that every environmental and social initiative creates a tangible, measurable impact.
Under Mr. Piyush’s leadership, GlobalLogic upholds transparency, accountability, and ethical integrity, guided by a Board-level CSR Committee. The company also enforces strong frameworks for data security, privacy, and AI ethics. Diversity, equity, and inclusion (DEI) have been another area of focus. APAC operations now exceed global benchmarks for female representation, thanks to inclusive recruitment practices and robust disability support policies.
GlobalLogic has achieved significant recognition under Mr. Piyush’s stellar stewardship— from being listed among the Great Place to Work Top 25 to winning multiple awards for sustainability, innovation, and workplace excellence. Personally, the dynamic leader has been honoured as Asia’s Emerging Leader by The Economic Times for his commitment to positioning India on the global technology map.


India’s 100th year of independence in 2047 represents a national aspiration to stand among the developed nations of the world — an aspiration embodied in the Government of India’s vision of Viksit Bharat 2047. The phrase Viksit Bharat means “Developed India” and the initiative seeks to transform India into a nation defined by prosperity, inclusivity, sustainability, and good governance.
Economically, the goal is to transform India into a USD 30–40 trillion economy by 2047, with a per capita income between USD 15,000 and USD 18,000. This transformation will require sustained growth in manufacturing, services, exports, and digital innovation. Socially, it envisions a country with zero poverty, universal education, accessible healthcare, and equal opportunities for all sections of society. Environmentally, the target is to achieve net-zero carbon emissions and promote sustainable growth. Governance reforms form another critical dimension, ensuring transparency, accountability, and citizen-centric administration. This grand vision is not a distant dream but a collective mission being driven sector by sector, ministry by ministry, under the decisive leadership of Prime Minister Shri Narendra Modi. From steel plants glowing green to ports handling record cargo, from electric buses rolling silently on city streets to Anganwadi children learning through play-based pedagogy, every cog in the national machinery is turning towards 2047.
Let’s see how key industries and their visionary ministers are leading India towards Viksit Bharat Vision @2047
BY RICHA SANG & MONALISA CHOUDHURY






















ransport infrastructure forms the veins through which a country’s growth and opportunity flow. Under the stewardship of Union Minister Shri Nitin Gadkari, the Ministry of Road Transport and Highways is transforming India’s roads, highways, and logistics systems to meet the ambitious goals of Viksit Bharat 2047.
TA key focus for Shri Gadkari is to reduce India’s logistics costs, which have historically hindered economic efficiency. Because of rigorous infrastructure investments, costs have already dropped from 16% to 10%. This reduction is expected to significantly boost exports and employment. According to Shri Gadkari, “Improved road infrastructure represents faster, cheaper, and more reliable movement of goods and people across the country, helping domestic industry compete globally.”
“As world’s 3rd largest automobile industry, India needs to focus on providing comfortable public transportation. We will maintain global alignment on BS7 and CAFE norms to address air pollution issues. In addition, moving to bio fuels helps in reducing India’s crude imports and enhances farmer incomes. More than 3 lakh vehicles have been scrapped following the implementation of the scrappage policy, benefiting industry, government,
and environment,” Shri Gadkari says.
Safe, Sustainable, and Inclusive Mobility
Safety and sustainability are pillars of Shri Gadkari’s agenda. He consistently emphasises the role of the construction equipment (CE) industry in building a Viksit Bharat. Simultaneously, he urges manufacturers to adopt green fuels, advanced machinery, and digital technologies to strengthen India’s position in sustainable infrastructure.
With CE sales growing 3 % year-on-year in FY25 to 1, 40,191 units and exports rising 10 %, the industry is poised for global demand. Shri Gadkari also stresses accountability by making it clear that lapses in road construction or machinery standards will invite strict enforcement, while investments in high-capacity tunnelling and pre-cast technology are encouraged to enhance efficiency, quality, and long-term infrastructure sustainability.
Transforming Road Infrastructure
Infrastructure development drives Shri Gadkari’s vision of a developed India. Projects like the Sonamarg tunnel and Zojila tunnel in Jammu & Kashmir are more than engineering achievements; they are enablers of regional growth. Across the country, the length of National Highways under NHAI, under his direction, has surged from 4,000 km in 2014 to 8,700
km in 2025. Shri Gadkari’s ministry has set an ambitious target of 100 km of road construction per day, reflecting a broader strategy to transform mobility infrastructure while enabling economic growth and employment generation.
Shri Gadkari’s vision extends beyond concrete and asphalt to green mobility technologies. His ministry also supports indigenous semiconductor manufacturing under the PLI scheme, linking transport development with domestic technology and manufacturing capacity. Urban transport is another focus. Decongestion initiatives in Delhi, worth ₹1, 00,000 crore, and additional ₹30,000 crore investments aim to improve traffic flow and reduce pollution. Compensatory reforestation and tree banks are being implemented alongside these projects to mitigate environmental impact and move India closer to its netzero emissions goal by 2070.
Shri Gadkari is also leading efforts to integrate infrastructure under the Bharatmala scheme and Gati Shakti master plan, to ensure the seamless connection of ports, industrial clusters, religious sites, and mining regions. This interconnected development reduces redundancy, lowers costs, and enhances the efficiency of both goods and commuter transport.
The Ministry of Road Transport and Highways under Shri Gadkari’s leadership demonstrates how infrastructure, technology, and sustainability can converge to power national development. With record investments, accelerated road construction, green mobility trials, and integrated logistics, India is building the backbone for a developed, self-reliant, and sustainable future.
“If the CE sector embraces sustainability, quality, and innovation, global demand will rise sharply,” Shri Gadkari noted, highlighting the economic and environmental potential of India’s infrastructure growth. By promoting safer roads, advanced construction practices, green fuels, and strategic connectivity, Shri Gadkari’s ministry is ensuring that India’s transport sector supports the broader vision of Viksit Bharat 2047, a nation where economic growth, technological adoption, and environmental stewardship move forward together.


The Ministry of Commerce and Industry, under the guidance of Union Minister of Commerce and Industry
Shri Piyush Goyal, is shaping the economic core of Viksit Bharat. Under his stewardship, the ministry has become a key driver of India’s rise as a global economic force. Once a $300 billion economy three decades ago, India today stands as a $4 trillion powerhouse, the world’s fourth-largest, and soon to be the third. Shri Goyal highlights this transformation with both optimism and confidence.
Digital India and Global Partnerships
“Viksit Bharat cannot happen without the adoption of technology,” Shri Goyal says. He adds, “We aspire to be a 32 trillion dollar economy by 2047. This vision is driven by policy reforms, digital innovation, and global partnerships that are transforming India’s role in global trade and manufacturing.
Shri Goyal attributes this progress to PM Shri Narendra Modi’s leadership, which has enabled widespread access to affordable data, clean energy, and AI-powered opportunities for 1.4 billion people.
“India today stands at an inflection point, a trusted global partner with low taxes, strong institutions and a focus on empowering consumers,” Shri Goyal says, adding that the country’s digital transformation will be crucial for sustaining momentum.
Even amid global uncertainty, India’s exports of goods and services have continued to grow steadily (estimated at 4–5% in recent years). Additionally, under Shri Goyal’s leadership, Digital India has evolved from a domestic mission to a global model for innovation. The launch of UPI abroad is an apt example of how India’s technological advancements are now creating real-world benefits for citizens and businesses worldwide. UPI has expanded to nine countries, further cementing India’s reputation as a reliable and technologically advanced trade partner.
When India’s UPI became operational in Qatar, Shri Goyal called it a “game-changer” for digital connectivity and seamless payments. With UPI now functional on Qatar National Bank’s point-of-sale terminals at major retail locations, Indian travellers and residents benefit from instant, secure transactions — a step that also strengthens trade, tourism, and financial inclusion. This move reflects India’s growing role as a digital leader that can export innovation as effectively as it exports goods and services.
Empowering Innovation and Enterprise
Shri Goyal’s push for programmes such as Make in India and Startup India has been energising entrepreneurs and manufacturers alike. He sees these initiatives as not just economic strategies but movements for empowering ordinary citizens to participate in nation-building. During his interactions
with Indian enterprises abroad, he urges them to fully harness the opportunities offered by these flagship programmes to strengthen India’s global economic linkages. By focusing on manufacturing, innovation, and entrepreneurship, he believes Indian businesses can expand their footprint while contributing directly to national growth.
Through the Make in India campaign, the Ministry encourages domestic production, reduces import dependence, and promotes India as a global manufacturing hub. The Startup India campaign, meanwhile, has nurtured one of the world’s largest and most vibrant startup ecosystems that thrives on technology, creativity, and social impact. Together, they are creating jobs, boosting exports, and shaping India’s future industries.
Shri Goyal emphasises that achieving Viksit Bharat requires collaboration across business, government, and citizens. His focus on collective growth highlights that the nation’s progress depends on trust, innovation, and shared responsibility across all sectors.
For Shri Goyal, Viksit Bharat 2047 is not a distant dream but a living mission already unfolding through every innovation, trade agreement, and entrepreneurial success story. Through his words and actions, he reminds the nation that development is not just about GDP growth or trade figures, but about people, their aspirations and commitment to building a better India. As he rightly put it, the journey to a developed India demands “capable and committed individuals who contribute to policymaking with compassion, dedication, and a spirit of service.” That spirit of innovation, integrity, and inclusion is what will define India’s rise as a truly Viksit Bharat by 2047. He also acknowledges the role of mentors and teachers in driving this transformation.
According to Shri Goyal, growth must be inclusive, sustainable, and people-driven. He often reminds India’s youth that building a developed nation is not just a responsibility but also a privilege. He also encourages them to consider roles in public service and politics, echoing the Prime Minister’s appeal for one lakh youth to join public life and become agents of change. As India marches toward 2047, leaders like Shri Goyal demonstrate the power of conviction, collaboration, and vision through their efforts. With each initiative, from expanding exports and promoting innovation to empowering the youth and strengthening global partnerships, he brings India one step closer to realising the promise of a Viksit Bharat, built by its people and powered by its purpose.

Shri Piyush Goyal, Union Minister of Commerce and Industry

s India moves towards its vision of Viksit Bharat 2047, Shri Ashwini Vaishnaw, Union Minister for Railways, Information & Broadcasting, and Electronics & Information Technology (IT) is strengthening technology, infrastructure, and communication by shaping the country’s digital foundation and modernising its transport systems.
AShri Vaishnaw emphasises that India’s progress depends on the strength of its technological and industrial base. “The technological base is rapidly being prepared for achieving Viksit Bharat,” he says, urging young innovators to build world-class technologies and products.
Laying the Digital Foundation
In the field of electronics and IT, India is entering a new phase of self-reliance and global competitiveness. Shri Vaishnaw announced that India’s first indigenous semiconductor chip will roll out soon, marking a defining moment in the country’s journey toward technological sovereignty. Additionally, six semiconductor fabrication plants are currently under construction, which indicates a strong policy push to position India as a hub for high-value manufacturing and advanced electronics. These developments align with the government’s broader goal to create a resilient semiconductor ecosystem, besides reducing dependence on imports.
The India AI Mission, also under his ministry, is designed to democratise artificial intelligence access. It offers free datasets and AI training programmes to equip students and startups with tools for innovation. Shri Vaishnaw is confident that this momentum will carry India to the forefront of the global economy. “India will secure its position as one of the top two economies by 2047,” he said, highlighting the role of technology in achieving sustainable and inclusive growth.
Alongside digital transformation, India’s transport infrastructure is undergoing a historic overhaul. As Minister for Railways, Shri Vaishnaw has outlined an ambitious plan to construct 7,000 kms of dedicated passenger corridors by 2047, in alignment with the Viksit Bharat vision. These new corridors, designed for speeds of up to 350 kmph, will revolutionise passenger travel through faster, safer, and more efficient rail services.
Speaking at the International Railway Equipment Exhibition, he explained that high-speed routes will use homegrown signalling systems and advanced operations control centres. “Vande Bharat 4.0 will be a new benchmark in performance and passenger experience,” he said, describing upcoming models that will feature improved seating, enhanced toilets, and superior design standards.
The Indian Railways’ transformation
also includes over 156 Vande Bharat, 30 Amrit Bharat, and four Namo Bharat trains that are already operational across the network. The Vande Bharat version three, being manufactured in Chennai, represents another leap forward in domestic engineering capability.
Under Shri Vaishnaw’s leadership, the Indian Railways has added 35,000 km of new lines and achieved 46,000 km of electrification in the past 11 years—making it one of the largest and fastest electrification drives in the world. The effort not only improves energy efficiency but also reduces operational costs and emissions, aligning with India’s commitment to environmental sustainability. “Prime Minister Narendra Modi’s leadership has ushered in a decade of modernisation,” Shri Vaishnaw said, crediting the government’s policy direction for these achievements.
India’s engineering capability is also gaining international recognition, with locomotives built domestically now being exported to Africa and Australia. This export expansion demonstrates the country’s growing reputation as a dependable global supplier of advanced rail technologies. Iconic projects such as the Chenab Bridge, Pamban vertical-lift sea bridge, and Bairabi-Sairang bridge demonstrate India’s technical expertise and execution strength. These engineering achievements enhance connectivity while symbolising the country’s ability to undertake complex infrastructure challenges at scale.
He also announced that India’s first bullet train is expected to become operational by August 2027, a milestone that will mark the country’s entry into the era of high-speed rail travel. This initiative, closely coordinated with the Gujarat administration, is part of a wider effort to boost industrial and infrastructure capacity. The state is also seeing rapid growth in the semiconductor and electronics sectors, with 30 Japanese companies set to establish units there to strengthen India’s semiconductor ecosystem.
Across his three portfolios—Railways, Electronics & IT, and Information & Broadcasting—. Shri Vaishnaw’s focus remains on connecting innovation with national development. His ministries collectively reflect that technology and infrastructure must work hand in hand to achieve the vision of Viksit Bharat 2047. Whether it is through the rollout of indigenous chips, the adoption of AI in public systems, or the modernisation of railways, each initiative highlights the goal of making India more selfreliant, interconnected, and future-ready.


riving the nation’s industrial and green agenda, Shri H. D. Kumaraswamy is playing a crucial role in realising the vision of Viksit Bharat 2047. As the Union Minister of Steel & Heavy Industries, he is steering some of the most important sectors for driving India’s industrial and green future. His ministry’s work in electric mobility, green steel, and advanced manufacturing reflects the country’s determination to lead the world toward a more sustainable tomorrow.
DDriving India’s Electric Mobility Revolution
For a country aiming for net-zero emissions by 2070, EVs are essential for both economic growth and environmental health. As Shri Kumaraswamy explains, “Under the leadership of Hon’ble PM Shri Narendra Modi, India is steadily becoming self-reliant and achieving Net Zero emissions. The EV sector plays a crucial role in this journey.”
To make this happen, the Ministry of Heavy Industries (MHI) is driving a series of powerful initiatives. The Production Linked Incentive (PLI) Scheme for Advanced Chemistry Cells (ACC) encourages domestic battery manufacturing; this is an essential step to cut imports and strengthen India’s energy independence. Out of a targeted 40 GWh, 30 GWh of capacity has already been awarded in two tranches, backed by ₹18,000 crore in incentives. Once production begins,
the scheme is expected to save up to ₹2.5 lakh crore in oil imports and significantly boost renewable energy integration.
Additionally, the PLI Scheme for Automobiles and Auto Components, with an outlay of ₹25,938 crore, is spurring investments and creating thousands of jobs. Within just a few years, this initiative has attracted ₹25,219 crore in reported investments, generated nearly 40,000 jobs, and enabled domestic manufacturers to compete globally in EV and component production.
The recently launched PM-eDRIVE Scheme adds another layer of momentum. With a ₹10,900 crore allocation, it aims to support 24.79 lakh electric two-wheelers, 3.16 lakh three-wheelers, and over 14,000 electric buses. India is investing ₹2,000 crore in EV charging infrastructure with 70,000+ fast chargers. The country is also deploying 38,000 e-buses via the PM-eBus Sewa mechanism.
If electric mobility represents India’s future, steel is its backbone. The steel sector under the Ministry of Steel & Heavy Industries is being revitalised to meet both domestic and global needs. Shri Kumaraswamy shares that the PLI Scheme for Specialty Steel, worth ₹44,000 crore, has already attracted strong investments and created 80,000 jobs. This has reduced India’s import dependency in
areas like defence, energy, and automotive manufacturing. The enhanced PLI 1.1 Scheme, launched in early 2025, brought in another ₹17,000 crore from 25 companies, focusing on high-grade CRGO steel essential for power infrastructure.
India is now firmly on track to reach its target of 300 million tonnes of steel production by 2030. To get there, the Ministry is working closely with the Ministry of Mines and state governments to secure raw materials, develop integrated steel hubs in Kalinganagar and Angul, and improve logistics under the PM GatiShakti initiative. The ₹11.21 lakh crore infrastructure investment announced in the 2025–26 Budget is further boosting demand. From metro rails to expressways and highspeed corridors, Indian steel now forms the core of the country’s infrastructure growth. Projects like Bharatmala, Sagarmala, and INS Vikrant (India’s indigenous aircraft carrier) show how home-grown steel is strengthening both the economy and national security.
The government’s green steel initiative links industrial growth with environmental care. India’s Green Steel Taxonomy, the world’s first, sets science-based lowcarbon standards, helping industries reduce emissions and invest in clean technologies, thus facilitating a gradual transition toward sustainable steel production. The Ministry is also leading pilot projects in hydrogenbased steelmaking under the National Green Hydrogen Mission, while promoting innovation through the Steel Research and Technology Mission of India.
The MHI is developing a skilled workforce for the green economy by partnering with NSDC, IITs, IISc, and industries to offer specialised training in hydrogen steelmaking, recycling, carbon capture, and other emerging sustainable technologies. Through initiatives under the Skill India Mission, thousands of young Indians are being equipped for new roles in clean mobility and sustainable manufacturing.
Every new plant, electric bus, or green steel project brings India closer to the dream of Viksit Bharat. The Ministry of Steel & Heavy Industries is showing how progress and sustainability can go hand in hand. By promoting electric mobility, clean energy, sustainable steel, and skill development, it is enabling industrial growth while driving selfreliance, and environmental stewardship to build a sustainable Bharat.
Shri H. D. Kumaraswamy, Union Minister of Steel & Heavy Industries


s India charts its course toward Viksit Bharat 2047, the country’s maritime and inland waterways sectors are emerging as anchors of growth, sustainability, and global integration. Leading this expansive transformation is Hon’ble Minister Shri Sarbananda Sonowal, Minister for Ports, Shipping & Waterways, whose vision combines infrastructure, innovation, and environmental stewardship to position India as a global maritime power.
A“India’s maritime sector is playing a pivotal role in realising the vision of Viksit Bharat by 2047,” says Shri Sonowal. Under his leadership, the Ministry has delivered a remarkable turnaround across ports and waterways. Major port cargo handling capacity has nearly doubled, while overall cargo traffic has risen by 47%. Turnaround times have also been cut almost in half, and Output Ship Berth-Day performance has improved by 47%, making India’s ports more efficient and globally competitive.
Shri Sonowal’s focus on inland waterways deserves a special mention. Cargo movement through these channels has surged from 18 million metric tonnes in 2013–14 to 146 million metric tonnes in 2024–25 — a phenomenal 700% increase. Coastal shipping, too, has grown more than two-anda-half times in a decade. The Ministry has set clear goals: 200 million MT by 2030 and 500 million MT by 2047. “These milestones
reflect our vision to make waterways a vital component of India’s multimodal logistics ecosystem,” Shri Sonowal affirms.
A key initiative in this effort is the Jalvahak Scheme, launched in 2024, which incentivises cargo transport on National Waterways by offering up to 35% reimbursement of operating costs for journeys exceeding 300 kilometres. Covering key rivers such as the Ganga (NW-1), Brahmaputra (NW2) and Barak (NW-16), it is designed to make inland water transport commercially attractive and environmentally sustainable. Additionally, through the Maritime Amrit Kaal Vision 2047, the Ministry has charted an ambitious roadmap to place India among the world’s top 10 ship-owning and shipbuilding nations by 2030 and among the top five by 2047. To power this, a ₹25,000 crore Maritime Development Fund will provide long-term financing for ports, shipyards, and green shipping. Complementing it is the Shipbuilding Financial Assistance Policy 2.0, which extends direct financial support to Indian shipyards to help them compete with heavily subsidised foreign counterparts and fully utilise the country’s existing 400,000 –500,000 GT capacity.
Sustainability forms the backbone of this transformation. Programmes like the Harit Sagar Guidelines, Green Hydrogen Hubs, Green Tug Transition Programme, and Harit Nauka are accelerating the shift toward cleaner, renewable energy sources across
ports and waterways. “Our goal is not just growth, but responsible growth — one that strengthens our economy while safeguarding our environment,” Shri Sonowal emphasises. Apart from domestic reforms, India’s maritime diplomacy is expanding rapidly. The India–Middle East–Europe Economic Corridor (IMEC) connects Indian ports to the UAE, Saudi Arabia, Israel and onward to Europe, promising up to 40% faster cargo movement than the traditional Suez route. Parallelly, the International North–South Transport Corridor (INSTC) links India with Central Asia, Russia and Europe via Iran, cutting transit times by half and logistics costs by 30%. The Chabahar Port, operated by India, stands at the centre of this strategic network. Together, these corridors enhance India’s global connectivity and resilience in the face of shifting trade dynamics.
International collaboration is another hallmark of Shri Sonowal’s tenure. In July 2025, Cochin Shipyard Limited signed a comprehensive MoU with HD Korea Shipbuilding & Offshore Engineering Co. Ltd. of South Korea, paving the way for longterm cooperation in ship design, productivity enhancement, workforce training, and global project exploration. Such partnerships are helping Indian shipyards adopt cutting-edge technology and elevate production standards to international levels.
Meanwhile, reforms under the Sagarmala umbrella continue to push digital transformation across India’s ports. Platforms such as the Maritime Single Window, SAGAR SETU, and the National Logistics Portal (Marine) are enabling paperless clearances and real-time tracking. The One Nation, One Port Process is standardising procedures nationwide, while smart port development ensures automation and data analytics become integral to daily operations. These efforts have delivered measurable results. India’s overall port turnaround time has improved by nearly 50%, with ports like JNPA now outperforming several global peers. Cargo-handling capacity at major ports has nearly doubled in a decade, from 873 MTPA to 1,681 MTPA; this reflects India’s progress as a logistics powerhouse. Through these initiatives, Shri Sarbananda Sonowal is steering India toward a resilient, technology-driven, and environmentally responsible maritime ecosystem. His vision merges infrastructure with innovation and economic ambition with ecological balance. As he aptly concludes, “These efforts reflect a unified commitment to build a future-ready, globally competitive and environmentally responsible maritime sector, fully aligned with the vision of a developed India by 2047.”

Sarbananda Sonowal, Union Minister for Ports, Shipping & Waterways

rof. S.P. Singh Baghel, Union Minister of State, Ministry of Panchayati Raj, and the Ministry of Fisheries, Animal Husbandry & Dairying, emphasises that India’s development cannot be complete without strengthening grassroots governance and empowering its rural citizens. For him, the vision of Viksit Bharat 2047 is inseparable from active participation at every level of society, particularly among youth, community leaders, and local governance institutions. He believes true progress occurs when rural communities shift from being passive recipients to becoming active participants in their own growth and national development.
PUnder his leadership, the Ministry of Panchayati Raj (MoPR) has taken concrete steps to equip Panchayati Raj Institutions with the knowledge, tools, and leadership capabilities necessary to implement development programs effectively.
Prof. Baghel highlights that healthcare is key to inclusive development. While India has made strides in digital healthcare, the focus remains on providing quality medical services to over 80 crore underprivileged rural citizens, ensuring equitable access and improving health outcomes across all communities. He emphasises the importance of maintaining uniform healthcare standards across all socio-economic groups, highlighting initiatives like Ayushman Bharat to cover the
most vulnerable. For him, healthcare reflects a society’s responsibility and commitment to the well-being of its citizens.
Prof. Baghel equally emphasises education and youth empowerment. He believes that leadership development must extend beyond governance to sectors such as healthcare, education, and social entrepreneurship. By providing knowledge, skills, and decisionmaking exposure, his Ministry aims to cultivate a generation equipped to tackle local challenges and contribute meaningfully to national development.
One of his Ministry’s landmark programs is the Model Youth Gram Sabha (MYGS), launched in October 2025 in collaboration with the Department of School Education & Literacy (DoSE&L) under the Ministry of Education, and the Ministry of Tribal Affairs (MoTA). The initiative seeks to educate students about the Panchayati Raj system, encourage participation, develop leadership skills, and promote awareness of local governance issues. By integrating experiential learning into schools, including Jawahar Navodaya Vidyalayas (JNVs), Eklavya Model Residential Schools (EMRSs), and state government schools, the MYGS provides students with first-hand exposure to the functioning of PRIs, participatory decisionmaking, and budget management. The MYGS uses digital tools like the MYGS Portal and a Teacher Training Module for nationwide implementation. It comprises three key
components: the National Level Master Trainer (NLMT) guide for understanding Gram Sabha processes, an engaging facilitation module for teachers, and a comprehensive evaluation framework to measure and enhance program effectiveness. Also, participating schools receive a one-time Rs. 20,000 to support logistics and arrangements. These measures help the Ministry of Panchayat Raj foster informed, engaged citizens prepared to contribute effectively to their communities and the nation.
The Ministry of Panchayat aligns with national programs like Digital India, Skill India, and Aatmanirbhar Bharat. By integrating digital solutions, vocational training, and participatory governance, Prof. Baghel ensures even remote communities gain access to opportunities for skill development, economic growth, and leadership.
Inclusivity and equality are also the key pillars of his approach. Special attention is given to marginalised, tribal, and economically weaker sections. The Ministry emphasises transparency, accountability, and community participation, thus enabling citizens to voice concerns and influence decisions that affect their lives. Such engagement builds a sense of ownership and responsibility.
Prof. Baghel also highlights the importance of healthcare and leadership in tandem. He advocates for accessible, high-quality healthcare services across all social segments, using digital health platforms and regulatory oversight to ensure reliability and equity. He stresses that young leaders, whether in governance, education, or healthcare, must be equipped to make decisions that balance efficiency with social welfare. By doing so, the Ministry is reinforcing the principle that development is meaningful only when it reaches every corner of society and every individual is empowered to participate.
Prof. Baghel also emphasises that achieving Viksit Bharat is not a responsibility that rests solely with governments, institutions, or businesses. He urges all Indians to take responsibility for the Viksit Bharat vision and emphasises that the nation’s progress is meaningful only when every citizen contributes to an equitable and empowered society.
He adds “AsiaOne Magazine is playing a unique role in highlighting inspirational stories and successful welfare initiatives. By doing so, the magazine is motivating citizens to actively participate in the Viksit Bharat mission and contribute to the nation’s progress. By sharing real-life examples of development, AsiaOne Magazine is inspiring engagement, shared responsibility, and national pride, thereby strengthening India’s journey toward a Viksit Bharat 2047.”

Prof. S.P. Singh Baghel, Union Minister of State, Ministry of Panchayati Raj, Fisheries, Animal Husbandry & Dairying

mt. Savitri Thakur, Union Minister of State for Women and Child Development, is driving initiatives that place children and women at the centre of India’s journey toward Viksit Bharat by 2047. Her Ministry is implementing comprehensive programmes to ensure nutrition, early learning, safety, and empowerment, setting a strong foundation for India’s future.
SThe MWCD is advancing child nutrition and early development through Mission Saksham Anganwadi and Poshan 2.0, integrating health, nutrition, and early education. These programs ensure children, pregnant and lactating women, and adolescent girls, including those in tribal and aspirational districts, receive essential services. By moving from calorie-focused guidelines to balanced diets, the Ministry emphasises quality proteins, healthy fats, and seven key micronutrients like iron, zinc, and folate. Alongside, modernised Anganwadi Centres are being reimagined as “vibrant earlychildhood development hubs,” equipped with improved infrastructure, digital monitoring, and trained Anganwadi workers.
To enhance early childhood care, initiatives like Navchetna (for children 0–3 years) and Aadharshila (for children 3–6 years) provide a structured curriculum, focusing on holistic development through love, play, and positive guidance. Anganwadi workers, trained
through a two-tier model at the Savitribai Phule National Institute of Women and Child Development, help ensure every child gets the care they need to grow and thrive.
Women-Led Development
Smt. Savitri Thakur emphasises that the journey toward Viksit Bharat relies on womenled development. Initiatives like “Mission Shakti”, with Sambal (safety) and Samarthya (empowerment), provide a comprehensive framework for women’s protection, justice, and opportunity. Collaborating with the Ministry of Rural Development, women are linked to Self-Help Groups (SHGs) under DAY-NRLM to boost entrepreneurship and financial inclusion, while coordination with the Ministry of Panchayati Raj strengthens their participation in local governance.
The MWCD’s pilot initiative NAVYA –Nurturing Aspirations through Vocational Training for Young Adolescent Girls, implemented across 27 districts, provides skill training for girls aged 16-18, and prepares them for non-traditional roles and economic independence. Through NAVYA, says Smt. Savitri Thakur, “the Government reaffirms its commitment to empowering girls with skills, confidence, and opportunity, thereby ensuring that every young woman contributes to India’s journey toward a selfreliant future.”
Smt. Savitri Thakur’s Ministry is also harnessing community power through
initiatives such as “Ab Koi Bahana Nahi” and “Nayi Chetna”, to mobilise Panchayati Raj Institutions and SHGs in a nationwide movement for gender equality. Nayi Chetna alone has seen more than nine lakh community-led activities. Likewise, Ab Koi Bahana Nahi, a partnership with the Ministry of Rural Development and UN Women— builds a culture of zero tolerance toward gender-based violence. To strengthen this convergence, 227 Gender Resource Centres have been launched across 13 States, serving as local hubs for awareness, counselling, and capacity building. “We are turning community participation into a collective movement for women’s safety and empowerment,” the Minister affirms.
Technology and Justice: The Backbone of
Digital governance has become the new foundation for social impact. The Poshan Tracker App, available in 24 languages, now covers over 14 lakh Anganwadi Centres and 10 crore beneficiaries, providing real-time data on service delivery and nutrition outcomes. By integrating with health platforms like RCH and UWIN, it allows officials to monitor stunting and wasting, track migration, and target high-burden districts with precision. In tribal areas, convergence with missions like PM JANMAN and DAJGUA ensures that development reaches the most remote communities.
On the justice front, the Government has reinforced protection frameworks with amendments to the POCSO Act and the establishment of Fast Track Special Courts for swift trials in sexual-offence cases. Similarly, the launch of Nari Adalats, Women Helplines (181), and One Stop Centres across all States provides immediate recourse and rehabilitation for women in distress.
Toward a Healthier, More Equal Bharat Campaigns like Poshan Pakhwada 2025 and Rashtriya Poshan Maah 2025, themed “Swasth Nari, Sashakt Parivaar,” have engaged over 14 crore activities nationwide, raising awareness on maternal and infant nutrition, local foods, and involving fathers in promoting family health.
Smt. Savitri Thakur says, “By 2047, children benefiting from Anganwadi services today will be the healthy, capable youth driving India’s growth story.” Through initiatives that unite technology, nutrition, empowerment, and justice, her Ministry is ensuring that India’s march toward Viksit Bharat is not just about economic advancement but about nurturing the human capital that defines a truly developed nation.

Smt. Savitri Thakur, Union Minister of State, The Ministry of Women and Child Development (MWCD)

n the journey of realising Viksit Bharat vision, the Ministry of Social Justice and Empowerment, led by Shri Ramdas Athawale, Union Minister of State, plays a crucial role in shaping an inclusive and equitable India. Shri Athawale, who has long championed the cause of the underprivileged, believes that true development can only be achieved when every section of society walks together. According to him, the dream of Viksit Bharat will be realised when the poor, marginalised, and backward communities are not just beneficiaries but active participants in India’s progress. His Ministry’s efforts are centred on building a just, inclusive society where social equity and opportunity are not limited by birth, caste, or background.
IThe Ministry of Social Justice and Empowerment, guided by Prime Minister Shri Narendra Modi, seeks to create an India where all individuals can contribute to growth, focusing on supporting and enabling self-reliance among society’s weaker sections as part of the broader development agenda. Among its many priorities, the Ministry is engaged in empowering Scheduled Castes (SC), Scheduled Tribes (ST), Other Backward Classes (OBC), and Economically Weaker Sections (EWS). Through schemes such as the Stand-Up India initiative, the National Scheduled Castes Finance and Development Corporation, and various
livelihood and credit programs, the Ministry has created pathways for entrepreneurship and economic self-sufficiency. By providing access to finance, training, and business support, these programs have enabled thousands of individuals to establish small enterprises and find meaningful employment. The underlying objective is to ensure that those who were once on the margins become active contributors to India’s development.
The Ministry prioritises education as a tool for empowerment by expanding scholarships, hostels, and residential schools for underprivileged students. Financial support is also provided for higher education in India and abroad. These measures aim to break the cycle of poverty and create new opportunities. By giving children from disadvantaged backgrounds access to quality education, they can uplift their families, strengthen communities, and contribute to national progress.
Promoting social harmony has also been a consistent objective of the Ministry. Efforts to encourage inter-caste marriages, awareness campaigns against discrimination, and targeted outreach programs are helping to create a society where equality and mutual respect form the foundation of coexistence. The guiding philosophy draws from the ideals of Dr. B. R. Ambedkar, whose vision of a society free from caste-based inequality continues to inspire the Ministry’s work. The emphasis is on equality not only in legal
frameworks but also in the attitudes and actions of everyday life.
The Ministry of Social Justice and Empowerment has also made major strides in advancing the rights and inclusion of persons with disabilities. Under the Sugamya Bharat Abhiyan, the focus has been on making public infrastructure, transportation systems, and digital platforms accessible to all. This initiative has led to the modification of over 1,500 government buildings and 700 railway stations across the country, allowing greater mobility for differently-abled citizens. The objective is to build an India where everyone can participate fully in social and economic life without barriers.
Women’s empowerment is another pillar of the Ministry’s vision for a just society. Through dedicated programs, women from disadvantaged communities are being encouraged to pursue education, entrepreneurship, and leadership roles. Increased representation through reservations and initiatives for skill development are enabling women to achieve financial independence and social confidence.
The Ministry’s initiatives also align closely with larger national programs such as Aatmanirbhar Bharat, Digital India, and Skill India that aim to equip India’s youth with the skills, resources, and opportunities needed to participate in the economy of the future. The focus is on digital inclusion, vocational training, and job creation so that young people can access new growth avenues even in remote areas.
In addition to economic empowerment, Shri Athawale’s Ministry of Social Justice and Empowerment has taken a strong stance on addressing social challenges. The Nasha Mukt Bharat Abhiyaan (Drug-Free India Campaign) has reached schools, colleges, and communities across the country, creating awareness and providing rehabilitation support
As India approaches its centenary of independence, the Ministry is serving as a bridge between growth and equality by promoting education, entrepreneurship, accessibility, and social harmony. Shri Athawale emphasises that every individual and organisation has a responsibility to contribute to India’s journey toward Viksit Bharat. Extending his warm wishes to AsiaOne Magazine, he said, “I extend my heartiest congratulations to AsiaOne Magazine, and Mr. Rajat Raj Shukal, and his entire team. Your team presents many subjects to the people. The way your team is presenting various aspects of a developed India and making India famous in the whole world, my best wishes are with you.”

Shri Ramdas Athawale, Union Minister of State, Social Justice and Empowerment

s India progresses toward the dream of Viksit Bharat 2047, technology acts as a powerful catalyst for inclusive and sustainable growth. Leading this charge in the corporate world is Mr. Piyush Jha, GVP & Head – APAC at GlobalLogic, whose work bridges the gap between innovation and real-world impact. Under his leadership, GlobalLogic isn’t just building software but building solutions that touch lives, transform industries, and contribute to India’s broader aspirations.
ALike a true leader, Mr. Jha is actively contributing to India’s development story through GlobalLogic. One of the company’s standout initiatives is Velocity. ai, GlobalLogic’s flagship GenAI platform. By helping businesses adopt artificial intelligence faster and more efficiently, it allows companies to innovate without being held back by complexity. For Mr. Jha, AI is not just a tool for automation but a way to empower people, create smarter systems, and open up opportunities for growth across sectors.
“Healthcare is another arena where GlobalLogic’s impact is visible,” Mr. Jha says. The company is working on MedTech innovations for improving patient outcomes and making quality care more accessible across the country. For many Indians, access to healthcare remains a challenge, and through technology-driven solutions,
Mr. Jha is helping to bring essential services closer to those who need them most. It’s an approach that integrates business goals with a tangible social purpose.
Apart from healthcare, GlobalLogic, under Mr. Jha’s direction, is making bold moves in semiconductors through its Silicon IP investments. These efforts are helping strengthen India’s role in the global technology supply chain, besides positioning the country as a credible and competitive contributor to advanced tech markets. For Mr. Jha, the focus goes beyond expanding the company’s portfolio—it’s about building long-term national capability. By nurturing talent, developing cutting-edge solutions, and fostering innovation, he aims to ensure India is ready to meet future technological needs and play a meaningful role in shaping global innovation.
Equally important is the company’s focus on people, another pillar of Viksit Bharat. GlobalLogic’s engineering hubs, guided by Mr. Jha, are more than workplaces as they serve as spaces where young professionals can learn, experiment, create, and grow personally as well as professionally. By offering opportunities to work on cuttingedge projects, these centres are helping prepare the next generation of technology leaders so as to make India’s workforce ready to meet the demands of tomorrow.
Mr. Jha’s leadership stand out for his
ability to align business with broader societal goals. Whether it’s advancing AI, healthcare, semiconductors, or talent development, each initiative reflects his commitment to driving sustainable growth, strengthening digital infrastructure, and empowering India’s youth. In this way, GlobalLogic’s role has become part of a larger national mission, thereby helping shape an India that is innovative, inclusive, and forward-looking.
Looking ahead, the company intends to continue investing in technology and talent that support both business objectives and India’s development agenda. From platforms that accelerate enterprise innovation to healthcare solutions that improve lives, Mr. Jha’s approach demonstrates how corporate initiatives can also contribute to social progress.
The story of Mr. Piyush Jha and GlobalLogic is about leveraging innovation to meet national ambitions. By translating technology into tangible outcomes, they are helping India move steadily toward its vision of a developed nation.
The journey toward Viksit Bharat 2047 is a shared endeavour, built on the strength of good governance and the energy of entrepreneurial ambition. On one side, government ministries are laying deep and long-term foundations through policies that improve education, healthcare, connectivity, and social welfare. Leaders such as Shri H.D. Kumaraswamy, Shri Piyush Goyal, Shri Ashwini Vaishnaw, Shri Sarbananda Sonowal, Smt. Savitri Thakur, Shri Ramdas Athawale, and Prof. S.P. Singh Baghel are shaping reforms that focus on inclusivity, opportunity, and longterm national growth.
At the same time, India’s entrepreneurial sector is translating these policies into real-world impact. Business leaders and innovators are creating jobs, building advanced technologies, and driving digital and industrial transformation. Entrepreneurs like Mr. Jha show how technology-led businesses can support national priorities.
Together, policy and enterprise form a powerful partnership. Besides expanding industries, their combined efforts empower citizens by enabling skill development and creating lucrative pathways for millions of individuals to participate in India’s growth story. This collaboration is steadily transforming the vision of a developed, inclusive, and resilient India into a tangible and achievable future.
Mr. Piyush Jha, GVP & Head –APAC at GlobalLogic




Fortune favours the fearless and women leaders, as fearless entrepreneurs and innovators are redefining industries, uplifting communities, and driving sustainable and inclusive growth. Every record they shatter, every market they conquer, every fortune they amass demonstrates their sovereign brilliance. AsiaOne Magazine celebrates these indomitable goddesses of enterprise who are setting new performance benchmarks. Their enterprises are not just successful but are setting new standards for sustainable and inclusive growth in the economy. Black Swan Women Entrepreneurs are those rare and indomitable forces who turn crises and opportunity, silence into influence, and exclusion into empire. With fierce intelligence, courage, and unshakeable purpose, they transform obstacles into gateways to opportunity. So, here’s to women who don’t follow paths, they blaze them!


The Chairperson Emeritus, OP Jindal Group, Smt. Savitri Jindal is not only renowned in Haryana and India but in the whole world as a popular leader. She has lead with grace the life of a successful wife, a successful mother, a successful politician as well as a successful entrepreneur
Avisionary leader, Smt. Savitri Jindal stepped into a leadership role after the sudden passing of her husband, industrialist O.P. Jindal, in 2005. She took charge of the diverse Jindal Group at a critical time and led it through an important phase of growth and consolidation. Over the years, she helped strengthen the group’s presence across key sectors such as steel, power, cement, and infrastructure, while
also supporting its expansion into international markets across Asia, Europe, Africa, and the Middle East.
Smt. Savitri Jindal has played an important role in taking Jindal Group to great heights and swiftly evolved from being a successful housewife to a successful entrepreneur, after the demise of her husband Shri OP Jindal ji in a plane crash. She says, “Jindal Saheb had an amazing ability to take everyone along, so taking inspiration from him, I played my part as a link – both with the kids and also with the Hisar-Haryana family. I am very proud of my children, who have not only successfully handled the business following the path shown by Jindal Saheb but are also living together lovingly and operating their business and family together. In today’s environment it is difficult for two brothers to live together but it is a big thing for us that all my children are living together with love.”
In addition to her business pursuits, Smt. Savitri Jindal has also made significant contributions to public service as a Member of the Haryana Legislative Assembly, representing the Hisar constituency. She has also successfully handled the responsibility of Ministry of Revenue and Urban Local Bodies in Haryana, in the past. Her work in politics reflected her interest in grassroots development, especially in education, healthcare, and rural infrastructure. Across both business and governance, her focus has remained on building strong institutions and creating real impact at the community level.
Her approach to philanthropy is practical and people-focused. As a child, she has seen her grandfather, parents, uncles and aunts and both brothers and sisters extending a helping hand to the needy. Her husband was also a great philanthropist. He laid great emphasis on education because he believed that education is the right way to attain prosperity. Education and health and wellness are subjects that are very close to her heart.
Under her guidance, the Jindal Foundation works across education, healthcare, women’s empowerment, environment, and rural development. From scholarships and schools to hospitals and community programmes, her initiatives reflect her belief that business success should contribute directly to social progress.
“DONNING MANY HATS WITH ÉLAN, SHE IS A LIVING LEGEND, WHOSE LIFE IS AN INSPIRATION FOR ONE & ALL”
Vidyadevi Jindal Residential School, OP Jindal School, OP Jindal Global University, OP Jindal University-Raigarh, OP Jindal Community College are some of the initiatives through which she promotes the talents of the country. Similarly, Acharya Shri Mahashraman ji has entrusted her with the responsibility of the Chancellor of Jain Vishwabharati, which she has been trying to fulfil sincerely. As far as health is concerned, right now her focus is on the development of Maharaja Agrasen Medical College, Agroha. Under her leadership, the team did a commendable job during the COVID-19 pandemic.
W“TRUE
ith over three decades of crosscontinental experience, Ms. Alka excels at guiding as well as transforming leaders. From law to global mobility and applied neuroscience, her journey reflects a relentless pursuit of human potential. As a Lead Facilitator and Mentor with the NeuroLeadership Institute, she empowers Fortune 100 companies to leverage brain science for smarter strategies and inclusive leadership.
STARTS IN THE MIND AND TRANSFORMS THE WORLD THROUGH ACTION AND PURPOSEFUL VISION”
Ms. Alka’s story began in the structured world of law, but her curiosity about people and cultures soon pulled her toward global mobility. While working with Northern Telecom in Hong Kong and consulting across EMEA and Asia, she became skilled at helping professionals adapt to and succeed in new environments. Her fascination wasn’t just with logistics but with the human mind. She wondered why some leaders perform well under pressure while others struggle. This curiosity sparked her interest in Applied Neuroscience, where she discovered tools to better understand decision-making, emotional triggers, and thought patterns.
For the past 20 years in Singapore, Ms. Alka has helped leaders and teams grow. She has created programs for women returning to work, coached executives, and developed leadership models focused on agility and self-awareness. Her involvement with organisations such as NetExpat, Arcadia Consulting, and Mums@ Work Singapore demonstrates her commitment to building inclusive and flexible teams. She believes leadership is not about giving orders, but about listening, learning, and growing alongside your team.
Ms. Alka’s edge lies in her ability to merge neuroscience with practical leadership. Through the NeuroLeadership Institute, she trains executives to understand how their brains work, how biases affect decisions, how stress lowers performance, and how cultural awareness improves teamwork.
Her sessions are not just theoretical; they give leaders real tools to succeed in high-pressure, global roles. She also stresses the importance of cognitive flexibility, i.e., the ability to adapt your
Ms. Alka Chandiramani, the CEO and Founder of Alvo Connexions Pte. Ltd., is an accomplished leader with a legacy of driving purposeful transformation. A passionate advocate for women’s empowerment, Ms. Alka has consistently broken barriers and set new benchmarks in empowering leaders worldwide
thinking under pressure, as a key leadership skill. She believes the brain is our greatest asset, and managing it leads to resilience and clarity.
Ms. Alka’s creative mission is driven by empathy and purposeful giving. One of her heartfelt aspirations is to host an art exhibition, where proceeds will benefit various organisations dedicated to children’s health and mental well-being. She also proudly supports ‘Mama on Palette’, a Singapore-based community that empowers art-loving mothers to embrace craetivity as a pathway to mental wellness.
Ms. Alka’s efforts have been honoured with several prestigious awards, including The Power Feminine Award (2025), Asia’s Most Influential Coaching Leaders Award (2023), and Singapore 40-over-40 Inspiring Women (2023). As an author and mentor, she shares her insights on leadership through contributions to publications like Living in Singapore.

Ms. Aparna Kaushik, the Founding Principal Architect of Aparna Kaushik Design Group, is a thoughtful designer whose work weaves together beauty, function, and meaning to create spectacular spaces that resonate deeply with those who inhabit them. Her designs reflect a rare ability to balance timeless elegance with the demands of contemporary living. From ultra-luxury residences to immersive lifestyle environments, her portfolio showcases a commitment to crafting spaces that are as emotionally impactful as they are visually stunning
Driven by a deep commitment to client relationships and site-specific design, Ms. Aparna has established herself as one of India’s foremost architects who is quietly shaping the future of highend residential design. Her journey into architecture was a path guided by instinct and a deep love for creating beauty. As a bright student and state-level skating champion, she initially considered a career in medicine. But something didn’t click. During family trips, she would often pause in front of grand monuments and palaces, completely taken in by their beauty and presence. There was something about the way they made her feel moved and inspired. That’s when she knew, deep down, that architecture was her true calling. Inspired by iconic designers like Zaha Hadid, Kelly Hoppen, and Kelly Wearstler, she saw the potential to create spaces that radiated positive energy and creativity.
Ms. Aparna’s professional foundation was laid during an internship at a renowned Delhi architecture firm, where she threw herself into every aspect of the work— from site visits to client meetings to coordinating with vendors. This handson experience gave her a practical edge,
which she carried into her own practice. In the early stages of her career, she worked with clients who had a keen eye for design, which challenged her to hone her skills and deliver impeccable results. One of her first projects, a farmhouse with a vibrant tropical and Balinese theme, was a turning point. She wasn’t afraid to dig deep, often spending hours learning, sketching, and experimenting until everything felt just right. She threw herself into the research, excited by the challenge of blending exotic influences with everyday practicality. That project confirmed what she loved most— bringing someone’s idea to life in a way they hadn’t imagined.
Today, Ms. Aparna leads a tightly-knit group of nearly 85 professionals, ranging from architects and designers to engineers and artisans. They don’t just work alongside each other but think, create, and solve
“MS. APARNA’S PASSION FOR DESIGN DRIVES HER TO CREATE IMMERSIVE AND ELEGANT SPACES THAT CONNECT EMOTIONALLY AND INSPIRE LASTING IMPRESSIONS”
problems as one cohesive unit. Together, they tackle every aspect of a project, from architecture to interiors, furniture, lighting, and landscaping. This all-in-one approach ensures that every element of a space works in harmony so as to create a seamless experience for clients. High-networth individuals, who see their homes as more than just buildings but as legacies, are drawn to her meticulous attention to detail. Her ability to translate their desires, sometimes even the ones they can’t quite articulate, into tangible spaces has made her a trusted name in luxury design.
Design for Ms. Aparna has never been just a profession; it is her identity. “I have always loved creating things,” she says. “It gives me a great sense of satisfaction.” From expansive estates to cosy city flats, her projects carry an emotional resonance that goes beyond visual appeal. Each home she designs is a reflection of her belief that good design isn’t just about how a space looks; it’s about how it feels. By harmonising beauty, function, and emotion, she has carved out a unique place in the world of architecture, proving that the best designs don’t just shape spaces—they shape lives.
Ms Aparna starts every project by

listening, not just to what clients say, but to what they feel. This intuitive approach allows her to design homes that reflect their inhabitants’ personalities and lifestyles. Her designs don’t follow fleeting trends; instead, they leverage the timeless principles of classical architecture, while incorporating modern sensibilities.
Collaboration has played a vital role in Ms. Aparna’s journey. By working closely with international designers and artisans, she has expanded her horizons, blending global standards with her own rooted values. These partnerships help keep her work fresh and meaningful, allowing her designs to stay relevant in today’s interconnected world. Still, no matter how far her work travels, her core focus remains the emotional impact of spaces. For her, every project is a fresh canvas—an opportunity to craft a new narrative. With a curious mind, she draws inspiration from her love for art, science, history, and human behaviour, designing spaces that are both thoughtful and aesthetically pleasing.
Leading in a field often dominated by men hasn’t been without its hurdles. Ms. Aparna has faced moments that tested her resolve, but she’s let her work do the talking. Over the years, her contributions have been recognised and celebrated by industry peers. She’s been named among Forbes’ Top 30 Architects of India and listed in LuxeBook’s Top 50 Most Powerful Women in Indian Luxury for 2024. She’s also been honoured at the FOAID Awards, where she has served as a jury member, and received the Smartex Young Achiever’s Award in 2024, alongside recognition from the World Woman Leadership Congress in 2021. These accolades are a byproduct of her deeper commitment to creating spaces that stand the test of time.
Looking ahead, Ms. Aparna shows no signs of slowing down. She is motivated to continually enhance her design skills by exploring new ideas while staying grounded. Whether through sustainable practices, innovative materials, or new design challenges, she sees her work as a lifelong pursuit of clarity and meaning. In an industry often focused on chasing the next big trend, the charismatic leader takes a different approach. She designs residences with timeless appeal, meant to be cherished by future generations.

Ms. Anisha Chandy Eckardt, the Managing Director of Bengaluru-based HOSMAT Hospitals, is a force to be reckoned with in India’s healthcare sector. With a head for strategy and a heart for service, she leads with passion and precision. Ms. Anisha’s success story is one of vision and purpose, where every patient’s smile is her greatest reward
Ms. Anisha earned her Master’s in Health Care Administration from Saint Joseph’s University in Philadelphia. Guided by her father, the Late Dr. Thomas Chandy, who was a respected orthopaedic surgeon and humanitarian, she stepped into a leadership role at HOSMAT (Hospital for Orthopaedics, Sports Medicine, Arthritis, and Trauma).
Under her sterling stewardship, the hospital has expanded well beyond its traditional areas. Considering the evolving needs of patients and advancements in medical science, she introduced high-impact specialities such as Oncology, Reconstructive Surgery, and Pain Management to help the hospital stay ahead of the curve and meet critical health demands with precision and care. Today, HOSMAT operates three hospitals across Bengaluru, with a total of 500 beds, 28 specialised operating rooms, advanced medical technology, and round-the-clock trauma care. It stands tall as a trusted name in quality care and medical innovation.
Ms. Anisha is a leader who believes in walking the talk. With transparency, teamwork, and digital transformation as the pillars of her philosophy, she has breathed new life into HOSMAT’s culture. Her hands-on leadership and can-do attitude have set the tone for ambitious yet achievable growth.
By staying one step ahead of market demands and medical trends, she has positioned the hospital as a leader in integrated care. Her goal has always been to create a hospital environment that not only meets medical needs but also promotes collaboration among clinical teams and continuous engagement with patients.
Ms. Anisha’s governance strategy is built on the principles of clarity and accountability. Through structured Key Performance Indicators, quarterly leadership reviews, rigorous compliance audits, and data-driven decisions, she ensures the hospital runs smoothly and efficiently. With ethics as her north star, she remains uncompromising on patient trust and confidentiality. Like a true leader, she always puts ethics first and never compromises on patient trust or confidentiality.
A goal-oriented individual, Ms. Anisha’s immediate priorities include enhancing personalised care tailored to individual patient needs, expanding telemedicine services to enhance accessibility, and adopting agile operational models. Her long-term vision is to make HOSMAT a gold standard for integrated, value-driven healthcare across the country. She balances ambition with compassion, keeping the patient’s well-being front and centre every step of the way.
Ms. Anisha has steadily made her mark on the healthcare domain with her exceptional leadership and dedication. In 2025, she bagged the Times Power Women Award for Emerging Healthcare Leaders. She was also named Healthcare Leader of the Year at the 12th Outlook Business Spotlight Enterprise & Leadership Awards in Bengaluru. These awards speak volumes about her growing influence and commitment to improving healthcare with passion and honesty.
“WITH ETHICS AS HER NORTH STAR, MS. ANISHA LEADS WITH TRANSPARENCY, INTEGRITY AND COMPASSION”
An alumna of Lady Shri Ram College for Women, Ms. Agarwal holds a Bachelor’s degree in Political Science and a Master’s degree in International Law and Legal Studies from the University of Westminster, London. She initially took charge of managing the legal side of her family’s business. Motivated by the remarkable learning outcomes she witnessed in her daughter at Kangaroo Kids, Mumbai, she brought the concept to Kanpur in 2001, and established a franchise of Billabong High International School. The school’s remarkable success prompted the launch of two additional campuses, which further solidified its status as one of the most progressive international schools in Uttar Pradesh and North India. Affiliated with Cambridge CAIE and CBSE, and regularly hosting global educators, the institution reflects Ms. Agarwal’s commitment to delivering global-quality education locally.
“MS. AGARWAL LEADS WITH A FRESH APPROACH TO PREPARE STUDENTS FOR REAL-WORLD CHALLENGES”
do”—and stayed consistent in her efforts. Slowly but surely, she built trust within the community. Today, the school stands as a respected institution, offering a well-rounded and forwardlooking approach to education that truly supports students’ overall growth.
Guided by the core principles of innovation, empathy, creativity, quality, and teamwork, Ms. Agarwal ensures these values permeate every aspect of her organisation. She prioritises the well-being and development of each child and places them at the heart of all decisions. Her approach encourages original thinking and teamwork, thus creating an environment where ideas are exchanged freely and challenges are resolved collectively.
Under Ms. Agarwal’s stewardship, Billabong High International School Kanpur offers a unique blend of academic excellence and vocational training. Subjects like food and nutrition, design and technology, robotics, artificial intelligence, and emotional intelligence form an integral part of the curriculum. Students are also encouraged to pursue internships aligned with their interests during school breaks, supported by partnerships with industry leaders. She also places strong emphasis on co-curricular engagement and life skills development so that students gain practical knowledge that goes beyond textbooks.
Ms. Agarwal has challenged outdated rote-learning systems and introduced contemporary global approaches in the region. Her affiliations with UCAS and UCLA’s Global Career Network brought advanced academic guidance and career preparedness programs to students. In collaboration with Yale University, she adopted the RULER program, focusing on emotional intelligence. As a result, Billabong Kanpur earned recognition as a Social and Emotional Learning (SEL) school—a first in the area.
Establishing a modern, international school in a traditionally conservative education environment came with its share of challenges. Convincing people to move beyond age-old methods took time, open conversations, and a lot of patience. Ms. Agarwal drew strength from Aristotle’s words—“We are what we repeatedly
Ms. Priti Agarwal, Founder & CEO of Billabong High International School, Kanpur, is one of North India’s most prominent education entrepreneurs and philanthropists. From a legal career to the forefront of education, her journey reflects clarity of vision and an exceptional drive to influence meaningful change education, business, and social activism
Honoured with the National Education Leadership Award (2018) and the Rashtriya Shiksha Ratan Award, Ms. Agarwal has established a distinguished reputation in the education sector. As she continues to elevate standards, drive innovation and empower the next generation, she proves that leadership is not just about building institutions — it’s about building lives.


Mrs. Saroj G. Warke, Co-founder and Director of Information Technology at HiMedia Laboratories Pvt. Ltd., has powered India’s bioscience evolution through determination and innovation. Her journey demonstrates how progressive vision, resilience, and a commitment to excellence can transform a small enterprise into a global leader
Back in 1974, when the biotechnology industry was heavily dominated by multinational companies, Mrs. Warke, along with her husband Dr. G. M. Warke and brother-in-law, Mr. Vishnu M. Warke, decided to take the road less travelled. With no external funding and limited resources, the trio began HiMedia in a basic kitchen setup, which later grew into one of the globally acclaimed Indian-origin bioscience enterprise.
Their goal was to provide high-quality, affordable microbiological products for Indian researchers, educators, and students. This initiative not only made scientific tools more accessible but also fueled India’s self-reliance in bioscience. Now, HiMedia serves over 150 countries and exemplifies the “Make in India” initiative.
Long before “digital transformation” became a buzzword, Mrs. Warke realised that technology would shape the future of every business. In the late 1980s, she brought HiMedia’s first computer on board for stock management and database maintenance, which eventually marked the company’s entry into the digital world. By the 1990s, she had rolled out Oracle-based systems linking production, sales, and finance, creating a truly integrated workflow. In 2006, she advanced the company’s digital journey by adopting SAP HANA, a bold move at a time when such systems were mostly the domain of global giants. Within just five months, HiMedia had fully transitioned to the new platform, aligning operations with global best practices and setting the stage for international expansion.
In 2008, Mrs. Warke rolled out HiMedia’s Dealers’ Portal, enabling real-time communication with distributors. In 2013, she introduced a multilingual labelling system through SAP EH&S—a first for any Indian life sciences company. During the COVID-19 pandemic, while many businesses struggled, she quickly implemented thinclient computing and remote access, keeping operations smooth and showing that foresight and agility truly go hand in hand. Under her direction, HiMedia also embraced RFID-enabled smart warehouses, IoT-driven smart factories, and AI-powered decision-making systems. She set up a dedicated AI team to rethink processes through smart automation, turning
technology from a simple operational tool into a powerful driver of innovation and efficiency.
Mrs. Warke’s leadership philosophy is grounded in clarity, compassion, and collaboration. She believes that Information Technology should function like the nervous system of an organisation. Her approach rests on five pillars: biotechnology, information technology, human resources, marketing, and yoga, each forming an integral part of her holistic management style.
In biotechnology, she guides HiMedia’s R&D efforts to drive innovation. On the IT front, she has helped make HiMedia one of the most digitally advanced bioscience companies globally. In people management, she focuses on empowerment, mentoring, and continuous learning to build a motivated and loyal workforce. Together with Mr. V. M. Warke, she has expanded HiMedia’s reach to many countries, bringing together her tech expertise and his market insight. Her fifth pillar, yoga, mirrors her personal belief in balancing mind, body, and spirit for lasting success.
For Mrs. Warke, yoga is a way of life. A certified Yoga Therapist from AYUSH, she uses her expertise to help people manage conditions like asthma, PCOD, infertility, and stress. She also conducts GarbhSanskar programs for guiding expectant parents to nurture physical and emotional well-being before and after childbirth. She believes that yoga enhances focus and fosters creativity, which is why she encouraged all HiMedia employees to embrace mindfulness, particularly during the challenging times of the pandemic.
Mrs. Warke views competition as a motivator rather than a menace. She believes that rivalry keeps an organisation “on its toes”
“MRS. WARKE UPHOLDS CORPORATE GOVERNANCE BASED ON ETHICS, TRANSPARENCY, & FAIRNESS. SHE PROMOTES PARTICIPATIVE DECISIONMAKING ACROSS ALL LEVELS”
and helps drive innovation. She says, “Competition is not about proving others wrong; it’s about proving yourself right.” Her strategy to stay ahead revolves around three core principles—uncompromising quality, relentless innovation, and deep customer empathy. She encourages her teams to focus on long-term value rather than short-term wins.
A goals-driven leader, Mrs. Warke aims to deepen HiMedia’s digital capabilities by expanding AI, IoT, and automation across operations. Her long-term goal is to democratise science globally so as to make research tools accessible to all, while building a sustainable, AI-driven enterprise.
Mrs. Warke believes in giving back to society. Under her leadership, HiMedia’s CSR work has touched countless lives. A major part of this impact comes through Manobal Foundation, which runs two impactful initiatives. Manobal (Deepstambh Foundation) empowers differentlyabled individuals, orphans, transgender persons, and underprivileged youth by providing education, training, and career opportunities. Likewise, Manobal: A New Beginning Foundation works against human trafficking by rescuing, rehabilitating, and reintegrating victims.
Under her leadership, HiMedia also supports the Autism Intervention Centre at Lokmanya Tilak Municipal Medical College and the Regenerative Medicine Research Centre at Sir J. J. Hospital. Further, projects like the water conservation pond in Nashik and partnerships with Isha Vidhya schools reflect her deep commitment to sustainable community development. During the COVID-19 pandemic, she ensured uninterrupted supply of HiMedia’s essential bioscience products and extended support to frontline workers and affected families.
Under Mrs. Warke’s guidance, HiMedia has embedded sustainability into its core operations. From energy-efficient manufacturing and water recycling systems to responsible waste management and eco-friendly sourcing, every initiative reflects her belief that “progress should never come at the planet’s expense.” She also promotes eco-consciousness among employees through awareness programs and workplace green drives, making sustainability a shared value within the organisation.

Ms. Sumitra Subrata Khanda, Managing Director and Founder of S K Overseas HR Consultancy, is making waves in the global recruitment world with her energy and vision. With a firm belief in the power of hard work and ethical practices, she has built one of the fastest-growing recruitment consultancies serving both India and the GCC
With strong willpower and a clear vision, Ms. Sumitra is making a real difference in the world of overseas recruitment. Starting from humble beginnings, she has built one of the fastest-growing HR consultancies serving both the Indian and GCC markets. She leads with determination, a people-first mindset, and a deep sense of purpose. Her approach is grounded in ethical recruitment, digital
innovation, and a passion for helping job seekers build successful global careers.
Under Ms. Sumitra’s leadership, S K Overseas HR Consultancy has scaled rapidly and expanded operations across key cities in India and the GCC. This regional footprint enables the firm to cater to critical sectors, including oil & gas, construction, marine, and healthcare. Her ability to build trust with clients and candidates allows her to deliver placements that are well-aligned with both strategic business goals and individual career paths.
Ms. Sumitra credits the challenges she faced early in life as the spark that ignited her ambition. Every time someone told her she couldn’t do something, she used it as motivation to push even harder. This inner fire continues to influence the way she leads. It also inspired the motivational training programs she now offers to candidates, helping them build the confidence and mindset needed to succeed in overseas opportunities.
A forward-thinking leader, Ms. Sumitra has spearheaded several industry-first initiatives to streamline and elevate the recruitment experience. These include city-wise targeted interview drives, paperless documentation, and customised manpower solutions for white-collar and blue-collar roles.
Ms. Sumitra describes herself as persistent, confident, and bold leader. Her ability to transform setbacks into opportunities is a source of inspiration for her team and partners. Driven by longterm goals, she is working to position S K Overseas HR Consultancy as a global leader in ethical recruitment. In the short term, she aims to strengthen client engagement and grow the company’s regional presence. Her broader vision is to create a dynamic, techenabled recruitment platform that supports long-term success for both clients and candidates.
Ms. Sumitra sees sustainability as the backbone of the company’s operations. Through digital transformation and operational innovation, she has positioned the company as a forward-thinking recruitment partner. Her goal is to reduce waste and improve her team’s efficiency. These efforts have helped cut down on paper and made her team work more efficiently.
“MS. SUMITRA EXEMPLIFIES A LEADERSHIP STYLE THAT INSPIRES PROGRESS AND EXCELLENCE”
Under Ms. Sumitra’s stellar stewardship, S K Overseas HR Consultancy has earned prestigious accolades, including Client Service Excellence Award, Recognition for Excellence in Recruitment Services, and honours for Regional Leadership & Growth. These awards reflect her foresight in creating a culture of accountability, quality, and trust.
When EPS was established in 2011, Mrs. Mamallan played a decisive role in transforming a vision into a thriving enterprise. Demonstrating remarkable resolve, she pledged her jewelry and house to raise the initial capital required to build the company. Her belief in EPS’s purpose and her regard for colleagues helped lay the groundwork for what has grown into one of India’s respected names in payment technology.
“MRS. MAMALLAN LEADS EPS WITH DISCIPLINED FOCUS, INTEGRITY, & PEOPLE-CENTRIC VISION”
With a postgraduate degree in Economics from the University of Mumbai and a postgraduate qualification in Entrepreneurship and Family Business from IIT Bombay, Mrs. Mamallan entered the professional world with a disciplined approach and genuine respect for people. Before co-founding EPS, she spent over 15 years at Bharat Petroleum Corporation, where she led teams across India and helped strengthen one of the country’s largest retail and distribution systems. That experience honed her understanding of organisational behavior, operations, and leadership, built on accountability.
At EPS, Mrs. Mamallan built a strong HR framework encompassing recruitment, performance management, capability building, and learning initiatives, for shaping a people-centric organisation. Under her leadership, the organisation grew to over 500 employees and achieved ₹430 crore revenue in FY 2022-23, balancing technology and empathy to ensure ethically grounded growth.
Mrs. Mamallan leads with empathy and clarity. She also puts people before processes. By investing in her team and introducing innovative programs, she enhances performance, talent engagement, continuous learning, and organisational resilience, thereby creating a culture where growth and accountability go hand in hand.
One of her landmark initiatives, EPS Academy, was established to prepare skilled professionals for the BFSI sector. Developed to provide comprehensive learning in payment systems, the academy has partnered with Dr. Babasaheb Ambedkar Technological University (Government of India) and its affiliates. This collaboration has helped bridge the long-standing gap between academia and industry, besides building a capable workforce ready to take India’s
Mrs. Vidya Rani Mamallan, Co-founder of EPS, embodies resilience and foresight in India’s fintech sector. Renowned for her empathy and determination, she leads EPS as a people-first organisation, fostering trust, inclusion, and a culture where every individual feels valued and empowered
digital finance ecosystem ahead.
An advocate for inclusion and equitable opportunity, she actively mentors women and young professionals to approach leadership with confidence and integrity. Her management style encourages openness, teamwork, and the decisiveness required to make meaningful choices. These qualities have helped establish a culture of ethics and progress across the organisation.
As EPS broadens its role in advancing financial access and digital integration, Mrs. Mamallan leads with discernment and purpose. She works closely with Founder and CMD Mr. Mani Mamallan to align people strategies with the organisation’s vision for secure and future-ready payment solutions across India.
Her ambition is to position EPS as a workplace defined by empathy, where each individual is recognised, every idea carries weight, and collective success is celebrated. She views business achievement not only through financial results but also through the confidence and integrity that guide the organisation.















A new generation of young leaders is leaving a far-reaching impact on the world. These visionaries are transforming industries, driving technological innovation, and creating opportunities that go far beyond business. They stand out because of their foresight, resilience, and the courage to challenge the status quo. They are rewriting the rules of success and proving that true achievement today is measured not just by wealth or influence, but by impact, purpose, and the ability to build systems that improve lives. Together, they are shaping a connected, progressive, and inclusive future. Let’s celebrate the vision, drive, and creativity of this new wave of leaders. Their journeys inspire us to embrace bold ideas, pursue substantial change, and think beyond conventional boundaries. In an ever-evolving world, these pioneers remind us that leadership is about purpose and leaving a positive mark on society
BY MONALISA CHOUDHURY

MARK ZUCKERBERG FOUNDER, CHAIRMAN, & CEO, FACEBOOK
Mark Elliot Zuckerberg is a prominent figure in the world of technology and innovation. He is widely known as the co-founder and CEO of Meta Platforms, formerly Facebook. Born on May 14, 1984, in New York, his passion for programming inspired him to create several software projects before even entering college. While studying at Harvard, he launched “The Facebook” in 2004 with his roommates. This project soon grew into the world’s leading social networking platform.
Over the years, Zuckerberg has expanded Meta into a global tech hub by acquiring Instagram, WhatsApp, and Oculus VR, and driving advancements in social media, virtual reality, and artificial intelligence. By 2025, his net worth is estimated at over $120 billion, which places him among the wealthiest individuals worldwide. Zuckerberg has earned numerous accolades, including being named Time’s Person of the Year and multiple listings in Forbes’ most influential rankings. Other than business, he is committed to philanthropy through the Chan Zuckerberg Initiative, which focusses on education, health, and scientific research.
Zuckerberg’s journey reflects innovation and social impact, marked by ambition, resilience, and a vision for the future of global connectivity. He lives in California with his wife, Priscilla Chan, and their two children.

CEO, RB CAPITAL GROUP
CO-FOUNDER,
CEO, NAGACORP
CHAIRMAN
CEO & FOUNDER, CALENDLY
CHAIRMAN, RELIANCE JIO INFOCOMM LIMITED
Akash Mukesh Ambani, the eldest son of Mukesh and Nita Ambani, is one of India’s most dynamic young business leaders. Born on 23 October 1991 in Mumbai, he completed his schooling in India before earning a degree in Economics from Brown University, USA. From a young age, Akash demonstrated remarkable business acumen, and today he plays a substantial role in building India’s business and technology scene.
In June 2022, he was appointed Chairman of Reliance Jio Infocomm Ltd., India’s largest telecom network, while also taking key responsibilities in Reliance Retail Ventures Ltd. Under his guidance, Jio has strengthened its leadership in telecom and is rapidly expanding into cutting-edge technologies like 5G, Artificial Intelligence, IoT, blockchain, and digital services.
Akash also focuses on transforming digital services across education, healthcare, commerce, and rural connectivity for driving meaningful impact across society. His achievements have earned him a place in TIME100 Next and Fortune India’s “40 Under 40.”
On the personal front, Akash married Shloka Mehta in 2019, and they have two children. With a forward-thinking vision, and a legacy of excellence, he is leading India’s digital transformation with energy, innovation, and purpose.

PAVEL DUROV FOUNDER-CEO, TELEGRAM
Pavel Durov, born on 10 October 1984 in Leningrad (now Saint Petersburg), is a technology entrepreneur celebrated globally for founding Telegram, one of the world’s most popular messaging platforms. Growing up in an academically inclined family, Durov displayed a keen intellect from an early age. He first came into the spotlight in 2006 when he co-founded VKontakte (VK), Russia’s leading social networking site.
In 2014, he made the bold choice of leaving VK and Russia after refusing government demands to share user data. This decision highlighted his commitment to privacy and digital freedom. Even before this, in 2013, he had launched Telegram alongside his brother Nikolai. The platform is now used by over a billion people worldwide. Telegram is admired not just for its speed and usability but for its strong focus on encryption and independence from government control.
As of 2025, Durov’s net worth is estimated at $17.1 billion; this makes him one of the richest and most influential tech entrepreneurs globally. Known for his minimalist lifestyle, disciplined routine, and low-profile personal life, he inspires millions with his principles and vision. From building Russia’s largest social network to championing digital privacy on a global scale, his journey is a story of courage, conviction, and innovation.

AIRBNB
CO-FOUNDER & CEO, KOPI KENANGAN
PRIMARY HEIR / STAKEHOLDER, PUBLIC BANK BERHAD
CO-FOUNDER & CEO, PHYSICS WALLAH
NEXT-GEN EXECUTIVE, CHAROEN POKPHAND (CP) GROUP
Nathan Blecharczyk, born in 1983 in Boston, Massachusetts, is a celebrated American entrepreneur and the co-founder and Chief Strategy Officer of Airbnb, the world-renowned home-sharing and travel platform. Fascinated by programming from an early age, Nathan began coding in high school. He even ran a small software business and earned enough to support himself before college. He later graduated in Computer Science from Harvard University around 2005.
In 2008, Nathan teamed up with Brian Chesky and Joe Gebbia to launch Airbnb, originally called “Airbed & Breakfast.” As the company’s first engineer and CTO, he built the original website and backend, which eventually laid the foundation for Airbnb’s scalable global platform. Over the years, he transitioned to Chief Strategy Officer and also became Chairman of Airbnb’s China operations, guiding the company’s international growth.
As of 2025, his net worth is estimated at several billion dollars, which makes him one of the richest figures in the global tech scene. Under his direction, Airbnb has transformed the way people travel, besides creating a marketplace that operates in hundreds of countries.
Despite his success, Nathan remains grounded, with a strong focus on innovation and giving back. He, along with his wife, contributes to philanthropy through the Giving Pledge for supporting education and STEM projects. His journey, from writing code as a teenager to building Airbnb into a global travel platform, demonstrates his determination, vision, and the significant mark he has made on the way people travel and connect worldwide.

ALEXEY MORDASHOV CHAIRMAN & MAJORITY SHAREHOLDER, SEVERSTAL
Alexey Mordashov, born in 1965 in Cherepovets, Russia, is a self-made billionaire and one of the country’s most influential industrial leaders. Born and raised in a modest family, his parents worked in a steel mill, which inspired his early interest in industry and economics. In 1988, he joined the same steel plant as an economist, and by 1992, he became its finance director. He became CEO at just 31, and led the plant through privatisation and transforming it into Severstal, a global steel and mining powerhouse.
Under Mordashov’s leadership, Severstal modernised operations, streamlined production, and expanded internationally, turning a Soviet-era plant into a globally competitive enterprise. Apart from steel, he diversified his portfolio by investing in gold mining through Nordgold, engineering via Power Machines, and tourism as a major shareholder in TUI Group. These moves strengthened his reputation as a versatile and forward-thinking industrialist.
As of 2025, Mordashov’s net worth is estimated in the tens of billions of dollars, which ranks him among Russia’s richest and most influential business figures. Recognised for transforming traditional industries and driving large-scale corporate growth, he has tackled challenges and controversies with resilience and strategic foresight. From humble beginnings to international success, the dynamic leader’s journey is a story of vision, determination, and remarkable achievement in the global industrial and business arena.
JIRAYUT SRUPSRISOPA FOUNDER & GROUP CEO, BITKUB CAPITAL GROUP HOLDINGS

Jirayut Srupsrisopa is a Thai entrepreneur and innovator, best known for founding a pioneering financial technology platform in Thailand. Raised in modest circumstances, he developed a keen interest in technology and finance from an early age. Seeing how many people struggled to access banking and credit, he aimed to create a platform that made financial services easier and more accessible for everyone.
Under his leadership, his company transformed the traditional finance model by offering digital banking, micro-loans, and online payment solutions to those previously excluded from the system. His platform quickly gained popularity among young adults, freelancers, and small-business owners who needed fast, flexible, and reliable financial services. By leveraging digital tools and user-friendly design, Jirayut’s innovation helped individuals gain control over their money, access credit, and embrace digital payments.
Other than business success, Jirayut has been recognised for his social impact, particularly in promoting financial inclusion in Thailand. His work demonstrates how technology can address structural inequalities and empower people economically.
Despite regulatory hurdles and strong market competition, the leader remains a leading figure in Southeast Asia’s fintech scene. His journey is a powerful example of entrepreneurship with a social mission. It shows how vision, innovation, and determination can reshape the way people manage money and access financial opportunities in the modern digital era.

SHEIKH TAMIM BIN HAMAD AL THANI EMIR OF QATAR, QATAR INVESTMENT AUTHORITY
Sheikh Tamim bin Hamad Al Thani, born on 3 June 1980, is the Emir of Qatar and one of the youngest monarchs in the world. Born and raised in the royal family, he was prepared from a young age to take on leadership and guide the country. He became Emir in June 2013, after his father abdicated in his favour, and has since played a central role in shaping Qatar’s domestic and international progress.
Under Sheikh Tamim’s leadership, Qatar has pursued ambitious economic diversification beyond oil and gas, investing heavily in infrastructure, education, healthcare, sports, culture, and global diplomacy. His tenure has seen modernisation of institutions, growth in public services, and social development, while positioning Qatar as a prominent player on the international stage. The country has hosted global events, strengthened its international presence, and promoted projects that raise its global profile.
Sheikh Tamim is known for his traditional values with a modern vision. He knows how to maintain stability while encouraging economic progress, investment, and modernisation. He is often described as focused and reserved for his calm and steady approach. Through a mix of inherited responsibility and personal vision, he has steered Qatar towards a diversified, forward-looking economy, which makes him a defining figure in the Middle East and a key influence on the country’s diplomatic path in the 21st century.
KAPUR FOUNDER, ZYBER 365 & XANFI

Pearl Kapur born in Punjab in 1997, is one of India’s youngest tech entrepreneurs and billionaires. He completed his M.Sc. in Investment Banking (CFA Pathway) from Queen Mary University of London and started his career as a business advisor at Antier Solutions and a financial advisor at AMPM Store.
In May 2023, Kapur founded Zyber 365, taking on the roles of Founder & Chairman and CEO of its core operations. The startup, driven by Web3, AI, and cybersecurity, aims to build a complete Web3/AI ecosystem—covering blockchain platforms, smart-contract auditing, decentralized identities, NFT marketplaces, data analytics, and other blockchain-based services. Zyber 365 achieved unicorn status within months, valued at around US $1.2 billion (≈ ₹9,800 crore), making it one of India’s and Asia’s fastest-growing unicorns. Kapur owns a majority stake of about 90%, with his personal net worth estimated at US $1.1 billion (≈ ₹9,100–9,200 crore).
Other than Zyber 365, he launched Xanfi, a multilingual generative AI chatbot for information retrieval, content generation, and real-time insights, proudly positioned as a “Made-in-India” platform. Recognised for his achievements, Kapur received the “Youth Icon of the Year” award in 2024. His journey, from a modest background to shaping India’s Web3 and AI landscape, reflects his ambition, vision, and youthful drive.



The 26th Edition of the Asian Business & Social Forum 2025, was held on 19th of September, 2025 at the JW Marriott Marquis Hotel in Business Bay, Dubai, by URS Media Consulting P.L. The magnificent event witnessed the gracious presence of His Highness Sheikh Al Nuaimi from the Royal family of Ajman, Ambassadors, Deputy Ambassadors, Consul Generals, and senior Diplomats of Zimbabwe, Armenia, Kenya, Philippines, Maldives, Mauritius and Indonesia. The magnificent event witnessed the gracious presence of Dr. J. C. Chaudhry, Founder and Chairman – Chaudhry Nummero Pvt. Ltd, Mr. Omar AlHumaidi, Director, Department of Anti-Injurious Economic Practices, Ministry of Economy, Govt. of UAE, HE Dr. Tariq Al Gurg, CEO & Vice Chairman, Dubai Cares, Dr. Bubbles Kandhari, Director, Al Dobowi Group, Ms. Poonam Bhojani, Founder & CEO, Innoventures Education, Mr. Paras Shahdadpuri, Chairman, Nikai Group, Dr. Shafi Ul Mulk, President, Mulk Healthcare Enterprises, Mr. Avi Bhojani, Group CEO, BPG Group, Dr. Surender Singh Kandhari, Chairman, Al Dobowi Group, and Mr. Feroz Allana, Director, IFFCO Group







































The 26th Edition of the Asian Business & Social Forum 2025 brought together eminent leaders from business, politics, and the arts worldwide, with diplomats and global leaders highlighting international economic and business opportunities.
Global Asian of The Year 2025 / Global Leader of The Year 2025 / Greatest Leaders of the Millennium 2025 / Viksit Bharat Commitment Award 2025: Only par excellence leaders and brands from across India, the UAE, Africa, and the US are worthy of being selected as AsiaOne Global Indian of the Year 2025, Greatest Leaders of the Millennium 2025, and Viksit Bharat Commitment Award 2025, and only exclusive leaders were felicitated at the Summit for their special work in the industry and society: H.E. Dr. Abdulla Busena, Director General, Dubai Customs, Mr. Maran Nagarajan, CEO & Founder, KaarTech, Mr. Sukh Sandhu, CEO, Career Calling International and CAQA, Mr. Piyush Jha, Group VP & MD – Asia Pacific Region at GlobalLogic; Dr. Vishal G. Warke, Director – R&D (Cell Biology & Hydroponics) at HiMedia Laboratories Pvt. Ltd.; Mr. Anish Singh Thakur, CEO of Booming Bulls Academy; Mr. Paras Shahdadpuri, Chairman of Nikai Group; Dr. Shafi Ul Mulk, President of Mulk Healthcare Enterprises; Mr. Avi Bhojani, Group CEO of BPG Group; Dr. Surender Singh Kandhari, Chairman of Al Dobowi Group; Mr. Feroz Allana, Director at IFFCO Group; and Dr. Raza Siddiqui, CEO of Arabian Healthcare Group
Main Brand Awardees include: Trust with Trade Group, The UAE Film Industry, Emirates Environmental Group (EEG), Ayan Beauty, Al Dobowi Group, Innoventures Education, Alvo Connexions Pte. Ltd., Dubai National Insurance (DNI), Ruwad Real Estate, Biznet Consulting, Amber Connect, Tembo Steels (U) Ltd., Dubai Customs, KaarTech, Career Calling International and CAQA, Chaudhry Nummero, DRC Ventures, The Root Brands, FORE School of Management, Apex Buildsys Limited, Dr. S R Chandrasekhar Institute / VARS Group, Jaipur National University, FAME Advisory DMCC, ArMee Infotech, Kumar Sunil & Associates,





Roswalt Realty, Rashmi Group, Translab Technologies, Elpro First Steps, Aurigene Pharmaceutical Services, 1st Glove, Elpro International School, HOSMAT Hospitals, WattPower, Ikeda Ltd., Electronic Payment & Services Pvt. Ltd., Matx Structures Pvt. Ltd., Aparna Kaushik Design Group, Kaar Technologies India Private Limited, Goyal Books Overseas, BCD Global, GlobalLogic, HiMedia Laboratories Pvt. Ltd., Booming Bulls Academy, Nikai Group, Mulk Healthcare Enterprises, BPG Group, IFFCO Group, Arabian Healthcare Group, S K Overseas HR Consultancy, Modern Group of Industries, Amber Group, Rishabh Group of Companies, Century Trader App, Kalyani Steels Limited, Trayak Consultancy Pvt. Ltd., Murli Krishna Pharma Pvt. Ltd., Allied Digital Services Limited, J K Jajoo Ventures, Amin Mohammad Group, Nutridor Dairy Manufacturing LLC, Livexpo Ventures, Octagon International, Diagnofirm Medical Laboratories (DML), Hosaf Group, Align Staffing Solutions.
Main Leader Awardees include:
Dr. Arshi Ayub Mohamed Zaveri, Ms. Fatima Al Taei, Ms. Zainab Al-Eqabi, Ms. Habiba Al Marashi, Ms. Taim Al Falasi, Ms. Amal Albalooshi, Ms. Chanel Ayan, Dr. Bubbles Kandhari, Ms. Poonam Bhojani, Ms. Alka Chandiramani, Mr. A.R. Srinivasan, Mr. Ismail Al Hammadi, Mr. Sanjay Awasthi, H.E. Dr. Abdulla Busena, Mr. Maran Nagarajan, Mr. Sukh Sandhu, Dr. JC Chaudhry, Dr. Christina Rahm, Prof. Subir Verma, Mr. Pankaj Agarwal, Mr. Lion V.V. Krishna Reddy, Dr. Sandeep Bakshi, Mr. Nirav Shah, Mr. Ridhish Patel, Mr. Sunil Kumar Agarwal, Ar. Shantanoo Vishwanath Rane, Mr. Gaganjit Singh, Mr. Clayton Thomas, Mr. Piyush Jha, Dr. Vishal G. Warke, Mr. Anish Singh Thakur, Mr. Paras Shahdadpuri, Dr. Shafi Ul Mulk, Mr. Avi Bhojani, Dr. Surender Singh Kandhari, Mr. Feroz Allana, Dr. Raza Siddiqui, Mrs. Saroj G. Warke, Ms. Anisha Chandy Eckardt, Ms. Sumitra Khanda, Ms. Aparna Kaushik, Mr. Ashish Monpara, Mr. Dushyant Savadia, Mr. Dinesh Musalekar, Mr. R. K. Goyal, Mr. Swetang Sinha, Dr. Satya Vadlamani, Mr. Nitin Shah, Mr. Jai Krishan Jajoo, Mr. Sankha Biswas, Dr. Navneet Vats, Ms. Venkata Lakshmi Haritha Vadlamani, Mr. Sukant Mishra, Dr. Mohammed Chand, Mrs. Mehtaj Hossain, Mr. Mabroor Hossain.





Every strong field has a strong farmer behind it.
Serving more than 5 million farmers, AlgaEnergy provides microalgae-based inputs that strengthen crops at the root.







40 Under 40 are Chosen Annually through a Passionate Research, Scouting across 16 Industries of Business and Leadership. Only the Most Worthy are Chosen. If You Also Feel You Have It in You, Then Apply for Open Nominations on dubai@asiaoane.co.in with 500 Words on Your Achievements
40 is an Age of Achievements, Maturity & Triumphs - both Personal & Professional. 40 Under 40 is a Compilation of the 40 Most Influential Leaders Curently Under the Age of 40
THOMAS Founder, The Root Brands
Opera N More Ventures


KIRLOSKAR Executive Director & CEO, Kirloskar Systems Limited





Recognised as one of the most influential young leaders of her generation, Ananya Birla embodies the spirit of a true karmayogi, someone who pursues excellence not merely for personal success but for collective progress. From an early age, she displayed an innate ability to combine ambition with responsibility. At just 17, she founded Svatantra Microfin, a pioneering venture that empowers women entrepreneurs in rural India by providing access to financial services, skill development, and long-term economic stability. Over the years, Svatantra has evolved into one of India’s fastest-growing microfinance institutions, impacting millions of women across the country and redefining inclusive finance.
PLAYING
Ananya always chose to do things differently.
A multifaceted personality of rare elegance and ambition, Ananya Birla stands as a luminous symbol of modern Indian leadership. An entrepreneur, singer, songwriter, and youth icon, she brings together creativity and commerce with remarkable ease, crafting a legacy defined by innovation, empathy, and commitment to purposeful growth
A quiet, observant and introspective child, she had an interest in music since an early age. She learnt to play santoor when she was just 11 years old. As she grew, so did her interest in music. She taught herself to play the guitar with the help of video tutorials on the web. This was the beginning of a passion that continues to grow even today.
Ananya is an acclaimed singer who writes her own songs. ‘I Don’t Want to Love’ is her much acclaimed song which first brought her to the music scene. She was signed as an artiste by the Universal Music Group (India). Her debut single ‘Livin the Life’ was launched worldwide in November 2016. ‘Meant to Be’ is the second international single released in July 2017 & has been certified ‘PLATINUM’ as per the standards followed by the Indian music industry, which makes her the first Indian artist to go Platinum.
In 2022, Birla ventured into acting with her debut appearance in the song “Inaam” from the streaming television series Rudra: The Edge of Darkness. Her official acting debut took place in 2023 in the spy thriller titled Shlok: The Desi Sherloc, directed by Kunal Kohli.
Ananya’s achievements extend far beyond the creative sphere. In 2025, she launched Birla Cosmetics, a future-forward beauty brand built on innovation, sustainability, and inclusive design, aimed at redefining the Indian beauty market for the global consumer. The same year, she took on a strategic leadership role at Aditya Birla Global Trading, contributing to the group’s international business expansion and strengthening its presence across global markets. Alongside this, she also founded Curo Carte, a premium global e-commerce platform curating luxury lifestyle products from nine countries, positioning herself as a powerful tastemaker in digital commerce.
“ANANYA EXEMPLIFIES THE COURAGE TO LET GO OF THE COMFORT ZONE & PURSUE HER DREAMS THROUGH HARD WORK”
After working with a student welfare charity in London and engaging closely with young people facing anxiety and depression, Ananya co-founded MPower with her mother, Neerja Birla. MPower works to dismantle stigma around mental illness in India by providing holistic mental healthcare, awareness initiatives, counselling services, and youth-focused workshops. Through MPower and Svatantra, Ananya drives meaningful social change, demonstrating that genuine leadership extends beyond personal success to service, empathy, inclusion, and long-term, sustainable social transformation that empowers communities, strengthens resilience, and prioritises wellbeing across diverse age groups.
Mr. Akhil Ravi, CEO of Aurigene Pharmaceutical Services, a subsidiary of Dr. Reddy’s Laboratories, is driving a sharp strategic focus on affordable & innovative drug development. With a people-first approach, he is charting a path where quality and compliance meet real-world healthcare impact
Mr. Akhil holds a B. Tech degree in Chemical Engineering from IIT Bombay and an MBA from the Indian School of Business. Prior to becoming CEO of Aurigene Pharmaceutical Services, he held various roles at Dr. Reddy’s, including Head of Strategy for Services and APIs, Head of Sales for APIs in Europe, and a brief stint as Plant Head.
He joined Dr. Reddy’s in 2018, following his tenure at McKinsey & Company. Since taking the reins at Aurigene in February 2022, he has leveraged his experience at Dr. Reddy’s and McKinsey to sharpen Aurigene’s capabilities in integrated drug discovery and manufacturing, while promoting a culture where science, sustainability, and people matter.
A forward-thinking leader, Mr. Akhil believes that innovation must be accessible, and leadership is about enabling that access with clarity, consistency, and purpose. More than managing operations or meeting targets, he is focused on connecting innovation to impact. At the same time, he is focused on building partnerships that bridge the gap between discovery and delivery, thereby ensuring new medicines reach those who need them. His approach is grounded, practical, and centred on value-creation rather getting swept up in industry hype.
Instead of chasing every market trend, Mr. Akhil is focused on doing a few things really well. Under his direction, Aurigene is concentrating its efforts on specific scientific capabilities such as drug discovery and large molecule development — areas where thoughtful investment and deep expertise matter more than speed.
Being a pragmatic leader, he isn’t in a rush to scale up for the sake of growth. Instead, he is building a company that stays closely connected to its customers. While many leaders talk about rapid expansion, he emphasises measured, sustainable progress. He has led major investments in digitisation and infrastructure upgrades, with a clear

understanding that quality and compliance are not optional but nonnegotiable. His focus remains on how many drug candidates move forward into clinical trials, seeing this as the clearest indicator of meaningful progress.
For Mr. Akhil, building a high-performing team is a top-line priority. He acknowledges that scientific ambition is only half the battle; the other half is finding and growing the right workforce. The demand for top-tier talent in the CDMO and CRO sectors is fierce, and Aurigene, under his sterling stewardship, is investing with intent. The company’s internal framework, called “Aspire,” encourages leaders to think big, act fast, and lead with clarity. It is less about hierarchy and more about getting the right mindset across the organisation. He believes that a company’s culture can’t be built in boardrooms; it’s shaped in day-to-day decisions, hiring calls, team reviews, and how success is measured.
“GUIDED BY A CLEAR SENSE OF PURPOSE, MR. AKHIL BRINGS A FOCUSSED APPROACH TO LEADERSHIP”
Mr. Akhil’s impactful leadership and progressive mindset have earned him widespread recognition within the industry. In 2024, he earned a prestigious spot in the Economic Times’ 40 under 40 list, an accolade reserved for India’s most promising young leaders who are not only excelling in their fields but also revolutionising the future of business. His inclusion in this elite group underscores both his personal influence and Aurigene’s rising stature in the domain of global life sciences.

With more than two decades of hands-on experience, Mr. Arul has steadily built a reputation for reliability and conviction in India’s renewable energy sector. Born and raised in a modest village in Kanyakumari district, he developed a fascination for windmills during his college days. His passion was so strong that he worked night shifts at a windmill site while attending classes during the day. That early exposure shaped his long-term commitment to clean power and prepared him for the demanding path ahead.
After holding important roles at Siemens Gamesa India, Vestas Wind Technology, and NEPC, Mr. Arul chose to channel his knowledge into something of his own. In 2021, he founded CALS Renewable Energy to contribute
Mr. Arul Balan R., Founder, Chairman, and Managing Director of CALS Renewable Energy India, is a leader whose journey reflects grit, purpose, and belief in clean energy. His success story stands as a reminder that passion, when paired with discipline and sacrifice, can transform an entire industry
meaningfully to the shift away from fossil fuels. Today, CALS stands as a respected name offering dependable wind and solar solutions, backed by technical depth and regulatory clarity. Under his guidance, the company has delivered close to 350 MW of renewable energy projects, thus improving India’s push toward cleaner power.
Mr. Arul is known for his straightforward leadership approach. He focuses on empowering his teams, promoting clear communication, and giving individuals the freedom to think independently and take responsibility. His style is calm and built on trust. He often reminds his team that they don’t need to see the whole staircase to take the first step—a belief he applies both in decision-making and in his own growth. In his view, people perform at their best when they feel trusted and included in the company’s larger mission.
To keep pace with changing times, Mr. Arul stays engaged with industry reports, e-magazines, and expert discussions at conferences. This steady flow of information helps him align his company with what the market will need tomorrow, not just what it expects today. As technologies like large-format wind turbines, advanced PV modules, and AI-based monitoring systems evolve, CALS has adopted them early, improving efficiency and reducing costs for clients.
Challenges, according to Mr. Arul, are simply steps that sharpen resilience. The leader sees every setback as a chance to grow. He urges young entrepreneurs to remain honest, stay focused on their purpose, and keep working hard, especially when progress feels slow.
Going forward, Mr. Arul plans to support India’s clean energy goals and help achieve net-zero emissions by 2050. He aims to ensure every project carried out by CALS adds lasting value for communities and the environment. By prioritising both high-quality solutions and sustainable practices, CALS, under his stewardship, is creating meaningful, long-term benefits while advancing India’s renewable energy transition. This dedication not only supports global sustainability efforts but also drives impactful change across the energy sector, thus building a cleaner, greener future for generations to come.
“UNDER MR. ARUL’S LEADERSHIP, CALS RENEWABLES ENERGY HAS DELIVERED CLOSE TO 350 MW OF RENEWABLE ENERGY PROJECTS”
A celebrated entrepreneur, Mr. Arul was honoured with Business Community Award 2024 in the category of Business Excellence by All India Business and Community Foundation.
Mr. Bal Krishen, Chairman and CEO of Century Financial, has built his life on determination and a sense of purpose. From his modest beginnings in Jammu and Kashmir to leading one of the UAE’s most respected financial institutions, his journey reflects a path of humility, and hard-earned success
Growing up in a family of nine children, life was never easy for Mr. Bal Krishen. From a young age, he took on various odd jobs to support his family and build a better future. His first taste of leadership came through an entrepreneurial venture in his hometown, an experience that laid the foundation for his future as a leader.
When his father chose to retire from employment, Bal Krishen took a decisive step and moved to Dubai in 1996 in search of new opportunities. With limited means and no connections, he entered the hospitality sector, where he gained practical experience in discipline, service, and respect. There, an encounter with an experienced banker prompted him to explore a career in finance, a decision that later shaped the direction of his professional life.
In 1999, fate introduced Mr. Bal Krishen to Emirati businessperson Sulaiman Baqer Mohebi, then Chairman of Century Financial. Impressed by his honesty and work ethic, Mr. Mohebi appointed him as a dealer, a step that opened the doors to the world of finance.
From there, his progress was steady and driven by effort. Mr. Bal advanced from trade management to market analysis, investment oversight, and strategic planning. Over the years, he held several key leadership roles before becoming Chairman and CEO. His journey at Century reflects perseverance, consistency, and commitment from the ground floor to the top. Colleagues describe him as firm yet composed, a thoughtful listener who leads by example. For him, leadership means empowering others and promoting a culture where people learn and grow together.
With Mr. Bal Krishen at the helm, Century Financial has become the UAE’s go-to financial services brand. His global market experience,

across equities, commodities, real estate, and currencies, enables him to create investment solutions that serve genuine needs. His emphasis on trust, transparency, and long-term relationships has earned the confidence of clients across generations.
He has led Century through a time of change, balancing the wisdom of experience with the pace of contemporary finance. By embracing technology to strengthen a customer-centric culture, he ensures that Century grows with intent and stays future-fit. Mr. Bal Krishen is also a hands-on philanthropist in India and the UAE, with a focus on education, community welfare, and healthcare. For him, philanthropy is not an obligation but a way to stay humble and thankful.
Mr. Bal Krishen’s commendable efforts have been honoured with several prestigious awards. Recently, he was honoured with the Visionary Leader in Financial Services Award at the Accounting & Finance Awards 2025. He was also nominated for Business Leader of the Year by Gulf Business Awards 2021.
“HARD WORK & DETERMINATION HELPED MR. BAL KRISHEN CLIMB FROM HUMBLE ORIGINS TO CORPORATE LEADERSHIP”
Despite his hectic work life, he remains deeply connected to his family and traditions. He credits his wife and children as his greatest source of strength. To keep himself calm and focused, he begins his day with yoga and quiet reflection. To him, leadership is not about titles but responsibility towards people, values, and the future.

Mr. Choraria studied at Jain International Residential School in Bangalore and Rai School in Kathmandu, followed by a BBA in Marketing from the Birla Institute of Management. Despite being part of established family enterprises, he followed his own path, starting as Executive Director at Enforce Solutions in Nepal. Guided by a strong entrepreneurial instinct, he co-founded an LED company in India in 2013, and later helped launch a platform for promoting residential and commercial solar adoption.
In 2017, Mr. Choraria co-founded Wattkraft Industries Pvt. Ltd. in India, further expanding his footprint in renewable technology. By 2021, he had ventured into alternative asset management platforms with a focus on renewable assets and plant optimisation. Considering the urgent need for climate action and the vast potential of solar energy in reshaping global energy systems, he
Mr. Divya Prakash Choraria, CEO and Co-founder of WattPower Systems Private Limited, has built a reputation as a distinguished figure in technology and entrepreneurship, driven by his passion for innovation, ambitious goals, and openness to new ideas
co-founded WattPower Systems Private Limited in 2022 to accelerate the transition toward renewable energy through advanced, highquality solar products and customer-centric solutions.
Mr. Choraria’s interest in renewable energy began during his academic years, when the concept of sustainable development inspired him. He explored opportunities to contribute to the clean energy sector and gained valuable experience through various professional roles that strengthened his understanding and purpose. These experiences deepened his commitment to advancing renewable energy and creating real environmental and social impact, which ultimately led to the founding of WattPower as a platform for innovative energy solutions.
Mr. Choraria believes in upholding the highest product standards through rigorous testing and adherence to global benchmarks. Under his leadership, WattPower’s solar inverters are designed for maximum efficiency, reliability, and intelligent performance. His expert team develops systems that enhance energy output and maintain smooth plant operations. Every unit undergoes multiple testing phases to ensure durability and precision. With smart monitoring and control features, users can track performance in real time and detect issues early.
Known for his collaborative spirit, Mr. Choraria actively engages with emerging innovators and startup founders. Through angel investments, he extends financial support and mentorship to promising ventures. He also helps young entrepreneurs in tackling the challenges of launching and scaling new ideas. An adaptive learner and unconventional thinker, he stresses the importance of applying knowledge in practice rather than viewing it as mere theory.
“MR. CHORARIA STANDS OUT FOR HIS INNOVATION, INVESTMENTS, AND OUTSTANDING ENTREPRENEURIAL SPIRIT”
Mr. Choraria’s long-term goal is to build an energy-positive world by making solar technology widely accessible. He seeks to accelerate the global move toward renewables through intelligent, secure, and scalable solutions. His focus is on broadening the reach of solar inverters, upgrading systems with digital innovation, and ensuring high operational standards. With this approach, he actively aligns business growth with environmental responsibility and technological advancement.
Dr. Mohammed Chand, Medical Director of Botswana-based Diagnofirm Medical Laboratory, is a serial entrepreneur whose work spans medicine, technology, and business. With hands-on business acumen, he has become a trusted name in healthcare and a revered figure across multiple industries
Raised with a deep appreciation for service and excellence, Dr. Chand’s approach to leadership is refreshingly grounded. He believes that healthcare must be both accessible and reliable, and that technology, when used wisely, can close gaps that have existed for decades. His specialised training in global health systems and AI-driven solutions allows him to introduce practical, forward-looking tools that elevate diagnostics and patient care. He has become known for his ability to anticipate what communities will need tomorrow — and begin building it today.
Under his stewardship, Diagnofirm Medical Laboratory has grown into a trusted national network with six full-service laboratories and over 70 collection points across Botswana. Every test processed within this network reflects his commitment to precision, empathy, and global-quality standards. During Botswana’s COVID-19 crisis, his leadership proved crucial as he launched the first private testing service and expanded it to 72 sites, ensuring no community was left behind. Through operational discipline and strict regulatory alignment, he positioned Diagnofirm as the market leader during one of the most challenging healthcare periods in modern history.
Dr. Chand’s influence reaches far beyond the laboratory space. A true multi-sector entrepreneur, he plays a hands-on role in industries as diverse as pharmaceuticals, hospitals, telecommunications, agriculture, food services, and electrical manufacturing. His portfolio includes Delta Diagnostics, Dawa Pharmaceuticals, Agile Hospitals, Kauai Botswana, Wireless 360, Excellent Winners Agriculture, Lesedi Board, and Sharps Electrical Company. Each venture benefits from his ability to blend vision with disciplined execution. His leadership style is rooted in identifying genuine opportunities, developing capable teams, and ensuring sustainable long-term growth.

He is also an active member of the Young Presidents’ Organisation (YPO), where he connects with global leaders. This international exposure enriches his thinking and allows him to benchmark Botswana’s progress against world standards. By exchanging knowledge with CEOs, innovators, and policymakers worldwide, he brings back strategies that fuel innovation across his ventures and uplift the communities he serves.
Dr. Chand is recognised not for the scale of his work, but for the purpose and intention driving it. He strives to improve lives by enhancing diagnostics, hospital support, supply chains, and healthcare technology guidance. He is known for balancing bold ambition with personal humility, a quality that has earned him deep respect within business and public sectors. His decisions consistently reflect responsibility, empathy, and commitment to national development.
“A LEADER WORTH KNOWING. A JOURNEY WORTH FOLLOWING. AND A STORY THAT UNFOLDS WITH PURPOSE AND MOMENTUM”
Today, Dr. Chand stands out as a forwardthinking leader. By strengthening people-focused healthcare, uplifting communities through impactful businesses, and inspiring young leaders to build ethically, he is shaping a chapter for Botswana rooted in innovation, compassion, and the courage to push new possibilities.

Dr. Swetapadma Dash’s life reflects purposeful resolve. A serious accident in her childhood led to the loss of a limb, and she was classified as 75% disabled. Rather than allowing that label to define her, she chose to forge her own path through selfbelief and perseverance. After finishing her schooling, she earned an MSc in Clinical Psychology from Manasa Gangotri, followed by an MPhil from Utkal University. She is currently pursuing her PhD in the same discipline.
Dr. Swetapadma’s professional journey began at Ayush Hospital in Bhubaneswar, where she served as a clinical psychologist and coordinated hospital services. She later moved to Apollo Hospital, taking on roles such as Manager of Quality, Senior Manager of Quality and Strategic Initiatives, and Deputy General Manager of Operations, Quality, and Research.
Dr. Swetapadma Dash, CEO of SUM Ultimate Medicare in Bhubaneswar, is admired for her veracity, balanced leadership. Her calm presence, adaptability, and thoughtful outlook shape an environment where people feel heard and encouraged to make meaningful contributions
In December 2018, she joined SUM Ultimate Medicare, where she now leads the hospital as CEO.
Under her leadership, SUM Ultimate Medicare has grown into a leading multi-super specialty quaternary care hospital, providing advanced medical services to Odisha and neighboring regions. For Dr. Swetapadma Dash, her focus is supporting the professionals who care for patients and guiding the hospital toward consistent, high-quality care for every citizen.
Dr. Swetapadma is known for her analytical clarity and deep understanding of human behaviour, which enable her to steer complex situations with poise. She has been instrumental in bringing several first-of-its-kind events to Odisha, including the 4th World Conference on Comprehensive Critical Care and the National Conference on Interventional Radiology. She also contributed to Odisha’s first multi-organ retrieval and transplant from a deceased donor, an achievement that broadened awareness of organ donation in the region.
In her role as CEO, Dr. Swetapadma strives to strengthen SUM Ultimate Medicare’s position as a preferred destination for clinical care and recovery. She ensures that treatments and therapeutic practices are updated, accessible, and delivered within technologically enabled settings with efficiency, and compassion.
In 2025, Dr. Swetapadma was named among the Women Torchbearers of Viksit Bharat by Outlook’s Special Edition. In 2024, she received The Prativa Samman for Healthcare in Odisha from the Jyotsna Charitable Trust. In 2023, she was honoured with the Businesswoman Leader of the Year award from News18 in collaboration with Rotary. The Six Sigma Healthcare Excellence Awards recognised her as Best CEO and Administrator of the Year n 2022. Additional recognitions include Excellence in Healthcare Leadership at the Odisha Women Excellence Awards, Most Innovative CEO in the Healthcare sector from the Times Power Women Awards, and the Kalinga Virangana honour in 2017.
“DR. SWETAPADMA STRIVES TO MAKE SUM ULTIMATE A TRUSTED & PREFERRED DESTINATION FOR CLINICAL CARE & RECOVERY”
Under her leadership, SUM Ultimate Medicare received the Six Sigma Award as Best Hospital and Best Patient Care Provider for 2021. Within its first two years, the hospital earned NABL Accreditation and HACCP Certification, demonstrating strong systems and operational excellence.
Mr. Vikrant Goyal, Director of Goyal Books Overseas Pvt. Ltd., has upheld his family’s legacy in education, publishing, and enterprise development by bringing steady leadership, entrepreneurial energy, and integrity to broaden the company’s reach and support purposeful new initiatives
Goyal Books Overseas Private Limited functions as the export division of Goyal Brothers Prakashan, serving the K-12 sector internationally. Mr. Goyal’s operational discipline and organisational capability, along with the guidance of his father, has helped the firm expand its footprint from the initial five retail locations in the GCC to 15 outlets across the Middle East, considerably expanding its regional reach.
Mr. Goyal completed his schooling at Delhi Public School, R.K. Puram, followed by a degree in International Business from the University of Manchester. Upon returning to India, he entered the family’s publishing businesses, thus bringing renewed clarity and structured thinking to established operations. In his current role at Goyal Books Overseas Private Limited, the young leader is fortifying the organisation’s global presence.
Mr. Goyal’s entry into the publishing sector marked a fresh and forward-looking phase for Goyal Brothers Prakashan. With his strong grasp of traditional publishing methods and a keen awareness of modern content technologies, he helped the company strengthen its connect with expatriate communities and broaden its reach across the region. His efforts supported the expansion of academic book distribution, improved the organisation’s visibility among schools and educators, and added momentum to its international growth. Through a balanced approach that respected legacy while embracing innovation, he played an important role in enhancing the company’s global presence and credibility.
In the GCC, where the company already had a presence, his stellar leadership played a substantial role in consolidating and intensifying operations. This included building stronger relationships with educators, institutions, and distribution partners, ensuring that the organisation remained responsive to evolving academic requirements.

Mr. Goyal also contributes as a sales and marketing specialist at Goyal Brothers Prakashan, facilitating the company’s transition into contemporary publishing formats. His entrepreneurial inclination led him to co-found Inventant Education, a STEM-focused publishing initiative designed to enrich experiential learning in K-12 environments.
The young leader also founded First Choice Stationery in Noida and established the Educators Guild of India, a platform intended to bring educators together for dialogue, collaboration, and shared professional growth. His latest venture, The Face Company in Delhi NCR, reflects his ability to diversify into sectors beyond publishing while maintaining disciplined execution.
Recognition for Mr. Goyal’s contributions has come from varied quarters, including an occasion where the Prime Minister of Sri Lanka honoured him at the CBSE Gulf Sahodaya Conference in February 2024. He also received an award from the Minister of Road Transport and Highways of India on Vijay Diwas. This award was presented by the Veterans India committee in 2023.
“A PROGRESSIVE LEADER, MR. GOYAL HAS MODERNISED GOYAL BROTHERS PRAKASHAN, BESIDES TRIPLING ITS GCC PRESENCE”
Under his guidance, the company has consistently earned the Government of India’s CAPEXIL Award of Merit in Export for nearly two decades, reinforcing its reliability in the international publishing landscape.
In a world brimming with choices, some brands do more than sell—they connect, inspire, and become an indispensable part of daily life. The Greatest Brands 2025-26 recognition by AsiaOne Magazine celebrates those that earn loyalty not just through products, but through trust, care, and memorable experiences. From everyday essentials to pioneering innovations, these brands influence lifestyles, shape decisions, and create moments that matter. They set benchmarks in quality, service, and brand experience, inspiring both consumers and the industry. This prestigious platform honours the names that touch lives, redefine standards, and continue raising the bar for excellence, innovation, and meaningful impact across sectors





Bajaj Auto, part of the renowned Bajaj Group, is a leading manufacturer of twoand three-wheelers with a market capitalisation of around INR 1 trillion. Since 1945, it has built a strong reputation for producing innovative and high-quality automobiles
Bajaj Auto Ltd. is a leading Indian multinational automotive manufacturing corporation, headquartered in Pune. It is known for its production of motorcycles, scooters, and auto rickshaws. An integral part of the Bajaj Group, Bajaj Auto was founded by the notable Jamnalal Bajaj in Rajasthan during the 1940s. Over the years, the brand has successfully ventured into various sectors, including electric vehicles and CNG, while also expanding its international presence. This reflects the company’s focus on adapting to new market trends and staying competitive in the fast-changing automotive sector. Under the leadership of Managing Director, Mr. Rajiv Bajaj, Bajaj Auto is shaping a strong brand-led strategy to position itself as a leading manufacturer of motorcycles and electric vehicles worldwide
Bajaj Auto offers an extensive selection

of three-wheelers and two-wheelers. Its motorcycle range includes the Freedom, Pulsar, Dominar, Avenger, Platina, and CT series. It offers everything from sporty and touring models to cruisers, fuel-efficient commuters, and affordable entry-level bikes.
The Bajaj Chetak stands out as an electric scooter manufactured by Bajaj Auto. In three-wheelers, the company offers models like the Bajaj Gogo, Etec, RE, Maxima Z, Maxima Wide, and Maxima C. It has

also launched the Bajaj Qute, a compact vehicle that combines the features of an autorickshaw and a small car, with space for a driver and three passengers. All these products follow high-quality standards under the company’s Total Quality Management system, ensuring strong build quality, fuel efficiency, low maintenance, and consistent customer satisfaction. This commitment is reinforced by favourable customer feedback for specific models, impressive market performance, and the implementation of quality assurance practices to guarantee consistency.
Bajaj Auto is expanding globally through its subsidiaries such as PT. Bajaj Auto Indonesia, Bajaj Auto International Holdings BV in the Netherlands, Bajaj Auto (Thailand) Limited, Bajaj Auto Spain, S. L., and Chetak Technology Limited. PT. Bajaj Auto Indonesia is actively involved in the trading, import, and export of Bajaj Auto’s two-wheelers and three-wheelers within Indonesia. Bajaj Auto International Holdings BV focuses on investment endeavours. Over the years, Bajaj Auto (Thailand) Ltd. has developed the International Business Centre and Engineering Design Centre. Likewise, Bajaj Auto Spain, S.L., a wholly owned subsidiary, operates a design studio in Spain. Chetak Technology Limited, also fully owned by Bajaj Auto, focuses on opportunities in the evolving mobility sector and plans to manufacture electric and hybrid vehicles across two-wheelers, threewheelers, and light four-wheeler.
The Bajaj Group believes that real growth relies on the impact businesses create in people’s lives. The Group has invested over Rs. 1,300 crore in initiatives focused on education, skilling, health, livelihoods, and water conservation. Through the Bajaj Education Initiative, it supports 76 underprivileged schools in Pune by strengthening infrastructure and capacity. It also partners with the Bharatiya Yuva Shakti Trust to help develop 1,000 entrepreneurs within five years. Bajaj Auto further advances science and technology education by promoting STEM-focused skill development. With a strong emphasis on youth empowerment, the company aims to enhance employability and support industrial transformation through the BAL CSR Skilling Initiatives and the Bajaj Engineering Skills Training (BEST) programme.

An offshoot of The Foundation for Organisational Research and Education (FORE), FORE School of Management (FSM) has dedicated itself to management education, development and research. With a vision to promote innovation, nurture human talent, and enhance social systems, the institute provides research-based and applicationoriented education. The nurturing at the institute is not limited to classroom studies but there is an equal focus on knowledge enhancement and sharpening of skills through various extra-curricular activities and co-curricular activities.
The courses offered by the New Delhibased institution are approved by the All India Council for Technical Education and are recognised as equivalent to PGDM/ MBA by Association of Indian Universities (AIU). The institution has also been granted SAQS Accreditation for a period of five years till September 2028.
FSM has been offering post-graduate programmes since 1992 and over 7,000 plus students have graduated from the institute since then. The institute has been thoughtfully built to make young minds future-ready and help organisations remain relevant in the fast-changing world by adopting the latest tech-driven changes. At FSM, application-oriented research and skill development are at the core of its philosophy. The institute focuses on encouraging lifelong learning, innovation, fostering entrepreneurship, and building a talent pool that can thrive in the present and be prepared for the future. It helps students develop skills they can monetise and apply in real-world careers.
FSM is also home to some esteemed teaching faculty who not only imparts knowledge of current developments to students but also contribute to


INSPIRING MANAGEMENT EXCELLENCE
FORE School of Management (FSM) is a leading institution for Management education and research. As a centre for excellence in Business & Management education, it prepares students to become future entrepreneurs and innovative leaders, by equipping them with the skills needed to thrive in a globalised world
groundbreaking research. The faculty members actively develop quality teaching methods, contribute to research publications, and regularly take part in Seminars and International conferences.
To further this contribution to management research, FSM has established several Centre’s of Excellence, that undertake domain-specific research, provide ongoing training to faculty members and foster entrepreneurship among students in Artificial Intelligence (AI), Machine Learning (ML), Block Chain (BC), Fraud Detection and Analytics.
FSM facilitates corporate interactions to create a thriving environment for students to gain hands-on experience as part of the curriculum. Under faculty supervision, students undertake several unique corporate-supported projects that have expanded their skills. The institution also gives students a sneak peek into
global best practices through a short but intensive ‘International Immersion Programme’ at an overseas location i.e Nanyang Business School (NBS), Nanyang Technological University (NTU), Singapore, SDA Bocconi School of Management, Milan, Italy, Frankfurt School of Finance and Management, Frankfurt (Germany), Risk Management Institute (RMI), National University of Singapore (NUS), Singapore, ESSEC, Paris, Rochester Institute of Technology, Dubai (UAE), ESC Rennes School of Business, France, University of California, Riverside (IEP), USA, National Research University, Higher School of Economics, Moscow, Russia, Ureka Education Group, UK.
GLORIOUS ACHIEVEMENTS
Over the years, FSM has earned several notable awards, including the Dewang Mehta National Education Award for National Best Institution in 2024, and Best Education Brands by ET Edge in 2025.


VinFast is a leading car manufacturer in Vietnam, renowned for its electric vehicles, electric scooters, and electric buses. In just three years since its inception, it has ventured into global markets such as North America, Europe, India, and Indonesia, establishing itself as a pioneer in the automotive industry
VinFast was established in 2017 by Vingroup, with its main office located in Hanoi, Vietnam. Within just 21 months of its debut, it became the top car seller in Vietnam, providing a seamless customer experience, design-focused features with exceptional craftsmanship, the highest safety standards, and an intelligent infotainment system tailored for your unique lifestyle. Although the company had been manufacturing electric scooters and buses since 2018, in 2022, VinFast ceased production of combustion engine vehicles to focus solely on electric cars, thus leading the nation’s green energy transition as mandated by the government. With a strong ambition to emerge as a global EV manufacturer, the company is dedicated to offering a comprehensive range of electric vehicles equipped with innovative features. Under the capable leadership of its CEO, Mr.

Pham Nhat Vuong, VinFast is making significant strides with its outstanding models and forward-thinking technology.
VinFast’s electric vehicles are outfitted with the most advanced technologies, including Mobile Home, Mobile Office, Incar Shopping, In-car Entertainment, and online meeting platforms. Furthermore, the cars boast voice-activated windows
and temperature control, assisted driving, and remote parking, along with integrated controllers for smart home devices. Some models even come with a cloudbased digital twin platform, delivering innovative features that improve safety and comfort for customers. These attributes contribute to making VinFast vehicles a highly demanded product in the marketplace.
VinFast has introduced remarkable products, including the VinFast DrgnFly eBike, which features a lightweight and robust frame crafted for ergonomic comfort and agility. Its automotive lineup encompasses the VF6, VF7, VF8, and VF9. The VF6 stands out with a sophisticated design that is seldom found in compact SUVs, offering a spacious and contemporary interior equipped with a 12.9-inch touchscreen display and seamless connectivity. With a strikingly futuristic aesthetic, the compact VF7 integrates dynamic, avant-garde exterior design with a generous, driverfocused, technologically advanced cabin experience, providing the ultimate EV journey. The VF8 incorporates the latest technology and unmatched interior space, seamlessly paired with the breathtaking Pininfarina design, offered in two variants: VF 8 Eco and VF 8 Plus. The VF 9 is optimized for aerodynamic performance efficiency, featuring a distinctive design emphasising human-centric approach, exceptional craftsmanship, cutting-edge technology, and ample interior space.
VinFast is anchored by three fundamental values that help it stand out in a fiercely competitive global market. The first value is the quality of its products, achieved through strong partnerships with top-tier suppliers who provide the most advanced technology throughout the entire value supply chain. The second value is inclusive pricing. The company aims for excellent collaboration with the world’s leading financial institutions to offer financial solutions that cater to the diverse financial capabilities and needs of its customers. Consequently, VinFast products are both accessible and affordable for a wide range of consumers. The third and most crucial value is its exceptional after-sales service. With a warranty that extends to 125,000 miles or up to 10 years, VinFast is setting a new industry standard.

Established in 2009, Career Calling International offers a range of professional services under the knowledgeable direction of its Founder and Executive Director, Mr. Sukh Sandhu. These services include web and IT solutions, language centre, general IT, management and business courses, IELTS/OET preparation training, counseling services, professional life skills and communication training, business process outsourcing, recruitment and management services, executive management education solutions, compliance and quality assurance (CAQA), and immigration services.
As a reliable partner for its clients, Career Calling International empowers them to handle the difficulties of crosscultural business management. It develops a skilled workforce with a global mindset, boosts virtual team performance, trains international assignees, and equips employees to succeed in target markets.
Career Calling International has many competent compliance experts. Every senior member of the group has worked in the training and education industry for more than 20 years. In addition to providing training and assessment materials to thousands of training organisations, its consultants have been providing services to clients since 2000.
Career Calling International upholds unwavering ethical principles. Unless required by law, it refrains from disclosing any client or confidential information without the originator’s explicit written consent. Access to such data is restricted to authorised personnel, who must comply with all relevant privacy laws, regulations, and internal policies. All information, whether verbal, written, or electronic, is treated with utmost discretion. Pricing details and operational expenditures are


A trusted name in global talent development, Career Calling International provides training, education, and consulting solutions. Its mission is to nurture growth, build skills, and create opportunities for individuals and businesses to achieve excellence in today’s competitive, and interconnected world
also considered confidential, regardless of labeling, to maintain trust and protect sensitive business information.
Career Calling International is guided by values such as integrity, respect, excellence, teamwork, innovation, customer focus, diversity, sustainability, and compliance. Even in challenging situations, employees act ethically and treat one another and clients with respect. The company focuses on delivering excellence in every task, while encouraging collaboration, creativity, and continuous improvement. Diversity and inclusivity are celebrated, and every action is centred on meeting client needs. Moreover, the organisation is committed to environmental responsibility and strives to incorporate sustainable practices into its operations. These defining attributes distinguish the company from its peers.
Career Calling International has received numerous prestigious awards for its outstanding contributions to the sector. It was named a winner at the Business Frontier Leadership Conclave & Awards 2025 and the CTODAY Awards 2025, and was among the finalists for the ILP Asia Pacific L&D Team Excellence Award 2024. The company has also been awarded with the Enterprise World Top Training Provider Award for 15 consecutive years, the CXO Time 2024 Award for Outstanding Leadership in Quality Education and Resources, the Executive Perspective Leading Brands and Business Leaders of 2024 Award, the CAQA 15th Anniversary Award for Excellence in Compliance and Risk Management Contributions, the Forttuna Global Excellence Awards, and the Online People’s Choice Awards in 2011, 2012, and 2013, among several others, reflecting its commitment to excellence.

Elpro International School in Pune stands on a legacy of scholastic achievements and well-rounded growth of students. Driven by its commitment to global education standards, the institution has become one of India’s most progressive schools. It is renowned for developing young minds via a future-ready pedagogy
With campuses in Chinchwad and Hinjawadi, Elpro International School offers CBSE, IGCSE, and IB curricula, along with Elpro First Steps Montessori for preschoolers. Over the years, the school has matured into an institution where children develop into confident, compassionate leaders. Under the guidance of its Director Principal, Dr. Amrita Vohra, the institution encourages students to learn 21st century skills, such as thinking critically, innovating, and embracing cultural diversity. Elpro International School has meticulously built an environment that allows students to excel intellectually and emotionally. Its focus on global preparedness and cross-cultural education is evident in partnerships with international schools like Sekolah Kebangsaan Seksyen 13 in Malaysia and Streatham and Clapham High School in the United Kingdom.

Over the past two years, Elpro International School has significantly elevated its brand visibility through a series of high-impact campaigns and signature events. Its five-year legacy of hosting TEDxElproIntlSchool has firmly established the school as a centre of thought leadership and intellectual discourse. Additionally, the Elpro Sports Fest continues to strengthen inter-school camaraderie, while Pangea, the school’s

global cultural exchange platform, connects students across continents.
The school’s digital campaigns, highlighting alumni achievements, board exam toppers, and milestones such as student acceptances into Harvard, have captured the interest of parents, students, alumni, and the wider community. Widely shared on social media, these success stories have significantly amplified the school’s reputation.
The launch of the school’s Hinjawadi campus was another milestone moment, accompanied by a high-impact campaign featuring high-visibility billboards and compelling digital initiatives that strengthened the institution’s local and online presence. Likewise, events like Xpressions, designed for early learners, and national achievements such as wins in the Veer Gatha initiative, a nationwide program by the Ministry of Defence and the Ministry of Education that encourages students to creatively honour the stories of Gallantry Award winners, highlight Elpro International School’s focus on holistic education and inclusive engagement.
The school incorporates sustainability as a core value and teaches students to protect the environment. The campuses use solar power and rainwater harvesting to conserve resources, while studentled eco-clubs champion initiatives like ‘Ek Ped Maa Ke Naam,’ a program under the Department of School Education & Literacy, Ministry of Education, Government of India, to promote tree planting and environmental responsibility.
Besides, waste segregation and upcycling programs engage students and parents and encourage community participation. In line with the UN Sustainable Development Goals, sustainability is integrated into the curriculum through comprehensive climate change awareness sessions.
Elpro International School’s track record highlights its strong academic reputation. It secured the #1 position for Academic Distinction in PCMC by the Times Mirror Survey and received India Today’s award for leadership in CBSE education. Recognised as a “Great Place to Study” by the Global League Institute (UK), the its scholastic standing has gained both national and international recognition.

ince its inception, crcCARE has focused on delivering solutions grounded in strong, defensible science and translating them rapidly into practice. One of its most visible innovations, matCARE™, a clay-based immobilisation technology for contaminants such as PFAS and petroleum hydrocarbons, exemplifies this approach and has been deployed across defence, industrial, and legacy contamination sites to reduce contaminant mobility, manage exposure risk, and support regulatory compliance.
crcCARE’s innovation portfolio extends well beyond matCARE™. The Centre has led the development of scientific frameworks that underpin national policy instruments and technical guidance, providing industry with the confidence to make risk-based, evidence-driven decisions. It has also advanced sensor and monitoring technologies, decision-support systems, and remediation strategies — including passive and nature-based solutions — that reduce energy use, operating costs, and long-term environmental liabilities.
crcCARE is defined by its strong focus on delivering outcomes. An independent economic assessment showed that every dollar invested in crcCARE generated approximately nine dollars in economic benefit. This strong ROI demonstrates crcCARE’s value as a trusted partner for industry, government, and communities.
Knowledge transfer underpins crcCARE’s impact. By working directly with regulators, industry, and practitioners, the Centre translates complex science into applied training and decision-ready tools that strengthen capability in contamination assessment and remediation.
crcCARE partners closely with government agencies, industry, and international organisations to ensure research outputs respond directly to regulatory,


crcCARE, known globally for protecting human health & the environment through world-class contamination assessment, remediation science & policy leadership, was founded in 2005 under the Cooperative Research Centres Program, to bridge the gap between fundamental science & real world environmental challenges practical, scalable impact. Looking ahead, the Centre is expanding its international footprint, with a strong focus on nutrient management, food security, and farm profitability in regions facing climate, resource, and productivity pressures— ensuring environmental protection aligns with economic resilience.
operational, and societal needs. Since 2021, it has operated as an independent, member-driven Centre of Excellence, enabling high-impact research, scienceto-policy translation, and rapid responses to emerging environmental challenges. crcCARE has made substantial contributions to Australia’s environmental policy, including revised national site contamination standards and the National Remediation Framework for consistent, risk-based decision-making.
Sustainability underpins all crcCARE activities, from remediation and resource recovery to environmental management. The Centre’s projects improve soil and water quality, help industry reduce emissions and resource use, and deliver measurable outcomes. By addressing challenges such as lead contamination, degraded soils, and low-impact remediation, crcCARE demonstrates
crcCARE combines research, technology, development, policy engagement, and industry partnerships within one integrated organisation. It goes beyond academic research by rapidly translating scientific findings into practical, costeffective tools and guidance for regulators and industry. Its multidisciplinary teams, spanning predictive modelling, chemistry, engineering, soil science, toxicology, data analytics, and environmental economics, enable the centre to deliver science that is rigorous, relevant, and ready for realworld application.

Jaipur National University (JNU), stands out for its strong academics and committment to social responsibility. Since its inception in October 2007, this NAAC A+ accredited university has evolved into a multi-disciplinary hub, driving innovation, inclusion, and sustainability
With Chancellor Dr. Sandeep Bakshi at the helm, JNU has developed a curriculum that spans undergraduate to postgraduate programs and addresses the demands of the newage global economy. Students can choose from disciplines ranging from engineering and management to law, life sciences, and medical education, gaining industryrelevant skills. Also partnerships with over 500 top recruiters ensure strong placement opportunities across diverse industries, while research and innovation hubs foster curiosity and prepare graduates to be both job-ready and future-ready.
JNU’s global presence grew with the launch of its Ras Al Khaimah (RAK) campus in the UAE. This initiative reflects the university’s vision of imparting world-class education with global foresight while retaining its Indian roots. RAK campus offers state-

of-the-art courses in new-age areas like AI/ML, cybersecurity, and FinTech to address the requirements of the changing global economy. Through a focus on industry-oriented curricula, the institution has developed a niche of being a soughtafter destination for quality education. The university’s brand proposition–”A brand built on trust. Proven by delivery”–resonates deeply with its stakeholders. Additionally, its impactful marketing efforts, including digital campaigns,

print media, and event sponsorships, have enhanced its brand visibility and recall across diverse audiences, thereby reinforcing its reputation as a reliable and performance-driven institution.
JNU follows a holistic approach to education to help students thrive academically, emotionally, and socially. As part of its broader educational vision, the Seedling Group of Schools, under the JNU brand, nurtures young minds with a values-based CBSE-aligned curriculum for emphasising personality development and academic excellence.
Sustainability is part of JNU’s DNA. Situated in the Aravalli hills, the university’s green campus incorporates solar power, rainwater harvesting, and sewage recycling systems to reduce its carbon footprint. Furthermore, its lush campus, equipped with therapeutic gardens, sports facilities, and counselling services, adheres to the World Health Organisation’s Healthy University Model. The university’s committment to sustainability is also evident in its community outreach programmes. It actively empowers rural communities through blood donation drives, free legal aid camps, and agro-training programs. The JNU Hospital and Medical College further complements these efforts by offering super-speciality health care, medical education, and community health programmes. The recent inauguration of the Cancer Centre at JNU Hospital showcases the university’s focus on innovation for the greater good. The adoption of nearby villages and schools by the university promotes inclusiveness and sustainable development. The institution integrates scholarship, global engagement, and a focus on sustainability and inclusivity to prepare students for emerging careers while empowering them to build a better world.
JNU has received numerous prestigious awards. The educational institution also served as a Knowledge Partner for the prestigious IIFA Awards 2025. The University was ranked 2nd in Rajasthan among India’s Top Medical Colleges in 2025. Additionally, the institution received the prestigious ‘Rajasthan Education Excellence Award’ in 2022 and has been ranked as the Best Private University in North India.

While the advisory industry is traditionally dominated by global giants, FAME Advisory has carved out its own space by focusing on what many larger firms overlook: deep personalisation and agility. Clients, especially SMEs and startups, appreciate the handson support and accessibility offered by the organisation. With its expertise and accessibility, the brand has built loyalty and generated strong word-of-mouth referrals. Founded in 2013, it has become synonymous with clarity in complex areas like corporate tax, VAT, AML compliance, and business incorporation. The brand’s strength lies in its personalised service, proactive regulatory monitoring, and a commitment to not just helping clients stay compliant but enabling them to grow with confidence. This promise is backed by quick turnaround times and a proactive approach to changing regulations. It is this consistency and commitment that have earned the organisation a remarkable 90%+ client retention rate, year after year, despite strong industry competition.
Founded and led by Director, Mr. Nirav Dinesh Kumar Shah, FAME Advisory has grown steadily by delivering surefire results. Over the past year alone, the company, under his stellar leadership, has helped over 500 businesses navigate regulatory changes. Most impressively, the leader has helped the brand achieve an impressive client retention rate over the years. FAME Advisory marked significant achievements in the 2023–24 fiscal year by successfully guiding 500+ clients through various regulatory transitions, especially those surrounding the UAE’s evolving tax laws. The company also expanded its services and partnered with top compliance software providers, showing adaptability and foresight.
Over the past two years, the company has made considerable branding/ marketing investments to enhance its


FAME Advisory DMCC, headquartered in Dubai, is one of the UAE’s most trusted business advisory firms, guiding SMEs and corporations through tax, compliance, and regulatory challenges. Known for precision and regional expertise, it delivers proactive solutions that drive long-term growth, resilience, and business success aligning with ESG values and choosing responsible vendors, the organisation is proving that professional services can be both profitable and sustainable.
visibility and recall. From revamping its website to increasing its presence through smart digital marketing, the firm has worked hard to make its voice heard. A growing presence on platforms like LinkedIn and Facebook now keeps clients and industry peers updated with business tips, regulatory alerts, and company news. This digital outreach is complemented by regular newsletters, webinars, and workshops, initiatives that have transformed the organisation into more than just a service provider; it has become a thought leader in its space.
FAME Advisory also places strong emphasis on sustainability. The company is transitioning to a paperless, cloudbased system to reduce its environmental footprint. It supports professional development through regular training and conducts free educational webinars for local entrepreneurs and startups. By
FAME Advisory DMCC has earned significant recognition over the years for its excellence in tax consulting, regulatory advisory, compliance management, and corporate governance solutions in the UAE. Most recently, in 2024, the firm was honoured with the ‘Excellence in Tax Advisory Services Award’ by International Tax Review, acknowledging its pioneering role in guiding organisations through the UAE Corporate Tax and Economic Substance Regulations landscape. In 2023, the firm received the ‘UAE Outstanding VAT & Compliance Consultancy Award’ from a renowned Middle East business council for its consistent contribution to strengthening tax transparency.

Booming Bulls Academy, established in 2019 by visionary investor and educator Mr. Anish Singh Thakur, has emerged as a benchmark of realistic financial education in India. Instead of pandering to “get rich fast” desires, the organisation promotes depth, consistency, and discipline. Headquartered in Noida (Uttar Pradesh), India, the academy addresses the overlooked societal need to bridge the gap between rote academic instruction and practical financial empowerment
In a country where financial literacy has long taken a back seat, Booming Bulls Academy is stepping in to make a real difference. For years, traditional education systems pushed students toward familiar paths, medicine, engineering, and government jobs, while leaving out the essential skills needed to understand and grow personal wealth. Booming Bulls Academy challenges that mindset by offering a hands-on, practical approach focused on real-world results and long-term financial confidence.
Booming Bulls Academy’s journey began in July 2020, a time when global uncertainty caused by the COVID-19 pandemic was at its peak. The academy’s CEO, Mr. Anish Singh Thakur uploaded
a simple video on intraday trading to YouTube; it was not a polished production with scripted lines or slick marketing tactics, but a raw, candid session based on real-time market experience. This authenticity struck a chord with viewers, many of whom were young Indians eager to make sense of the markets amid economic turmoil. The response was swift and overwhelming. Soon, the subscriber count grew exponentially, and Booming Bulls Academy evolved from a solitary channel into a dynamic educational platform. Today, it boasts over 2.6 million YouTube subscribers and has trained more than 35,000 students across the nation. But more importantly, it has built a community characterised by seriousness, discipline, and a hunger for genuine financial literacy.

The financial education sector, particularly in India, has long struggled with credibility issues. From dubious gurus promising instant wealth to vague courses with no structured curriculum, learners have often been left disappointed. Booming Bulls Academy’s growth is remarkable precisely because it challenges this status quo. The brand’s strong digital presence extends well beyond YouTube. With active engagement across Instagram, Facebook, and LinkedIn, the academy speaks directly to India’s youth in a relatable and aspirational tone. Also, the institution serves as a community as well as an academy. Here students are encouraged to exchange ideas, share successes, and support one another through the realities of learning to invest wisely.
Booming Bulls Academy stands out for its methodical approach to trading education. The academy’s mission is to guide young Indians beyond rote learning so that they can take control of their financial futures. By emphasising patience, clarity, and discipline, the academy aims to instil confidence in students as they learn to manage and grow their finances. To that end, it encourages independent thinking, challenges outdated norms, and promotes adaptability in today’s dynamic economic environment. With proper mentorship and a solid philosophy, Booming Bulls Academy demonstrates that anyone can enter the finance arena with confidence and conviction, regardless of their background. It is dedicated to instilling confidence and abilities in young people in India to think independently, trade intelligently, and step away from traditional finance concepts. With markets constantly evolving, the academy continues to lead in innovation and empowerment.
Booming Bulls Academy’s flagship programme, Trading with Data Science, is delivered via a hybrid model that combines online and offline formats. The programme is meticulously structured into two progressive phases. Phase 1 builds a strong foundation by introducing market fundamentals through interactive live sessions, comprehensive revision modules, and direct engagement with Mr. Anish Singh Thakur. Regular assessments ensure students fully grasp concepts like

market behaviour and risk management. Phase 2 explores advanced technical analysis, futures and options strategies, and developing the mental resilience needed for active market participation. Students are taught to skillfully manage risks, maximise profits, mitigate losses, and execute trades with composure under pressure.
While Booming Bulls Academy’s growth as a premier trading academy is undisputed, the company is now entering its most strategic phase yet. In response to shifting market dynamics and learner needs, the academy is pivoting from purely educational offerings to real-market execution services. This transition now involves winding down offline centres, not as a setback, but as a move to sharpen its focus. The company’s ambition is to develop algorithmic trading capabilities, private fund management, and eventually the launch of a proprietary hedge fund. This evolution signals a shift from teaching trading as a skill to executing trading as a scalable business. Yet, despite this transformation, the academy’s core mission is to empower young Indians with the discipline, knowledge, and psychological resilience to navigate financial markets confidently. Behind the academy’s remarkable growth is a highly experienced and ambitious leadership team. Together they oversee a workforce of over 250 professionals spanning operations, content creation, media, and education.
This leadership has also cultivated a culture of innovation. From developing proprietary learning platforms to expanding physical centres, the team ensures Booming Bulls Academy remains agile in a fast-evolving industry. Their ability to merge digital accessibility with in-person engagement has made the academy a model for hybrid education in India.
In the coming years, Booming Bulls Academy seeks to be the go-to institution for financial literacy throughout India. Strategy for additional learning facilities, enhanced online platforms, and expanded course offerings demonstrates a brand well-positioned to make an even greater impact. However, its mission at heart is to enrich lives by providing individuals with the education and self-discipline to define their financial destiny.
Booming Bulls Academy’s groundbreaking contribution towards financial education has been universally acclaimed through several prestigious and high-profile awards. The academy was awarded the Most Trusted Stock Market Learning Platform in India at the highly regarded Atal Achievement Awards in 2022. Additionally, Mr. Anish Singh Thakur was conferred with the Millennium Brilliance Award for his outstanding work in trading education. Furthermore, the academy has been prominently covered in mainstream publications like The Times of India, Hindustan Times, and The Economic Times.


Aparna Kaushik Design Group is a renowned name in luxury architecture and design, renowned for creating some of India’s most refined and elegant estate homes. Founded and led by the talented Ms. Aparna Kaushik, who is both the Founding Principal and Design Director, the group has become a go-to destination for clients looking for bespoke, high-end spaces that are as functional as they are beautiful

eadquartered in Noida, Uttar Pradesh, Aparna Kaushik Design Group offers complete design solutions, from architecture and interiors to landscaping and lighting. The group’s holistic approach ensures that every element of a project, from the grandest structural feature to the minutest finishing detail, is thoughtfully conceived and flawlessly executed. While the brand’s portfolio spans residential, commercial, retail, and hospitality sectors, it is its ultraluxury estate home designs that have become its signature.
the group takes inspiration from classic design principles, reimagined in a modern way. This helps it create timeless styles defined by elegant symmetry, quiet luxury, and a calming, balanced feel.
What really sets the group apart is its fully in-house approach. Everything from design to construction is handled under one roof. Whether it is the layout, lighting, furniture, or finishing touches, every part of the space is carefully curated to create a smooth, cohesive experience.
Under the passionate and hands-on leadership of Ms. Aparna, the group embraces a detail-focused approach. Her involvement extends to every corner of a project, be it sketching a custom chandelier, selecting artisanal materials, or mapping out the layout of a formal garden. Her unique ability to blend intuitive creativity with analytical rigour is key to the group’s success. Like a true leader, Ms. Aparna leverages her extensive experience to lead complex projects with clarity and confidence. By doing so, she ensures that even the most ambitious designs are executed with flawless precision and delivered on schedule. She directs her team to begin every project with a deep and genuine understanding of the client’s personality, lifestyle, and aspirations. This client-centric approach ensures that the spaces crafted are not only visually striking but also thoughtful, liveable, and highly personalised.
Aparna Kaushik Design Group is known for its commitment to clarity, simplicity, and individuality. Instead of chasing trends,
Aparna Kaushik Design Group’s strength lies in creating ultra-luxury residential spaces and stylishly intimate boutiques that feel elegant yet liveable, sophisticated yet personal. Drawing inspiration from diverse periods, including the Belle Époque, Gothic Revival, and Mid-Century Modernism, it integrates historical richness with contemporary relevance. Every material is carefully picked for its aesthetic appeal, performance and longevity, while layouts are designed to ensure seamless flow and practicality. Lighting is also thoughtfully planned to enhance mood and experience. From spatial planning and material selection to ergonomics and fine detailing, the group prioritises functionality in every aspect of design.
From concept development to final handover, Aparna Kaushik Design Group’s in-house team works closely with clients

throughout the entire process. This integrated approach ensures consistency, efficiency, and creative integrity. Whether it’s a sprawling estate, a boutique retail outlet, or a wellness retreat, the group brings the same level of discipline and imagination to every project. The firm’s portfolio spans private residences, commercial spaces, hospitality ventures, and more, each one defined by a distinct character, comfort, and a commitment to quality.
What truly sets Aparna Kaushik Design Group apart is its belief that luxury isn’t defined by size or excess, but by thoughtfulness, quality, and purpose. For the organisation, real luxury means understanding what genuinely matters to the people who will live in the space, and designing in a way that reflects and supports their lifestyle. Every detail, whether it’s a cosy reading nook, a grand staircase, or the perfect lighting for a dining room, is carefully considered. The focus is always on creating spaces that feel intuitive, comfortable and meaningful, blending elegance with everyday functionality in the most seamless way possible.
Aparna Kaushik Design Group skillfully integrates modern innovation with global design trends. Hand-drawn sketches blend seamlessly with detailed digital renderings, and traditional craftsmanship works handin-hand with modern technology. This meticulous balance between innovation and tradition gives each project a distinct character. Guided by Ms. Aparna’s clear and focused vision, the team ensures that every space reflects a consistent and authentic style, one that values meaningful depth over flashy showmanship.
Each luxury residential project by Aparna Kaushik Design Group reflects a calm and clear vision where elegance gracefully meets every day practicality. These creations are beautiful yet comfortable, sophisticated yet welcoming. While many contemporary designers chase the spotlight, Aparna Kaushik Design Group stays grounded, driven by integrity and a timeless sense of style. By listening attentively and responding thoughtfully to each client’s unique needs, the group breathes life into spaces that feel personal, purposeful, and truly reflective of their inhabitants. This dedication to timeless craftsmanship is what has earned this design group a reputation as one of India’s most trusted names in luxury design.
In an era where education is evolving at an unprecedented speed, driven by global connectivity, technological breakthroughs, and the need for new-age skills, Indira University (IU) Pune stands at the forefront of experiential learning, innovation, and holistic development, empowering students to excel professionally, navigate complex challenges, and contribute meaningfully to society - locally and globally.
Established in 2025, the university represents a contemporary vision of
higher education, while remaining firmly grounded in academic rigour, ethics, and enduring institutional values, building on the 31+ year legacy of the Indira Group of Institutions, a leading and respected education ecosystem in India.
Founded under the leadership of Dr. Tarita Shankar, President DesignateIndira University and Chairperson and Chief Mentor- Indira Group of Institutes, the University is committed to delivering high-quality accessible education that goes beyond just academic learning. Dr. Tarita envisions Indira University as a
space where curiosity is encouraged, growth becomes a norm, and innovation remains central to the learning journey..
Recognised with prestigious accolades such as the World Education Congress Awards, World HRD Congress Awards, World CSR Congress Awards, and Dr. Tarita Shankar Awards, the University delivers high-quality education, industryrelevant skills, and a future-ready learning approach.
Indira University offers a wide range of


undergraduate, postgraduate, and doctoral programmes across disciplines such as management, commerce, liberal arts, information technology, and pharmacy, delivered through its five schools in Pune: the School of Business, School of Commerce and Computer Applications, School of Information Technology, School of Liberal Arts, and School of Pharmacy.
At Indira University, the curriculum is thoughtfully designed based on insights from industry experts and corporate
Indira University (IU), Pune, formerly known as the Indira Group of Institutes, is one of India’s most progressive centres of learning, focused on shaping leaders who think critically and act responsibly. Guided by Chairperson and Chief Mentor Dr. Tarita Shankar, the University focuses on holistic development, innovation, and social responsibility, thereby preparing graduates to confidently face the challenges of an evolving world

leaders, ensuring it remains relevant, practical, and aligned with real-world professional expectations. This approach empowers learners to become adaptable professionals, innovative thinkers, and impactful contributors to their fields.
The curriculum includes core courses in sustainability, decoding AI, and Indian Knowledge Systems, complemented by certification partnerships with LinkedIn Learning, Automation Anywhere, Barclays LifeSkills, Kamalberry IT Solutions, EXCELR, Sai Infotech, IKKA EduTech Inspire, and others, enhancing skills and career opportunities.
In today’s interconnected world, businesses and careers no longer operate within borders. Recognising this, Indira University has introduced globally oriented programs that prepare students to thrive in international markets. The Management School now offers the MBA in Global Finance and BBA in International Business with Global Immersion, programs that provide insights into international financial markets, cross-border trade, and global business strategies.
At Indira University, learning is immersive and research-driven and not confined to traditional lectures. The university employs flipped classrooms, case studies, peer-to-peer learning, live projects, and simulations, providing hands-on experience, enhancing problem-solving, critical thinking, and practical application of knowledge. To maintain these high pedagogical standards, the faculty undergoes regular Faculty Development Programs to stay updated with the latest teaching methodologies and industry trends.
At Indira University, students receive learning beyond the classroom through carefully curated exposure trips that connect students with industries, communities, and global perspectives.
The exposure trips are an integral part of holistic education. From visits to leading corporations and research centres to international academic excursions, these experiences provide students with a first-hand understanding of professional environments, emerging technologies, cultural knowledge, and international market dynamics that textbooks alone
cannot offer.
At Indira University, campus life promotes learning, creativity, and personal growth, supported by modern facilities like labs, an auditorium, basketball courts, recording studios, and a gymnasium. Students engage in festivals like the 10day Ganeshotsav, competitions such as IndiaPreneur, and community initiatives like tree plantations, developing leadership skills, and social responsibility. Student Clubs including SheCan, The Groove, The Wild Ones, StageCraft, and The Capture Crew, guided by industry experts, provide platforms for collaboration and holistic growth. The CARE Club, founded by Dr. Tarita Shankar, promotes emotional wellbeing and social impact through initiatives like Mid-Day Meals, Covid Care, and support for children’s and elderly homes.
At Indira University, there is a strong focus on career readiness and employability. The University’s dedicated Placement Cell provides personalised guidance and 100% placement assistance, ensuring every student has access to meaningful professional opportunities. Leveraging long-standing relationships with over 650 recruiters, Indira University facilitates placements across diverse sectors. A comprehensive pre-placement training programme, including aptitude development, skill workshops, mock interviews, group discussions, resume building, and soft skills enhancement, prepares students for the competitive job market.
Swakiyam Centre for Incubation and Innovation at Indira University, led by Chairman Baljit Gujral, nurtures creativity, innovation, and entrepreneurship by providing infrastructure, mentorship, and resources to help founders launch successful ventures. Recently, in partnership with Maratha Entrepreneurs’ Association and guided by Dr. Tarita Shankar, the centre launched a meaningful CSR initiative: the Women Entrepreneurship Program – M-BYBE ((Mindset for Bridging, Yielding, and Building for Excellence), for empowering women entrepreneurs. It also hosts regular industry sessions to inspire students with real-world insights and success stories.

Billabong High International School, Kanpur Cantonment, part of the Lighthouse Learning Group, is a pioneering institution nurturing curious, compassionate, & future-ready learners. Guided by the “Child First” philosophy, the institution combines innovation, technology, and care to create a nurturing environment
As a Microsoft Showcase School , Billabong Kanpur leads in hybrid teaching and learning, integrating cutting-edge digital tools with human-centered pedagogy. This fusion enables students to collaborate, innovate, and think critically — skills essential for thriving in the modern, interconnected world.
Billabong offers parents and learners flexibility through the Cambridge (CIE) and CBSE curricula, complemented by its Kangaroo Kids early years programme. Each pathway is designed to nurture individual aptitude, curiosity, and ambition while aligning with international standards and local educational goals. Through its ongoing academic partnership with Billanook College, Australia, students engage in global

exchanges and collaborative learning experiences that broaden perspectives and strengthen cultural fluency. Set across a 12.5-acre green campus in the heart of the city , the school features state-of-the-art multidisciplinary labs — including Science, Food & Nutrition, Robotics and Design & Technology — where theory meets hands-on exploration. These spaces inspire discovery, creativity, and innovation across disciplines.

Billabong’s philosophy extends beyond academics to foster emotional intelligence, mindfulness, and ethical responsibility. Students are guided to balance intellect with empathy, cultivating resilience, respect, and self-awareness.
The school avidly nurtures and support students academic excellence and relevant super curricular engagements, for their University destinations .The professional College Guidance counselling cell curates individual academic and super-curricular pathways. This structured guidance with curated opportunities at school ensures that every student can navigate their academic future with confidence and clarity. Our Annual TEDxYouth@ BHIS KANPUR platform involves young students to share their ideas that inspire and impact, embodying the school’s spirit of inquiry and leadership.
Billabong High International School, Kanpur Cantonment, has been consistently ranked as the No. 1 International Day School in Kanpur and Uttar Pradesh by the EducationWorld India School Rankings since 2014 till date. The school’s commitment to academic excellence and innovation has also been recognised through several prestigious national and international accolades, including being ranked Uttar Pradesh’s Best International Day School by the C Fore School Rankings 2025, receiving the Vidhya Bharti Award and Rashtriya Vikas Ratan Award from the National Achievers Recognition Forum 2025, and being honoured for Outstanding Practices for Academic Excellence at the World Education Summit Awards 2025. Additional recognitions include the Tech School of the Year at the IDA Education Awards (2018), awards for Best Innovative Practices for Academic Excellence – Digital Learning in 2016 and 2018, the British Council International School Award (2018–21), and the Great Place to Work Certification for the period May 2025 to May 2026. The school has further secured Rank 1 in Uttar Pradesh and Kanpur in the EducationWorld India School Rankings 2024–25, Rank 2 in the 2025–26 rankings, and has been listed among the Top 20 India’s Best NGOs to Work For 2025, reinforcing its standing as a leading institution in education and workplace excellence.

Headquartered in Jaipur, Rajasthan, JK Jajoo Ventures is driven by a clear and unwavering objective — customer delight — ensuring that every business delivers reliability, transparency, and consistent value. The group believes that sustainable growth is achieved not through rapid expansion alone, but by building enduring relationships with customers, partners, and communities.
JK Jajoo Ventures operates through a carefully structured portfolio of subsidiaries that complement its core vision.
KJ Logistics delivers integrated logistics and supply chain solutions focused on efficiency, reliability, and scalability. By supporting infrastructure and industrial clients with optimised transport and distribution networks, the company enables timely execution and operational continuity.
Aretha Facility Management provides comprehensive facility management services for residential, commercial, and institutional developments. With trained manpower, structured processes, and technology-enabled systems, it ensures smooth operations, high hygiene standards, safety, and long-term asset performance.
Shubhashish Wealth Management Consultants offers customised financial advisory and investment planning services, helping individuals and businesses achieve financial stability through disciplined, long-term strategies.
BKJ Airports is a specialised airport ground handling company delivering critical airside and terminal services across India. It currently provides ground handling operations at 17 airports nationwide, supporting both domestic and international airlines. BKJ Airports provides ramp, passenger, baggage, and load handling, plus operational coordination, emphasising safety, compliance, training, and service quality, significantly enhancing India’s


aviation ecosystem.
JK Jajoo Ventures is a diversified Indian business group built on a strong foundation of integrity, trust, and long-term value creation. Operating across real estate, airport ground handling, logistics, facility, and wealth management, it has steadily grown into a prominent multi-sector organisation with a strong presence illiteracy and providing free education to underprivileged children in Rajasthan’s urban slums. What began as a small tinshed school with just 40 students has grown into an initiative that has adopted 21 schools, transforming the lives of over 6,000 children.
Shubhashish Homes, the flagship real estate arm of JK Jajoo Ventures, specialises in luxury residential communities. Known for thoughtful design, premium amenities, and customer-focused planning, its landmark projects—Shubhashish Geeta, Prakash, Marina, and Forest—exemplify quality construction, lifestyle enhancement, and timely delivery, reinforcing the brand’s reputation for excellence in real estate development. With a strong emphasis on security systems, open green spaces, community living, and modern infrastructure, it has earned the trust of discerning homebuyers and continues to set benchmarks for luxury living in Jaipur.
Founded in 2001, Jagriti is the group’s social initiative dedicated to combating
Jagriti empowers children through enrolment drives, better infrastructure, learning resources, and nutritious meals, helping them overcome adversity. Additionally, its Antim Darshnika mobile mortuary service, running for over 13 years, has supported 10,000+ families with dignity, earning recognition in the London World Book of Records.
JK Jajoo Ventures, guided by Founder & Chairman Mr. J.K. Jajoo’s philosophy, prioritises exceptional customer service, ethical leadership, and long-term impact, embedding client satisfaction and integrity at the core of its culture.

BUILDING BRIGHT PATHWAYS OF LEARNING
Bramhapriya World School, situated in Pune, is committed to holistic growth through a wellness-centred approach in education. The institution’s philosophy unites international academic standards with Indian value systems to drive intellectual and emotional development of students
An initiative of the Priyadarshani Group of Schools, which has upheld educational excellence for over 42 years, Bramhapriya World School (BWS) carries forward the vision of its founder, Dr. Rajendra Singh. The school seeks to harmonise international pedagogy with comprehensive learning practices that encourage independence, self-discipline, and reflective thinking. It focuses on developing multifaceted individuals through a balance of academics, creativity, and life skills.
BWS offers an inclusive environment where every student’s potential is valued. Its classrooms stimulate participation, collaboration, and active learning, making education engaging and interactive. The school makes learning fun and practical by taking it beyond the classroom and connecting lessons to real-life and the community.

BWS follows the Cambridge Curriculum along with the Indian Knowledge System. It focuses on conceptual learning, inquiry, and analytical thinking, offering a wide range of subjects in science, humanities, languages, and the arts. This balanced assessment model includes written examinations, coursework, and practical evaluations, ensuring strong academics, while building student confidence.
Simultaneously, the integration of the
Indian Knowledge System connects students to indigenous wisdom in subjects like mathematics, science, and philosophy. This synthesis combines traditional approaches with contemporary methodologies aligned with frameworks of the Ministry of Education, UGC, and AICTE.
BWS provides modern facilities, including spacious tech-enabled classrooms with flexible layouts and a fully air-conditioned auditorium equipped with LED screens, advanced sound systems, and projection facilities for events and performances. The school also offers a library, science and technology labs, indoor and outdoor sports areas, dedicated early-years spaces, a contemporary cafeteria that serves healthy meals, creative zones and student lounges—all designed to support learning, well-being, and community engagement.
The school integrates technology into every aspect of learning. Smart classrooms, digital tools, and collaborative software enhance interactivity and ensure deeper conceptual understanding. The school’s DARC (Drone, AI, Robotics & Coding) initiative introduces learners to emerging technologies through hands-on experimentation. Additionally, dedicated STEAM and coding programmes, supported by labs, encourage design thinking and creativity. These initiatives help students build digital skills, logical thinking, and adaptability for the future.
BWS has a peaceful wellness area with a bamboo dome, lush greenery, and a botanical garden. It encourages mindfulness, connection with nature, and supports eco-friendly living. The school encourages its students to engage in yoga, reflection sessions, and nature-based activities that strengthen physical vitality and mental balance.
Bramhapriya World School has been honoured with accolades including the “Emerging School” award at the Rabindranath Tagore National Awards 2025, as well as the “Emerging School in Cambridge Curriculum” award from Times Education Icon 2025, highlighting the Institution’s accomplishments in the field of education.

Align Staffing Solutions provides a complete range of manpower services, making it a single-source partner for enterprises of all sizes. Its portfolio covers permanent placements, temporary staffing, mass hiring, overseas manpower sourcing, outsourcing services, and professional workforce deployment for complex industrial and infrastructure projects. With an extensive network of international recruitment partners, Align Staffing Solutions sources skilled professionals from key regions in Asia, Africa, and Europe, supporting the UAE’s expanding economy with a diverse and multi-skilled talent pool. The company follows a structured recruitment process that includes screening documentation, medical evaluation, and orientation to ensure seamless workforce integration. Align Staffing Solutions stands out in the industry for its customised and scalable staffing models—ranging from short-term project teams to managing large workforces for ongoing operations. The firm leverages technology-driven recruitment solutions, including advanced software, tracking tools, and automated platforms, to enhance transparency and efficiency. Its adaptable approach helps companies meet changing market needs while reducing turnaround times and improving service quality across industries.
Under the stellar leadership of its Co-founder and CEO, Mr. Atul Sinha, the company has integrated digital recruitment technologies, transparent business practices, and a client-focused approach built on longterm relationships rather than shortterm transactions. Mr. Sinha emphasises compliance, ethical recruitment, and employee welfare, ensuring that both clients and staff feel valued and supported. This balanced philosophy has strengthened firm’s position as not just a manpower provider but a socially responsible organisation within the staffing industry. Under his direction,


Align Staffing Solutions is a Dubai-based manpower company that provides customised workforce solutions across industries. By connecting businesses with the right talent through efficiency, expertise, and a people-first approach, the company enhances productivity and supports sustainable economic growth
the company is expanding into new service verticals, including digital HR solutions and sector-specific outsourcing.
Align Staffing Solutions has strengthened its presence through strategic alliances and an expanding international network. Its global operations provide access to diverse talent pools while maintaining close alignment with local labor regulations, cultural expectations, and market dynamics. This approach ensures that clients benefit from international workforce capabilities delivered with localised service precision. The company’s portfolio includes largescale manpower deployments across infrastructure projects, government programs, and private enterprises. It also offers outsourcing and HR consultancy services, allowing organisations to focus on their core operations while it manages recruitment, deployment, and employee administration. Over the years, Align
Staffing Solutions has expanded its regional presence across the GCC and now employs around 7,500 professionals across 250 locations in the UAE, UK, and Saudi Arabia. Through strategic recruitment partnerships, the company ensures a steady supply of skilled talent to meet the evolving manpower needs of various industries.
Align Staffing Solutions is officially licensed by the UAE Ministry of Human Resources and Emiratisation (MOHRE) and holds ISO 9001:2015 and ISO 14001:2015 certifications, reflecting its commitment to quality management and environmental standards. Over the years, the company has received multiple accolades for its industry excellence, including the Dubai Chamber CSR Label (2019–2022), the Tawteen Gold Membership Award by MOHRE, recognition as a finalist at the Gulf Capital SME Awards 2020, and the UAE Recruitment Excellence Award for workforce solutions.

Brindavan Group of Institutions (BGI), based in Bengaluru, is known for its wide range of undergraduate, postgraduate, and research programs. With over three decades of commitment, it is strengthening academic standards and broadening prospects for students and the community via progressive initiatives
Established in 1993, Brindavan Group of Institutions offers an education model that combined professional relevance with academic depth. Over the years, it has grown to cover multiple disciplines by offering research, undergraduate, and postgraduate programmes in fields such as business administration, engineering, architecture, commerce, aviation, and journalism.
Under the leadership of Dr. Shruti Sharma, CEO of the institution, BGI has attained academic distinction and built a strong reputation for employability and holistic student growth.
DRIVING ACADEMIC EXCELLENCE
Comprising a dynamic network of colleges, the Brindavan Group of Institutions brings together centres of learning that span multiple fields. The group includes Brindavan College, Brindavan College of Engineering, Brindavan Independent

PU College, and Brindavan College of Polytechnic. Established in 2005, Brindavan Independent PU College offers students thoughtfully designed course combinations for their pre- university journey, while the Brindavan College of Engineering–Polytechnic has grown into a trusted destination for technical education. These institutions attract learners from across India and overseas.
Brindavan College of Engineering, established in 2008, is approved by the

All India Council for Technical Education (AICTE), and affiliated with Visvesvaraya Technological University and accredited by NAAC.
With three decades of academic heritage, BGI delivers programs in business administration, commerce, aviation management, logistics and supply chain management, computer applications, and industry-relevant skills.
Set within a purpose-built campus, BGI provides an environment designed to promote focused learning and overall development. Its library serves as a central academic resource, housing 8,954 volumes, 1,870 titles, 63 national journals, 33 international journals, 21 magazines, 8 newspapers, and 441 CDs, along with extensive digital collections.
The campus also supports co-curricular engagement through several student-led clubs — including the Eco Club, Language Club, Oratory Club, and Readers Club — each encouraging participation that complements classroom learning and cultivates diverse interests and skills.
Through partnerships with universities and organisations worldwide, BGI opens doors for students and faculty to learn and grow globally. These collaborations facilitate student-exchange programmes, joint research projects, and international internships. Such global exposure prepares students to excel in diverse professional environments worldwide.
The institution also hosts regular conferences and seminars with experts from different fields, thus creating opportunities to share ideas, learn from real experiences, and broaden perspectives.
BGI’s placement cell takes the same global-minded approach by building strong industry partnerships. Its focuses on connecting what students learn in the classroom with real workplace needs, thus helping them step confidently into careers that match today’s fast-changing industry expectations.
Many MNCs, established companies, and fast-growing startups participate in institute’s campus placements, offering students opportunities across sectors and regions. The success of its alumni, now working in organisations around the world, reflects institute’s consistent commitment to quality education.

An undisputed leader in global education, Global Vision Consultancy has created awareness and opened doors for thousands of students across India. Its reputation is built not just on numbers, but on the genuine care and commitment it brings to each student’s journey. It carefully evaluates each student’s profile before accepting the case and applying for admission. Over the years, it has conducted over 800 seminars, helped create 8,000 success stories, collaborated with 210 universities, facilitated 800 immigration cases, and assisted 1,700 students in pursuing MBBS degrees abroad.
Founded by Mr. Sai Krishna Vejju, Global Vision Consultancy comprises a team of young, skilled, and knowledgeable professionals. They guide students in study abroad options with extensive experience, tailored to each student’s unique profile and needs. Their knowledge of the overseas education industry has helped the company achieve remarkable success.
CUSTOMER-CENTRIC PHILOSOPHY
Global Vision Consultancy places its clients at the core of its services. It offers free consultations to help students and their families make well-informed decisions without any pressure. The consultancy provides cost-effective solutions, ensuring expert guidance is accessible to all. It also assists with university selection, education loans, and scholarship opportunities to make studying abroad more affordable. The team offers expert test coaching, overseas travel guidance, and flight ticket consulting to ensure a smooth transition. Additionally, it offers 24/7 FOREX support to meet students’ foreign currency needs. Trusted by many, the consultancy is committed to providing personalised, comprehensive support throughout the entire study abroad journey.


Global Vision Consultancy, based in Hyderabad, specialises in guiding students to the right courses and universities abroad. Partnering with leading global institutions, the consultancy offers personalised, expert support to help students choose the best educational path for a successful job-ready future
Visa assistance is one of Global Vision Consultancy’s strongest pillars. With a high visa success rate, the consultancy delivers reliable visa advice tailored to each individual’s profile. Its team of experts not only helps students prepare and file their visa applications but also follows up with the authorities until final approval is granted. In addition, they help students determine the best time to travel, arrange flight tickets, and secure travel insurance. With 24/7 forex support, students and their families can manage their currency needs smoothly and efficiently. Global Vision Consultancy also extends its support beyond the visa phase. Understanding that students face numerous uncertainties once they reach their destination, the consultancy offers pre-departure briefings, helps with finding accommodation, and even provides on-ground assistance in foreign countries. Its associates abroad play
a vital role in helping students adjust to new environments, including assistance with finding part-time jobs to support themselves while studying.
In 2025, the consultancy was honoured with the prestigious national award: “Trusted & Outstanding Study Abroad Consultancy Firm of the Year – India 2025” at the India Elite Education & International Excellence Awards & Conference. The award was presented by none other than Padma Shri Dr. Chandrashekar Channapatna Rajannachar, in recognition of the consultancy’s transparent, ethical, and student-focused approach to overseas education. Adding to its growing list of accolades, the consultancy was also honoured with the “Times Business Leaders 2025” award. This prestigious recognition further solidifies its reputation as a leader in the field of overseas education and student empowerment.

REIMAGINING LEARNING FOR A NEW GENERATION
Driven by a vision to reimagine learning, Vasal Education is empowering young minds across India through innovative teaching and holistic development. Its approach blends curiosity, ethics, and critical thinking to build a generation ready to explore the ever-evolving opportunities of the future
Founded by Mr. Sanjeev Vasal, Vasal Education has expanded from a single institution to a network encompassing K–12 and Preschools. Guided by his belief in equal access and experiential learning, it equips students with the skills and confidence to thrive in today’s world.
Vasal Education began as a regional initiative and has gradually matured into a well-structured educational ecosystem known for its focus on teacher development, digital learning integration, and learner well-being. The model shows how strong educational design and leadership can align education with society’s evolving needs.
Vasal Education rests on the belief that learning extends beyond textbooks and examinations; it is an initiation into lifelong inquiry. Since its inception, the institution

has upheld academic distinction alongside emotional and social development. Its schools, vibrant in atmosphere and intent, bring together global educational standards and enduring Indian values. This equilibrium has produced achievers who contribute meaningfully to their communities. With institutions across Punjab and adjoining regions, Vasal Education continues to set new reference points in pedagogy, experiential methods, and learner engagement. Its modern

facilities, digital classrooms, and learnby-doing frameworks encourage students to question, explore, and create, ensuring education nurtures curiosity with purpose. Recently, Vasal Education celebrated two decades of legacy, reaffirming its commitment to student empowerment and educational excellence.
Innovation drives Vasal Education’s growth, as reflected in its curriculum, technology use, and teacher development programs. Each classroom integrates creativity with structured thinking to create engaging learning experiences. The institution prepares students for a globalised world through innovative methods like blended learning, projectbased assessments, and cross-cultural programs. Additionally, teachers engage in ongoing professional development to keep up with the latest teaching methods to help students think independently and apply their knowledge effectively.
Vasal Education emphasises value-based learning and collaborative engagement. The organisation promotes learning that balances intellect and ethics and involves students in social, environmental, and cultural projects to build empathy and civic responsibility. Vasal Education also contributed ₹4.57+ crore in terms of scholarships and discounts to students, reaffirming its dedication to community welfare. The group also prioritises inclusivity and provides equitable opportunities through scholarships, mentorship, and counseling, while nurturing students’ character and intellect.
Vasal Education stays true to its founding principles while adapting to modern learning needs. By focusing on skills and meaningful collaborations, it integrates India’s educational heritage with contemporary practices to prepare students for academic and professional success. Under Mr. Sanjeev Vasal’s leadership, Vasal Education has received numerous prestigious accolades, including the Innovative Pedagogy Award from Education World, the Great Place to Study Award at the House of Commons in the UK, the Red Cross Activity Award, and the Innovation in Education Award from News18, among others.

Founded with a mission to elevate the standards of consultancy beyond templated advice, KSA has grown into a reliable partner for enterprises striving to meet the demands of new-age businesses. The company operates on the belief that every business requires a tailored strategy, not generic advice. By understanding each client’s unique needs and goals, it designs customised solutions aligned with market trends and financial realities, thus helping clients achieve a competitive edge. From forensic audits and financial planning to compliance architecture and corporate restructuring, the firm provides tailored and sophisticated services designed to deliver measurable impact and long-term value. Also, it approaches each client with intellectual discipline and industry insight to offer effective and enduring solutions.
Additionally, KSA’s zero-error culture stands out to clients as a unique strength in the high-stakes advisory arena. The careful scrutiny of every audit, compliance note, and financial model ensures nearperfect precision and solid client trust. Also, the company’s early and agile adoption of emerging technologies sets it apart as a forward-thinking leader in the advisory space. Artificial intelligence, Blockchain integration, and data-driven financial diagnostics are not merely industry trends at KSA but are integral to the firm’s approach to value creation. This proactive use of technology enables the organisation to anticipate regulatory challenges, enhance compliance efficiency, and identify strategic opportunities for its clients.
Apart from client success, KSA promotes a stimulating and empowering workplace culture driven by continuous learning, innovation, and holistic well-being. This vibrant and inclusive environment drives it to deliver superior advisory services with unmatched precision and integrity. By nurturing


Kumar Sunil & Associates (KSA), founded in 1986, is one of India’s most refined business advisory firms driven by financial precision, regulatory clarity, and strategic intelligence. In a marketplace saturated with noise, KSA commands attention through performance, discretion, and results that speak for themselves
talent and encouraging creative problemsolving, the organisation keeps its workforce agile and future-ready; this practice allows the firm to anticipate market fluctuations and address intricate challenges effectively.
Every trusted firm has a leader who inspires confidence and drives excellence. For KSA, that leader is CA Sunil Kumar Aggarwal. With over three decades of experience in financial consulting, Mr. Aggarwal is known for his uncompromising integrity. From banks to hospitals to tech innovators, his stellar leadership has made KSA the go-to advisor for industries where trust is nonnegotiable.
KSA, originally founded in Punjab, has grown into a multi-state financial consulting firm across India and is now ready for global expansion. With a strong team and growing portfolio, the company
aims to enter markets in Southeast Asia, the Middle East, and North America to meet the rising demand for reliable financial consulting amid growing business opportunities and tighter compliance standards. Simultaneously, the company is heavily investing in cybersecurity to ensure digital resilience, thereby positioning itself as a future-ready advisor in an environment where compliance and digital resilience are crucial.
Another defining pillar of KSA’s future strategy is the integration of Environmental, Social, and Governance (ESG) frameworks. This initiative enables clients to embed sustainability and ethical governance deeply into their core operations. This forwardthinking approach helps businesses stay compliant with changing standards while also building strong and socially responsible foundations for the future.

Hosaf Group is one of Bangladesh’s renowned private business conglomerates, known for its remarkable contributions to the nation’s industrial and economic development. From manufacturing and energy to real estate and technology, the group’s success story reflects decades of persistence, innovation, and dedication to national growth and community welfare
Founded under the dynamic leadership of its Chairman, Mr. Moazzam Hossain, Hosaf Group began its journey to build industries that serve people, strengthen infrastructure, and drive sustainable development. The Group has evolved from a small enterprise into a diversified conglomerate with over five business units, each recognised for its operational excellence. The conglomerate thrives in power generation and real estate, driven by integrity, excellence, innovation, and a commitment to progress.
Hosaf Group aims to be among the most respected business institutions
in Bangladesh. With around 500 skilled professionals, it operates across key sectors, including energy, manufacturing, real estate, mining, and education, thus playing a crucial role in Bangladesh’s journey toward sustainable development. Every venture under its umbrella reflects a careful balance of business ambition and social responsibility.
Energyprima Limited, a key subsidiary of Hosaf Group, is a pioneer in private-sector rental power generation in Bangladesh. Established to meet growing energy needs, it leverages advanced technology to supply reliable electricity. Its subsidiary, HF Power Limited, addresses the country’s power shortage by operating an Independent Power Producer Plant


in Noakhali and delivering 113 MW to the national grid and supporting Bangladesh’s vision of universal electricity access.
Likewise, Hosaf Meter Industry plays a crucial role in Bangladesh’s energy sector by producing high-quality electric meters. Established in collaboration with Chinese experts, the company employs state-ofthe-art machinery and skilled engineers to manufacture products known for reliability, precision, and affordability.
Hosaf Group’s real estate arm, Citylink Apartment Limited, focuses on modern, sustainable living and commercial infrastructure, with developments including Hosaf Tower, a 14-storied corporate headquarters and Hosaf Skyline, another 21-storied building which will be the

future corporate office both in Mohakhali; Hosaf Malibagh Complex, a 16-storied commercial and shopping hub with the Hosaf Convention Centre capable of hosting 2,500 guests; and Citylink Apartments, a premium six-storied residential project in Dhanmondi, Dhaka. Each property reflects meticulous attention to detail high-quality construction, and customer comfort.
Additionally, Hosaf Group has been making waves in mining and exploration projects. Hosaf International Limited, established in 1994, operates in coal exploration and development, with the Khalashpir Coal Mine Project in Rangpur exemplifying its contribution to national energy resources. Spanning 25 square kilometres, the project aims to produce millions of tons of coal, supporting electricity generation and economic growth. In collaboration with Chinese experts, the company conducted feasibility studies and plans to produce 1 million tonnes of coal by the fifth year, doubling output by the seventh, while generating 500 MW of electricity to support Bangladesh’s energy independence.
The Hosaf Green Bricks Limited specialises in eco-friendly construction. It produces non-fired concrete bricks, blocks, and tiles. These sustainable products save fertile land, reduce construction costs, and support government initiatives, and effectively meet the growing demand for green and environmentally responsible building materials.
Hosaf Group has also expanded into the food and beverage sector with City Mart
Limited, which runs the popular dining destination At The Table. The venue offers a wide variety of cuisines, a dedicated kids’ zone, and ample parking, thereby providing families and food enthusiasts with a complete and enjoyable leisure experience in the heart of Dhaka.
Hosaf Group actively engages in philanthropic initiatives with a strong focus on education and community development. It has established institutions such as Bokter Munshi Moazzam Hossain High School and Bhor Bazar Belayet Hossain High School in Feni, providing quality education and improved infrastructure for students. The Group also awards scholarships to meritorious students, encouraging academic excellence. In addition, Hosaf Group supports holistic community engagement through extracurricular activities, sports, and cultural initiatives, including sponsorship of the Hosaf President Cup Golf Tournaments, promoting talent, healthy competition, and overall well-being.
A sustainability champion, Hosaf Group is dedicated to achieving sustainable growth through excellence in every product and service it delivers. With a strong focus on creating lasting value, the Group, under the direction of Mr. Moazzam Hossain, ensures that each initiative is aligned with long-term national priorities and global development goals.


Driven by a commitment to energy security, innovation, and sustainable growth, Abu Dhabi National Oil Company (ADNOC) stands at the forefront of the evolving energy industry. Established to support and stabilise the UAE’s economy, ADNOC has emerged as one of the world’s most influential energy companies
ADNOC is born out of the founder Sheikh Zayed bin Sultan Al Nahyan’s vision of leveraging the country’s natural resources for the betterment of society and for future sustenance in terms of economic prosperity. Over the years, ADNOC has grown into an integrated energy giant in every segment of the downstream and upstream business in the hydrocarbon industry. Presently, it has an entire series of subsidiaries that include businesses in exploring, producing, refining, petrochemicals, transportation, logistics, and low-carbon energy solutions and remains an ally for over 50 counties in the world.
One of the defining qualities of ADNOC is its passion for innovation. It has taken the digital transformation of its business to unprecedented levels, incorporating artificial intelligence tools and intelligent

technologies in its business processes. Its Digital Command Center is an epitome of efficiency in monitoring and making decisions on the entire value chain of its business. Future-proofing has not only optimised efficiency for the business, it has also ensured that it is in sync internationally on sustainability issues. Its full downstream expansion, in partnership with world-class companies and an aggressive industrialisation strategy, has consolidated its role as an important world-
scale supplier of product, petrochemicals, and industrial solutions. In addition, the creation of one of the world’s largest integrated refining and petrochemicals’ centers at Ruwais Industrial City signifies its dedication to innovation-driven national development.
Sustainability is at the very core identity and values of ADNOC. From inception, the corporation has always known the need for protecting natural resources this comes from Sheikh Zayed’s views of environmental harmony and sustainable development. Now, this is what ADNOC has committed itself to, in keeping with this vision of the past, in taking proactive steps on climate change and in developing low-carbon energy sources.
ADNOC is propelling the UAE’s Net Zero by 2050 Strategic Initiative in carbon capture and storage, scalable hydrogen development, and low-carbon intensive facilities upgrades. Its reliance on gridbased, zero-carbon power in onshore business and its lowest-in-the-world lowcarbon intensive oil supply proves ADNOC’s commitment to having a sustainable and resilient energy sector.
Another aspect of importance is the strong commitment that exists in ADNOC in relation to the concept of “Corporate Social Responsibility”. The organisation undertakes comprehensive programs that are aimed at community development in relation to areas such as education, youth programs, health, sports, road safety, and preserving cultures. In this way, the different programs that are initiated by ADNOC aim at contributing to society in every aspect, and this goes beyond the energy sector that it deals in.
The success of ADNOC has also received international acclaim. It has been ranked in the Top 10 Most Valuable Oil & Gas Brands globally on several occasions and has won awards in relation to sustainability, excellence, digital transformation, and work environments.
Its innovative carbon capture programs and environmental leadership efforts have received awards and accolades from prominent international energy and climate-related associations. ADNOC has also been recognised for its superior health, safety, and environmental performance, social investment programs, and role in supporting UAE’s national development.
As a fully licensed recruitment consultancy, S K Overseas adheres to the legal and professional standards required in the UAE and India. The company, led by Managing Director Ms. Sumitra Khanda, has gained the confidence of numerous clients by delivering consistent results while maintaining complete transparency throughout the hiring process. Its understanding of regional labour laws and employment regulations ensures smooth and compliant operations, which make it a reliable partner for businesses looking to hire responsibly and efficiently.
Over time, the consultancy has delivered consistent results in sectors such as oil and gas, marine, construction, and healthcare. It has conducted focused interview drives in key cities across India and the Gulf region, focusing on both skilled and semi-skilled professionals. These efforts have not only helped companies fill critical roles quickly but have also demonstrated the brand’s ability to manage recruitment at scale without compromising on quality.
With its expansive network and solid presence across Chennai, Vadodara, and several other regions, including Uttar Pradesh, Bihar, Odisha, Andhra Pradesh, Telangana, Maharashtra, and Gujarat, the organisation offers unparalleled reach into India’s vast talent pool. This enables the company to quickly meet client’s hiring needs with skilled, jobready candidates. By combining local knowledge with global reach, it offers a smooth and efficient recruitment process.
The company’s ability to manage the entire recruitment process from start to finish makes the organisation stand out in the crowded HR consultancy market. S K Overseas handles every step - from sourcing and interviewing candidates


to managing documentation, visa processing, and final mobilization. The integrated solution supports the clients to focus solely on running their business while S K Overseas takes care of building their workforce.
Over the years, S K Overseas has taken deliberate steps to grow its brand visibility and improve client engagement. The company has completely redesigned its website to make the platform more informative and user-friendly so that clients and candidates can easily navigate available services and job opportunities. It has also built a robust presence on Instagram to engage and inform a broader audience. Simultaneously, citybased interview drives across India and the GCC have helped boost the brand’s visibility in key talent hubs.
The expansion of S K Overseas’ operations into new cities and regions has given it
S K Overseas HR Consultancy is a licensed recruitment firm operating in India and the UAE. Known for its ethical practices, fast hiring processes, and end-to-end manpower solutions, the company specialises in connecting skilled professionals with leading semi-government and private sector organisations access to a broader and more diverse candidate base. Whether it is white-collar professionals or blue-collar workers, the organisation ensures every placement is aligned with employers’ requirements and candidates’ capabilities. Its successful recruitment drives have led to the swift placement of professionals in sectors where precision and expertise are considered highly critical. Client relationships have been strengthened through consistent, high-quality service delivery, resulting in a high rate of repeat business. Additionally, online and offline marketing efforts have enhanced brand recall and positioned the company as a serious player in the HR consultancy field. Clients and candidates alike see S K Overseas as a trustworthy recruitment partner. Employers value the company’s responsiveness and ability to provide tailored staffing solutions. Likewise, candidates appreciate its supportive recruitment process.

Driven by the vision to lead Indonesia’s transition toward a cleaner future, Barito Renewables stands as a pioneering force in sustainable energy. By harnessing geothermal and renewable resources, it is reshaping the nation’s energy landscape while creating long-term value for communities and the environment
Barito Renewables has grown significantly over the years. Today, it is one of Indonesia’s leading clean energy companies with a strong focus on supporting the country’s drive towards net-zero emissions. As the Barito Pacific Group’s renewables energy business, the company brings a powerful combination of industrial strength and environmental responsibility. Built on innovation and operational excellence, its core values and commitment to sustainability drive its growth across geothermal, wind, and other renewable sectors.
DRIVEN
Barito Renewables is a reflection of the Barito Pacific Group which was established by visionary Prajogo Pangestu whose business acumen built a diversified business empire closely tied to Indonesia’s development. As the

group’s renewable energy arm, Barito Renewables continues this legacy by focusing on growth with environmental responsibility.
As the majority shareholder of Star Energy Geothermal Group, the largest geothermal producer in Indonesia, Barito Renewables plays a key role in delivering sustainable power to millions of homes. The company also leads Indonesia’s clean energy sector through focussed initiatives in Wayang Windu, Salak, and Darajat,

ensuring the country’s renewable energy pool remains reliable and sustainable. Its long-term vision focuses on expanding greenfield developments and acquisitions, including the Sidrap Wind Power Plant in South Sulawesi.
The company is also committed to operational integrity and excellence. It designs every project with environmental responsibility in mind. By combining advanced technology with prudent financial investment, Barito Renewables delivers energy solutions that benefit both business and the environment.
Driven by the philosophy “Make Tomorrow Brighter,” Barito Renewables integrates environmental and social considerations into every aspect of its operations. From energy generation to community development, it works to minimise carbon emissions, protect biodiversity, and improve local livelihoods, aligning with global ESG principles and the United Nations Sustainable Development Goals. Assessing success by social and planetary impact, the company leads Indonesia’s clean energy movement by stopping millions of tonnes of CO₂ annually through geothermal projects.
Barito Renewables actively supports education, human development, and environmental conservation across Indonesia through the Bakti Barito Foundation. Its community initiatives focus on skill development, local employment, and infrastructure support near project sites. By engaging with stakeholders, understanding local needs, and creating shared value, the company ensures its growth benefits communities inclusively. Actions like reforestation and safeguarding natural resources support the organisation’s long-term sustainability goals.
Barito Renewables and its subsidiary Star Energy Geothermal have been honoured with several prestigious awards for their commitment to environmental and sustainable operations in Indonesia. The most notable ones are Gold and Green PROPER Awards conferred upon Star Energy Geothermal by the Ministry of Environment and Forestry for energy efficiency strategies and developmental processes. It was also felicitated with the Best Renewable Company 2021 Award by CNBC Indonesia 2021.

maar, through the years, has grown into one of the most influential development groups with operations across the UAE, Egypt, India, and other international markets. Its portfolio spans premium residences, retail centres, integrated townships, hospitality assets, and entertainment venues. Focused on comfort, culture, sustainability, and community, Emaar is celebrated for its distinctive design, quality construction, and creating aspirational, well-planned urban environments.
Emaar’s sustainability strategy, guided by an advanced ESG framework, emphasises eco-friendly construction, energy efficiency, and responsible resource use. Smart energy systems, efficient cooling, retrofit programs, and structured waste segregation collectively reduce emissions, promote sustainable urban development, and minimise landfill contributions.
Water management is a key focus for Emaar. Some projects use district cooling powered by treated seawater to reduce demand for fresh water. Landscaping uses native plants and smart irrigation, while newer homes feature better insulation, solar elements, and high-performance façades.
The company has earned regional recognition for its sustainability performance in building operations and facilities management, highlighting its mission to develop enduring cities, regenerative environments, and resilient communities.
Emaar Foundation, the company’s philanthropic arm, supports education, health, inclusion, and social welfare. It funds broad learning initiatives, aids humanitarian efforts addressing hunger, and raises awareness of mental health and neurodiversity through community outreach. The foundation also provides


scholarships, skills training, and cultural programmes that build social cohesion. It responds swiftly in times of crisis, repairing storm-damaged homes and delivering essential support to vulnerable families.
Emaar, founded in 1997 and headquartered in Dubai, is a global developer renowned for creating integrated urban communities. Its high-quality residential, commercial, and leisure projects have earned international recognition for designing coherent, large-scale environments that redefine modern urban living service standards, and architectural accomplishments have placed it among the world’s most respected developers. In 2024, the Burj Khalifa secured LEED Platinum (v4.1) certification under the Operation and Maintenance category, demonstrating its environmental performance. That same year, Reel Cinemas at Dubai Mall was recognised as a Certified Autism Centre by IBCCES, Emaar Development was also named Developer of the Year at the Arabian Business Achievement Awards for its leadership and originality.
International subsidiaries further extend this impact. In Egypt, Emaar Misr has rebuilt houses, supported vocational training for young people, and contributed to public services in disadvantaged areas. In India, its projects incorporate wastewater recycling, rainwater harvesting, and green mobility infrastructure. These efforts portray a developer that values empathy, listens to its residents, and views progress as a shared outcome.
Emaar Properties has received multiple recognitions for its forward-thinking design, and community-focused living. Its environmental achievements,
Additional honours arrived in 2023. Recognition for Dubai Hills Park’s sustainability at the Middle East Design Awards and KidZania’s leading edutainment experience at MENALAC further highlights Emaar Properties’ integrated focus on environmental care, community value, and quality leisure, shaping a superior standard of modern living.

Ageas Federal Life Insurance is a leading private life insurer in India, recognised for its customer-first philosophy and strong institutional backing. Established in 2008, it operates as a joint venture between Ageas, a European insurance leader, and Federal Bank, a trusted Indian private bank partner
From its inception, Ageas Federal Life Insurance has been focused on financial discipline and innovation.
The company reached breakeven within five years. This milestone reflects careful planning and effective management and marks an important step in its growth journey. Backed by a nationwide network, the insurer has established a strong presence in urban, semi-urban, and rural areas.
This wide presence has enabled the company to understand varied customer needs and respond with suitable life insurance offerings. The emphasis has always been on long-term value creation rather than short-term gains, which has helped establish trust among policyholders and partners alike.
Ageas Federal Life Insurance offers a comprehensive range of solutions

spanning protection, wealth management and retirement planning. These products cater to individuals, families and corporate clients, and address life stages and financial goals with clarity and simplicity.
As of March 31, 2025, the company had issued more than 19.71 lakh policies, with a sum assured exceeding ₹1,87,425 crore. Its assets under management stood at over ₹18,956 crore, supported by a capital base of more than ₹800 crore. The claim settlement ratio of 98.52 per cent highlights

the insurer’s commitment to honouring promises and ensuring timely support to customers during critical moments.
Under the leadership of its Managing Director and CEO - Mr. Jude Gomes, Ageas Federal Life Insurance has sharpened its focus on customer-centric innovation, operational efficiency and meaningful partnerships. The leadership team has prioritised digital enablement, process improvement and transparent communication to enhance customer experience.
In line with its commitment to financial inclusion, the company has entered partnerships with organisations such as Muthoot Microfin, CSB Bank, Vakrangee and Jio Credit. These associations aim to extend insurance access to underserved regions and communities. Additionally, the collaboration with CIMSME reflects the company’s intent to support Indian MSMEs through insurance solutions aligned to their business realities.
The strength of Ageas Federal Life Insurance lies in the credibility of its promoters Ageas Group and Federal Bank. Ageas Group brings with it over 200 years of insurance expertise and operates across 14 countries in Europe and Asia. It is the number one insurer in Belgium and a leading player in several other markets, offering life and non-life solutions to millions of customers.
On the other hand, Federal Bank contributes deep-rooted trust built over decades in Indian banking. With a strong presence in Kerala and a national network of over 1,300 branches and 1,800 ATMs, the bank adds stability, local insight and customer confidence to the joint venture.
Ageas Federal Life Insurance has also earned recognition as an employer of choice. The company has been named among India’s Top 3 Best Workplaces in the Insurance sector by Great Place to Work. It has also been featured among India’s Best Workplaces in BFSI – Top 25, reflecting its people-centric culture, inclusive practices and focus on employee well-being. These awards demonstrate the organisation’s belief that a motivated workforce is crucial to delivering consistent value to customers.

Founded by the late Mr. Ng Teng Fong, Far East Organization started as a small housing development in Serangoon Gardens and has grown into one of the largest real estate groups in Asia. Today, it delivers thousands of projects and serves customers across residential, hospitality, commercial, industrial, healthcare, and food and beverage segments. Its portfolio includes wellknown Singapore landmarks such as Orchard Central, Far East Plaza, Oasia Hotel Downtown, and One Holland Village. The listed subsidiaries, Far East Orchard, Far East Hospitality Trust, and Yeo Hiap Seng, represent a widening regional presence across Singapore, Australia, and other international cities.
Far East Organization has grown through continuous improvement and customer-focused design. It prioritises long-term value over short-term gain. The brand has introduced mixed-use developments, renowned hospitality brands, and enhanced experiential retail and integrated living, setting elevated standards for Singapore’s urban and lifestyle landscape.
Far East Hospitality, the group’s hospitality arm, manages an expanding portfolio of hotels and serviced apartments across APAC and Europe, delivering lifestyle-focused solutions with practical operations. By investing in technology, engineering, and functional design, and following measured expansion rooted in its founding principles, the group ensures its developments remain relevant, adaptable, and capable of evolving successfully across decades.
Far East Organization emphasises community upliftment. Its Gift of Space program repurposes empty building


Far East Organization is known as Singapore’s largest private property developer. Since 1960, the company has combined business discipline with long-standing Christian values, creating environments that strengthen enterprise, hospitality, and community life across several regions
spaces into free-use hubs for non-profits and social enterprises. Employment pathways are created through Agape Services for individuals overcoming life’s challenges by offering training and placement in meaningful work. The group also supports social service agencies, religious initiatives, education-related charities, and healthcare programs in line with its philosophy of responsible stewardship.
Environmental care also shapes its corporate direction through the use of sustainable materials, energy-conscious practices, and green infrastructure. Oasia Hotel Downtown, known for its living façade, stands as an example of climate-aware architecture that blends biophilic elements with urban hospitality. Several of its developments hold Green Mark certifications, and the company has been acknowledged under the LowCarbonSG program for measurable progress in carbon reduction. By blending
nature, wellness, and efficiency, it enhances conversations on urban sustainability in Singapore and globally.
Far East Organization has earned international awards for its contributions to the built environment. It has won multiple FIABCI World Prix d’Excellence Awards for functional, architectural quality, and distinguished projects. Its digital innovations, including the Central Engineering Management System and tenant engagement apps, have been honoured with SBR Technology Excellence Awards. One of its forwardleaning initiatives is Chef X, a culinary residency that offers mentorship and kitchen space to emerging chefs without rental obligations. This program won the Social Innovation of the Year Award in Singapore in 2025, illustrating how the organisation combines business insight with community uplift.

Headquartered in Singapore, DBS Bank is one of Asia’s most respected financial services institutions, with operations across 19 markets. Known for its digital excellence and customer trust, the bank leverages advanced technology with the purpose of creating value for individuals, businesses, and communities
Established in 1968 by the Government of Singapore to take over the industrial financing activities of the Economic Development Board, DBS began as The Development Bank of Singapore, focused on national progress. Over time, it evolved into a globally admired financial group known for providing a comprehensive suite of services that include retail banking, SME and corporate banking, wealth management, and investment banking. With over 36,000 employees and a strong presence in India, Indonesia, China and Hong Kong, DBS is redefining Asia’s financial landscape while positively impacting the lives of millions.
DBS has long been recognised for its technology-led approach to modern banking. It was among the first institutions to embrace a paperless, branchless model

through the launch of DBS digibank, an AI-enabled and secure digital platform. The app simplifies the banking experience by eliminating physical documentation, giving customers complete control through their mobile devices.
The bank leverages predictive analytics to anticipate customer needs while its machine-learning systems ensure fraud prevention and security. Through open banking products and API integrations, DBS enables businesses and start-ups

to access efficient financial solutions, besides promoting collaboration and transparency. Its operations rest on the principles of trust, innovation, and accountability. These values, combined with rigorous ethical standards, have earned DBS a global reputation for its transparency and forward-thinking financial management.
DBS believes that true banking success lies in contributing positively to society and the environment. Its sustainability framework is built around three pillars: responsible banking, business practice, and social impact. The bank integrates strong ESG (Environmental, Social, and Governance) practices across its operations to generate lasting value. Through the DBS Foundation, more than 800 social enterprises across Asia receive funding and mentorship to address challenges such as climate change, financial inclusion, and employment creation. DBS supports initiatives ranging from women-led microenterprises in India to climate adaptation projects in Southeast Asia. In 2023, it launched the Live More, Carbon Less campaign to promote sustainable lifestyles among its customers and employees.
Additionally, the bank has mobilised substantial capital through green bonds and sustainability-linked loans, thus reinforcing its pledge to achieve net-zero operational carbon emissions by 2050. By improving Digital efficiency to save paper and energy, DBS has earned recognition from Global Finance and the Dow Jones Sustainability Index for sustainable banking leadership.
DBS has consistently been acknowledged for excellence, customer trust, and responsible leadership. It was named World’s Best Bank by Euromoney in 2024, 2022, 2021, and 2019, and by Global Finance from 2020 to 2023. The Banker also honoured it as Best Bank in the World in 2018, while Global Finance rated it among the World’s 10 Safest Commercial Banks. These awards reflect DBS’s commitment to innovation, integrity, and sustainability. Over the years, the bank has strengthened its reputation as a trustworthy institution for managing wealth responsibly and supporting a resilient and more inclusive global economy.
The Amin Mohammad Group (AMG) started its journey under the visionary leadership of its Founding Chairman M.M. Enamul Haque, whose steadfast commitment to righteous growth and nation-building has cemented the organisation’s legacy of resilience. He led the company to set new standards in Bangladesh’s real estate industry through architectural brilliance coupled with social responsibility.
Building on this strong foundation, Md. Ramzanul Haque Nihad, the Managing Director, has brought a contemporary perspective and forward-thinking approach, resulting in AMG’s fast-paced growth and diversification. The group now maintains a strong foothold in a competitive marketplace while adhering to its founding principles. AMG runs its business under three flagship companies: Amin Mohammad Foundation Limited (AMFL), Amin Mohammad Land Development Limited, and Amin Mohammad Engineering and Construction Limited. Together, these firms have delivered some of the most iconic residential and commercial projects in Dhaka and beyond. Its landmark projects, such as Amin Mohammad City and Green Model Town, have revolutionised the concept of urban living through the promotion of sustainable living, comfort, and modern living solutions. Each project embodies the company’s aim to deliver quality, safe, attractive, and environment-friendly homes to people from all walks of life.
AMG has transformed into a versatile corporate with interests in finance, construction, media, hospitality, education and agriculture. This diversification enabled it to deepen its value addition to the socioeconomic development of Bangladesh and carve out a reliable name in different sectors. The group’s construction division has delivered large-scale government and private infrastructure projects. Meanwhile, Amin Mohammad Foundation Limited


Dedicated to quality and innovation, Amin Mohammad Group (AMG) has emerged as one of the most reliable and diversified business houses in Bangladesh. The group has made a defining impact on the nation’s urban infrastructure and real estate sector while diversifying across industries over the years
(AMFL), the welfare and development arm of the group, continues to stand true to AMG’s humanitarian vision. It is making a difference in people’s lives and inclusive growth by positively contributing to education, healthcare, housing and community services. With the future-focused leadership of its management, AMG has realised that it can successfully achieve both profit and purpose and translate its business success into social impact.
AMG now plans to grow its footprint in Bangladesh and overseas through eco-friendly developments and wellresearched urban infrastructure solutions. It is also consolidating its real estate and construction business while exploring new and innovative ventures in renewable energy, technology, and international cooperation.
Quality, innovation and sustainability are the pillars of AMG’s operations. Each
project is carried out with a meticulous eye for design, safety, and long-term effects on the environment. The company’s engineers and architects embrace worldwide best practices and technology and meet the highest standards of durability and visual appeal.
AMG has been honoured with several prestigious accolades. In 2024, the group was recognised as a leader in sustainable real estate. It was featured in the Luxury Lifestyle Awards report titled “TOP 100 Sustainable Real Estate Companies,” highlighting its commitment to eco-friendly development practices. It also received the Most Improved Company Award from the Aviation Dhaka Consortium. Additionally, AMFL was honoured with the 7th GYPROC Trophy for High-Rise Construction Excellence, reflecting the group’s dedication to quality and innovation across its ventures.


Established in 1960 in Kuala Lumpur, Maybank is one of Southeast Asia’s leading financial services groups known for its regional footprint and customer-centric banking solutions. Its presence across the globe and good governance, with a community focus, make it a model for modern banking
Over the decades, Maybank has transformed from a modest Malaysian lender into a universal financial hub that offers retail, corporate, investment, and Islamic banking, alongside asset management and insurance solutions. With over 2,000 branches across ASEAN, Greater China, the Middle East, the UK, and the US, the bank is advancing its vision of an inclusive financial ecosystem. Additionally, strong leadership and innovation position it as the region’s largest bank by market capitalisation and assets.
Maybank promotes a people-first culture and is committed to social responsibility. Through the Maybank Foundation, the group leads highly effective initiatives within ASEAN, including the flagship R.I.S.E. programme for empowering persons with disabilities through

structured entrepreneurship training, mentorship, and financial literacy. The initiative has boosted economic independence and has earned top honours, including the JCI Malaysia Sustainable Development Awards.
Maybank actively promotes education and financial literacy, with its Cashville Kidz programme helping over 500,000 students learn essential money management skills. This initiative has earned recognition at the Global CSR
Summit & Awards. The organisation also supports volunteerism through the Maybank Global Corporate Responsibility Day, where employees contribute millions of service hours annually across causes related to education, environment, welfare, and community resilience.
Maybank promotes sustainable business practices across ASEAN, focusing on renewable energy, green buildings, energy efficiency, and sustainable supply chains. Through its Sustainable Product Framework, it aims to mobilise RM80 billion in sustainable finance by 2025 and achieve net-zero carbon emissions by 2050.
The company has introduced greener options such as the myimpact Credit Card, which allows cardholders to monitor their carbon footprints from transactions and make greener choices. Maybank also supports biodiversity conservation. It follows a decarbonisation roadmap and practices transparent emissions reporting, reflecting a holistic approach to sustainability.
Maybank’s journey reflects adaptability, strategic vision, and purpose. Its transformation programmes, M25 and M25+, drive digital adoption, enhance customer experience, and promote sustainable financing. The bank has diversified into digital banking, SME support, wealth management, and regional trade. Maybank Investment Bank ranks among top advisors and underwriters, while Maybank Islamic offers globally recognised Shariahcompliant financial solutions, reinforcing the Group’s comprehensive and innovative approach to banking.
Multiple accolades have been bestowed on Maybank’s green and inclusive banking leadership. The bank bagged three awards at the 2024 Euromoney Awards: Best Bank in Malaysia, Best Digital Bank and Best International Bank in Cambodia. At the ESG Business Awards 2025, Maybank emerged as the winner of the Net-Zero Award for Banking and the Wildlife Protection Award for its contributions to tiger-protection. Recently, it won four prizes in the Global Finance Sustainable Finance Awards: Best Bank for Sustainable Finance in Emerging Markets and Best Bank for Sustainability Transparency in Asia Pacific, among others.

arma Developers, established in 2013, was born from a shared vision to democratise luxury living. Under the stewardship of its forwardthinking founder, Mr. Navneet Mandhani, recently ranked as the No. 2 real estate leader by Arabian Business Review, Karma Developers has achieved unprecedented success over the years.
Karma Developers is a dedicated real estate development company, strengthened by the founders’ global entrepreneurial experience across technology, trading, shipping, and investment. This diversity of expertise informs Karma’s forward-thinking approach and brings a broader, more strategic worldview to every development.
With operations spanning 7+ countries, Karma Developers brings together a global outlook with local expertise. Over the last decade, the group has delivered over 25 high-impact projects across the UAE, UK, Cyprus, Romania, and strategic investments in Australia. This international reach, coupled with over 75 years of combined leadership experience, allows Karma Developers to develop properties that offer luxury, functionality, as well as design excellence.
Karma Developers stands out in Dubai’s real estate landscape with a development pipeline exceeding 5 million sq. ft. across some of the city’s most sought-after communities. Its portfolio spans luxury residences, modern workplaces, and lifestyle-driven communities defined by thoughtful design and long-term value.
Among its notable developments is Olivia Residences in Dubai Investment Park, a contemporary residential complex overlooking the Green Community Park. Complementing it are Trinity in Arjan, Milos in Dubailand, and the recently launched Antalya in Dubai Sports City—each reflecting Karma’s commitment to refined living, functional elegance, and sustainability. Karma Developers is also building gated community developments in partnership within Dubai Silicon Oasis and Falcon City, reinforcing its position as a forward-thinking


Karma Developers has earned a top spot in Dubai’s real estate market. With honesty, integrity, and quality at its core, the company builds meaningful client relationships, turning every transaction into a genuine friendship and ensuring customers feel valued and confident long after their purchase
developer shaping new urban experiences across the city.
Investors find Karma Developers a reliable choice because of its extensive experience in handling varied client needs with a personal, attentive approach. The company ensures transparency by setting clear terms, provides plenty of options, and sticks to high professional standards, which make it a goto for real estate deals. Whether buying a home or funding a commercial spot, clients are provided with guidance tailored to their specific situation.
Karma Developers is committed to social responsibility. Its recent partnership with the Dubai Autism Center demonstrates the company’s commitment to creating real positive change and building communities that matter. Through this ongoing collaboration, the company actively
promotes inclusivity, supports community health programs, and engages in initiatives that benefit both individuals and families. Additionally, every project by Karma Developers aims for LEED certification by prioritising quality and sustainability, striving to create environments where eco-friendly living and social responsibility work together smoothly.
GLORIOUS
Recognised for consistent performance and strong client trust, Karma Developers’ Antalya project earned two major industry awards in 2025. It won Best Affordable Luxury Project at the Construction Innovation Awards by BNC Publishing and Best Off-Plan Project at the Construction Middle East Awards by ITP Group. These honours underscore Karma Developers’ commitment to quality, innovation, and the creation of value-driven communities that inspire buyer confidence across international markets.


Founded in 1985 and headquartered in Mumbai, Kotak Mahindra Bank is among India’s largest private sector institutions. With a broad suite of financial offerings and a focus on customer needs, the organisation has earned a dependable reputation within the country’s banking system
Kotak Mahindra Bank’s journey began as Kotak Mahindra Finance Limited and reached a defining moment in 2003 when it became India’s first non-banking finance company to convert into a bank. Across nearly four decades, Kotak Mahindra Bank has developed an extensive ecosystem serving over 40 million customers. Its network of over nineteen hundred branches and more than thirtysix hundred ATMs reflects an ongoing effort to deliver accessible, technologyenabled banking nationwide. This growth, combined with consistent service quality, has positioned Kotak as a trusted advisor for individuals and businesses.
Kotak Mahindra Bank has enhanced its digital capabilities to provide faster and more convenient services. With products like Kotak 811, a zero-balance digital

savings account, users can open accounts within minutes, while its mobile apps, AI tools, and unified digital platforms simplify financial transactions for customers across locations.
The bank also invests heavily in data analytics and cybersecurity to ensure secure and efficient service delivery. Its outreach extends to micro-finance, affordable housing solutions, and rural programmes, enabling wider sections of society to access dependable financial
tools.
Kotak Mahindra Bank works on the foundation of transparency, careful risk assessment, and ethical conduct. Its guiding line, “Let’s make money simple,” conveys an intention to ease financial decision-making for customers. The internal culture encourages accountability, teamwork, and purposeful leadership at every level.
The organisation has been recognised for performance across diverse fronts. It has received titles such as “Best Domestic Bank “from Asiamoney, “Best Company to Work For” by Business Today, and “Best Digital Bank” from Global Finance Magazine. These awards highlight the Bank’s operational standards, service quality, and progressive workplace initiatives.
Kotak Mahindra Bank maintains stability despite market fluctuations. Its emphasis on measured growth and thorough risk management supports a strong balance sheet and sound capital adequacy, attributes that reinforce the confidence of investors and customers.
Kotak Mahindra Bank is highly active in social development. Through the Kotak Education Foundation, it works with under-resourced communities by providing access to schooling and vocational training. During the COVID-19 crisis, Kotak Mahindra Bank and its group entities contributed fifty crore rupees to the PM CARES Fund to support national relief efforts. Additional initiatives focus on healthcare, skills development, and income-generation programmes for marginalised groups.
Environmental responsibility forms another part of its agenda. The bank promotes resource-efficient branches, reduced paper usage, and the adoption of eco-friendly technologies. It also supports projects in renewable energy and responsible energy consumption.
Over time, Kotak Mahindra Bank’s ethical governance, measured growth strategy, and sustained community engagement have reinforced its stature as an institution that delivers value while contributing to India’s broader progress. Each milestone underlines its role in the country’s financial landscape and its commitment to customers and communities.

Roswalt Realty has been witnessing incredible success under the stellar stewardship of Ar. Shantanoo Vishwanath Rane, the Chairman and an architect with global experience. Like a true leader, he laid the foundation of the real estate firm after identifying critical gaps in Mumbai’s real estate sector. Also, his empathy for homebuyers facing high interest rates and design imperfections drove him to create a systemised, transparent approach. With a global portfolio, including the iconic Grand Hyatt and a UNESCO Award-winning sustainable school, the brand, under his guidance, brings a unique perspective to Mumbai’s real estate sector.
Roswalt Realty’s portfolio consists of thoughtfully designed projects across Mumbai, including Roswalt Heights in Chembur, Ibis Tower in Kandivali, Brizo Tower and Ryan Park in Govandi, 72 Maheshwardham in Ghatkopar, and Ray by Roswalt. The company’s upcoming flagship projects further solidify its commitment to design innovation. Its ongoing projects include Roswalt Zaiden and Roswalt Zyon in Jogeshwari-Oshiwara, Roswalt Raya in Chembur, Roswalt Vanya in Versova, Roswalt Shatartarka in Andheri West, Roswalt Sujata Niwas in Bandra West, and Roswalt Rua (yet to be launched) in Oshiwara. These housing projects are set to elevate luxury living with innovative design and nature-inspired aesthetics to cater to varied lifestyles.
Roswalt Realty stands out for its transparency, together with its designdriven and consumer-focused approach. Unlike traditional developers, the company integrates architectural precision with consumer needs to create personalised living spaces. Simultaneously, the realty firm emphasises Vastu-compliant layouts and functional designs like L-shaped kitchens and niche wardrobe spaces, with a focus on ‘Zero Space Wastage’ in


every home.
Roswalt Realty, established in 2014, has built a strong reputation for its architectural brilliance. With the powerful motto, “On Time. Every Time.”, Roswalt Realty delivers premium residential projects that epitomise luxury, functionality, and sustainability gardens, and pet-friendly zones. Roswalt Zyon, on the other hand, offers ultra-luxury residences equipped with advanced smart home technology and enhanced privacy. Moreover, green features like solar panels further set Roswalt Realty’s homes apart, besides attracting contemporary and ecofriendly homebuyers.
Roswalt Realty offers an integrated real estate ecosystem, managing every aspect in-house through its sister firms — Buildcon for construction, Eternia for facility management, Render Studio O25 for interiors, and VJS (Vaishali Jain Solanki) for architecture. Pinnacle Makler further assists clients in buying, selling, or upgrading properties, making Roswalt Realty a complete property solutions provider.
Sustainability lies at the core of Roswalt Realty’s vision. The organisation integrates nature-inspired elements into its projects, such as tranquil water bodies and butterfly gardens in Roswalt Raya, for creating serene urban retreats. Similarly, Roswalt Zaiden features expansive lifestyle podiums with amenities like a 5,400 sq. ft. gym (the largest in Oshiwara), Zen
Roswalt Realty’s innovative approach has earned it several prestigious accolades. Ar. Rane’s exceptional work has garnered recognition from the Council of Architecture, Mumbai, and the Indian Institute of Architects. His crowning achievement came with the UNESCO Award for his sustainable designs supporting the government’s “Education for All” initiatives. Also, the brand’s forest-inspired Roswalt Raya and the ultra-luxury Roswalt Zyon, have garnered immense praise for their impact on urban living.


Facilitating accessibility in international trading through its innovative financial trading software, Century Financial is one of the favorites among local and foreign clients in the UAE. The company has become well-known for their extensive range of trading instruments in several asset classes and excellent customer service
Century Financial was established to provide clients with an exceptional trading experience through high-touch services, multiasset trading platforms, customised research, and diverse investible products. Committed to delivering value, the firm offers dedicated support to every client, regardless of investment size. It also equips traders with educational resources, like specialized training sessions, guiding them from foundational concepts to advanced strategies. The brand provides clients with added assurance through safeguards such as insurance coverage of up to US $2 million per client in the unlikely event of insolvency. Led by Chairman and CEO Mr. Bal Krishen, Century Financial has become a pioneer in trading and investment innovation, leveraging over 35 years of experience in the UAE market to consistently set high standards in the

financial services sector.
Century Financial prioritises responsible risk management and provides clients with tools, custom desktop and mobile alerts, and advanced features to help manage trading risks effectively. Additionally, the company, regulated by the Securities and Commodities Authority, maintains segregated client accounts, and is registered and licensed by the
Department of Economic Development, Government of Dubai. It also offers round-the-clock support, allowing clients to trade with confidence and security.
Century Financial drives inclusive growth by creating an environment where every employee is supported to develop and excel. The company invests in regular training programs, skill-building workshops, and mentorship initiatives to enable continuous professional advancement. They also actively celebrate cultural diversity and encourage open collaboration across teams. This people-first approach has strengthened engagement, belonging, and shared progress. As a result, Century Financial has been recognized as a Great Place to Work® for five consecutive years, reflecting its commitment to nurturing a supportive workplace.
Century Financial has received widespread recognition for its outstanding services. In 2025, it won Best Trading Experience – MENA and Best Trading Platform –MENA at the Global Forex Awards, along with Best Trading Platform of the Year 2025 and Best Mobile Trading Platform in the Middle East 2025. It also received the Most Innovative Trading Technology Award in the UAE at the International Finance Awards 2024. Its app was recognised as the Leading CFD Broker in the UAE and Most Innovative Trading App in the UAE by Brands Review Magazine in 2024. In 2023, Century Financial earned Best Trading Experience – MENA and Best Trading Support – MENA at the Global Forex Awards, Fastest-Growing Trading Platform in the UAE at the International Finance Awards, and Best Client Service Provider and Best Trading Platform by Global Business and Finance Magazine.
Century Financial’s long-term goal is to maintain its status as a leading choice for global investments in the UAE by improving services and adopting innovative practices. Its dedicated team members focusses on simplifying investments through a customer-centric approach, top-tier expertise, and advanced technologies, with a strong emphasis on investor education to empower clients to make informed decisions.
& BEVERAGES
Founded in 1933 by Phya Bhirom Bhakdi in Bangkok, Boon Rawd Brewery was established with the vision of crafting beer to international specifications while maintaining Thai character. From its early brewhouse operations to today’s advanced facilities, the company has expanded into a global enterprise spanning beverages, food, and packaging, maintaining consistency and craftsmanship in every stage of production. Its flagship brands—Singha, Leo, U Beer, and Snowy Weizen—stand alongside a growing range of non-alcoholic drinks, food products, and packaging solutions. The brand focuses on sustainable brewing practices and environmental stewardship, driven by the belief that responsible production benefits individuals, communities, and the environment.
Boon Rawd Brewery’s legacy is rooted in a balance between time-tested methods and technological precision. Brewhouse operations meticulously follow strict international standards, incorporating stateof-the-art automation, quality assurance protocols, and sustainable processing systems. Controlled fermentation, advanced filtration, and rigorous conditioning help preserve the signature flavour profile and purity of every single batch produced. Strategic ventures such as Singha Drinking Water, Singha Soda Water, and Singha Park Chiang Rai demonstrate forward-thinking expansion while staying true to the founding principles of reliability and consumer trust.
Sustainability underpins Boon Rawd Brewery’s operations. The company integrates environmentally responsible practices across its production cycle for emphasising water conservation, energy efficiency, and waste-toresource management. Additionally, its comprehensive and sustainabilitydriven Environmental Management Policy



promotes a circular-economy model through resource optimisation, pollution prevention, and eco-friendly process innovation.
Boon Rawd also actively contributes to social development through a variety of programmes in education, healthcare, and rural livelihoods. The Singha R-SA Project engages volunteers to provide handson support to communities affected by natural disasters, ensuring timely relief and rehabilitation. Meanwhile, Singha Park Chiang Rai encourages organic farming, generates local employment opportunities, and drives environmental restoration initiatives. Collectively, these efforts demonstrate Boon Rawd’s commitment to maintaining a harmonious balance between business growth and the well-being of the communities it serves.
Boon Rawd Brewery was awarded the Royal Warrant of the Garuda Emblem on October 25, 1939, signed by the Regent
Boon Rawd Brewery is Thailand’s first and most renowned brewery, known for producing premium beverages that have become hallmarks of quality and pride. With a diverse portfolio covering beer, water, and food products, the company sets new standards in excellence and sustainability of King Rama VII, in recognition of its superior standards and integrity. It is the only brewery in Thailand to hold this prestigious distinction. Additionally, Boon Rawd Brewery has earned national and international recognition for its rigorous production standards and people-focused management. The company also received Dual Gold Awards at the 2025 International Conference on Quality (ICQ) Japan for outstanding manufacturing performance. The brewery’s workplace culture has also been widely commended. Boon Rawd was named among the HR Asia Best Companies to Work for in Asia and received the HR Asia Most Caring Companies Awards in 2021 and 2022, reflecting a people-first ethos. Furthermore, the Singha portfolio has achieved distinctions including the Monde Selection Awards, International Brewing Awards, and Superior Taste Awards, affirming Boon Rawd’s reputation for precision brewing and consistency across global markets.

From ATM Service to digital payments, Electronic Payment and Services (EPS) has been powering the invisible infrastructure that makes everyday transactions seamless and secure. Together with its customers, EPS is building a robust, inclusive payment ecosystem across physical and digital channels
When you scan a QR code to pay for groceries, drive through a FASTag-enabled toll plaza, or transfer money instantly to a friend, you’re experiencing the visible face of India’s digital payments boom. But behind every seamless transaction lies an intricate web of technology—and companies like Electronic Payment and Services are the ones keeping it all running.
Founded in 2011, Electronic Payment and Services (EPS) began with a simple mission: making cash accessible through ATMs across India. Today, that commitment has evolved into building the digital backbone that connects banks to India’s booming payment ecosystem.
Think of EPS as the engine room of a ship—you don’t see it, but without it, nothing moves. As India’s digital payment volumes exploded through

UPI, RuPay cards, and instant bank transfers, banks faced the challenge of managing enormous transaction volumes with speed, accuracy, and security. To meet this demand, EPS delivers robust, cloud-based technology platforms that seamlessly process millions of transactions each day while automatically reconciling payments across multiple channels.
Fully compliant with RBI and NPCI regulations, EPS’s systems enable banks

to efficiently manage UPI transactions, FASTag toll payments, and instant money transfers, ensuring reliability, transparency, and uninterrupted digital banking experiences for customers nationwide.
EPS helps banks participate in India’s Account Aggregator system—a secure way for you to share your banking and investment data digitally, with your permission. Whether you are applying for a loan, seeking investment advice, or wish to track all your finances in one place, this technology eliminates the need for paperwork and gives you faster, more personalised financial services, thus making everyday banking simpler, more convenient, and accessible to customers across India.
EPS addresses a critical challenge: helping small businesses access formal banking. Through a bank-led digital platform, MSMEs can manage payments, expenses, taxes, and invoices in one place.
The organisation helps banks gain realtime visibility into verified transactions and financial data, enabling them to confidently offer working capital and business loans to deserving enterprises. EPS provides the intelligence—banks deliver tailored financial solutions.
Despite India’s rapid digital progress, cash continues to play a vital role in everyday transactions. EPS recently became the first company in a decade to receive a White Label ATM license, deploying eps BANCS™ ATMs in semiurban and rural areas. The organisation always focusses on reliability, whether in deploying ATMs, processing transactions, or enabling banks on new payment channels.
While consumers experience smooth, effortless digital payments, EPS operates silently behind the scenes, powering the critical banking infrastructure that processes, secures, and reconciles millions of transactions every day. Its robust, reliable systems enable banks across India to serve customers seamlessly at massive scale, ensuring trust, continuity, and efficiency—one transaction at a time.

Nutridor Dairy Manufacturing LLC, headquartered in Dubai, UAE, is a subsidiary of Tropical General Investments (TGI) Group, a global conglomerate with operations in 13 countries across Africa, the Middle East, and Asia. The company selected the UAE as its regional base and established a state-of-the-art dairy production facility in Dubai Industrial City. Spanning 100,000 sq. ft., the plant produces up to 120,000 liters of liquid dairy each day. Powered partly by solar energy with an annual generation capacity of 100,000 kWh, the facility was designed with a strong emphasis on sustainability, clean energy, and zero-waste operations. Incorporated in January 2016, Nutridor quickly earned recognition across emerging markets by building an international presence and offering consumers a selection of nutritious, high-quality dairy products. The company’s growth continues under the leadership of its Chief Executive Officer, Mr. Sankha Biswas. He brings more than 25 years of global experience in the food and beverage industry. A graduate of Harvard Business School’s Executive Management Program, he is widely regarded for his strategic insight and deep sector expertise. Mr. Biswas also serves on the Board of Directors of the UAE Food & Beverage Business Group. This role underscores his impact on the region’s food sector, with his vision and global perspective reinforcing Nutridor’s standing in the global dairy market.
Nutridor offers an extensive selection of dairy and non-dairy items, including evaporated milk, sweetened condensed milk, UHT milk, soy milk, cheese, butter, milk powder, butter oil, fruit juices, UHT malt beverages, and energy drinks. Under its flagship brand Abevia, the company applies scientific expertise and product innovation to create nutritious milk products and flavourful dairy


Nutridor Dairy Manufacturing LLC is an esteemed dairy manufacturer recognised for delivering high-quality, sustainable dairy products to households worlwide. Recognised as a Superbrand, the company’s success stems from its deep consumer insights and market responsiveness
treats. Alongside standard formulations enriched with calcium and vitamins, Nutridor develops products designed to deliver essential micronutrients while being accessible and affordable to a broad consumer base.
A skilled and motivated team forms the foundation of Nutridor’s operations. They work collectively to deliver lasting value for customers. Team members possess a clear understanding of how dairy products influence everyday consumption and maintain a focus on customer satisfaction through dependable quality. Their efforts align with TGI Group’s objective of enhancing resource utilisation across diverse ventures in emerging markets. The workforce consistently refines both the nutritional profile and overall standard of each product, ensuring every offering meets Nutridor’s benchmark for quality.
In addition to its business achievements, Nutridor takes an active role in social initiatives that support community welfare. The company contributes to programs and campaigns designed to improve living standards and promote inclusion. It is the executive sponsor of Climb to Change a Life, an initiative that helps children with mobility challenges gain independence and confidence.
Aligned with its goal of making a healthier tomorrow, Nutridor integrates social responsibility into its long-term objectives. The company focuses on developing nutritious dairy products through research and innovation in both health and flavour, supported by investments in advanced production facilities. This approach has bolstered customer confidence and driven the company’s growth in the dairy sector.

Valency International, founded in 2007 in Singapore, is a leading agribusiness player. With a vertically integrated model spanning agriculture, agri-inputs, industrial chemicals, and FMCG, it employs over 2,600 professionals across 22 countries
Under the sterling stewardship of Mr. Sumit Jain, Executive Director and Chief Executive Officer, Valency International has been witnessing remarkable success. Since taking the reins in 2021, Mr. Jain has driven the organisation’s growth by expanding its presence worldwide and leading the company into new, highgrowth markets. Under his direction, the Singapore-based commodity trading company has evolved into a sustainabilityoriented, value-driven organisation committed to innovation and strategic integration.
Valency International’s success lies in its ability to operate at a global scale while maintaining deep local insight. Its footprint extends across Africa, Asia, the Middle East, and Australia through

a network of 22 subsidiaries. The company’s operations are categorised into four main verticals. Its agriculture segment is involved in the trading and processing of agricultural commodities such as cashews, almonds, walnuts, sesame, soybeans, rice, corn, wheat, cocoa, sugar, and spices. Likewise, its agri-inputs division distributes essential products like fertilisers, agrochemicals, seeds, and farming equipment, helping farmers boost their productivity.

The company’s industrial segment caters to various industries by distributing chemicals, steel, and paper products. Similarly, its FMCG division focuses on creating and marketing branded food items. Its “With Love, Gretel” line of healthy snacks suggests a future-focused transition towards consumer-oriented, branded products. Such a diversified strategy enables the organisation to cater to a wide range of market needs while emphasising quality and innovation.
Valency International has aggressively followed backward integration since 2015 with the aim of improving supply chain efficiency. One of its major accomplishments is the launch of one of the world’s largest cashew processing facilities in Côte d’Ivoire. Additionally, the acquisition of Aarna Singapore Pte Ltd. brought a 110,000 MT per annum rice milling facility in Vietnam, thereby strengthening the company’s processing capabilities.
Valency International has secured substantial financial support to drive its expansion. A USD 60 million syndicated loan from Proparco and DEG has facilitated the growth of agro-processing facilities in Nigeria, including cashew processing and food packaging units. Furthermore, a USD 30 million equity investment from British International Investment has supported sustainable agriculture initiatives in West Africa. These partnerships reflect the organisation’s focus on sustainable expansion and its effort to boost regional economic growth.
Sustainability lies at the core of Valency International’s mission. Through its Farmer Relationship Management program, the company promotes responsible sourcing and encourages sustainable farming practices. It is also committed to reducing its carbon footprint and meeting high environmental regulations in addition to providing safe working conditions through its Occupational Health and Safety program. Gender diversity is another primary area of interest, with over 68% of its employees being women, particularly in labour-intensive production activities like cashew processing in Sub-Saharan Africa and Asia.

Established in 1977 in Bengaluru, Dr. SRCISH serves as the academic arm of the Bangalore Speech and Hearing Trust, founded by Dr. S. R. Chandrasekhar (FRCS), a distinguished ENT surgeon. Ranked among India’s leading centres for speech and hearing sciences, it provides diagnostic and rehabilitative care for individuals with voice disorders, hearing impairment, stuttering, cerebral palsy, cleft lip and palate, learning disabilities, post-stroke communication deficits, intellectual disability, and autism spectrum disorders. Dr. SRCISH’s diagnostic expertise is well-regarded by otolaryngology and neurology specialists. The organisation also launched Bengaluru’s first cochlear implant programme in 1997, setting new benchmarks in auditory rehabilitation.
Dr. SRCISH focuses on developing skilled professionals who can lead preventive and early intervention efforts to reduce the incidence of communication disorders. The institute has created transformative programmes to help individuals with communication challenges achieve selfreliance and social participation. Its modern infrastructure includes advanced laboratories, a well-resourced library, and specialised research facilities, positioning the institute as a reliable centre for learning and innovation. Upholding this responsibility, Dr. SRCISH trains students in speech, language, and hearing sciences through academic pathways in audiology, special education, and speech-language pathology—fields that offer rewarding careers as audiologists, speech-language pathologists, and educators for children with hearing impairment.
To address the growing demand for qualified professionals, Dr. SRCISH offers a wide spectrum of graduate, postgraduate, and doctoral programmes.


Dr. S. R. Chandrasekhar Institute of Speech and Hearing (Dr. SRCISH) envisions an inclusive world for individuals with communication disorders. The institute’s mission is to advance research, develop innovative technologies, and deliver world-class clinical services that transform lives and restore communication disorders. Through partnerships with government health departments, it offers diagnostic services in public hospitals, helping ease the burden on government healthcare systems. It also provides free newborn communication-disability screenings in several Bengaluru-based government hospitals, thus enabling early detection and intervention.
All courses are affiliated with Bangalore University and recognised by the Rehabilitation Council of India (RCI). The institute’s academic offerings include a Diploma in Special Education (Hearing Impaired), a Postgraduate Diploma in Auditory Verbal Therapy, and an undergraduate programme, the Bachelor of Audiology and Speech-Language Pathology (BASLP). It also provides postgraduate degrees in Audiology and Speech-Language Pathology, along with Ph.D. programmes in both fields to advance research in communication disorders. Its Fellowship Programme in Speech and Swallowing Rehabilitation after Head and Neck Cancer Surgery continues to attract professionals seeking specialised clinical expertise.
For over forty years, Dr. SRCISH has focused on diagnosing, rehabilitating, and educating people with hearing and speech
Dr. SRCISH further conducts behaviour management programmes for children and provides specialised therapy for stroke patients, enabling them to regain swallowing and speech functions.
Dr. S. R. Chandrasekhar Institute of Speech and Hearing was recently honoured with the prestigious Dr. Shantha Radakrishna Endowment Award (2023) for service in Hearing Impairment, and the Rajashri Shree Nalwadi Krishnaraja Wadiyar Award (2022) for the Empowerment of the Disabled.

BCD Group, founded in the year 1952, has grown from a humble construction company into one of India’s most respected and diversified real estate conglomerates. Over more than seven decades, BCD has delivered excellence, innovation, and trust, thereby earning a reputation that now places it among the world’s most reliable real estate brands
The story of BCD Group mirrors the growth of modern India. What started as a small construction company has grown into a global enterprise that has delivered over 150 million square feet across residential, commercial, industrial, and mixed-use spaces. Today, BCD proudly stands out as India’s fourth-largest real estate company by total area delivered. Often referred to as the “TATA of India’s real estate sector,” the company symbolises reliability, integrity, and class.
What defines BCD is its legacy. Four generations of leadership have steered
the group through changing times, each one infusing new ideas while preserving the company’s founding values. Under the leadership of its Managing Director Dr. Angad Singh Bedi, the Group’s fourthgeneration entrepreneur, the company has transformed from a family-run construction firm into a globally integrated real estate conglomerate. Dr. Bedi realised early that the market was shifting and that BCD needed to evolve. “We started as a founder-driven company,” he shares, “but the market demanded a more professional approach. We embraced data and insights to make better decisions, ensuring every move we make is backed by intelligence

and purpose.” This shift from instinctdriven to insight-driven management has fueled BCD’s global rise. Today, it manages over 60 million square feet of assets worldwide, with 20 million square feet currently under development. What’s more, its presence extends across seven Indian states and into the UAE, Mauritius, Nepal, Iraq, Africa, and Singapore.
BCD Group has diversified into emerging verticals such as senior living, co-living, student housing, healthcare, religious tourism, hospitality, commercial real estate, education, facility management,
and vocational training. This expansion reflects its understanding of the world’s changing social and demographic needs. As populations age, cities expand, and lifestyles shift, the company aims to deliver not just spaces, but holistic living environments.
One of BCD’s most groundbreaking initiatives, BCD Vanaprastha, introduced India’s first senior rental living model, by offering care, community, and comfort for the elderly. The success of this concept has inspired plans to expand similar projects in Chennai and Delhi-NCR, thereby creating a new benchmark in senior care. Similarly, Educity, an initiative redefining student housing and education infrastructure, reflects BCD’s commitment to supporting young India with thoughtfully designed, affordable, and connected communities.
BCD’s team adopts data-backed strategies to address real market demands. It leverages advanced analytics and technology to make smarter, faster, and more sustainable decisions. Additionally, its large in-house construction workforce, the biggest in Indian real estate, gives BCD unmatched control over quality, timelines, and execution. This operational independence enables the company to consistently deliver projects that surpass expectations and set new industry standards. Moreover, BCD’s emphasis on renewable energy, sustainable materials and smart design ensures its projects meet the needs of a greener future.
BCD aims to become the world’s first borderless real estate brand that delivers standardised quality and experience across continents. Whether in Mumbai, Dubai, Nairobi, or New York, a “BCD stamp” will soon stand as a global symbol of trust and quality. This borderless approach draws inspiration from the consistency of prominent brands and the innovative mindset of global leaders. BCD’s secret lies in maintaining global standards while respecting local culture, community, and environment. To support this mission, it is setting up headquarters in Dubai, New York, and Riyadh, ensuring that its presence reflects both its global ambition and its deep cultural understanding.
Perhaps BCD’s most exciting innovation is its global real estate franchise model— the first of its kind. This concept allows entrepreneurs, developers, and investors


to partner with BCD, leveraging its 75-year legacy of excellence and systems built for success.
BCD actively participates in CSR activities. During the COVID-19 crisis, the group supported over 5,000 workers and their families by ensuring their safety during the uncertain times. In the past two years alone, it has created 500+ new jobs, contributing to India’s employment and development goals. The Group also handed over 5,000 apartments to struggling homebuyers. BCD also strengthens the economy and creates jobs through its Special Economic Zones (SEZs) for Fortune 500 companies. Also, BCD is deeply committed to sustainability, integrating eco-friendly practices like reducing carbon footprints and promoting green design in every new project.
Unlike many competitors, BCD operates with zero debt. This disciplined financial model gives it stability and freedom, and enables it to reinvest profits into innovation, R&D, and sustainable practices. By reviving stalled projects and injecting new life into the sector, BCD drives positive change across the industry. With revenue growth of over 30% in two years, the Group’s momentum shows no sign of slowing.
BCD Group has earned multiple accolades for its outstanding contributions to real estate, including the Best Real Estate Company of the Year (People’s Choice) at the Construction Week Awards 2025. It was also recognised as the Fastest Growing Construction Company in India at the 8th India Property Awards 2023 and received the Affordable Housing Project of the Year 2023 award at the same event.

Acer India, a wholly owned subsidiary of Acer Inc, is part of Acer’s global presence across160+ countries. In India, Acer has grown beyond PCs into a multicategory technology ecosystem covering gaming, AI-led computing, enterprise infrastructure & smart home solutions, supporting India’s growing digital economy
At the centre of Acer India’s remarkable transformation is the leadership of Harish Kohli, President and Managing Director of Acer India. Kohli plays a defining role in shaping the brand’s long-term vision—one that blends global technology leadership with deep local relevance. Under his stewardship, Acer India has consistently anticipated shifts in consumer, enterprise, and institutional needs, enabling the futureready brand to expand meaningfully.
Kohli is a strong advocate of the Make in India initiative, positioning local manufacturing as a strategic enabler rather than a tactical necessity. Acer India’s investments in domestic manufacturing and assembly have enabled faster customisation for Indian conditions, improved supply-chain agility, and closer collaboration with local partners. Equally

important has been his emphasis on local R&D and engineering inputs—ensuring innovation is increasingly shaped in India, for India, while meeting global quality benchmarks.
One of Kohli’s most significant contributions has been guiding Acer India’s expansion beyond its PC heritage. Recognising early the convergence of technology, lifestyle, and performance,
he led diversification across three key growth pillars: gaming, smart consumer electronics, and enterprise infrastructure. The launch of Acerpure marked Acer India’s entry into smart home and lifestyle technology, bringing air purifiers, smart TVs, ACs, vacuum cleaners, and connected appliances to consumers. This move addressed growing demand for health, comfort, and smart living, leveraging the brand’s retail and service network.
Under Kohli’s leadership, Acer India has strengthened its enterprise and institutional portfolio through the expansion of Altos India—Acer’s dedicated brand for servers and workstations. Altos supports India’s growing demand for high-performance computing across government, education, BFSI, manufacturing, and emerging AI workloads.
Altos servers and workstations are AIready, built to handle data-heavy tasks like analytics, simulations, AI training, edge computing, and critical enterprise workloads. By integrating global Acer engineering with local deployment and support capabilities, Kohli ensures Altos drives India’s digital infrastructure, enabling data localisation, AI adoption, and public sector transformation.
AI sits at the core of Kohli’s technology vision for Acer India. Across consumer PCs, gaming devices, Altos enterprise systems, and emerging smart ecosystems, AI is being integrated to deliver adaptive, intelligent, and future-ready experiences. This AI-first approach positions Acer India as a holistic technology partner— serving individuals, institutions, and enterprises navigating the next phase of digital transformation.
Acer India consistently champions inclusive growth. Its omnichannel strategy, spanning a D2C platform reaching 18,000+ pin codes, strong retail partnerships, and accessible financing options, reflects Kohli’s belief that innovation must reach beyond urban centres.
Equally, sustainability and CSR are core to his leadership, with Acer India driving environmentally responsible operations and initiatives in healthcare, education, environmental conservation, and inclusive technology, balancing purpose with performance.
ounded in 1990 by Professor Mohammed Iqbal Chand, DML continues to advance his vision under the leadership of Dr. Mohammed Chand, who joined the organisation in 2019 after completing his medical training in South Africa. Under his guidance, the company is strengthening its regional footprint through precise pathology services and modern diagnostic technologies. With a test menu exceeding 3,000 analyses ranging from routine screenings to complex histological examinations. DML employs advanced equipment and validated methodologies to ensure clarity, accuracy, and consistency in every result.
DML has been raising standards in medical diagnostics through a thoughtful, patient-centered approach. The process begins with a warm, courteous reception in a well-designed environment where trained staff manage each step with professionalism and discretion. Registration is completed efficiently before the phlebotomy team collects samples with careful, methodical precision. Laboratory automation has significantly increased efficiency and result uniformity, while the introduction of digital pathology allows specialists to review specimens remotely, accelerating interpretation and improving operational reliability.
With over 76 branches and six laboratories across Botswana’s towns and villages, DML has expanded access to reliable diagnostic care. Most citizens now live within five kilometers of a DML service point, an achievement that supports the country’s broader health objectives. Employing more than 230 qualified professionals, the organisation acts as a key referral center for both public and private healthcare providers. Its offerings now include advanced genetic testing and specialised analyses, with approximately


Diagnofirm Medical Laboratories (DML) stands among Botswana’s foremost providers of medical laboratory services. Operating across the nation, the firm has built a reputation for dependable, affordable, and comprehensive clinical testing supported by advanced diagnostic systems that ensure credible results
70% of national clinical decisions informed by DML’s diagnostic outputs.
Professional development and continuous technological adoption remain central to DML’s leadership in the sector. The organisation invests heavily in training laboratory scientists and technicians, ensuring technical competence and ethical practice across all operations. This sustained commitment to excellence keeps DML aligned with international standards and reinforces confidence among clinicians and patients nationwide.
During the COVID-19 pandemic, DML played a vital role in enhancing Botswana’s diagnostic capacity. Accredited by both the Southern African Development Community Accreditation Services
(SADCAS) and Independent Counseling and Advisory Services (ICAS), its main laboratory served as the nation’s sole facility authorised to conduct both PCR and antibody testing. DML further supported national preparedness by donating an extractor machine to the Ministry of Health and Wellness, demonstrating its commitment to public health resilience.
DRIVING COMMUNITY WELL-BEING Corporate responsibility is integral to DML’s mission. The organisation supports initiatives that address critical public health issues, including breast cancer awareness, free prostate screenings during Men’s Health Awareness Month, and partnerships with the Diabetes Association of Botswana to provide complimentary glucose testing. These efforts reflect DML’s belief that impactful healthcare extends beyond diagnostics to meaningful community engagement and wellness advocacy.

TATA Steel is a leading global steel company with an impressive annual crude steel capacity of 34 million tonnes. It is widely recognised as one of the most geographically diverse steel producers, with operations and a strong commercial presence across the world
Founded in 1907, TATA Steel is a premier global steel enterprise and a distinguished member of the TATA Group, boasting operations across more than 26 nations and manufacturing facilities in India, Europe, and Southeast Asia. The company manufactures and supplies a broad portfolio of products with a comprehensive business model that encompasses everything from mining to the production and marketing of finished steel goods. TATA Steel has already reached the pinnacle of excellence under the guidance of Chairman Mr. Natarajan Chandrasekaran.
TATA Steel consistently redefines its standards of performance to set global performance benchmark in the steel industry. By prioritising raw material security, it has become Asia’s lowestcost steel producer. The company’s Raw Material Division manages captive iron ore

and coking coal mines located in the Indian states of Jharkhand and Odisha. Essential manufacturing functions are carried out by the raw materials and iron-making groups, while Shared Services ensures seamless production support. The downstream and related businesses operate as profit centres, including Ferro-alloys and Minerals, Tubes, Wires, Bearings, Agrico, Industrial Byproducts Management, and TATA Growth Shop. Today, TATA Steel stands among the select few steel companies with fully

integrated operations, encompassing everything from mining to the manufacturing and marketing of finished products.
TATA Steel serves a variety of sectors, including agriculture, automotive steels, construction, consumer goods, energy and power, engineering, and metal handling. In the agriculture and forestry equipment industries, TATA Steel acknowledges the essential function of wear-resistant steel and produces a diverse range of specialised machinery.
The company has also taken the initiative in creating specialised products for the automotive sector, such as micro-alloyed high-strength steels, Interstitial Free steel, and Galva Annealed steel for two-wheeler fuel tanks. For the global construction industry, it provides structural frames (sections, tubes), infrastructure solutions, building products (roof and wall solutions), and internal fit-out applications. TATA Steel’s energy and power sector offerings include pipelines, structural products, fabricated systems, and steel components for drilling and power generation, all made to high-quality standards.
In 2025, TATA Steel was recognised as a Sustainability Champion by the World Steel Association for the eighth consecutive year. It also received multiple prestigious accolades in 2024 including, the Worldsteel Safety and Health Excellence Recognition, the Golden Peacock National Training Award and Digital Enterprise of India – Steel Award by The Economic Times CIO 2024. The brand has been distinguished as one of the Top 3 Most Attractive Employers in India, according to the Randstad Employer Brand Research (REBR) conducted in 2023. Furthermore, TATA Steel has been certified a ‘Great Place to Work’ for six consecutive years (2018–2023) by the Great Place to Work Institute for six consecutive years. Moreover, in 2022, TATA Steel’s Jamshedpur plant received India’s first BIS license for manufacturing structural weather-resistant steel.
Tata Steel’s community initiatives focus on education, healthcare, and sustainable livelihoods. The company empowers communities through skill development, agriculture, and entrepreneurship. It also prioritises the preservation of indigenous culture and maintains social consent through structured public consultations.
or over 30 years, HOSMAT Hospitals has dedicated itself to providing affordable and best-inclass healthcare services. With more than 20 lakh patients treated, it stands out as a trusted name in India’s healthcare sector. The hospital has over 500 beds across three hospitals, 30 dedicated ICU beds, 28 state-of-theart operation theatres, AI-integrated MRI scans for advanced diagnostics, and specialised centres such as the Joint Replacement and Spine Centre. With over 100 robotic joint replacement surgeries performed, the hospital leverages cutting-edge technology to cater to patients’ complex orthopedic needs with precision and expertise.
HOSMAT Hospitals also offers advanced services like dietetics, physiotherapy, and corporate health plans, focusing not just on treatment but on prevention and overall long-term wellness.
SAVING LIVES EVERY SECOND Emergency and trauma services play a vital role in patient outcomes, where every minute matters. To that end, HOSMAT Hospitals offers 24-hour accident and trauma care supported by advanced surgical facilities, dedicated orthopaedic and neurosurgical teams, and rapid-response systems capable of managing complex fractures, spinal injuries, and multiple traumas. Additionally, immediate access to operation theatres, radiology, CT and ultrasound, laboratory diagnostics, and pharmacy ensures continuous and coordinated care. This integrated setup enables patients to receive critical treatment without delay, thereby reinforcing the hospital’s reputation for excellence in trauma and emergency management. Also, its modern infrastructure, accessible environment, and efficient emergency response have made it a trusted name in healthcare. The hospital also provides a wide range


Since 1994, HOSMAT Hospitals in Bengaluru has set high standards in healthcare and patient care. As one of India’s largest and best-equipped orthopaedic centres, it provides advanced services in joint replacement, arthroscopy, sports and paediatric orthopaedics, orthotics, prosthetics, physiotherapy, and rehabilitation
of medical and surgical specialities, including neurosurgery, oncology, cardiology, pulmonology, plastic and reconstructive surgery, neurology, spine surgery, urology, internal medicine, psychiatry, and others.
HOSMAT Hospitals offers advanced medical expertise with a deeply humane approach to care, a balance that has earned it patient trust and national recognition. The hospital’s high satisfaction rates, word-of-mouth reputation, and record of successful clinical outcomes reflect its commitment to world-class care and compassion. Accredited by the National Accreditation Board for Hospitals & Healthcare Providers (NABH) and certified under ISO 9001:2015, the hospital meets rigorous standards of safety and patient-centred management. Over the years, it has received multiple honors, including the
Best Hospital Award from The Times of India and Outlook, and has been ranked second among orthopaedic hospitals in Bangalore and seventeenth nationwide by The Week magazine.
HOSMAT Hospitals’ sustainability initiatives reflect its commitment to long-term environmental responsibility and strengthening trust among patients, employees, and the wider community. In recent years, the hospital has implemented several strategies focused on environmental stewardship, community engagement, employee wellbeing, and operational efficiency. These efforts include green hospital initiatives, digital transformation to reduce paper usage, community health and preventive care programmes, employee welfare and culture-building measures, and a focus on ethical branding with transparent communication.

FORGING THE FUTURE OF AFRICA’S GROWTH
Since its establishment in 2000, Tembo Steels Uganda Limited (TSUL) has grown into one of East Africa’s leading industrial enterprises. As Uganda’s only producer of primary steel, TSUL is driving the nation’s shift from reliance on secondary steel toward a more advanced, value-added manufacturing model
For over 25 years, the ISO 9002–certified company has introduced key products, such as TMX Rebars and lightweight structural steel. With Uganda now producing Directly Reduced Iron (DRI), TSUL uses it as the primary input, ensuring output defined by consistency, purity, and strength. Its portfolio includes TMX Rebars for high-rises and dams, structural steel for fabrication, HRC for hot-welded sheets, and other products. This diverse range establishes the company as a trendsetter in Africa’s steel industry.
TSUL strives to lead Africa’s steel industry through innovation and integrity, aiming to make Uganda’s steel sector self-sufficient while meeting the needs of customers, employees, suppliers, and the nation. Under the leadership of its Chairman and

Managing Director, Mr. Sanjay Awasthi, the company has strengthened its position against foreign competition, including Chinese imports, by expanding production capacity. Since diversifying into structural steel in 2008, it now operates two facilities in Bukharaji and Lugazi. Furthermore, since 2018, it has managed a DRI plant with an annual capacity of one lakh tonne, followed by a 2.5 lakh-tonne unit launched last November. Combined, these facilities have raised TSUL’s capacity to 3.5 lakh

tonnes, establishing it as Uganda’s only producer of primary steel.
With the recent expansion of its Balaji facility, TSUL has reached a wire rod capacity of 300,000 tons, structural steel of 150,000 tons, and crude steel of about 600,000 tons. It operates one of Africa’s most diversified steel plants, encompassing all four verticals through the primary route—TMX rebars, wire rods and products, light-gauge sections, and structural sections. The company utilises varied raw materials, including sponge iron, recycled scrap, and cast iron. At the core of Tembo Steels’ philosophy lies sustainability. The company champions the practical application and widespread adoption of green steel across Uganda, achieving a carbon emissions matrix nearing 70% surpassing global averages. TSUL is also ahead of schedule in meeting international CO2 emission benchmarks, maintaining an average close to 2.45 tons.
TSUL actively contributes to healthcare, education, and environmental causes. It allocates $150,000 annually to philanthropic initiatives and cultural events related to cancer care, charitable outreach, patient support, and eye surgeries. During the COVID-19 crisis, it produced oxygen for hospitals and improved medical support. Today, it runs Uganda’s largest oxygen facility, supplies 500 hospital beds each year, and promotes afforestation through organised plantation drives.
TSUL has set multiple global benchmarks and achieved continental milestones in steel manufacturing. Since 2004, it has produced Uganda’s lightest auto steel profiles and is the world’s lightest structural steel manufacturer. It pioneered converting cast iron into lowcarbon liquid steel and, in 2008, became the first globally to produce 0.7 mm Hot Rolled Sheets via direct rolling.
TSUL also developed the lightest structural sections in 2012 and commissioned Africa’s first billet caster in 2015. With the most diversified commercial steel portfolio in Africa, it produces nearly 70% of steel globally through integrated routes and leads the region in liquid steel, structural steel, and TMX rebar capacities.
When India was taking its first confident steps as a young nation, there was an urgent need for quality educational materials. Late Shri Kewal Ram Gupta recognised this gap and decided to bridge it by creating resources that were both affordable and accessible. His vision was to make learning available to everyone, everywhere. What started as a small operation has today become a household name in the education sector.
Over the years, the company has not only expanded its reach but also earned the trust of generations of teachers, parents, and students. Its enduring commitment to quality and relevance has made it a cornerstone of school education in India.
From those modest beginnings, Goyal Brothers Prakashan has achieved remarkable growth. Today, it serves over 30,000 schools and academic institutions, including 25,000 in India and others across 30 countries, through its international arm, Goyal Books Overseas (GBO). The company has recorded an average annual sale of 10 million books annually. Its extensive catalogue includes school textbooks (K–12), reading guides, competitive exam books, novels, workbooks, and premium notebooks. Additionally, for businesses and corporates, GBO offers custom paper stationery, calendars, magazines, and promotional material with elegant design. With a keen understanding of evolving educational needs, the company introduces new formats and digital tools that make learning engaging and effective. Its global presence reflects not just scale, but a deep belief in the power of education to bring lasting change.
GBO’s editorial board, guided by experienced subject experts, ensures each title maintains academic integrity while being engaging for learners. Many renowned authors have contributed to the company’s growing legacy, thereby helping millions of students excel in their




studies.
Goyal Books Overseas Pvt. Ltd., once known as Goyal Brothers Prakashan, began as a small-scale dream and blossomed into one of India’s most respected publishing houses. For more than 60 years, it has passionately worked to shape young minds and redefine quality education through its extensive collection of learning materials company’s reach to new global markets. Apart from scaling the legacy publishing business, he has co-founded several ventures promoting STEM learning and wellness education for driving holistic growth in education.
The company’s textbooks are modelled on CBSE and ICSE/ISC curricula, which make them a trusted companion in classrooms across the country. The company regularly conducts annual sales conferences that bring together its staff, dealers, and booksellers from all over the country, encouraging collaboration and constructive feedback to strengthen future editions.
Under the leadership of its Director, Mr. Dinesh Goyal, and his son Mr. Vikrant Goyal, GBO has embraced innovation while staying true to its founding values. The company’s modern printing facilities deliver greater speed, efficiency, and quality, helping maintain high standards while keeping books affordable. Mr. Goyal has also led the expansion of Goyal Books Overseas across the GCC region, tripling its retail presence and extending the
Over the years, GBO has earned the trust of leading corporate clients, including SpiceJet, Air India, and the Dabur Group, for its exceptional printing and stationery products. Whether producing a child’s first learning book or a company’s branded magazine, GBO applies the same care and attention to detail. True to the saying, “Excellence is not an act but a habit,” quality and consistency are at the core of everything the company does.
Six decades on, GBO stands tall as a name people associate with quality learning. From one man’s vision to a brand that reaches classrooms globally, its mission is to keep inspiring young minds and making education a little brighter every day.

Crystal Group, a renowned realty brand, has consistently redefined India’s industrial and logistics sector through its flagship vertical, Crystal Industrial & Logistics Park (CILP). Since its inception, the Group has transformed vast stretches of land into modern, sustainable, and futureready industrial hubs. With over 10 million sq. ft. of industrial space developed across 1,000+ acres of Net-Zero land, the group has delivered Grade-A infrastructure across key locations like Ahmedabad, Mumbai, Pune, Chennai, Bengaluru, and NCR. Also, the group manages 50+ projects across industrial, commercial, and residential sectors with 70+ prestigious national and global clients
rystal Group began its journey in 1990 as Gandhi Realty, a reliable developer building homes and offices in Gujarat with rock-solid quality and care. From those humble beginnings, it has firmly established itself as India’s preferred partner for Grade-A industrial and logistics infrastructure, specialised in building grand townships, buzzing retail complexes, and commercial landmarks that changed city skylines. Under the stellar leadership of its Chairman & Managing Director, Mr. Bakir Gandhi, the group has become a reliable partner for marquee clients, including Amazon, the TATA Group, Cars24, and CANPACK India. Crystal Group’s simple yet effective approach is to deliver end-

to-end, customised solutions while prioritising sustainability and long-term value. Additionally, companies like Honda, Maruti Suzuki, Coca-Cola, and others operate efficiently within Crystal Group’s spaces, supported by its endto-end services. Prime location, smart infrastructure, and flexible design enable tenants to operate efficiently and scale without constraints.
Since its inception, Crystal Group has raised the benchmark in industrial and logistics development. The group has partnered with industry leaders such as ESR, Indospace, Amazon, and Tata to deliver large-scale parks with record speed. For instance, Bavla in Ahmedabad hosts world-class warehouses for e-commerce, retail, FMCG, and auto sectors. In Sanand, a Tata-backed battery pack facility is under development to support India’s electric vehicle ambitions. Likewise, Matoda accommodates Amazon’s state-of-the-art sort centre, fully equipped for future robotics technology. Notably, Crystal Indus & Logistic Park completed the Amazon Sort Centre at Zydus Park – Ahmedabad ahead of schedule and earned a Letter of Appreciation from Amazon in recognition of the team’s exceptional performance. Across Maharashtra, Tamil Nadu, Karnataka, and NCR, the group offers plug-and-play and built-to-suit solutions ranging from 50,000 sq. ft. to over a million sq. ft., thereby efficiently meeting global supply chain requirements.
Crystal Group offers fully built-tosuit solutions and ready-to-move-in


facilities that eliminate the hassle of land acquisition and approvals. From smallscale units to mega facilities exceeding a million sq. ft., tenants gain the flexibility to grow operations without infrastructure constraints. Additionally, each park delivered by the group features highspeed connectivity to highways, ports, and airports, along with access to skilled manpower and ancillary services. Also, the parks’ smart, integrated systems allow businesses to optimise logistics, reduce costs, and achieve global competitiveness, reinforcing Crystal’s position as a partner of choice for industrial and supply chain leaders.
Crystal Group’s commitment to innovation has earned it industry acclaim. In 2025, the group was recognised as the “Most Emerging Brand in Industrial & Logistics Parks” for its leadership in delivering modern infrastructure with speed and precision. Right alongside, Mr. Bakir Gandhi received a well-deserved leadership award for his sharp thinking and commitment that has put Gujarat and India on the global warehousing map. These accolades have positioned the group as a trusted partner for national and international brands seeking reliable and future-ready facilities.
A sustainability champion, Crystal Group has pioneered the development of a 1,000acre zero-carbon park, incorporating IGBC-certified green buildings, renewable energy integration, EV-enabled parking, rainwater harvesting, and water recycling systems. Each park is designed to minimise environmental impact while providing cutting-edge technology for operational ease. By creating energy-efficient and green spaces, the group helps businesses scale confidently without compromising ecological responsibility.
Crystal Group is expanding its footprint across India and beyond. Its upcoming projects in Bhiwandi, Pune, Bengaluru’s Hoskote and Narsapura clusters, and Chennai’s booming OragadamSriperumbudur corridor are set to meet growing demand for Grade-A logistics and industrial infrastructure. Internationally, the Group is expanding into the UAE with a flagship Dubai logistics hub, thus taking Indian standards of efficiency and excellence to the Middle East.
Founded in 1973 & headquartered in Pune, Maharashtra, Kalyani Steels Ltd. (KSL), is part of the over $4.0 billion Kalyani Group, a diversified industrial enterprise with interests across engineering, automotive components, bearings, aerospace, energy, seamless tubes & other critical sectors. As the group’s primary steelmaking arm, it manufactures high-quality products, alloy & specialty long steels, & serves as a single-source supplier of critical components across key industries. In 1997, KSL established Hospet Steels Ltd., an integrated steel plant in Hospet Karnataka, to leverage the region’s rich iron ore & logistical benefits

alyani Steels Limited operates a fully integrated manufacturing facility at Ginigera, near Hospet in Koppal district, Karnataka. Spread across 375 acres and located in India’s iron ore–rich belt, the plant offers significant logistical and raw material advantages, ensuring uninterrupted operations. The facility is outfitted with modern equipment for iron making, steel melting, continuous casting, rolling, finishing, and testing, allowing KSL to produce Alloy and Specialty Long Steels of exceptional quality with precise metallurgical and dimensional control. The plant has an installed hot metal capacity of approximately 700,000 tonnes per annum. Under strategic alliance, KSL’s effective capacity is around 250,000 tonnes per annum. The facility manufactures steel for engineering, automotive, aerospace,
defence, oil & gas, bearing, seamless tubes, and energy sectors for critical components/applications such as engines, crankshafts, connecting rods, gear shafts, bearings, fasteners, transmission systems, axle parts, and seamless tubes. Advanced quality assurance systems, including rotary bending fatigue testing and mechanical property evaluation, ensure that all products meet international standards. These capabilities have established KSL as the most preferred single source supplier to leading domestic and global customers.
Under the stewardship of its Managing Director, Mr. R.K. Goyal, KSL has achieved remarkable success. As part of its long-term growth and diversification strategy, the company has entered into an agreement with the Govt. of Odisha

to establish an advanced specialty steel and automotive manufacturing complex at Dhenkanal district, Odisha. With an investment of ₹11,750 crore, the project will leverage Odisha’s abundant natural resources, skilled manpower, and strong infrastructure connectivity to expand KSL’s manufacturing footprint. The upcoming plant will focus on producing Alloy and Specialty Long Steels, primarily for the critical sectors, for meeting growing domestic and export demand. The project is expected to create large direct and indirect employment opportunities, boost regional socio-economic development, and support the growth of ancillary industries and the local industrial ecosystem.
KSL caters to a wide spectrum of industries with a strong focus on the highimpact sectors. In the Energy segment, the company supplies critical steel solutions to customers engaged in heavy engineering, and industrial equipment manufacturing. Similarly, in the Bearing sector, KSL is a key supplier to leading bearing manufacturers, supporting applications that demand high precision and reliability.
KSL’s Automotive segment represents a significant share of KSL’s customer base. It supplies to global and Indian OEMs across commercial vehicles, passenger vehicles, and two-wheelers. Its customers include several well-known automotive brands. KSL’s products are widely used in


vehicles, tractors, diesel engines, turbines, and seamless tube manufacturing. The company also supplies to the railways and general engineering sectors. Its strong customer-centric approach, ability to deliver application-specific steel solutions, and consistent quality have earned KSL long-standing international clients.
KSL’s R&D efforts focus on developing new steel grades, improving metallurgical properties, and enhancing manufacturing efficiency. Its strong emphasis on highquality, research and process excellence enables KSL to meet the evolving demands of high-performance applications. The company is backed by 100% in-house testing facilities equipped with state-ofthe-art instruments, along with a dedicated and highly experienced quality assurance team that ensures strict monitoring, quality control and process consistency. Also, continuous investment in technology upgradation, process optimisation and skill development, supported by strategic backward integration, enables KSL to exercise greater control over raw material quality and ensure consistency of inputs.
KSL strives for industry leadership through operational efficiency, capacity expansion, and optimal use of resources. Its backward and forward integration ensures strong control over raw materials and enables value-added offerings tailored to customer needs. By prioritising sustainability, innovation, and advanced technology, the company consistently enhances product quality and process efficiency. Its customer-centric approach delivers customised solutions, reliable support, and services, thereby reinforcing KSL’s reputation as a trusted end-toend supplier to the high-value sectors it serves.
KSL has earned several prestigious awards, including the National Award for Manufacturing Competitiveness (Gold Medal) from the International Research Institute for Manufacturing; the Global EHS Award for Best EHS Practices from Green Tech, Bangkok, Thailand; the National Award for Manufacturing Competitiveness (Gold Medal) for two consecutive years, and Ispat Suraksha Puraskar from JCSSI for four consecutive years.
PETRA Group has emerged as a globally active corporation with a strong focus on solving real-world challenges through technologydriven and socially responsible business practices. Headquartered in Malaysia, the group operates across multiple sectors including sustainable technologies, infrastructure, media, lifestyle, and research. Driven by the philosophy of social capitalism, PETRA Group aims to remain profitable while positively impacting people, communities, and the environment across the regions it serves

PETRA Group is driven by the belief that business success and societal wellbeing grow together. This belief is championed by its Chairman and Chief Executive, Datuk (Dr.) Vinod Sekhar, who has positioned social capitalism as the foundation of the group’s strategy. His approach promotes financial performance alongside responsibility towards employees, customers, communities, and the natural environment. The aim is not short-term
gain, but sustainable wealth creation that benefits all stakeholders connected to the group’s activities. Under his leadership, PETRA Group has expanded its footprint across Asia, Australia, Europe, and North America, and established operations in over nine countries. All ventures in the group believe that profit must go hand in hand with ethics.
PETRA Group draws its strength from a diverse portfolio of businesses,
united by a shared, solution-focused mindset. The group specialises in sustainable technologies, infrastructure & development, agriculture, lifestyle, media and entertainment, consulting services, news, research, and advocacy. While these sectors may appear varied, they share a commitment to addressing economic, environmental, and societal challenges.
Technology and innovation play a substantial role across all its enterprises. PETRA Group invests in advanced



systems and research-driven solutions that aim to improve efficiency, reduce environmental harm, and enhance quality of life. This focus has made the group a key player in industries vital for future growth.
One of PETRA Group’s most notable initiatives is Green Rubber, a division dedicated to addressing the global problem of discarded rubber tyres. Billions of tyres are thrown away each year, creating serious environmental hazards.
Green Rubber has developed and patented a technology that transforms used tyres into renewable resources. This process not only reduces landfill waste but also creates valuable materials that can be reused across industries. By addressing both environmental damage and resource scarcity, Green Rubber reflects PETRA Group’s broader commitment to sustainable technologies that deliver practical, long-lasting solutions.
Affordable and sustainable housing is a pressing issue in many parts of the world. PETRA Modular, a subsidiary of the group, addresses this challenge by constructing high-quality modular homes using ecofriendly technologies. These homes are designed to be versatile, durable, and cost-effective, without compromising on safety or comfort.
PETRA Modular has successfully completed projects across Asia, Australia, and Europe, demonstrating the scalability of its construction model. The company’s work supports communities by providing housing solutions that meet modern needs while reducing environmental impact.
Apart from infrastructure and sustainability, PETRA Group has also built a strong presence in media and entertainment. PETRA Media serves as the umbrella organisation for PETRA Entertainment, PETRA Films, and PETRA Studios. The division creates and distributes film and TV content through cinemas and digital platforms.
The group also owns Ablemen Communications, a branding and marketing agency that offers strategic communication services. Through media,
storytelling, and brand development, PETRA Group aims to influence public discourse and support businesses in building meaningful connections with their audiences.
Infrastructure development is another key area of focus for PETRA Group. The group works on creating safe, healthy, and sustainable infrastructure solutions designed for long-term use. Advanced technologies are used to improve productivity and operational efficiency, benefiting both local communities and large-scale developments.
These projects are aligned with the group’s belief that infrastructure should not only support economic growth but also improve quality of life. By addressing safety, sustainability, and profitability together, PETRA Group contributes to responsible development across regions.
PETRA Group’s efforts have gained prestigious recognitions from several esteemed regional and international bodies. In 2022, the group received the Asia Responsible Enterprise Awards (AREA) from Enterprise Asia in the Social Empowerment category. This award highlighted PETRA Group’s commitment to social responsibility and inclusive business practices.
In the same year, Singapore Business Review honoured PETRA Group at the Malaysia Technology Excellence Awards for its innovative technologies and application of social capitalism principles.
PETRA Group’s consistent mission is to elevate and positively impact the lives of people and communities it connects with, while remaining commercially successful. The group’s enterprises operate within a solution-centric framework to seek better ways to address real-life problems.
With a growing global presence and a clear ethical foundation, the group represents a model of modern enterprise where innovation, social responsibility, and profitability work together. As economic, environmental, and social challenges grow more complex, the group’s purpose-driven approach demonstrates how businesses can act responsibly and play a meaningful role in building a sustainable and inclusive future.
The Modern Group, an African conglomerate founded in 2015, is one of the leading industrial players in Uganda. With 10 factories operating across the country and a total investment of over $200 million, the group has made a significant contribution to local manufacturing, import substitution, job creation, and national revenue growth
ver the years, the Modern Group, under the stewardship of its Chairman, Mr. Ashish Monpara, has expanded across diverse sectors. He first visited Uganda in late 2015. During his visit, he was deeply moved by the country’s natural beauty and peaceful atmosphere. This experience, along with thorough research into regional markets, led him to choose Uganda as the home for his longterm investment plans.
He noted that Uganda offered a stable political, economic, and social environment with strong potential for industrial growth. He launched his




first project, Modern Distillers Ltd, in December 2015, marking the beginning of an ambitious venture that steadily grew to become a major industrial group in the country.
Since that time, the Modern Group has built a wide range of industries, including gas, aluminium, fertilisers, sanitisers, tiles, sugar, power, and beverages.
One of the group’s most significant projects is Modern Tiles, based in Njeru, Buikwe District. The tile plant currently produces 49,000 square meters of tiles per day and is being expanded to reach a full capacity of 150,000 square meters per day. This factory not only serves the local market but also targets exports, helping to boost foreign exchange earnings and elevate Uganda’s standing in the regional market.
Under Mr. Monpara’s direction, the Modern Group has also entered into a production agreement with Lamborghini Drinks & Beverages. The venture focuses on producing premium beverages for export to the United States and Asian markets. This collaboration highlights Modern Group’s string global alliances and its committment to positioning Uganda as a hub for world-class products.
The Modern Group is actively expanding its investment footprint. A $50 million refined and industrial sugar project is currently underway in Buyende District. Plans are also in progress for a $200 million iron ore steel plant in Muko, where ore samples tested in Austria showed excellent results. Additionally, the group is exploring the establishment of a $100 million pharmaceutical and vaccine manufacturing plant to support regional health systems.
In the long-term, Modern Group aims to remain focused on producing high-quality products for supporting Uganda’s local communities, and expanding its reach in international markets.
Sustainability is a core value at Modern Tiles. The factory incorporates ecofriendly manufacturing practices, responsible material sourcing, and energy-efficient technologies to reduce environmental impact and promote green industrial growth.
Other than production, the Modern Group plays a key role in job creation and local empowerment. The group employs over 2,000 Ugandan youth directly and supports the livelihoods of nearly 20,000 individuals indirectly. Its operations have helped reduce Uganda’s dependence on imports and strengthened domestic production capacity across multiple sectors.
Modern Group’s commitment to quality has earned it numerous awards. Its tile plant was recognized as the Superbrand of East Africa for three consecutive years — 2022, 2023, and 2024. The Group also received the Manufacturing Excellence Award from the Ministry of Trade, Industry, and Cooperatives in 2022. It also won the East Africa Brand Quality Award for its aluminium and tile products. The most prestigious of all was the Best FDI Award for its tile plant at the Global Investment Awards held in the UAE in April 2023. This recognition, achieved among 170 participating countries, marked the first time Uganda had won this international award in the event’s 12year history.

WattPower is one of India’s leading solar technology providers. Established in Germany in 2013, the company has steadily advanced solar innovation through its involvement in global projects, exposure to cutting-edge technologies, and adoption of international best practices in clean energy
Founded in India in 2022, WattPower has become a key player in the country’s smart photovoltaic solutions sector, specialising in solar inverter manufacturing and hybrid energy systems. Serving utility-scale, commercial, and industrial segments, the company achieved 100% year-on-year revenue growth between 2023 and 2024. With a commitment to continuous improvement and uncompromising quality, WattPower directs its investments toward precision engineering and technological refinement. Renowned for reliability, efficiency, and intelligent design, the company’s solar inverters enable seamless conversion of solar energy into usable electricity. Built for longevity, they function for up to 25 years with minimal moving components. WattPower’s patented design enhances both safety and performance by eliminating DC-side failures, which are responsible for nearly 74% of safety-related incidents

in photovoltaic plants.
WattPower initially operated as a distributor for Huawei inverters in India before shifting to direct sales following Huawei’s market exit. The company continues to service and maintain Huawei’s extensive network of installed inverters across the country. It was also the first organisation to introduce string

inverters in utility-scale solar projects. Since establishing its manufacturing facility in Tamil Nadu in 2023, WattPower has produced and supplied approximately 15 GW of solar string inverters. The plant has an annual production capacity of 10 GW and manufactures high-performance models, including the 330KTL series. With an investment of around USD 172 million during its initial phase, the Chennai-based facility is expected to generate nearly 180 direct and indirect employment opportunities. Spanning 3.5 acres, the site dedicates 40 percent of its area to green cover.
WattPower recently secured one of the largest contracts in the solar inverter sector, valued at ₹200 crore. The agreement, which further consolidates the company’s presence in the market, involves supplying 1.2 GW of string inverters to ReNew Power, India’s leading renewable energy developer by installed capacity. Through its high-efficiency string inverters and smart array controllers, the company has enabled the generation of 4.12 billion kWh of clean electricity, preventing 1.78 million tonnes of carbon dioxide emissions, the environmental equivalent of planting 2.43 million trees. With clients like Adani Green Energy, Avaada Energy, Greenko, and MEIL, WattPower has expanded its stakeholder base by over 40%, while driving multiple large-scale solar installations across India’s clean-energy sector.
Wattpower delivers over 500 solar projects each year, with over 100 additional installations in development. It now plans to enter the power-storage domain while reinforcing its technical and service division. The company also aims to achieve a 24-hour response time for service requests nationwide and increase its workforce by 30% across departments. These initiatives reflect its commitment to building strong capabilities and improving operational excellence, paving the way for sustained growth in India’s evolving solar-energy ecosystem.
WattPower received the Best Inverter in the Utility Segment award at the Global Solar Expo 2025, and was recognised for innovation at the CII Industrial Innovation Award 2024. The company was also acknowledged for leadership at the ET Energy Leadership Award 2024.

Rishabh Group, over the years, has diversified to become a multi-business organisation with interests spanning electrical and industrial products, real estate development, instrumentation and engineering solutions. With a keen focus on quality and sustainability, the group has built a longlasting reputation as a trustworthy and customer-focused innovator. Established with a vision for the future, Rishabh Group has not only developed world-class infrastructure and technology-driven solutions but also created lasting societal value through responsible leadership.
From humble beginnings, Rishabh Group has become a leading name in engineering precision because of its wide array of innovative products. Its electrical and instrumentation products support global industrial operations, with standardscompliant solutions that enhance efficiency and promote energy conservation.
Rishabh Group, led by Group CEO and Executive Director, Mr. Dinesh Musalekar, has redefined modern living with marvellous residential and commercial projects that reflect superior architecture and sustainable design. His commitment to quality, transparency, and timely delivery has earned the group widespread customer trust.
Purposeful innovation is what sets Rishabh Group apart. With continuous research, advanced manufacturing, and a skilled workforce, the group ensures every solution meets customer expectations while promoting a greener and sustainable future. Its global presence reflects India’s growing industrial strength and highlights the Group’s vision to become a world-class organisation.


Rishabh Group’s success is guided by the philosophy of “Building Trust Through Performance.” Whether engineering, power, or real estate, its undertakings are tailored to generate long-term value for society without ever compromising on quality.
Rishabh Group, driven by a vision for an empowered, energy-efficient, and sustainable India, is a diversified conglomerate excelling in electrical, power, real estate, and technology sectors. Over the years, it has built a strong legacy of innovation and integrity, besides contributing to the India’s industrial growth that end, it participates vigorously in community development in the fields of education, health, environment and social advancement. It also focuses on reducing carbon footprints, conserving resources, and promoting green practices, while supporting India’s industrial infrastructure and aligning its growth with national development.
Every decision at Rishabh Group is driven by integrity and excellence. Its management promotes innovation, cooperation, and continuos enhancement throughout the organisation. Employees are nurtured through training and exposure to create a culture where ideas thrive and performance speaks louder than promises. This strong ethical approach has helped Rishabh Group build lasting relations with its partners, clients, and stakeholders.
Rishabh Group actively participates in CSR activities. It believes that true progress lies in empowering others. To
Rishabh Group was honoured with the Sardar Patel Unity Award 2025 for Excellence in Sustainable Materials for Energy Efficiency by the Topnotch Foundation in Goa. The award was presented by the Hon’ble Chief Minister of Goa, Dr. Pramod Sawant, and Union Minister Shri Shripad Naik. Additionally, Mr. Musalekar has been honoured with several accolades, including the Highest Civilian Honour from the Mayor of Zielona Góra, Poland, and the Indian Achievers Award for Business Leadership from the Indian Achievers Forum.

Founded in 1958, APAR has evolved from a modest power conductor manufacturer into a global leader in electrical and energy infrastructure space. Renowned for its pioneering spirit, the company has embraced technological innovation and market expansion, extending its presence to over 140 countries worldwide
Apurpose-driven enterprise, APAR’s journey began under the leadership of Shri Dharmsinh Desai, whose foresight established a culture of engineering excellence and enduring value. Through successive phases of growth, the organisation has continuously strengthened its capabilities to meet emerging technologies and global demand, while retaining its Indian manufacturing DNA. As the brand enters its next chapter, focused efforts in marketing and communication, spearheaded by Ms. Gaurangi Desai Mehra, are helping the company focus on delivering superior, sustainable, and socially responsible solutions, thus fulfilling its mission of providing “Tomorrow’s solutions today” for a brighter future.
Today APAR operates 10 advanced manufacturing facilities across India and

one in Sharjah, UAE. These world-class facilities empower it to deliver a diverse range of products, including conductors, speciality oils, lubricants speciality cables, crafted to meet the highest global standards. Each facility enables the company to serve utilities, industries and infrastructure developers across continents.
Listed on India’s Bombay Stock Exchange and the National Stock Exchange since 2004, APAR has demonstrated consistent
performance and governance. Over the years, the company has strengthened its global presence while investing steadily in technology and people. Its vision is to deliver solutions that make energy systems more efficient, safer and environmentally responsible. With its focus on engineering strength, ethical practices and long-term value creation, the brand delivers on its promise of “Tomorrow’s solutions today,” thus reinforcing India’s role in building reliable global infrastructure.
APAR places strong emphasis on responsible operations and social commitment. Certified as a Great Place To Work™, the company employs over 2,000 people and promotes a culture driven by innovation, accountability, leadership and entrepreneurial thinking. Its CSR initiatives support healthcare, education, rural development, gender equality, and inclusive growth, fostering positive impact in communities surrounding its facilities. APAR drives India’s future through R&D, global best practices, technology, and environmental stewardship, thus creating stakeholder value, supporting economic growth, and aligning with the Atmanirbhar Bharat initiative. The brand enhanced its sustainability efforts by raising renewable energy use to 36%, cutting water consumption by 21%, reducing energy intensity in cable plants by 8%, and lowering Scope 1 and 2 emission intensity by 12% in FY 2024-25, reflecting its strong commitment to minimising environmental impact and promoting ESG-driven growth.
APAR is the world’s largest manufacturer of aluminium and alloy conductors and India’s largest exporter of speciality and renewable cables. It is also India’s largest and the world’s third-largest producer of transformer oils, a segment critical to reliable power transmission. Notably, APAR is the first and only Indian company to offer end-to-end solutions in copper and fibre hybrid cables. Through these efforts, APAR contributes to inclusive growth and aims to bring long-term benefits to society.
Over years, APAR has earned several prestigious accolades. It ranked 154th on the Fortune 500 India list in 2024 and 155th on the ET 500 India list in 2023, and was named ET NOW’s Iconic Brand of India in 2025.

n 1974, a visionary microbiologist Dr. Gangadhar M. Warke, along with his wife Mrs. Saroj G. Warke and brother Mr. Vishnu M. Warke, founded HiMedia as a modest venture to provide affordable culture media. Over the past five decades, the organisation has evolved into a global enterprise that develops, manufactures, and markets over 30,000 bioscience products. Headquartered in Mumbai, HiMedia has established offices and warehouses in Europe, the USA, and Brazil, ensuring seamless accessibility for scientists, researchers, and healthcare professionals across the globe. It has a strong presence in over 150 international markets, including Japan, Brazil, the Middle East, the USA, and Africa.
Celebrated as the “Pride of India,” HiMedia revolutionises research by replacing expensive imports with high-quality, affordable products. By channeling profits into R&D, the company drives innovation and technological excellence. It is currently undertaking a fivefold expansion of ready-prepared culture media plate production.
HiMedia’s serum-free and animalcomponent-free cell culture media, such as HEKin1™ and CELLin1™, supports global vaccine production against diseases like COVID-19 and Foot-and-Mouth Disease. Its cell biology wing pioneers bioink development for 3D bio-printing and media cultivated meat manufacture. During the pandemic, HiMedia played a vital role by producing and supplying Swab Sample Collection Kits, Viral RNA Extraction Kits, and Multiplex PCR Detection Kits. Its innovations include Insta NX® Mag, India’s first CDSCO-approved automated platform for rapid nucleic acid extraction, capable of processing up to 96 samples in 11–30 minutes, and the Insta NX® Geno


HiMedia, driven by advanced in-house R&D, is India’s first globally recognised biosciences brand. It pioneers innovations across microbiology, cell biology, molecular biology, immunology, animal health, hydroponics, and agrobiotechnology, reflecting India’s rising prominence in the global biosciences sector CSR programs supporting regenerative medicine, healthcare, rural education via Ishavidya, and STEM outreach. The company has further strengthened its research-based initiatives by collaborating with IIT Bombay’s Wadhwani Research Centre for Bioengineering to launch the WRCB-HiMedia Bio-Innovation Laboratory.
series, a flexible PCR workstation for automated workflows. Its HiPetriSlim™ plates have improved microbial testing efficiency in food and pharmaceutical industries, while its range of HiVeg products, high-quality ready prepared media, including HiCrome® enable rapid & precise microbial differentiation through chromogenic technology. Partnering globally in probiotic research and advanced instrumentation like ANOXOMAT® III and MALDI-TOF MS, HiMedia drives innovation in microbial identification and empowers researchers with nextgeneration microbiological solutions. HiMedia is advancing intuitive medicine with PCR-based antimicrobial resistance detection kits, bioinformatics for sequencing, gene mapping, and AI diagnostics, while its Higronics division supports smart and hydroponic farming.
HiMedia drives social impact through
HiMedia’s committment to innovation and excellence has earned it several prestigious accolades such as the Hurun Award 2024, BioSpectrum’s Best Innovator for COVID-19 Solutions, and the BIRAC Innovator Award-2020. The organisation has also been recognised amongst the top 3 global microbiology media manufacturers, by the prestigious ‘American Society of Microbiology’, in their ‘Handbook of Microbiological Media.’ It has also received the Rajiv Gandhi National Quality Award for outstanding quality and innovation.

At Apex Buildsys Limited, we are specialists in structural steel engineering, delivering integrated steel solutions and pre-engineered buildings (PEB) at scale. We aspire to be the world’s most reliable partner for manufacturing, services, and structural solutions — driven by engineering excellence & execution certainty
Our mission is to consistently deliver high-quality outcomes by fostering a culture of continuous improvement, ethical conduct, and responsible corporate citizenship. We aim to create lasting value for our customers while ensuring sustainable growth, trust, and long-term returns for all stakeholders.
Established in 2006, we integrate civil engineering, advanced structural design, precision fabrication, and strong project management to deliver efficient and highquality construction solutions. Our end-toend approach, supported by deep technical expertise and practical execution, enables us to consistently meet industry standards and exceed client expectations across diverse projects.
We operate one of India’s largest machine-installed steel facilities in Nagpur, Maharashtra, ensuring smooth execution

from design to project completion. Our portfolio includes prefabricated structural members, profiled metal sheets, insulated panels, and composite deck sheeting, all engineered for high performance, durability, and long-term reliability across applications.
Over the years, we have delivered landmark projects across diverse sectors, including stadiums, industrial facilities, aircraft hangars, shipyards, supermarkets, and metro infrastructure. Our execution
portfolio features complex metro stations and depots, refineries, logistics parks, and large-scale pre-engineered building (PEB) complexes. Each project is executed with meticulous planning, strong coordination, an uncompromising focus on safety, and a proven ability to deliver on time, even under demanding conditions.
Engineering precision and operational discipline are at the core of everything we do. We specialise in heavy steel fabrication, producing large and complex components for industrial plants, bridges, and critical infrastructure. Every structure is built to meet stringent standards of durability, safety, and structural strength, ensuring long-term performance in challenging environments.
Our pre-engineered building solutions are designed, manufactured, supplied, and erected to meet exact client requirements. Known for their flexibility, cost efficiency, and long service life, our PEB solutions are widely used for factories, warehouses, logistics hubs, and commercial developments. By combining smart design with efficient fabrication and erection practices, we help clients achieve faster project timelines without compromising on quality.
Our manufacturing ecosystem reflects scale, advanced technology, and operational efficiency. Equipped with modern machinery, automated systems, and precision-driven processes, our facilities maintain rigorous quality benchmarks at every stage of production. Continuous process optimisation allows us to improve productivity, reduce lead times, and deliver consistent results across large and complex orders. Skilled teams and robust quality control systems ensure that every component leaving our plants meets exacting standards.
Our committment to engineering excellence and execution rigour has been recognised across the industry. We are recipients of the CIDC Vishwakarma Award for Outstanding Construction Practices, the Construction Times Award for Excellence in Pre-Engineered Buildings, and the Golden Aim Award for Best Infrastructure Project Execution — affirming our leadership in quality, innovation, sustainability, and project delivery.
Kansai Plascon’s product philosophy is driven by quality, responsibility, and purposeful innovation. Every solution is created with a clear focus on performance, safety, and environmental care. This approach is reflected across all its core business sectors.
Kansai Plascon’s Decorative Coatings are designed to improve daily life through innovation. From washable and stainresistant paints to scratch-resistant and eco-friendly options, the company delivers solutions that are safe, sustainable, and high performing. Its products are developed to enhance well-being while maintaining exceptional durability. By prioritising low VOC content and lead-free formulations, the brand ensures its paints are environmentally responsible. Each launch introduces new improvements that support a sustainable future, reflecting the company’s ongoing commitment to advancing industry standards.
Kansai Plascon’s Industrial Coatings meet diverse needs across manufacturing and infrastructure sectors. Designed for durability and corrosion resistance, these coatings also adhere to strict environmental standards. The company implements advanced processes to reduce carbon emissions, water usage, and waste production while maintaining superior product performance. Every batch is developed with precision to handle extreme conditions and meet client-specific requirements, making Kansai Plascon a trusted partner for industries that demand both reliability and responsibility.
In the automotive sector, the brand provides coatings that ensure rust prevention, longevity, and vibrant colour retention. Through collaboration and onsite technical support, it helps partners reduce life cycle costs while maintaining high quality. The products are formulated to endure rigorous operational conditions, providing both aesthetic and functional


With over 130 years of expertise in paints and coatings, Kansai Plascon Uganda Ltd. has earned a trusted reputation across Africa. Apart from creating highquality products for Industrial, Automotive, and Decorative sectors, the company makes a meaningful difference in the communities where it operates
benefits. By integrating sustainability into every step of production, Kansai Plascon demonstrates that environmental responsibility can coexist with industryleading performance.
Green is not just a colour but a guiding principle for Kansai Plascon. Sustainability is embedded in the company’s operations, with ISO 9001, ISO 14001 and ISO 45001 certified management systems implemented across its production facilities in Uganda. It actively reduces electricity and water consumption while implementing environmentally considerate manufacturing processes. Its Green Handbook showcases a comprehensive approach to ecofriendly solutions, covering compliance, sustainability, and production. By consistently innovating in green coatings, it ensures the future remains environmentally responsible.
Kansai Plascon invests significantly in social initiatives, particularly education, healthcare, and culture. It supports underprivileged schools, hospitals, and religious and cultural institutes by improving infrastructure and providing learning resources. Most notably, in 2025, the organisation contributed funds to send 100 children to India for heart surgeries.
Kansai Plascon Uganda has earned multiple prestigious accolades, including the MEA Business Awards 2024, Best Paint & Coatings Manufacturer at the People’s Choice Awards 2024, recognition for Environmental Sustainability by NEMA, and Best Paints & Coatings Brand – East Africa 2025 at the MEA Markets Excellence Award. These honours reflect the organisation’s dedication to quality, innovation, and sustainability across the continent.

Clean spaces lead to healthy lives — and Livexpo Ventures Pvt. Ltd. is on a mission to make both possible. As a new-age leader in cleaning and hygiene, its flagship brand FRESHER® offers high-performance, sustainable products for homes, industries, and institutions that value results and responsibility
Livexpo has steadily evolved from a young start-up into a trusted name in India’s cleaning and hygiene sector. It integrates scientific formulation with strict quality standards to create products that are powerful on grime yet gentle on the environment. Under the stewardship of its Founder and CEO Dr. Navneet Vats, the brand aims to build on its mission of creating a cleaner and healthier tomorrow based on honesty, innovation, and care.
Its brand FRESHER® offers a complete range of cleaning and disinfecting products used in households, hospitals, transportation systems, and large organisations. Renowned clients such as Indian Space Research Organisation (ISRO), Indian Air Force, Indian Navy, Indian Army, Defence Research and Development Organisation (DRDO), Indian Railways, Delhi Metro Rail Corporation (DMRC) and AIIMS trust Livexpo for its

consistent quality and reliability.
Livexpo’s growth is driven by transparency, discipline, and innovation. From its early days as a bootstrapped start-up, the company has stayed true to its ethics and commitment to customer trust. Every FRESHER® product is thoroughly tested and meets international safety and sustainability standards. The company’s marketing and outreach strategy have

also played a key role in its success. The company’s marketing and outreach initiatives continue to strengthen its presence. Livexpo is building its digital and distribution networks, with supplies already reaching over 120 locations across India.
Sustainability is the topmost priority at Livexpo. With science and conscience at its core, the company strives for a cleaner, safer, and greener tomorrow. Every stage of production, from formulation to packaging, reflects ecofriendly thinking. Its cleaning solutions use responsibly sourced ingredients that deliver exceptional performance while minimising harm to the planet. The company’s facility features gravitybased filling lines, natural lighting, and rainwater harvesting systems, which reduces resource use and operational waste.
Livexpo’s dedication to responsible manufacturing is backed by a long list of global certifications, including CII GreenPro, ISO 9001, ISO 14001, ISO 14025, GMP, GDP, HACCP, HALAL, and KOSHER. These accreditations represent its core belief in “performance with responsibility.” The company also invests in workshops, training sessions, and awareness programs to promote sustainable hygiene practices among distributors and institutions.
With the goal of delivering “Smarter Cleaning. Superior Results,” Livexpo is steadily expanding its reach across India and global markets, besides strengthening its distribution network. It strives to drive innovation via digital tools, green chemistry, and eco-friendly packaging to deliver sustainable cleaning solutions for global consumers and businesses.
Livexpo has been honoured with Top 10 Most Promising Household Cleaning Brands in India 2025 by Homes Magazine, Entrepreneur of the Year 2025 by Business Outreach Magazine, India’s Leading Ecofriendly Cleaning Solutions Brand 2025 by Business World Eureka Magazine, and Best MSME Award by India5000 Magazine. The brand’s cover story was featured among Inspirational Icons to Watch in 2025 by Insight Success Magazine. These achievements highlight Livexpo’s rising reputation as a reliable brand committed to excellence.
Rooted in precision and accountability, 1st Glove has set a benchmark in producing nitrile and specialised gloves for industrial, healthcare, and consumer segments. Over the years, the company has broadened its global footprint and earned recognition for its reliability, resilience, and comfort. Under the leadership of Sunil Kumar Patwari, 1st Glove has strengthened its global presence significantly. His emphasis on technological progress and environmental responsibility has shaped a forwardlooking enterprise in the protective equipment domain. From research-led material selection to advanced automated manufacturing, every stage of production reflects the brand’s focus on quality.
Nitrile examination gloves are used to provide a durable, chemical-resistant, and latex-free barrier for safe handling in medical, laboratory, and hygiene applications.
Through a measured integration of automation, robotics, and environmentally conscious systems, 1st Glove has modernised production without losing precision. Its advanced facility uses energy-efficient equipment to curb waste and reduce environmental impact; this reflects a long-term aspiration for a safer and cleaner future. Driven by integrity, ingenuity, and inclusiveness, the organisation keeps perfecting its expertise. Its talented team of engineers, designers, and technicians ensures each glove reflects the brand’s trusted quality.
Known for its strong social conscience, 1st Glove incorporates environmentally responsible practices throughout its operations. It recycles water, uses biodegradable materials, and keeps



Guided by the conviction that “protection drives performance,” 1st Glove has become a globally trusted manufacturer of superior hand-protection solutions. The company emphasises safety, sustainability, and craftsmanship, setting industry benchmarks for precision and innovation in the industrial glove sector through smart technology, the company is advancing research into AI-enabled inspection systems and next-generation protective materials. The company is equally broadening its footprint across Europe, North America, and high-growth Asian markets to offer tailored handprotection solutions that address diverse industrial needs. Also, its foresight in design is shaping its upcoming range of sensor-integrated gloves capable of detecting temperature shifts, chemical exposure, and comfort variations. Such developments are poised to establish new benchmarks in occupational safety.
emissions tightly controlled. These practices reflect its Protection Beyond Hands philosophy that cares for both people and the planet. By partnering with local communities, the company promotes safety awareness besides supporting health initiatives. Additionally, it has built lasting trust among clients and employees through steady job creation, employee welfare programs, and fair labor practices. Ethical sourcing anchors every stage of production, ensuring that human rights, safety, and environmental considerations are observed with diligence. Built on such principles, the enterprise stands not merely as a producer but as a conscientious global participant that contributes enduring value to society.
By leveraging innovation and sustainability, 1st Glove has set the stage for a safer, smarter, and more responsible industrial future. With an ambition to redefine safety
1st Glove aims to become a global leader in innovative and environmentally responsible protection solutions. Its mission is to ensure workers across the globe experience lasting confidence, comfort, and safety. Guided by ethics and a commitment to excellence, the company remains dedicated to protecting what builds the future—the hands.

Amber Group, founded in 2015 in Jamaica by Mr. Dushyant Savadia, began with a simple yet powerful idea of using technology as a force for good. Driven by compassion, innovation, and integrity, the company has grown from a small startup with a humanitarian purpose into a global technology hub operating across more than 100 countries and five continents
Amber Group is known for its technological excellence and unrelenting commitment to improving lives. Every business within the group operates with the mission of making a meaningful impact through innovation and social responsibility. From mobility and payments to aviation and cyber security, Amber’s ventures reflect a balance of progress and purpose.
One of Amber’s most transformative innovations is Amber Connect, an AIpowered vehicle telematics and security solution, which has completely redefined how people interact with their vehicles. This app helps users track their cars in realtime, view detailed trip reports, manage fleets efficiently, and even reconstruct accidents using historical data. Businesses use it to improve logistics, while individuals rely on it for safety and peace of mind. Adding to this innovation is Amber Vision, an innovative video telematics solution that streams live, high-definition footage from

vehicles. With advanced driver monitoring and assistance systems, such as Advanced Driver Assistance Systems (ADAS) and Driver Monitoring Systems (DMS), it ensures safer driving and smarter fleet management for companies across the world.
While Amber Connect focuses on mobility, Amber Fuels brings together convenience and technology, thereby transforming how we think about refuelling. It ensures cashless, digital transactions with instant e-invoices and detailed expense analytics. Through the use of RFID-enabled payments and a feature-packed mobile app, customers can refuel their vehicles and pay instantly and safely. Whether it’s gasoline, LPG, or aviation fuel, Amber Fuels makes it effortless. The app also includes a rewards program that makes every refill rewarding, while empowering customers with better insights into their energy usage.
Amber’s vision of simplicity extends to the world of finance through Amber Pay, a suite of payment platforms that make digital transactions seamless for individuals and
businesses alike. Whether it’s generating digital invoices, collecting payments through QR codes, or managing multiple payment modes from one super app, Amber Pay enables seamless financial transactions for everyone. In addition, Amber Rewards allows businesses to create their own loyalty programs or join a shared rewards network, helping them attract and retain customers. Combined with in-depth analytics, these tools help merchants grow smarter and customers shop more easily and confidently.
Amber Group also contributes to the spirit of adventure through Amber Aviation. The company offers recreational flying experiences in ultralight and light sport aircraft. Its Jet-Share program offers affordable access to private jets with flexible schedules and personalised service to make flying accessible. The goal is to create new jobs, train local pilots, and strengthen the aviation ecosystem across the Caribbean. Amber Ontime represents the company’s entry into the transportation sector through a 50% acquisition of On Time Taxi in 2024. By merging Amber’s technology expertise with On Time’s operational reach, the venture enhances ride-hailing through AI-driven analytics, mobile integration, and better customer experience while ensuring regulatory compliance and strong community engagement.
Education and empowerment have always been integral to Amber Group’s identity, and the Amber HEART Academy stands as an apt example of that vision. Established in partnership with the Government of Jamaica’s HEART/NSTA Trust, this initiative provides underprivileged youth with free, one-year residential training in high-demand digital skills, such as cybersecurity, mobile app development, and data analytics. Students receive full scholarships, including accommodation, meals, and equipment. On graduation, they are certified, connected with potential employers, and supported by its vast professional network. The program aims to train 20,000 young Jamaicans within five years, equipping them with the skills to thrive in the digital age. It’s a life-changing initiative that is helping to shape Jamaica’s future as a regional tech hub.
Amber Group has made significant acquisitions to strengthen its global presence. The acquisition of Night Vision, a U.S.-based


cyber security firm, adds advanced risk analysis, vulnerability assessment, and penetration testing capabilities to the group’s offerings. Similarly, Amber’s acquisition of Intelli Business Solutions in South Africa has reinforced its IoT capabilities. Through Amber IoT, the company builds custom hardware and firmware that facilitate smart, automated operations. Its newest division, Amber Robotics, marks a bold step forward, signalling Jamaica’s entry into global stage of robotics and advanced AI. It aims to make humanoid robots and intelligent automated systems accessible to developing nations. Media is another space where Amber Group is driving transformation. Under Amber Media, it operates platforms that modernise and democratise Caribbean broadcasting. Amber Radio offers access to over 30 radio stations, catering to diverse interests, while the Revo App brings interactive, digital-first news experiences to audiences. Likewise, Amber Gresham Music supports Jamaican musicians by helping them distribute their work globally and manage royalties efficiently. The acquisition of Nationwide News Network (NNN) further strengthens Amber’s media footprint.
Partnering with the Art of Living Foundation, Amber Group contributed US$5 million to education and humanitarian aid in Jamaica. It also launched Amber FundMe, a digital crowdfunding platform for entrepreneurs and social enterprises, and established the Amber UTech Launchpad with the University of Technology, Jamaica for supporting aspiring innovators with marketing, IT, finance, and legal resources. With a goal of creating 100 successful start-ups in 1,000 days, the journey is captured in a TV series celebrating Jamaican entrepreneurship. Unlike typical CSR models, Amber reinvests over 80% of profits into community development, youth empowerment, education, and national technology infrastructure, demonstrating that purpose and profit can go hand in hand.

Orchestro.AI is rebuilding artificial intelligence from the ground up. Here’s the problem nobody talks about: today’s AI systems like ChatGPT and others you’ve heard of, are amazing at demos but can’t actually be used where it matters most. An AI can pass a medical licensing exam but hospitals can’t legally use it to diagnose patients. An AI can analyse legal contracts but law firms can’t deploy it in actual cases. These systems are blocked from healthcare, banking, education, government—everywhere they could genuinely help people. Why? Because they were built to be impressive, not trustworthy
The problems are baked into how current AI works. These systems can’t explain their decisions—even their creators don’t fully understand how they arrive at answers. They give different responses to the same question because randomness is built in. And most importantly, they are trained to be powerful first, with safety added as an afterthought. Imagine hiring someone brilliant who sometimes makes things up, can’t explain their thinking, and gives you different answers each time you ask the same question. You wouldn’t trust them with anything important. That’s today’s AI. There’s another problem: companies don’t know how to deploy AI without getting sued or facing worker backlash. When a bank uses AI to decide loans, will it face discrimination lawsuits? When a factory uses AI for scheduling, will the union file grievances? When a hospital uses AI for patient care, will regulators shut it down? Current AI companies promise efficiency but ignore these realworld consequences. They sell dreams of automation while enterprises face nightmares of litigation, regulatory fines, and workforce disruption.
Orchestro.AI created something called the Human Index to solve this. It’s a simple score that tells you: Is this AI decision good for humans? Orchestro.AI measures five things: Does it eliminate jobs or help workers do better work? Does it take away human control or give people better tools? Can affected people understand and challenge the decision? Can humans override it when needed? Does it treat everyone fairly or favour some groups over others? When a company sees the Human Index score, they know whether deploying this AI will lead to lawsuits and protests or actually improve their operations. It’s like a nutrition label, but for AI decisions. This is what the brand mean by Humanic Intelligence—intelligence that remembers us. Instead of building powerful AI and trying to make it safe afterward, Orchestro. AI builds it to be safe from the start. Think of it like raising a child: you don’t let them develop bad habits and then try to fix them later. You teach good values from day one. Likewise, Orchestro.AI teaches its AI to care about human welfare as its primary goal, not as a rule to follow. Compassion, justice, and wisdom aren’t constraints it

adds—they’re what the system is designed to achieve. It’s not about preventing bad behavior but about building something that wants to do good.
Orchestro.AI’s system—MACI—uses the right tool for each job. Current AI is like using a hammer for everything—cutting, measuring, or painting. MACI is trained for 27 digital angels / virtues and ensemble of reasoning and symbolic models; some are perfect for logical problems, others handle uncertainty, while others focus on fair decisions. Using the right architecture makes it 1 million times more efficient. But more importantly, it can do things current AI can’t: explain decisions in plain language, give the same answer every time for the same question, show its reasoning step by step like a student solving a math problem, let humans verify its reasoning, and prove that decisions are fair and legal. These aren’t bonus features—they’re requirements for using AI in healthcare, banking, education, and everywhere else that actually matters.
Orchestro.AI is led by Shekhar Natarajan, who came to America with $34 in his pocket. His mother pawned her wedding ring to pay for his education. He spent 25 years running operations at major companies—growing Walmart’s grocery business from $30 million to $5 billion, negotiating with unions, managing thousands of employees. He didn’t just build technology; he learned how real organisations work, how workers react, how regulations function. Every morning at 4 AM, he paints intricate Indian art
where a single feather takes three hours. His philosophy: “You don’t solve hard problems by moving fast. You solve them by moving carefully, with love.”
The opportunity is enormous because the problem is everywhere. Every company trying to use AI hits the same walls: regulators won’t approve it, workers don’t trust it, lawyers fear the lawsuits, it can’t explain its decisions. Hospitals spend billions on AI they can’t use. Banks build algorithms they can’t help people. That’s every industry. That’s the entire economy trying to adopt technology that doesn’t work for real-world needs.
Billions have been invested in AI that looks impressive but can’t be deployed where it matters. The problem isn’t going away with the next version or the next breakthrough—it’s built into the foundation. You can’t take an opaque system and make it transparent by tweaking it. You can’t add human-centered values to systems that never considered humans except as obstacles. You have to rebuild from scratch, which is what Orchestro.AI is doing. Today’s AI asks, “What can we build?” and races ahead. Orchestro.AI asks “What should we build?” and take the time to build it right. Today’s AI treats humans as problems to work around. The company treats human dignity as the goal.
This is the world’s first Humanic Intelligence—intelligence that remembers us.

Finkeda is an Indian fintech company driving financial inclusion by enabling local merchants to offer digital banking and financial services in rural and small-town areas. By bringing services like EMI options, travel, and ticketing directly to people’s doorsteps, it makes financial access simpler and more convenient
Finkeda was established in 2019 by Mr. Manish Kumar Goyal with the purpose of making digital banking accessible to all, particularly in rural areas, which are commonly overlooked. The company is achieving this goal by collaborating with local shopkeepers, who represent the new face of financial services. Finkeda equips local merchants with the latest technology and support to offer a wide range of digital financial services— from utility and credit card payments to investment options. By providing a trusted, accessible alternative to traditional banking in smaller towns, the company is meeting rising digital demand and thriving under the leadership of Chairman and Managing Director Mr. Goyal.
Finkeda tackles the critical issue of financial inclusion by leveraging trusted community connections. It offers

diverse financial and digital services, including bill payments, travel bookings, insurance, investments, money transfers, FASTag, AePS, micro-ATMs, BBPS, cash management, and PAN services. The company’s mission is to make digital banking simple and accessible for everyone, especially in rural communities.
Finkeda aims to become India’s largest financial service provider by

revolutionising banking services in distant places and small towns. This communityfocused strategy is the key advantage for the company. The company is also on the verge of significant expansion, with upcoming initiatives like the launch of an innovative super app that will consolidate and improve its lending, investment, travel, energy bill payment, and insurance operations.
Through smart alliances and recurring events, Finkeda has created a powerful brand identity. It has partnered with renowned sports teams, such as Tamil Thalaivas Pro Kabaddi, Gujarat Titans Dabang Delhi Table Tennis Club, and Dabang Delhi Pro Kabaddi. Cricket player Shikhar Dhawan has also endorsed Finkeda as a brand ambassador. Also, the company actively engages in community projects in addition to sports, as seen by its collaborations with the Indian Army K5 Rally, the Gurugram Police Cyber Security Summer Internship 2025 (GPCSSI 2025), and the Gurugram Cyber Cell. The business is supported by private capital, and it is actively seeking new investors to strengthen its position in the market and speed up its growth.
Finkeda has grown rapidly since its inception, driven by a strong business model and impressive financial performance. With over 45,000 merchants onboard, the company has helped boost local incomes and businesses while enabling millions to access digital financial services. Facilitating more than 1.5 million transactions monthly, Finkeda’s impact is both widespread and measurable. It has earned prestigious recognition from esteemed organisations, including the Gujarat Titans, Haryana Police, Times of India Business Awards, Big FM Big Impact Awards, and the Global Brand and Leadership Conclave 2025.
Finkeda’s dedication to trust sets it apart from its competitors. The organisation has built strong, localised relationships with reliable shops, which encourages end consumers to use its product. It has dealt with initial uncertainties in these communities by creating confidence on both a personal and professional level through extensive training and support.
KaarTech has evolved through a purpose-driven approach into a timeless enterprise.
Founded in 2005 by Maran Nagarajan, the company saw substantial growth with the inclusion of Ratnakumar N, Selvakumaran M, and Gaurdian George. Their collective efforts and shared values have catapulted the company to new heights of success. Today, KaarTech is a 2,500-member organisation that has delivered over 3,200 SAP programs across 15 global offices. It stands out by addressing structural barriers such as legacy gravity, rigid regulations, switching costs, and organisational complexity, through a productized operating model that guarantees strong governance, delivery precision, and measurable outcomes. Backed by 38+ awards and four Great Place to Work certifications, KaarTech is shaping an IPO-ready, billion-dollar future through a high-density leadership cohort committed to long-term impact.
KaarTech follows a streamlined services philosophy driven by the belief that SAP Core forms the foundation of modernisation. Its advisory practice diagnoses legacy gravity, regulatory tension, and system fragmentation through structured assessments and transformation roadmaps, feeding insights into enterprise platform services that deliver S/4HANA, RISE with SAP, and GROW with SAP through a governance-led, productized model. Surrounding this core, KaarTech’s application services stabilise SAP and non-SAP systems, support organisational change, and ensure operational continuity. The company builds resilience through infrastructure and digital services, including cloud, security, compliance, and disaster recovery. Advanced digital capabilities across analytics, AI and ML, full-stack engineering, IoT, digital experience platforms, automation, and blockchain help clients improve processes


KaarTech is an enterprise transformation leader combining SAP depth, AI-driven execution, and engineered delivery to reduce complexity, scale modernisation, and advance toward an Enterprise Operating System built for measurable, outcome-led impact across global markets
and boost performance. This architecture is reinforced by its GenAI platform KTern. AI, which accelerates S/4HANA programs with smart automation.
KaarTech is redefining its GTM motion as it pushes beyond its SAP roots and enters a phase where technology adjacency becomes the engine of scale. The company enhances its S/4HANA edge while integrating AI, Salesforce, and ServiceNow into a broader transformation system, creating a value proposition built on engineered execution rather than effort. AI sits at the center of this shift, reshaping how advisory, delivery, and program orchestration operate, and giving KaarTech a consistent way to reduce complexity across markets with different maturity curves. Across MENA’s national programs, North America’s high-velocity verticals, and Europe’s complexityintensive enterprises, the company is
unifying its GTM around productized services, accountable leadership, and outcome-led delivery. KaarTech is moving beyond ERP consulting to an Enterprise Operating System, where forward deployed engineering, intelligent agents, and blueprint-driven execution deliver orchestrated, measurable, and outcomefocussed business transformation.
KaarTech’s social impact is led by Kaar Arakattalai, the company’s foundation dedicated to expanding educational access for underserved communities. It has supported over 11,200 children from farming families, war-widow households, and differently-abled communities. Originating in rural Tamil Nadu, the initiative is scaling nationally, reflecting KaarTech’s belief that enterprise success and societal progress must advance together.

With empathy and technological ingenuity at its core, Vertex Group delivers intelligent, human-centered solutions that help businesses thrive. Headquartered in New York, with a strong presence in Gurgaon, India, it has emerged as a trusted name in redefining digital transformation through integrity and inclusivity
Over time, Vertex Group has evolved into a leading enterprise across five dynamic verticals—Vertex Global Services, Vertex Next, Vertex Learning, ILC Solutions, and Vaani. Each division works toward a shared goal of helping organisations operate efficiently and achieve measurable results. Together, they provide end-to-end capabilities in digital consulting, technology integration, customer experience optimisation, and workforce development. The group’s philosophy emphasises the seamless integration of human intelligence (HI) and artificial intelligence (AI) to drive agility and create lasting business value.
Under the stewardship of its Founder and President, Mr. Gagan Arora, the company nurtures an ecosystem where technology and creativity converge to produce tangible results. Its portfolio includes AI-based automation tools, bilingual voice solutions, digital advisory services, omnichannel CX

frameworks, and adaptive learning platforms that strengthen enterprise performance across industries. Among its proprietary developments, V Assist stands out as an AI co-pilot delivering real-time analytics, sentiment mapping, and contextual recommendations designed to elevate efficiency and customer engagement.
The success of Vertex Group stems from its people-centered philosophy that shapes

every internal practice and external partnership. The organization values workforce empowerment, diversity, and continuous learning as essential components of its growth model. Regular upskilling sessions, mentorship initiatives, and creative programs encourage analytical thinking and leadership across all levels. A culture of open communication fosters collaboration and transparency, ensuring that every perspective receives due attention.
The company also strives to create measurable social impact through inclusion and purpose-driven engagement. Its corporate social responsibility (CSR) initiatives promote equitable growth by supporting education, digital literacy, and community development. Through its vertical, Vaani, the group expands access to learning and digital tools for underserved populations while running awareness and skill-building programs for youth. This balanced pursuit of corporate achievement and social advancement underscores the company’s belief that progress acquires true meaning when shared with the larger community.
The group has achieved steady financial growth through strong client retention, diversified services, and expansion into new markets. With a customer-focused approach, the company has built solid partnerships, while its investments in AI-powered customer experience platforms and unified learning systems have enabled enterprises to adopt advanced technologies seamlessly. Looking ahead, Vertex aims to expand its footprint across North America, Europe, and Southeast Asia while strengthening its role in India’s growing digital economy.
Vertex Group’s eco-conscious initiatives include paperless operations, responsible resource utilisation, and energy-efficient workspaces across its global locations. Continuous automation and investment in data-driven systems help reduce waste while amplifying productivity.
Over the years, Vertex Group has been honoured with several prestigious awards and accolades, including India’s 5000 Best MSME Award, the Best Innovative Enterprise title at the 2024 MSME & StartUp Conclave, Brand Opus India’s 2020 honour, a global ranking among the Top 50 Innovative Companies, and key partner awards from technology leaders like Hitachi Vantara and HP.

Built on the values of integrity, reliability, and service excellence, ArMee Infotech has built a strong identity and positioned itself as a key enabler of India’s digital and green future. The organisation’s growth story is nothing short of remarkable. Between FY21 and FY24, it achieved a revenue CAGR of over 117%, crossing the milestone of ₹ 1000 crore in annual revenue, all without external funding. Its unbilled revenue stood at an impressive ₹ 232.8 crore by FY24, backed by a robust receivables portfolio. Presently, ArMee Infotech is focusing on diversifying into three new verticals and planning the launch of 100 Acer Plaza retail outlets across India. These initiatives demonstrate the company’s ability to balance ambitious expansion with sustainable, client-centric solutions, ensuring its relevance in a fast-paced market.
Mr. Ridhish Patel’s stellar leadership has been instrumental in shaping ArMee Infotech’s vibrant culture. His peoplefirst and technology-forward philosophy empowers teams with autonomy, encourages lifelong learning, and drives excellence. Such immaculate leadership has enabled the company to deliver highquality projects swiftly while exploring new growth areas.
ArMee Infotech’s strength is reflected in the quality of its services. As a leader in system integration, the company handles large-scale government and enterprise projects from design to deployment with precision. Its IT infrastructure solutions deliver secure, reliable networks and state-of-the-art data centres, thereby empowering clients with operational efficiency and digital readiness. Apart from technology, ArMee Infotech


ArMee Infotech, founded in 2003 by Mr. Ridhish Patel, is a top-tier public limited company set for a mainboard IPO. Operating from 14 locations across India, the organiosation stands out for driving innovation in IT infrastructure, system integration, and digital transformation for government and BFSI clients the organisation ensures that these initiatives benefit communities for years to come. Its green energy projects and employability initiatives further strengthen its reputation as a brand that cares for people and progress.
is making its mark in renewable energy through solar EPC projects that align with India’s clean energy goals. Additionally, its skill development programs enhance employability by bridging the digital divide and promoting inclusive growth. In addition, its ventures into eSports infrastructure and retail highlight its forward-looking approach to addressing modern business and consumer needs.
ArMee Infotech’s commitment to creating a lasting impact in society is evident in projects such as Gujarat’s E-gram Vishwagram, Gyankunj, and central government initiatives like Samagra Shiksha Abhiyan. These programs have enabled ICT labs, smart classrooms, and digitised welfare systems, improving transparency, accessibility, and educational outcomes. Additionally, by prioritising safe, durable, and future-ready designs,
In 2023, ArMee Infotech won the “Best National System Integrator - Highest Revenue Government Business” from Acer India, for its leadership in public sector projects. It also received the Top Seller in the Woman Entrepreneur category on the Government e-Marketplace, which was presented by Minister Piyush Goyal. Besides highlighting ArMee Infotech’s commitment to innovation, diversity, and impactful digital solutions for India’s government and communities, these awards also validate ArMee Infotech’s growth from a modest startup to a ₹ 1000 crore revenue powerhouse.

Headquartered in Dubai, UAE, Finmall is an e-marketplace service provider focused on fintech and insurtech solutions. By creating innovative and ethical services that address the financial needs of different generations, it aims to make finance more accessible to help people manage their time, money, and effort more effectively
Formerly known as iBnk, Finmall is a fintech enterprise founded in 2023. The firm has gained immense recognition for its retail-assisted, embedded digital marketplace platform. It serves as an allin-one B2B2C ecosystem for consumers and retailers, offering access to nonphysical financial products and services such as mobile and wallet recharges, utility bill payments, flight bookings, school fees, money transfers, microloans, digital gold investments, and savings products.
Finmall connects service providers, including neo-digital banks, with retailers and end users, and enables cost-efficient access to essential digital financial services for underbanked communities. Its “phygital” business model, which blends physical reach with digital accessibility, allows the company to integrate underserved segments into the

broader shared economy. Through its mobile and web platforms, supported by a growing network of retail partners, it simplifies how financial institutions reach customers. Under the leadership of Dr. Mohammad Salem Omaid, Founder and CEO, the firm is redefining accessibility in financial technology through its Banking as a Service model. Expansion plans include entry into Saudi Arabia, other GCC nations, Africa, and parts of Asia within the next few years.

Finmall delivers a variety of everyday financial services to simplify people’s lives. Its offerings include Salik and M-Parking top-ups, utility and RTA (Nol) payments, loans, money transfers, rewards and loyalty programs, flight bookings, and prepaid mobile and DTH recharges. It also supports prepaid payment instruments, ensuring secure and convenient transactions that bring multiple financial solutions together under one platform.
Finmall has built strong collaborations with several reputable organisations, which reinforce its credibility and service quality. Shufti Pro, a regulated entity based in DIFC, Dubai, provides KYC, AML, CFT, and risk assessment solutions for onboarding merchants and service providers using AI-based identity verification. Travelwings enables easy domestic and international flight bookings through Finmall’s marketplace. Likewise, DING, a leading global provider of mobile top-up services, has partnered with Finmall to offer recharges and gift cards across more than 150 countries. DT ONE works with Finmall to deliver non-cash payment and digital prepaid solutions, extending reach to over 160 countries and a potential audience of five billion people.
Finmall complements its customer focus with a strong commitment to its employees. The company fosters a learning-oriented environment that encourages continuous improvement and performance excellence. Teams are equipped with advanced tools and technology, along with on-the-job mentorship that supports professional and personal development, ensuring a motivated and future-ready workforce.
Finmall envisions building a globally trusted phygital financial marketplace that meets a wide range of customer needs through a single, integrated platform. It aims to make approved financial products available quickly, securely, and affordably through retail stores and digital channels, ensuring every interaction is based on technology, transparency, and reliability.

The company was founded on a realisation that feels obvious yet radical in enterprise IT— people don’t need more dashboards, alerts, or manual fixes. They need relief. They need systems that anticipate issues, act intelligently, and resolve problems without breaking momentum. eBlissAI was created to bring back digital harmony at a time when complexity has surpassed what humans alone can manage.
eBlissAI is human-centered by design. The platform removes friction, reduces cognitive load, and helps people do their best work—faster, smoother, and with fewer interruptions. Its goal is not just operational efficiency, but emotional ease.
Enterprise IT has outgrown humanscale operations. Hybrid work, security threats, device sprawl, and data overload have made reactive, slow, and delayed IT a structural failure—driving several hundred billion dollars in cost and lost productivity every year. eBlissAI replaces firefighting with proactive intelligence through a compounding engine that senses, reasons, learns, and adapts—so every fix makes the system smarter.
At a technology level, this intelligence is delivered through a continuously learning architecture combining predictive analytics, multi-agent reasoning, and autonomous self-healing. Instead of static rules, the system evolves in real time to identify root causes, personalise responses, and prevent repeat failures.
“The world needs foresight, not more firefighting.”
Founder and CEO Mr. Shirish Nimgaonkar leads eBlissAI with a deeply human conviction: people deserve clarity, not chaos; flow, not friction; elevation, not


exhaustion. That purpose shapes how eBlissAI is built and how it grows— pairing disciplined execution with strategic empathy to turn complexity into confidence, and technology into a quiet enabler of progress.
eBlissAI is an AI-driven autonomous IT operations platform, headquartered in Massachusetts, built on a simple promise: technology should feel calm, supportive, and human. eBlissAI exists to elevate human experience and potential at work— restoring focus, flow, and confidence in a world overwhelmed by digital noise for a world where complexity keeps accelerating. Strengthened by leaders from IIT, Stanford, Harvard, MIT, Google, Target, Intel, and Meta, the team blends deep domain expertise with disciplined execution to deliver impact at enterprise scale.
“Excellence earns trust. Empathy gives it purpose. Execution turns both into impact.”
eBlissAI adapts to how people actually work. Developers need performance. Sales teams need reliability. Leaders need seamless responsiveness. The platform learns behavior patterns and real-time context to personalise experiences by role and environment—so work stays uninterrupted and intuitive.
eBlissAI is building the Autonomous IT Layer with multi-agent intelligence and an advanced architecture designed
For enterprises with large IT footprints— across banking, manufacturing, healthcare, and retail—eBlissAI reduces human intervention, speeds resolution, and lowers total cost of ownership while improving employee experience.
All this results in a 15x–45x ROI through predictive fixes, reduced downtime, and reclaimed productivity— along with something harder to quantify: calm, confidence, and creative momentum.
“When technology restores calm, people rediscover confidence, creativity, and their best work.”


Some brands wait for the market to move. Others move the market. This category of awards celebrates the latter — brands that have risen with speed, clarity, and conviction. Built on bold ideas and decisive action, these names have scaled quickly, compelling established players to look at the market through a new lens. They respond fast, adapt faster, and turn every challenge into momentum. These are brands whose growth tells a bigger story; it signals influence. They generate opport unity, reshape traditional models, and prove that relevance is driven by vision, not vintage. Recognised here are brands that show up every day with intent, resilience, and the hunger to keep raising the bar and redefine what success looks like



With a goal to streamline the insurance business through the use of technology, Acess Meditech is reshaping the global InsurTech industry with its intelligent automation solutions. By bridging the gaps between people, processes and performance, the organisation enables insurers to provide a consistent, compliant, and customer-centric experience internationally
stablished in 2007 with the vision of Syed Aijazuddin, Acess Meditech has evolved as a global technology partner that helps Insurers transform fragmented legacy solutions into a cohesive digital ecosystem. The company operates in the Middle East, Africa and South Asia where it has assisted insurers in modernising their underwriting, policy issuance, claims, reinsurance and customer service.
Its core platforms, LIMRA and Toshfa, are comprehensive ERP solutions developed from scratch and tailored to the specific operational and regulatory requirements of each client. LIMRA offers a comprehensive policy management, renewal and claims platform, whereas Toshfa provides health insurance solutions for TPAs and insurers, with faster implementation and integration. Acess Meditech’s solutions have made a clear difference by bringing 48 insurance products onto one system for Al Sagr Cooperative Insurance, reducing reconciliation errors by 30% and speeding up policy issuance by 40%.
Acess Meditech relies on innovation. It dedicates around 20% of revenue to R&D to enhance its automation, AI, and cloud offerings. Its AI-powered CoPilot and Dynamic Search tools simplify insurance work, handle complex queries with simple commands, cut search time by over half, reduce manual effort, and boost departmental efficiency.
Apart from AI, the firm is testing blockchain-based applications to facilitate clean reinsurance settlements and investigating IoT integration to power usage-based insurance solutions for the auto and upcoming health lines. They also guarantee strong compliance with NPHIES and NHIC standards within Saudi Arabia, the Central Bank reporting standards in the UAE, and AML/KYC regulations throughout
the APAC markets. And each system is GDPR-ready, for safe, transparent and compliant operations around the world.
Acess Meditech takes an adaptable, scalable, and collaborative approach. Considering each insurer’s unique systems and regulations, it develops modular solutions tailored to customer needs. Its process—from analysis and customisation to deployment and support—ensures smooth adoption and measurable results. Focused mainly on the APAC market, Acess Meditechs is expanding across borders through partnerships with regional compliance experts and developing regionspecific ERP solutions. It is also introducing modular product suites for small insurers and MGAs, thus facilitating flexibility and cost-effectiveness. These strategies help Access Meditech drive digital transformation, besides enabling insurers to achieve efficiency and sustainable growth in a competitive market.
Acess Meditech has consistently earned
recognition across the global technology and insurance ecosystem. It was twice honoured as Company of the Year by Silicon India and later acknowledged with the same title by CIO Review. APAC CIO Outlook spotlighted the company as a Top Insurance Tech Solution Provider and among the region’s Hottest Insurance Tech Companies. Insight Success. The firm also secured the Insurance ERP Product of the Year, received acclaim from WCRC Leaders and achieved the prestigious CMMI DEV ML 3 Class A Appraisal.





Ashiana Ispat Limited, an ISO 9001:2013-certified company, has been producing steel of exceptional strength since 1992. Serving India’s construction, engineering, automotive, and infrastructure sectors, it manufactures high-grade, value-added steel under the AL Kamdhenu Gold brand, designed for durability, resilience, and consistent performance
D For over two decades, Ashiana Ispat has supplied steel for what it calls ‘Damdar’ infrastructure (meaning strong and durable). The company ranks among India’s largest manufacturers of Turbo TMT Bars, ranging from 8 mm to 32 mm in diameter and available in Fe-415, Fe-500, and Fe-550 grades. Marketed as AL Kamdhenu Gold Saria, these bars have become a preferred choice for India’s construction community.
Under the leadership of Mr. Taarun V. Jain, MD of Legend Group, Strategic Business Partner of Ashian Ispat Limited, AL Kamdhenu Gold has evolved into a trusted name in the steel manufacturing industry. Through strategic investments and a focused growth plan, the brand has achieved rapid expansion, now operating with an annual turnover of ₹2000 crore, supported by more than 100 distributors and over 3,500 dealers across India. The Al Kamdhenu Gold TMT Bars are known for high ductility and a distinctive ribbed pattern that strengthens their bond with concrete. These bars exhibit superior resistance to corrosion and seismic stress, ensuring longlasting, reliable structures. Developed under the supervision of skilled engineers and metallurgists, AL Kamdhenu Gold TMT Bars feature a minimum Corrosion Resistance Index (CRI) of 1.7, making them well-suited for coastal and humid regions of the GCC. Laboratory tests show up to 70% lower corrosion compared with conventional TMT bars.
AL Kamdhenu Gold’s product portfolio goes beyond just reinforcement steel, including MS Pipes & Tubes, Steel Angles, Beams, Channels, Flat Bars, Color-Coated Sheets, GC Sheets, and Binding Wires. The superior quality of each product has earned the trust of builders, contractors, and industrial users across the country.
TAKING INDIAN STEEL WORLDWIDE
AL Kamdhenu Gold’s strong distribution
network remains one of its defining assets. With widespread dealer coverage, its highquality steel reaches nearly every major district in India. The brand is also planning to expand internationally to Nepal, the UAE, the GCC, and Africa.
The company’s ongoing research and development ensure its products stay aligned with the latest metallurgical innovations. A key advancement is the bars’ optimized section weight, deliberately set below the nominal value, which reduces steel consumption by 10–20% without affecting tensile strength. This strategy boosts efficiency, sustainability, and costeffectiveness for end users.
Built on transparency and integrity, AL Kamdhenu Gold has earned the confidence of stakeholders while maintaining leadership in a competitive industry. The company holds BIS certification, ISO 9001:2015, ISO 14001:2015, and UAE Taxation compliance. Ashiana Ispat Ltd. also received a Letter of Appreciation from the Minister of Steel, Government of India, for its contribution to strengthening the nation’s steel-production capacity.
Al Kamdhenu has been recognised as the Best TMT Bars Brand of the Year by bizzOPP, ET Edge, Times Group, and India’s Fastest Growing Brands 2025. These recognitions highlights the brand’s consistent focus on quality, innovation, and reliability. Widely trusted by builders and contractors across India, the brand has set high standards in TMT bar manufacturing, besides contributing to safer and stronger construction nationwide.



Allied Digital Services Limited (ADSL) is a leading provider of IT services and digital transformation for enterprises, governments, and institutions. With its excellence in innovation, customer centricity, and operations, the Indian company has established a global presence, delivering end-to-end digital solutions
ounded in 1984, ADSL is a trusted partner that helps businesses embrace digital transformation. With deep expertise in automation, it enhances efficiency, improves customer experience, and promotes sustainable growth.
ADSL’s services cover infrastructure management, cybersecurity, cloud solutions, and digital workplace and engineering services. The firm provides customised software for healthcare, transportation, education, and government organisations. It offers endto-end cloud migration, management, and data analytics capabilities. It also helps clients build frameworks for security operations, risk assessment, and regulatory compliance.
To strengthen digital workplaces, ADSL offers services such as remote infrastructure monitoring, service desk management, and end-user computing solutions. It also manages complex IT projects that seamlessly integrate hardware, software, and applications into unified digital systems.
ADSL has empowered digital-first organisations in both private and public sectors through customised, scalable solutions. The company reported strong Y-o-Y growth in revenue and profitability for 2024–2025, driven by rising demand for digital transformation and managed services. The organisation’s emphasis on high-value offerings, strong governance, ESG commitment, and disciplined financial management reinforces performance and builds investor confidence, supporting long-term value creation.
ADSL invests strategically in innovation, technology, and talent to strengthen its leadership in the digital era. It is
expanding its portfolio with advanced capabilities in AI, ML, IoT, and automation while emphasising sustainability through green IT, energy-efficient operations, and community initiatives. It also prioritises employee upskilling to foster innovation and continuous learning. The company also collaborates with global technology leaders and startups to broaden its service capabilities, accelerate innovation, and lead the Industry 4.0 transformation. Over the past four decades, ADSL has expanded across the Americas, Europe, the Middle East, and the Asia-Pacific region. It has facilitated digital transformation for Fortune 500 companies, multinationals, and government agencies worldwide through its global delivery centres and partner networks, delivering reliable, scalable, and secure digital solutions.
ADSL’s long-term goal is to expand its global presence and deepen its domain expertise across industries. The organisation has identified high-growth verticals for digital transformation in healthcare, finance, and smart city


projects. To stay ahead of the curve, it is strengthening its focus on cybersecurity and cloud services as key areas for future growth and innovation. Globally recognised for its advanced digital solutions, the firm received the ‘Best Organisation in Innovation’ award from ET Now – Global Innovation Network 2024 and was listed among ‘India’s Best Companies of the Year 2023’ as the Best IT Infrastructure Management Company by Berkshire Media LLC, USA, along with several other honours.





Aurigene Pharmaceutical Services Limited, headquartered in Bengaluru, is known for accelerating innovation to support global biotechs and pharmaceutical manufacturers. With strong scientific expertise and purpose driven mindset, the company is reshaping drug discovery through collaborative and innovative approaches
urigene Pharmaceutical Services Limited, an endto-end integrated global CRDMO is a wholly owned subsidiary of Dr. Reddy’s Laboratories. With the scientific expertise of 1000+ scientists including 450+ doctorates and with 16 USFDA sites across India, Mexico and Mirfield, it is a trusted CRDMO partner to biotechs and global pharma manufacturers, accelerating the journey of their assets from discovery to clinic. The organisation has undergone a significant transformation over the last few years, repositioning itself from a capacitycentric organisation to a capability and technology-led partner of choice.
Aurigene has broadened its portfolio through its integrated services platform spanning discovery, development, and manufacturing offerings for advanced modalities such as biologics, peptides, and nutraceuticals. Specific financial and clinical assets pipeline metrics have improved significantly over this period, with clinical stage assets and top line/ EBITDA growing by strong percentages.
The transformation has been driven by a clear strategy - build distinctive capabilities, strengthen foundations, and enable non linear growth. The leadership team set explicit multi-year goals, invested selectively in people and infrastructure, and worked closely with the broader manufacturing network of the parent group to embed world-class quality and operational standards, ensuring global compliance with unmatched agility. New digital tools were introduced across Lead Generation, Presales, finance, and project management processes, significantly improving turnaround times, data integrity, transparency, and funnel discipline, so that global programs can be run with high transparency and speed.
Aurigene has also driven significant
investments for building new facilities, advancing digital infrastructure - fixing foundational gaps while creating headroom for growth. These “fix the foundation” initiatives reduced operational friction and created a scalable backbone for future expansion.
Aurigene’s innovation agenda is anchored by its AI–Assisted Drug Discovery (AIDD) ecosystem, which integrates CADD, Bioinformatics, computational platforms, in-silico design, and data-driven decision tools into its discovery engine, allowing teams to design, prioritise, and optimise molecules efficiently. This has shortened cycle times, improved hit-to-lead quality, and differentiated Aurigene as a partner that can combine wet lab excellence with advanced analytics and AI. This enables the innovators to fail fast and iterate faster.
The company has articulated clear DEI goals, including significantly higher representation of women in senior leadership over the next decade, targeted
inclusion of persons with disabilities, and the creation of an employee resource group for women to strengthen networks and inform policy. On sustainability, Aurigene has committed to 100% renewable power and carbon neutral direct operations by 2030, material reductions in supply chain emissions, and has already achieved water positive status. Driven by innovation, Aurigene Pharmaceutical consistently focusses on real-time visibility and flexibility with clients ensuring faster turnaround-times and compliance.




Mumbai-based Avant Group is a prominent real estate firm known for its innovation, reliability, and excellence. The company focuses on delivering high-quality infrastructure while integrating advanced technology and sustainable practices. Its customer-centric projects have helped transform urban spaces into modern, future-ready communities
D Avant Group, founded in 2010 by Mr. Sudeep Saha, aims to redefine affordable luxury in India’s housing sector. Catering to the growing aspirations of the middle class, the group delivers high-quality residences with modern amenities at reasonable prices. Its projects are thoughtfully designed for a market segment often overlooked. Avant Group creates lifestyle spaces that support ambition, comfort, and modern aspirations, thereby empowering young India with homes that reflect contemporary living standards and elevated, well-planned communities.
Avant Group has, to date, successfully completed projects spanning over 8 lakh sq. ft. It is currently engaged in endeavours covering over 50 lakh sq. ft. in the western suburbs of Mumbai, including Khar, Vile parle, Andheri, Jogeshwari, Goregaon and Malad, as well as a second home project in Pawna. Apart from transforming lives, the group is also redefining the very landscape of Mumbai. With a robust emphasis on SRA (Slum Rehabilitation Authority) initiatives, the real estate player is revitalising previously neglected areas into desirable locales, enriched with contemporary amenities and proximity to elite social and commercial centres. Over the years, the Avant Group has successfully completed remarkable projects such as Avant Heritage-I, Avant Heritage-II, Avant Hillway and Avant Heera. Some of their current endeavours include Avant Heritage - V, Avant Heritage - IV, and Avant Heritage - III.
Avant Group is driven by a passionate team that values transparency, trust, and growth. The company encourages open communication and values constructive feedback, ensuring ideas flow freely. The
group nurtures its team through senior mentorship, a culture of lifelong learning, and constructive feedback. Employees are encouraged to grow personally and professionally within a performancedriven environment that recognises excellence and upholds a collective commitment to quality.
Avant Group upholds values of commitment, integrity, humility, and social responsibility. Its dedicated team focuses on delivering high-quality service, continually improving, and supporting one another. They recognise the contributions of clients, families, and colleagues while giving back to the community and helping those in need.
The Avant Group is deeply engaged in community service. Established in 2023, the Avant Sahaya Foundation is devoted to positively influencing the lives of orphans, children in need, and slum residents by providing them with educational opportunities. The Foundation supports
the education of one underprivileged child from the moment of booking of a property until the time of possession. Furthermore, it provides accessible medical assistance and educational resources to families in slums.
Avant Group has set new standards in affordable luxury housing. In May 2025, the group was featured in the Times of India for winning the Iconic Developer for Affordable Luxury award.





CALS Renewables reflects a confident push toward India’s clean energy future. Backed by extensive industry knowledge, focused leadership, and a commitment to dependable service, the company delivers practical solutions that help industries and communities adopt renewable power with clarity, purpose, and long-term value
Dstablished in December 2021, CALS Renewables, headquartered in Chennai (Tamil Nadu), develops utility-scale wind and solar projects, rooftop solar systems, solar pump installations, and commercial and industrial solar solutions. In just 1.5 years, the company has completed 25 MW of solar power projects and is on track to expand its capacity to 30 MW. CALS has also stepped into the solar production line. It ensures ongoing operational maintenance, thereby supporting clients long after project completion.
The company’s foundation rests on nearly 25 years of hands-on renewable energy experience. Under the stewardship of Founder, Chairman, and Managing Director Mr. Arul Balan R., a seasoned windmill specialist, CALS covers the entire project lifecycle with precision. From land identification and site assessment to installation, commissioning, and maintenance, the company brings together technical depth and reliable execution.
CALS’ mission is to advance renewable energy systems using non-conventional technologies that compete effectively with traditional power sources. Its vision to empower a billion lives through sustainable, affordable, and innovative energy solutions guides every initiative. The organisation adheres to the values of Care, Agile, Learning, Safety, and Ethics to shape its work culture and client engagement. The company offers complete EPC solutions for wind and solar projects. Its wind services include project management, engineering, quality assurance, site assessment, due diligence, and full-scope delivery. CALS also offers specialised technical support to help developers execute projects efficiently.
In the solar segment, CALS provides
integrated EPC services covering site planning, land agreements, permitting, grid interconnection, and power purchase facilitation. Whether executing utility-scale installations or offering advisory support, it ensures compliance, efficiency, and smooth progress across all project phases. CALS also delivers advanced rooftop solar systems for homes and businesses, thus turning unused roof space into powerful energy assets.
Its additional capabilities include skilled manpower solutions for wind turbine erection and operations, transmission and distribution commissioning up to 400 kV, captive and third-party power solutions, and strong regulatory and government affairs support. With experience in liaison, compliance, approvals, and stakeholder coordination, CALS helps clients navigate complex processes with confidence.
CALS Renewables’ modern manufacturing facility strengthens this ecosystem. Equipped with automated European technology, SAP-integrated operations, AI-driven analytics, and rigorous digital
quality systems, the facility produces highperformance and durable solar PV modules and energy storage systems.
CALS’ actively participates in impactful and meaningful social initiatives such as offering support to students at Panchayat Union Primary School in Keelapatti Village. Guided by Mr. Arul’s benevolence and committment to responsible growth, the company plays an active role in building a cleaner, greener, and a socially responsible future.



mroads is a global technology company driving innovation through IT, cloud, and AI-powered solutions. Founded in 2011, it partners with organisations worldwide to enable digital transformation, deliver measurable value, and build future-ready workforces through a customer-centric, sustainable, and holistic approach to business and technology
D Founded in 2011, mroads enables organisations to build innovative workforces by harnessing technology and data. The company operates independently of any single cloud platform and collaborates with clients worldwide to meet their technology and consulting needs. Its services include staff augmentation, consulting, and its flagship HR solution, Paññã. Under the leadership of its Founder, President, and CEO, Mr. Manohar Kesireddy, the company has expanded successfully. With offices in Plano, Texas, and Hyderabad, India, mroads has emerged as a trusted partner that approaches business challenges holistically.
In today’s fast-moving IT landscape, organisations face growing demands for efficiency, digital transformation, and resilient solutions. mroads focuses on enabling this transformation not just as a technical upgrade but as a complete solution to clients’ business challenges.
With over 11 years of experience, mroads has become a trusted partner for businesses across industries. The company offers a wide range of services, including talent solutions, data science, DevOps, cloud enablement, and quality assurance. It also provides staffing and talent solutions across multiple levels, with a focus on IT and digital roles. mroads’ clients include both small and large enterprises seeking to strengthen their teams through the firm’s expertise. To meet the growing demand for data science professionals, mroads trains teams in data science, machine learning, and advanced technology development. Additionally, to meet the rising demand for skilled professionals, it trains teams in data science, machine learning, and advanced technologies. As a DevOps service provider, it focuses on automation, software quality, and continuous deployment. Its strong expertise in software development
helps it deliver customised solutions and comprehensive quality assurance across all stages of software development, ensuring high-performing outcomes for every client.
mroads has achieved notable success with two groundbreaking solutions: Paññã and Saññã. Paññã, an AI-powered interview platform, simplifies hiring by speeding up screening, improving reliability, and helping recruiters identify top talent through a unified system. The platform supports live, face-to-face video interviews and candidateonly sessions. Using pre-built question banks and AI, it helps distinguish qualified applicants from those lacking relevant expertise. Saññã, on the other hand, is a cloud-based smart port solution that uses automated technologies to enhance seaport operations and tackle key challenges in the shipping industry through digital innovation.
Over the next five years, mroads aims to drive business transformation that benefits customers, society, and nations. With a focus on generative and ethical AI, the


company strives to reduce manual work, enhance work–life balance, and promote greater flexibility within organisations.
mroads received the prestigious Best Cloud-Agnostic Solutions Award at the World’s Future Awards 2024. It was also named among the 10 Most Recommended IT Service Providers of 2024 by CIO Insider Magazine In addition, mroads was honored with the Time2Leap Award at the MSME Innovation and Startup Summit.




Onix Renewable has grown into one of India’s most forward-thinking renewable energy enterprises, driving the transition from conventional fuels to clean power sources. The company develops efficient, low-emission solutions that contribute to a sustainable future and strengthen the nation’s clean energy framework
stablished in 2007, Onix Renewable has helped propel India’s shift toward sustainable energy. The firm has successfully delivered over 500 MW of wind, solar, storage, and hybrid projects, thus setting benchmarks in technical precision and environmental responsibility. Backed by an expert team of technocrats, Onix Renewable offers complete solutions, from design to maintenance and ensures operational reliability at every stage. With a current solar PV module capacity of 100 MW, Onix Renewable is on track to expand to 1,200 MW by 2025. Under the guidance of Chairman and Managing Director Mr. Divyesh Savaliya, the company is driving innovation in sustainable energy and collaborating with esteemed industry partners, including Idol, Balbir, Gril, SPML, Powerica, Ashoka, Gawar, Falcon, SIPC Kandla, JSW, Hinduja, Ayana, EDF, Torrent Power, Thermax, GUVNL, Cargill, TATA Power, ACME, and several others.
The company focuses on sustainable energy using environmentally responsible methods. Its solar rooftop systems provide affordable, clean electricity, besides reducing costs for households and businesses while enhancing energy independence and long-term sustainability. In the wind energy sector, the company holds one of India’s most extensive portfolios, encompassing 4.5 GW, which represents nearly 5% of the nation’s total wind capacity. Onix Renewable’s solar division demonstrates technical excellence by developing cost-effective projects based on careful analysis of land, solar radiation, grid infrastructure, and emerging technologies. Through meticulous risk assessment and project planning, the company ensures that every capital investment is executed with precision and foresight.
Onix Renewable has developed hybrid energy systems that combine wind and solar power to improve efficiency and cut
operating costs.
Onix Renewable’s product portfolio focusses on efficiency, durability, and innovation. Its solar modules are known for their reliability and exceptional performance in challenging environments.
The Onix Powerwall, built with modern battery technology, ensures advanced and uninterrupted energy storage during outages. Complementing this is Onix BESS, a next-generation storage system that provides cost-effective energy retention for residential and commercial users.
Onix Renewable has executed an array of landmark installations, including substations, hybrid power plants, windmills, solar ground mounts, industrial and residential rooftops, solar pumps, transmission and distribution lines, underground cabling, metering systems, and line-shifting projects.
Its current initiatives include the PMKUSUM Solar Project in Maharashtra and Gujarat, a Captive Solar Project, hybrid and wind power plants, and the Solar Park +
BESS initiative.
Onix Renewable has received several accolades for its excellence. The company was honoured with the Real Estate & Business Excellence Awards 2025 by Talent Value Media. It also was conferred with the “Best EPC Solar Company” award by TV9 in 2020, for its stellar performance in solar project construction. The brand has also been recognised with the Global Business Achievement Award for Renewable Energy.





EXCELLENCE IN HEALTHCARE AND HEALING
SUM Ultimate Medicare, headquartered in Bhubaneswar, Odisha, is a multi-speciality quaternary care hospital that delivers exceptional healthcare through advanced medical technology and compassionate patient care. With modern facilities and expert doctors, it has earned a strong reputation for delivering quality healthcare at affordable costs across the state
cutting-edge healthcare facility, SUM Ultimate Medicare is the go-to destination for healthcare and healing. The hospital delivers innovative treatments in a patientcentred and technologically advanced environment. It focuses on delivering efficient care while upholding integrity and accountability, supported by strong medical research and evidence-based learning.
THE COMMITMENT TO SERVE
Under the leadership of CEO, Dr. Swetapadma Das, SUM Ultimate Medicare goes beyond business goals to serve patients with care and dedication. Equipped with modern facilities, advanced medical technologies, a skilled team of doctors, physiotherapists, nurses, and technicians, the hospital ensures safe, compassionate, and high-quality treatment for all. With the aim of putting patients first, the hospital has built a “Bridge of Trust” with the community through openness and patient-friendly practices. By nurturing a culture rooted in empathy, compassion, coordination, and competence, it ensures high-quality care and achieves excellent clinical outcomes.
SUM Ultimate Medicare comprises multiple departments, including Anaesthesiology & Pain Management, Cardiology, Cardiovascular & Thoracic Surgery, Clinical Laboratory, Clinical Psychology & Counselling, Clinical Research, Critical Care Medicine, Dermatology & Venereology, Dentistry, Maxillofacial Surgery & Orthodontistry, Diabetology, ENT, Emergency Medicine, Paediatric Surgery, Pathology, Phlebotomy, Physiotherapy, Plastic, Cosmetic & Reconstructive Surgery, Psychiatry, Prosthetics & Orthotics, Radiology, Rheumatology, Respiratory Medicine, Robotic Surgery, Surgical Gastroenterology, Trauma Care, Urology, Wellness Health Check, 24-Hour Emergency
Ambulance Services, 24-Hour Pharmacy Services, Pulmonary Medicine, and Spine Surgery.
SUM Ultimate Medicare actively contributes to community-focused health initiatives through free health screenings, health awareness camps, cancer awareness programs, and Basic Life Support training at workplaces. Recent initiatives include a Health Screening Camp at Tushi Motors in Cuttack, a Mega Health Camp at Tata Ariana, a Health Screening Camp at OPHCA in Jagatsinghpur, a Health Camp at SBI RO, Cancer Awareness Talks at Vivant in Bhubaneswar and the National Informatics Centre, a Breast Cancer Awareness Session at Dalmia Cement, and a BLS First Aid Awareness Program at HPCL in Jatni.
SUM Ultimate Medicare has earned top recognition for healthcare excellence, including the prestigious Joint Commission International (JCI) Prime Certification, NABH accreditation within a year of its inception with the latest 5th Edition
Guidelines, and awards such as Best MultiSuper Specialty Quaternary Care Hospital, Pioneer in Advanced Healthcare at the OTV Business Odisha Awards 2025, and the Times Health Icon Award 2021. It was also presented with the Times Stellar Brand (East) Award 2021 in the Emerging category and earned the CII Recognition of Excellence in Nursing – 2021 for its voluntary efforts and exceptional service during the COVID-19 pandemic. The hospital was named the Best Patient Care Provider of the Year at the Six Sigma Healthcare Excellence Awards 2022.


Techurate Systems Pvt. Ltd. is a fintech company dedicated to bringing innovation, transformation, and smart banking experiences to markets worldwide. By supporting business growth, building a diverse global team, and driving social impact, the company serves developing and developed nations with equal focus


eadquartered in Bengaluru, India, Techurate Systems Pvt. Ltd. is a global leader in smart-banking technology that offers tailored digital solutions for banks and financial institutions. With operations across Africa, Latin America, the GCC, and India, the company excels through deep domain expertise and over 500 years of collective IT experience. Guided by its Co-Founder and CEO, Mr. Harshvardhan Pusala, Techurate adopts a bespoke approach that aligns with each client’s environment, digital-readiness, and business goals while effectively managing risks. Its portfolio covers every critical area of modern banking—digital and internet banking, mobile and agency banking, wallet banking, reports and analytics, FLEXCUBE services, reconciliation systems, onboarding solutions, loan management systems, USSD banking, smart-branch automation, API management, and technology consultancy.
Techurate has launched its Smart Branch in India to cater to the rising demand for seamless, paperless banking. The Smart Branch redefines teller operations by automating core processes and enabling self-service transactions. It digitises customer activities like onboarding, deposits, and withdrawals to enhance speed and accuracy, while supporting sustainable, eco-friendly banking. Techurate’s Smart Branch suite includes Smart Integration, Smart Biz, Smart Analytics, Smart Recons, Smart Omni, and Smart Corporate. With Smart Integration, banks can safely connect to third-party apps and enhance their digital services. Smart Biz empowers business customers to market and sell their products directly through the banking platform, creating new revenue streams. Smart Analytics converts data into actionable insight,
supporting performance optimisation and predictive decision-making. Likewise, Smart Recons automates reconciliation across channels, cutting costs and improving control, while Smart Corporate offers a complete digital banking platform for SME and SMB clients.
Techurate Systems serves customers across four continents, expanding digital banking access in underbanked regions. With 250+ banking partners in 15+ countries and proven impact in Zambia, Cameroon, and Botswana, the company is now strengthening its presence in Latin America and India.
At the Singapore Fintech Festival 2022, Techurate launched Tigiverse, a Digital Service Platform that enables end-toend digital transformation for financial enterprises. Tigiverse integrates modular products from mobile banking to Web 3.0 and Metaverse applications, providing banks with a secure, scalable, futureready digital ecosystem.
Techurate Systems Pvt. Ltd. has been recognised with multiple awards, including the Best Digital Banking Innovation Platform 2025 for its TigiOS platform by Outlook India. Additionally, the company’s Digital Banking Platform has been recognised as the “Banking App of the Year” at the eAfrica Awards 2025. Similarly, it has also been felicitated for innovation in “Smart Branch - Enabling Virtual Banking” at the Technoviti Awards 2023.


16th Edition – World’s Greatest Brands & Leaders 2025-26, 14th Edition – Asia’s Greatest Brands & Leaders 2025-26 and 15th Edition – India’s Greatest Brands & Leaders 2025-26
The 120 World’s Greatest Brands & Leaders 2025-26, Asia’s Greatest Brands & Leaders 2025-26 and India’s Greatest Brands & Leaders 2025-26 are a researchbased listing of Brands using both primary and secondary data researched across sixteen industries and sixty-two sub-categories evaluating Brands from all over Asia. World’s Greatest Brands, Asia’s Greatest Brands & India’s Greatest Brands are a mission where brands are scanned, researched, understood and, after much deliberation by a competent team of experts, put on deserving pedestals for the admiration and veneration of the world. We delve into the history of the brands, let their beams of achievement play with us, feel the fire within these brands, and move along with their driving force. Finally, after reveling in the process, we feature our humble yet expert insights into the making and rising of these brands that are truly the Greatest! For anyone who is interested in the success story of these Greatest Brands, or the fire within that made them succeed, or the driving force that put them on the path to great success, or finally the certitudes that make them great and the beacon of tomorrow that provides a hint and an insight into their future, we render in a transparent manner all the desirable information about these brands and more.
World’s Greatest Leaders 2025-26, Asia’s Greatest Leaders 2025-26 and India’s Greatest Leaders 2025-26
A few Leaders of the final 120 list of World’s Greatest Brands, Asia’s Greatest Brands & India’s Greatest Brands may be recognized for their contribution in building the brand. A number of these brands have corporates, entrepreneurs, first-generation or inheritance entrepreneurs, cooperatives, CMDs, Board of Directors involved behind the brands. Hence, a qualitative assessment would be done in the form of a research Leader Form which will have aspects of Vision for the company, Growth aspirations, and Corporate Social Responsibility. Finally, the Leader Forms with primary research data filled by the leaders will be sent to the jury for scoring along with the Brand scoring forms.
The first phase of the research will be initiated by generating a list of categories (to be covered under the purview of the survey mentioned at the end of this document). The entire research platform will be divided into:
A list of about 1200 brands across 16 industries and 62 sub-categories will be drawn up through secondary research driven by the URS Media research team and AsiaOne editorial team using online surveys via:
• Google Analytics
• Market studies
• Industry white papers
• Category-specific brand reports
• Brand-specific scrutiny
*Companies with net revenue exceeding US$12 billion will not be considered. Group turnovers will not be considered but may be only that of individual companies
The preliminary list of 1200 Brands generated of World’s Greatest Brands & India’s Greatest Brands will be scrutinized and graded on a scale of 1 to 10 (where 1 is the lowest and 10 is the highest) by the research and editorial teams to generate a list of the top 300 brands based on the following parameters:
1. Brand Popularity
2. Brand Innovation
3. Brand Growth
4. Brand Promise
5. Brand Impact
The list of the top 300 brands will then further be scrutinized by an independent jury. The brands will be rated on the parameters of Brand Popularity, Brand Innovation, Brand Growth, Brand Promise and Brand Impact on a scale of 1 to 10 (where 10 is the highest and 1 is the lowest).
Disclaimer
*In addition to the above methodology, a few Brands with relatively competitive scoring may be part of the list due to their recent yearonyear growth and emergence as a brand, but, these companies would be featured, if any, under Editor’s Choice feature and awards.
The final phase of the research will entail the analysis of the jury and editorial questionnaire ratings based on the above-mentioned parameters and weightage assigned below by the research and editorial teams: Analysis: The 120 World’s Greatest Brands and Leaders, Asia’s Greatest Brands and Leaders and India’s Greatest Brands and Leaders list will be based on the cumulative scores of the shortlisted Brands received from the Jury Council and the research and editorial teams. URS Media’s editorial team will shortlist from 1200 to 300 and then based on the weightage given to the independent Jury scoring a final list of 120 Brands will be created. The list of the 16 industries and their sub-categories covered under the purview of the study is as follows: Automotive, Education, Energy & Power, Finance, Food & Beverages, Healthcare, Household Products, Infrastructure, IT & Telecom, Lifestyle, Manufacturing, Media & Entertainment, Personal Care, Real Estate, Retail and Services.

PRO VICE CHANCELLOR
HIMALAYIYA UNIVERSITY, DEHRADUN (UTTARAKHAND)
Dr. Rajesh Naithani completed his post-graduation from Kurukshetra University, Kurukshetra, Haryana, India. He was awarded PhD with Ranbaxy Fellowship from Kurukshetra University. He has done MBA in Stuart School of Business, Illinois Institute of Technology Chicago. He is a medicinal chemist with more than 20 years of experience. Presently, Dr. Naithani is the Pro Vice Chancellor of Himalayiya University, Dehradun. Apart from his academic experience; he has been associated with several national and international educational institutions and sociodevelopmental organizations as advisory positions. He served as Advisor to the Chief Minister of Uttarakhand. He worked as an Advisor to the former Education Minister, Government of India. Apart from being a cancer scientist, he has been involved in strategy management, marketing, and communications. A senior scientist in the USA who had a bright career in research, he decided to return and serve his homeland, India and spearheaded myriad initiatives to prepare underprivileged youth for life.
VICE CHANCELLOR, IILM UNIVERSITY, GURUGRAM
An astute academic, a thought leader, an institution builder, and a celebrated author, behavioural scientist and management professional with path-breaking contributions to academic administration, flexible curriculum design, and contribution to skill development in India have garnered international acclaim. Her diverse experiences have played a key role in her establishment of a broad network of professionals, spanning from creative artists to corporate leaders and policymakers. Currently serving as the Vice Chancellor at IILM University, Gurugram. She has served as the VC SPSU Udaipur, Pro VC Amity University Gurugram. She serves as the governing body member at Medanta Institute of Education and Research, editor of the SIS Journal of Projective Psychology & Mental Health and International Journal of Hinduism and Philosophy, and Bhagavad Geeta Research Foundation UK.

DIRECTOR, BRENCIS CENTRE FOR RESEARCH TRAINING & CONSULTANCY (BCRTC) EDUCATION
Currently helming the position of a Director at Brencis Centre for Research Training and Consultancy (BCRTC) in Ghaziabad, India, Dr. Amita Srivastava is a well-known expert in the fields of Management Philosophy, Strategic Management, Human Resource Development, Quality Systems, and Human Values. A gold medalist in her area of expertise, she has experience spanning more than 25 years in areas of Research, Training, Consultancy, Teaching, and Administration in Management. She has conducted many FDPs and MDPs, and done assignments for some leading Institutions of National and International repute like IIM-(Lko), Nuvia (UK), UNIDO, Central Defence Academy, Syndicate Bank, IBA, Semi-Conductor Complex Ltd., ABCL, Kirloskar Brothers, WPIL Ltd., Jaipur Stock Exchange, and KRIBHKO. She has also been the Chief Editor for management journal, Attitude and has been functional in organising many national and international conferences. She has widely experimented with new approaches to learning and creativity.


DIRECTOR, ICFAI GROUP
Mr. Sudhakar Rao, Director at ICFAI, brings a wealth of expertise and a remarkable career spanning over two decades in branding, marketing, corporate relations, and international operations. A Mechanical Engineering graduate, he pursued his Post Graduate Program in Management at IIM Bangalore and recently completed a specialised program on “Design Thinking” from MIT Sloan School of Management. Starting his career as a Brand Manager and rising to the roles of SBU Head and Director, Mr. Rao has worked across diverse sectors such as textiles, food, and education, launching and nurturing numerous brands to prominent market positions. Currently, Mr. Rao oversees branding for ICFAI’s extensive network, including 11 universities, 9 business schools, 7 tech schools, 7 law schools, and a comprehensive distance learning program. As the Chairperson for Education at FICCI, he is a soughtafter keynote speaker at national and international forums.

At NBR Group, we redefine urban living by crafting exceptional spaces for homeowners. Recognized as one of the best real estate companies in Bangalore, we offer a seamless blend of elegance, innovation, and exclusivity in every project.The Best Real Estate Company in Bangalore with a legacy spanning over 2 decades, we are among the leading builders in Bangalore, known for delivering premium developments in prime locations such as Sarjapur, Hosur, and Nandi Hills and coming up with Luxury High Rise at Sarjapur road-Whitefield . Each project is a masterpiece, thoughtfully designed with world-class amenities, modern architecture, and lush green spaces. Our homes are more than residences–they are a statement of style and comfort. As one of the leading real estate developers in Bangalore, we strategically choose locations near IT corridors, top schools, and premier healthcare facilities, ensuring unmatched connectivity and convenience.









